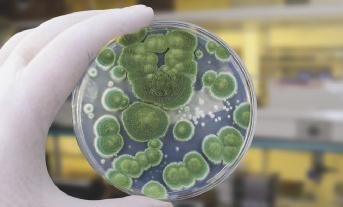

CIÊNCIAS DA NATUREZA
COLEÇÃO
baobá
LIVRO DO PROFESSOR
Anos Iniciais do Ensino Fundamental
Componente curricular: Ciências da Natureza
LEANDRO PEREIRA DE GODOY
Mestre em Microbiologia pela Universidade Estadual de Londrina (UEL-PR).
Bacharel e licenciado em Ciências Biológicas pela UEL-PR.
Atuou como professor na rede particular de Ensino Superior. Ministrou aulas na rede estadual de ensino do Paraná para Ensino Fundamental, Ensino Médio e Ensino Técnico.
Realiza palestras, cursos e assessorias para professores em escolas públicas e particulares.
Autor de livros didáticos para o Ensino Fundamental e o Ensino Médio.
1a edição, São Paulo, 2025
Copyright © Leandro Pereira de Godoy, 2025
Direção-geral Ricardo Tavares de Oliveira
Direção de conteúdo e performance educacional Cintia Cristina Bagatin Lapa
Direção editorial adjunta Luiz Tonolli
Gerência editorial Natalia Taccetti, Nubia de Cassia de M. Andrade e Silva
Edição Valquiria Baddini Tronolone (coord.), Leve Soluções Editoriais
Preparação e revisão Leve Soluções Editoriais
Produção de conteúdo digital Leve Soluções Editoriais
Gerência de produção e arte Ricardo Borges
Design e projeto de capa Bruno Attili
Imagem de capa vectorfusionart/Adobestock/Easy Mediabank
Arte e produção Leve Soluções Editoriais
Diagramação Leve Soluções Editoriais
Coordenação de imagens e textos Elaine Bueno Koga
Licenciamento de textos Leve Soluções Editoriais
Iconografia Leve Soluções Editoriais
Ilustrações Alex Argozino, Alex Silva, Allmaps/Samira Dantas, Artur Fujita, Bentinho, Dani Maximo, Estúdio Ampla Arena, Estúdio Ornitorrinco, Fabio Eugenio, Fórmula Produções Editoriais, Leo Teixeira, Lucas Farauj, Luis Moura, Luiz Rubio, Mauro Salgado, OracicArt, Roberto Weigand, Rodrigo Figueiredo/YANCOM, Samira Dantas, Vanessa Alexandre
Cartografia Leve Soluções Editoriais
Dados Internacionais de Catalogação na Publicação (CIP) (Câmara Brasileira do Livro, SP, Brasil)
Godoy, Leandro Pereira de Baobá : ciências da natureza : 4º ano : ensino fundamental : anos iniciais / Leandro Pereira de Godoy. – 1. ed. – São Paulo : FTD, 2025. – (Coleção Baobá)
Componente curricular: Ciências da Natureza
ISBN 978-85-96-06362-3 (livro do estudante)
ISBN 978-85-96-06363-0 (livro do professor)
ISBN 978-85-96-06364-7 (livro do estudante HTML5)
ISBN 978-85-96-06365-4 (livro do professor HTML5)
1. Ciências da natureza (Ensino fundamental) I. Título II. Série.
25-299127.1
Índices para catálogo sistemático:
CDD-372.35
1. Ciências da natureza : Ensino fundamental 372.35
Maria Alice Ferreira - Bibliotecária - CRB-8/7964
Reprodução proibida: Art. 184 do Código Penal e Lei 9.610 de 19 de fevereiro de 1998. Todos os direitos reservados à EDITORA FTD
Rua Rui Barbosa, 156 – Bela Vista – São Paulo – SP CEP 01326-010 – Tel. 0800 772 2300
Caixa Postal 65149 – CEP da Caixa Postal 01390-970 www.ftd.com.br central.relacionamento@ftd.com.br
Em respeito ao meio ambiente, as folhas deste livro foram produzidas com fibras obtidas de árvores de florestas plantadas, com origem certificada.
Impresso no Parque Gráfico da Editora FTD CNPJ 61.186.490/0016-33
Avenida Antonio Bardella, 300 Guarulhos-SP – CEP 07220-020 Tel. (11) 3545-8600 e Fax (11) 2412-5375
APRESENTAÇÃO
Queridos professores,
Este Livro do Professor foi pensado como um companheiro para suas aulas de Ciências. A ideia é facilitar o entendimento dos conteúdos e torná-los interessantes, por meio da apresentação de exemplos próximos da realidade dos estudantes e alinhados à Base Nacional Comum Curricular (BNCC).
Neste livro, encontram-se sugestões de atividades extras, ideias de abordagem, indicações de leitura e links para acessar materiais que podem enriquecer suas aulas. Tudo isso foi preparado para dar segurança ao planejamento e abrir espaço à criatividade de cada professor.
Desejamos que este material ajude a transformar cada aula em uma oportunidade de descoberta e encantamento com as Ciências da Natureza.
Um fraterno abraço e desejos de um excelente caminho!
SUMÁRIO
3.
4.
5.
2.3
2.4
DOS CONTEÚDOS, COMPETÊNCIAS E HABILIDADES
CONHEÇA SEU LIVRO
A coleção é composta do Livro do Estudante e do Livro do Professor, nas versões impressa e digital.
LIVRO DO ESTUDANTE
Nesse livro, apresentamos os temas entrelaçando texto e imagem, a fim de familiarizar os estudantes com a exploração do registro visual. Com as seções e as atividades distribuídas nos capítulos, pretende-se, sobretudo, auxiliar os estudantes a desenvolver as competências leitora e escritora, que são complementares e interdependentes, e capacitá-los para o exercício da cidadania.
SISTEMA DE POSICIONAMENTO GLOBAL (GPS)
os aparelhos ou aplicativos que o utilizam podem ajudar as pessoas a traçar caminhos e encontrar rotas para diferentes destinos. O GPS pode ser usado em aparelhos como celulares, tablets e computadores, além de veículos como carros, aviões e navios. Ele funciona por meio de sinais enviados e recebidos por satélites artificiais que giram em torno da Terra. Esses satélites são produzidos pelo ser humano para, entre outras funções, se comunicar com os aparelhos na Terra, o que possibilita indicar a localização pelo GPS com boa precisão.

LIVRO DO PROFESSOR
SISTEMA DE POSICIONAMENTO
GLOBAL (GPS)
Os instrumentos de orientação mais utilizados atualmente costumam usar o Sistema de Posicionamento Global conhecido pela sigla GPS (do inglês, Global Positioning System). Esse sistema informa, com boa precisão, a posição de um aparelho
O Livro do Professor está organizado em duas partes. Na primeira parte, o Livro do Estudante é reproduzido na íntegra, em miniatura, com algumas orientações e respostas em magenta. Nas laterais e abaixo da reprodução das páginas do Livro do Estudante, estão presentes as seguintes seções: Introdução à unidade (breve descrição dos principais conteúdos explorados na unidade); Habilidades (lista de habilidades trabalhadas na unidade); Objetivos de aprendizagem (lista dos objetivos de aprendizagem da unidade); Encaminhamento (orientações para o trabalho pedagógico com os assuntos presentes no Livro do Estudante); Orientações e respostas (demais orientações e/ou respostas relacionadas às atividades presentes no Livro do Estudante); Para oprofessor (sugestões de recursos que podem ser utilizados para apoiar o trabalho pedagógico ou para complementar a formação continuada do professor); Para o estudante (sugestões de recursos que podem ser indicados aos estudantes para auxiliar em seu processo de aprendizagem); Texto de apoio (material textual de terceiros que apoia o trabalho pedagógico ou complementa a formação continuada do professor); +Atividades (atividades complementares de recuperação de aprendizagens e de aprofundamento de conteúdos. Há sugestões de realização com os membros da família ou responsáveis).

ficas, o GPS pode determinar a velocidade de objetos em movimento, como carros, bicicletas ou até mesmo pessoas caminhando ou correndo. Comentar suas múltiplas aplicações no cotidiano, na navegação terrestre, aérea e marítima, além do uso em esportes, serviços de entrega e monitoramento.

PROBOWENING/SHUTTERSTOCK.COM
descobertas e refletir sobre o que aprenderam.
Na segunda parte, são apresentados os subsídios teóricos que sustentam a coleção.
OBJETOS EDUCACIONAIS DIGITAIS
Ao longo do volume, ícones indicam objetos digitais que podem ser acessados pelo professor e pelos estudantes para enriquecer a aprendizagem de maneira dinâmica e promover o uso de ferramentas digitais presentes no dia a dia.
CIÊNCIAS DA NATUREZA
COLEÇÃO
baobá
LIVRO DO PROFESSOR
Anos Iniciais do Ensino Fundamental
Componente curricular: Ciências da Natureza
LEANDRO PEREIRA DE GODOY
Mestre em Microbiologia pela Universidade Estadual de Londrina (UEL-PR).
Bacharel e licenciado em Ciências Biológicas pela UEL-PR.
Atuou como professor na rede particular de Ensino Superior. Ministrou aulas na rede estadual de ensino do Paraná para Ensino Fundamental, Ensino Médio e Ensino Técnico.
Realiza palestras, cursos e assessorias para professores em escolas públicas e particulares.
Autor de livros didáticos para o Ensino Fundamental e o Ensino Médio.
1a edição, São Paulo, 2025
Copyright © Leandro Pereira de Godoy, 2025
Direção-geral Ricardo Tavares de Oliveira
Direção de conteúdo e performance educacional Cintia Cristina Bagatin Lapa
Direção editorial adjunta Luiz Tonolli
Gerência editorial Natalia Taccetti, Nubia de Cassia de M. Andrade e Silva
Edição Valquiria Baddini Tronolone (coord.), Leve Soluções Editoriais
Preparação e revisão Leve Soluções Editoriais
Produção de conteúdo digital Leve Soluções Editoriais
Gerência de produção e arte Ricardo Borges
Design e projeto de capa Bruno Attili
Imagem de capa vectorfusionart/Adobestock/Easy Mediabank
Arte e produção Leve Soluções Editoriais
Diagramação Leve Soluções Editoriais
Coordenação de imagens e textos Elaine Bueno Koga
Licenciamento de textos Leve Soluções Editoriais
Iconografia Leve Soluções Editoriais
Ilustrações Alex Argozino, Alex Silva, Allmaps/Samira Dantas, Artur Fujita, Bentinho, Dani Maximo, Estúdio Ampla Arena, Estúdio Ornitorrinco, Fabio Eugenio, Fórmula Produções Editoriais, Leo Teixeira, Lucas Farauj, Luis Moura, Luiz Rubio, Mauro Salgado, OracicArt, Roberto Weigand, Rodrigo Figueiredo/YANCOM, Samira Dantas, Vanessa Alexandre
Cartografia Leve Soluções Editoriais
Dados Internacionais de Catalogação na Publicação (CIP) (Câmara Brasileira do Livro, SP, Brasil)
Godoy, Leandro Pereira de Baobá : ciências da natureza : 4º ano : ensino fundamental : anos iniciais / Leandro Pereira de Godoy. – 1. ed. – São Paulo : FTD, 2025. – (Coleção Baobá)
Componente curricular: Ciências da Natureza
ISBN 978-85-96-06362-3 (livro do estudante)
ISBN 978-85-96-06363-0 (livro do professor)
ISBN 978-85-96-06364-7 (livro do estudante HTML5)
ISBN 978-85-96-06365-4 (livro do professor HTML5)
1. Ciências da natureza (Ensino fundamental) I. Título II. Série.
25-299127.1
Índices para catálogo sistemático:
CDD-372.35
1. Ciências da natureza : Ensino fundamental 372.35
Maria Alice Ferreira - Bibliotecária - CRB-8/7964
Reprodução proibida: Art. 184 do Código Penal e Lei 9.610 de 19 de fevereiro de 1998. Todos os direitos reservados à EDITORA FTD
Rua Rui Barbosa, 156 – Bela Vista – São Paulo – SP CEP 01326-010 – Tel. 0800 772 2300
Caixa Postal 65149 – CEP da Caixa Postal 01390-970 www.ftd.com.br central.relacionamento@ftd.com.br
Em respeito ao meio ambiente, as folhas deste livro foram produzidas com fibras obtidas de árvores de florestas plantadas, com origem certificada.
Impresso no Parque Gráfico da Editora FTD CNPJ 61.186.490/0016-33
Avenida Antonio Bardella, 300 Guarulhos-SP – CEP 07220-020 Tel. (11) 3545-8600 e Fax (11) 2412-5375
APRESENTAÇÃO
Você sabia que estudar Ciências nos permite entender melhor o mundo em que vivemos?
Neste livro, apresentamos temas sobre os seres vivos, o corpo humano, o ambiente e muitos outros assuntos. Você poderá descobrir, por meio de textos, imagens e atividades, como as Ciências se relacionam com o nosso dia a dia e por que é importante conhecê-las.
Ao explorarmos esses temas, também compreendemos melhor o lugar onde vivemos. Aprender sobre o planeta Terra nos mostra que ele é nosso lar e precisamos cuidar dele. Quanto mais conhecemos, mais fácil é proteger e valorizar o mundo que nos cerca. Afinal, só se ama aquilo que se conhece!
Bons estudos!
O autor.


Você
CAPÍTULO 2 –


CAPÍTULO 2 – INSTRUMENTOS DE ORIENTAÇÃO
O magnetismo da Terra .........................................................................
Sistema de Posicionamento Global (GPS) ..........................................
Você cientista! BÚSSOLA CASEIRA
CAPÍTULO 3 – MOVIMENTOS DA TERRA E DA LUA
Rotação da Terra
Você cientista! MODELO DE ROTAÇÃO DA
Translação da Terra

Dialogando com História e Geografia –

OBJETOS DIGITAIS
Infográfico clicável – História do pão 23
Infográfico clicável – Biogás 27
Infográfico clicável – Como a vacina chega até você? .......... 37
Infográfico clicável – Relações alimentares no Pantanal 58
Infográfico clicável – Reações reversíveis e irreversíveis na cozinha 90
Infográfico clicável – Traçando rotas ........................................ 125
Algumas atividades são acompanhadas de ícones. Descubra o significado de cada um.
Atividade oral.
Atividade em dupla.
Atividade em grupo.
Atividade para casa.
Esta obra também é acompanhada de infográficos clicáveis que complementam e ampliam seu aprendizado. Eles estão indicados no sumário e nas respectivas páginas com um ícone.
ALEXARGOZINO
O QUE SABEMOS?
Esta seção favorece o diagnóstico dos conhecimentos dos estudantes sobre os conteúdos já trabalhados em anos anteriores. Alguns serão aprofundados neste ano. Para desenvolvê-la, sugere-se orientar os estudantes a realizar as atividades individualmente e a registrar as respostas no caderno. Ao final, convidar a turma a compartilhar suas respostas oralmente, promovendo uma discussão coletiva. Alternativamente, é possível solicitar que as respostas sejam registradas e entregues em uma folha de papel sulfite, de modo que possam ser utilizadas para orientar o planejamento das próximas aulas.
| ORIENTAÇÕES E RESPOSTAS
1. a) O tuiuiú vive em ambiente terrestre, mas utiliza o ambiente aquático para buscar alimentos.
b) O tuiuiú pode caminhar (com o auxílio das pernas) ou voar (com o auxílio das asas).
c) O corpo do tuiuiú é coberto de penas.
d) O tuiuiú pode ser classificado como carnívoro, pois se alimenta de outros animais (em uma das fotografias, está se alimentando de um peixe).
O QUE SABEMOS?
1 Um cientista estava estudando animais em uma região de Mato Grosso do Sul. Ele registrou, por meio de fotografias, o comportamento de um tuiuiú ao longo do dia. Observe algumas dessas fotografias para responder às questões.




Tuiuiú em diferentes situações ao longo de um dia. Consultar orientações e respostas no Livro do Professor.
a) O tuiuiú vive em que tipo de ambiente?
b) Como o tuiuiú se locomove? Quais estruturas ele utiliza para se movimentar?
c) O corpo do tuiuiú é coberto por que tipo de revestimento?
d) Com base nas fotografias, o tuiuiú pode ser classificado como um animal herbívoro ou carnívoro? Explique sua resposta.
2 Considere os animais indicados a seguir.
jacaré beija-flor tartaruga coruja tucano serpente
• Como você organizaria esses animais em dois grupos diferentes? Explique o critério que utilizou.
Consultar orientações e respostas no Livro do Professor 8
2. Resposta pessoal. Avaliar os agrupamentos feitos pelos estudantes. Sugestão: animais com penas (beija-flor, coruja e tucano) e animais sem penas (jacaré, tartaruga e serpente).
Nesta atividade, os estudantes podem retomar a habilidade EF03CI06, relacionada ao agrupamento dos seres vivos com base em suas características externas comuns.
Esta atividade tem como objetivo investigar o conhecimento dos estudantes sobre o modo de vida dos animais, fazendo uso da análise de imagens que retratam comportamentos de um tuiuiú. O tema está relacionado à habilidade EF03CI04 e sua retomada contribui para o estudo da habilidade EF04CI04, ao possibilitar a compreensão das relações alimentares entre os seres vivos, pelo reconhecimento da posição de cada um nas cadeias alimentares.
NÃO ESCREVA NO LIVRO.
3 Analise a fotografia a seguir e faça o que se pede.

Consultar orientações e respostas no Livro do Professor
ao papel desempenhado pelos decompositores. A decomposição será aprofundada neste volume, contemplando a habilidade EF04CI06. 5. I-A; II-C; III-B.
Pessoas caminhando no Parque Nacional dos Lençóis Maranhenses, em Santo Amaro do Maranhão, no Maranhão, 2024.
a) Qual é a fonte de luz presente na fotografia? Classifique-a em artificial ou natural.
b) Explique como as sombras das pessoas são formadas.
4 Observe a seguir as fotografias de três amostras de solo (1, 2 e 3).
Três amostras de solo.


2 3
Consultar orientações e respostas no Livro do Professor

a) Sabendo que as amostras correspondem a um solo arenoso, um solo argiloso e um solo humífero, identifique-as, considerando características como o tamanho das partículas e a cor.
b) De modo geral, qual das três amostras de solo apresenta maior quantidade dos nutrientes necessários para o desenvolvimento das plantas?
5 Copie as frases a seguir no caderno e relacione corretamente os astros às informações sobre cada um deles.
I. Sol.
II. Lua.
III. Estrelas distantes.
Consultar orientações e respostas no Livro do Professor
A. Astro luminoso que é visto só durante o dia.
B. Astros luminosos que são vistos só durante a noite.
C. Astro iluminado que pode ser visto durante o dia e durante a noite, dependendo da fase em que se encontra.
3. a) A fonte de luz é o Sol, uma fonte natural.
b) A luz se propaga em linha reta. Quando a luz encontra em sua trajetória um material opaco, como o corpo das pessoas, não consegue atravessá-lo. Assim, forma-se uma sombra atrás dele. Esta atividade propõe a análise de uma fotografia na qual se pode observar a formação de sombras. Esse trabalho resgata o conteúdo relacionado à habilidade EF03CI02, que trata da interação da luz com materiais opacos. A partir dele, cria-se uma base para avançar para as
habilidades EF04CI09 e EF04CI10, relacionadas à observação e à compreensão da formação de sombras por meio do uso de um gnômon.
4. a) 1: solo argiloso; 2: solo humífero; 3: solo arenoso.
b) Solo 2 (humífero).
Esta atividade retoma o estudo sobre o solo ao propor a comparação entre três amostras representadas em imagens, mobilizando a habilidade EF03CI09 Além disso, destaca a presença de grande quantidade de matéria orgânica no solo humífero, característica associada
Com esta atividade, é possível avaliar os conhecimentos dos estudantes sobre os astros visíveis no céu em diferentes períodos do dia e da noite, mobilizando a habilidade EF03CI08. Além disso, é uma oportunidade de introduzir o estudo sobre o movimento aparente do Sol ao longo do dia e sobre as diferentes fases da Lua, conteúdo que será aprofundado neste volume, de modo a contemplar a habilidade EF04CI11
NÃO ESCREVA NO LIVRO.
INTRODUÇÃO À UNIDADE
Esta unidade aborda assuntos relacionados aos microrganismos, incluindo as características e aplicações do microscópio, além de definir microrganismos e fornecer alguns exemplos, como bactérias, protozoários, fungos e algas. Os vírus são explorados como um caso à parte, uma vez que parte da comunidade científica não os considera seres vivos.
Também são abordadas as aplicações dos microrganismos em diversos setores da sociedade, como na fabricação de alimentos, na produção de medicamentos e de vacinas, na agricultura e na produção de combustíveis. Por fim, são destacadas as principais doenças causadas por microrganismos e por vírus, considerando suas diferentes formas de transmissão, além de atitudes que contribuem para a prevenção delas.
HABILIDADES
• EF04CI07
• EF04CI08
OBJETIVOS DE APRENDIZAGEM
• Compreender a importância dos microscópios para o avanço da Ciência e o estudo dos microrganismos.
• Descrever as principais características de bactérias, protozoários, algas e fungos.
• Reconhecer características dos vírus que motivam parte dos pesquisadores a não classificá-los como seres vivos.
• Identificar aplicações dos microrganismos em diferentes setores da sociedade, como saúde, indústria e agricultura.
• Refletir sobre o papel dos microrganismos em
MUNDO MICROSCÓPICO 1
AS CORES NÃO SÃO REAIS

inovações tecnológicas que promovem benefícios ambientais e sociais.
• Conhecer diferentes doenças causadas por microrganismos, considerando seus agentes causadores, formas de transmissão e principais sintomas.
• Propor atitudes para a prevenção de doenças causadas por microrganismos, com base no conhecimento de suas formas de transmissão.
• Reconhecer a importância de adotar hábitos de higiene para a manutenção da saúde.
ENCAMINHAMENTO
Convidar os estudantes a observar atentamente a imagem e a descrevê-la. Para auxiliá-los, sugere-se realizar alguns questionamentos, como:
• Que ambiente está representado na imagem? Como vocês chegaram a essa conclusão?
• Que componentes típicos desse ambiente da casa estão representados na imagem? Quais vestimentas são utilizadas pelos personagens? O que elas estão fazendo?
Representação de família preparando alimento.
IMAGENS FORA DE PROPORÇÃO.
Em quais lugares você gosta de estar? Em casa, preparando uma refeição com a família? No parque, passeando? Brincando com os amigos?
Não importa o lugar, estamos sempre em contato com seres vivos. Alguns são fáceis de observar, como uma árvore, um cachorro ou uma borboleta. Mas há outros seres vivos que, mesmo estando praticamente em todos os lugares, não conseguimos vê-los.
Qual será a importância de conhecer esses seres vivos? Quais relações eles apresentam com o ambiente? E com a saúde do ser humano? Essas e outras perguntas serão respondidas no estudo desta unidade.
1. Elas estão preparando pão.
1. Que alimento as pessoas da imagem estão preparando?
2. Resposta pessoal. Verificar se os estudantes já associam microrganismos aos seres vivos que não são vistos a olho nu.
É possível que eles citem os termos micróbios ou germes nas respostas.
2. Para o preparo desse alimento é comum o uso de microrganismos. Você sabe o que são microrganismos?
Explicar que, embora esses termos geralmente estejam associados a doenças, a maioria dos microrganismos não é prejudicial ao ser humano.
3. Como você acha que um microrganismo pode ser observado?
Resposta pessoal. Aproveitar a oportunidade para trabalhar hipóteses com os estudantes e verificar o que já sabem sobre o microscópio e sua relação com a observação de microrganismos.

O trabalho com a página e com as questões propostas incentiva os estudantes a se expressarem com clareza, a fim de serem compreendidos em uma situação de intercâmbio oral. Portanto, essa etapa estimula a leitura de imagem e a oralidade, além de promover a interação entre os estudantes. Trabalham-se, assim, as habilidades de Língua Portuguesa indicadas a seguir.
• EF15LP09: Expressar-se em situações de intercâmbio oral com clareza, preocupando-se em ser compreendido pelo interlocutor e usando a palavra com
tom de voz audível, boa articulação e ritmo adequado.
02/10/25 15:49
• EF15LP11: Reconhecer características da conversação espontânea presencial, respeitando os turnos de fala, selecionando e utilizando, durante a conversação, formas de tratamento adequadas, de acordo com a situação e a posição do interlocutor.
Utilizar a imagem para articular o cotidiano da turma com os conteúdos científicos abordados no capítulo, especialmente com o da atuação dos fungos no processo de fermentação. Para verificar
os conhecimentos prévios dos estudantes sobre o assunto, perguntar:
• Como vocês imaginam que esse alimento é preparado? Quais ingredientes são utilizados? Quais procedimentos são realizados?
• Depois de a massa do pão ser feita, ela deve “descansar”, ou seja, ficar um tempo parada. Vocês sabem por quê?
Se considerar oportuno, durante a execução das unidades, elaborar um portfólio com as produções dos estudantes, de maneira a contribuir para a avaliação individual.
ATIVIDADES FAMÍLIA
Com seus responsáveis, os estudantes devem preparar um alimento simples de sua escolha. Verificar a possibilidade de sugerir a produção de um alimento que possa ter ação de microrganismos, como uma massa de pão com fermento biológico ou um iogurte caseiro a partir de iogurte natural. Informar aos estudantes que deverão registrar o momento com fotografias ou desenhos e que posteriormente serão compartilhados em sala de aula, em um mural coletivo. O objetivo é integrar as experiências vividas em casa ao ambiente escolar, promovendo o protagonismo do estudante e o reconhecimento das vivências familiares como parte importante do processo de aprendizagem.
A atividade propicia a integração com Língua Portuguesa, ao propor o trabalho com o gênero textual receita.
ENCAMINHAMENTO
Propor à turma uma leitura compartilhada, alternando os leitores para incentivar a participação de todos e favorecer o envolvimento e a compreensão coletiva. As atividades de leitura e compreensão do texto contribuem para o desenvolvimento da habilidade de Língua Portuguesa indicada a seguir.
• EF35LP26 : Ler e compreender, com certa autonomia, narrativas ficcionais que apresentem cenários e personagens, observando os elementos da estrutura narrativa: enredo, tempo, espaço, personagens, narrador e a construção do discurso indireto e discurso direto.
Organizar um tempo e um espaço adequados para que os estudantes realizem, de forma individual, as atividades propostas. Essa etapa favorece o desenvolvimento da autonomia na resolução das tarefas.
O texto introduz o tema do mundo microscópico por meio de uma situação cotidiana próxima dos estudantes. Embora não mencione diretamente os microrganismos, desperta a curiosidade para a observação de seres vivos e de suas partes com instrumentos que ampliam as imagens, como as lupas, estimulando o interesse pela continuidade do estudo.
SERES VIVOS MICROSCÓPICOS
Você já observou seres vivos muito pequenos? Leia atentamente a história de Arthur. Em seguida, responda às questões.
O mundo microscópico de Arthur — Arthur, pare de mexer nestas formigas! Isto não é brincadeira! Elas vão te picar e depois você vai chorar! Dona Isabela, mãe de Arthur, chamava sua atenção, enquanto ele atrapalhava o carreiro de minúsculas formigas rumo ao açucareiro da cozinha. — Veja, mãe! Como estas formigas são tão pequenas! Mal dá para a gente enxergá-las!
[…]
Arthur pegou a lupa de sua avó e observou uma formiguinha a caminho do açucareiro bem de perto. Ela é tão pequeninha, mas tem tudo o que uma formiga grande tem – antenas, cabeça, olhos, pernas, corpo. Que legal! No jardim da casa ele pode descobrir formigas carregando pedaços de folhas para um buraco na terra.
[...]
Assim, no próprio jardim de sua casa, Arthur descobriu um mundo de belezas que ele nunca imaginara: — Nossa! Como tem muitas coisas bonitas quando a gente chega mais perto para ver! Eu não fazia a menor ideia disto! É um novo mundo bem aqui no chão!
[...]
COSTA, João José da. O mundo microscópico de Arthur. [S. l.: s. n.], 2017. Disponível em: https://literaturaeducativa.com.br/download/.juvenil/81-seven-o-mundo -microscopico-de-arthur.pdf. Acesso em: 8 maio 2025.
Representação das formigas observadas por Arthur.
1. Considerando as atitudes de Arthur na história, qual dessas palavras representa melhor sua personalidade: esquecido, curioso ou distraído? Justifique.
2. No texto, Arthur usa a lupa para observar seres vivos pequenos. Você conhece outro instrumento que pode ser usado para observar seres vivos menores ainda do que as formigas?
3. Você conhece algum ser vivo que só pode ser visto com a ajuda desse instrumento? Onde ele pode ser encontrado?
| ORIENTAÇÕES E RESPOSTAS
1. Pode-se concluir que Arthur é curioso, pois ele observa atentamente as formigas e usa a lupa para fazer novas observações.
2. Resposta pessoal. É possível que os estudantes citem o microscópio. Não é necessário que eles já saibam que os microscópios possibilitam a observação de imagens ampliadas, permitindo visualizar em detalhes seres vivos, objetos e materiais muito pequenos, ou mesmo que não podem ser vistos a
olho nu. Utilizar esse questionamento para verificar os conhecimentos prévios deles.
3. Respostas pessoais. Os estudantes podem mencionar microrganismos de forma geral. Considerar o termo popular micróbios. Observar se surgem respostas mais específicas, como bactérias, que muitos já podem conhecer. Ainda não se espera que eles saibam que os microrganismos estão presentes nos mais diversos ambientes da Terra, mas é importante que comecem a pensar sobre o assunto.
NÃO ESCREVA NO LIVRO.
IMAGENS FORA DE PROPORÇÃO.
AS CORES NÃO SÃO REAIS.
Consultar orientações e respostas no Livro do Professor.
MICROSCÓPIOS:
REVELANDO O QUE ESTÁ ESCONDIDO
Observe a imagem. Ela reproduz um desenho feito pelo cientista inglês Robert Hooke (1635-1703), publicado em 1665.

Reprodução de ilustração de pulga feita por Robert Hooke, publicada em 1665 na obra Micrographia, de sua autoria.
Resposta pessoal. Espera-se que os estudantes percebam que a pulga é um animal muito pequeno, não sendo possível observar tantos detalhes de seu corpo a olho nu sem o auxílio de algum equipamento, como a lupa ou o microscópio.
DIALOGANDO
Uma pulga tem aproximadamente 2 milímetros de comprimento. Em duplas, verifiquem essa medida em uma régua. Depois, respondam: Como vocês acham que o cientista conseguiu desenhar tantos detalhes da pulga?
Os seres vivos apresentam diferentes tamanhos. Alguns são pequenos, como a formiga e a pulga. Mesmo que não seja possível observar todos os seus detalhes a olho nu, ainda conseguimos enxergar esses animais sem a ajuda de equipamentos. Contudo, existem organismos tão pequenos que, em geral, são invisíveis aos olhos dos seres humanos. Eles são chamados de microrganismos. As bactérias, os protozoários e alguns fungos e algas são exemplos desses seres que só podem ser observados com o uso de microscópios. Esses aparelhos permitem ampliar imagens tanto de seres vivos quanto de objetos minúsculos.
Diversos cientistas colaboraram para o desenvolvimento do microscópio. No século XVII, Robert Hooke construiu um modelo e o utilizou para estudar diferentes materiais e seres vivos, como a pulga.
Microscópio projetado e usado por Robert Hooke para muitas observações que fizeram parte da obra Micrographia (1665). Ele faz parte do acervo do Museu Nacional de Saúde e Medicina, em Maryland, nos Estados Unidos.
ENCAMINHAMENTO
A atividade proposta no boxe Dialogando possibilita o exercício da curiosidade intelectual, contribuindo para o desenvolvimento da competência geral 2. Orientar os estudantes a se organizarem em duplas para realizar a atividade. Em parceria, eles poderão compartilhar suas percepções iniciais e trocar ideias.
Após a conclusão da atividade, pedir às duplas que apresentem suas respostas para a turma, promovendo uma discussão coletiva.

02/10/25 15:49
Aproveitar a oportunidade para destacar que, embora o uso dos microscópios seja frequentemente associado à observação de microrganismos, esses instrumentos também permitem visualizar, com riqueza de detalhes, estruturas pequenas que são visíveis a olho nu, como é o caso da pulga. Outras aplicações dos microscópios incluem a observação de células e de tecidos de seres vivos, ou mesmo de materiais diversos, como fibras têxteis e partículas de solo.
Ao abordar o que são microrganismos, destacar que alguns deles formam
estruturas ou se agrupam de tal forma que podem ser vistos a olho nu. Alguns exemplos são os fungos que formam o mofo do pão, as colônias de bactérias que podem crescer em placas de Petri e mesmo algas macroscópicas. Alguns desses casos serão apresentados posteriormente.
| PARA O PROFESSOR
SITE . ARTIS-MICROPIA. Disponível em: https:// www.artis.nl/en/artis-mi cropia/featured-at-artis -micropia. Acesso em: 4 ago. 2025.
Museu de ciências interativo. Embora o conteúdo esteja em língua inglesa, alguns navegadores possibilitam a tradução automática para a língua portuguesa. Verificar as configurações de seu navegador e buscar a opção “Traduzir”.
TEXTO . VIEIRA, Fabiana Silva. Introdução à Microscopia. São Cristóvão: Universidade Federal de Sergipe – CESAD, 2008. Disponível em: https:// cesad.ufs.br/ORBI/ public/uploadCatala go/16525916022012In troducao_a_Microscopia_ Aula_1.pdf. Acesso em: 4 ago. 2025.
Manual que apresenta aspectos históricos relacionados ao processo de invenção do microscópio e detalha o funcionamento dos diferentes tipos existentes.
ENCAMINHAMENTO
Ao trabalhar os conteúdos relacionados à observação do mundo invisível a olho nu, é fundamental que os estudantes compreendam a importância dos instrumentos que tornaram esse conhecimento possível: os microscópios. Ao longo do tempo, os microscópios evoluíram significativamente, tanto em termos de estrutura quanto de capacidade de ampliação. Atualmente existem microscópios de luz (ópticos), que permitem ampliar imagens em até 1 000 vezes, possibilitando visualizar células inteiras e alguns detalhes de seus componentes. Já os microscópios eletrônicos têm capacidade de ampliação muito maior, podendo ultrapassar 1 000 000 de vezes, dependendo do tipo, o que permite visualizar vírus, organelas e componentes intracelulares com elevado grau de detalhamento. Esses avanços tecnológicos foram fundamentais para o desenvolvimento da ciência, especialmente nas áreas da Biologia, da Química e da Medicina. Por isso, é importante proporcionar aos estudantes uma visão histórica e contextualizada desses instrumentos. O trabalho com esse assunto promove o desenvolvimento da competência geral 1 e da competência específica 1 de Ciências da Natureza Destacar que a fotografia presente na página mostra um menino manipulando um microscópio óptico. No entanto, algumas imagens dos microrganismos e a imagem dos vírus apresentadas ao longo do capítulo foram obtidas por microscopia eletrônica. Caso seja pertinente, explicar aos estudantes as diferenças entre esses dois tipos de microscópio, apontando suas aplicações e capacidades de ampliação.
Como sugerido no boxe Para você explorar, uma boa estratégia é levar os
Outro cientista importante no desenvolvimento dos microscópios foi o construtor de lentes holandês Antonie van Leeuwenhoek (1632-1723). Em 1674, ele construiu um microscópio com o qual observou pela primeira vez microrganismos vivos. Esse feito o tornou reconhecido como uma figura importante para a Microbiologia, área da ciência que estuda os microrganismos.
Ao longo do tempo, os microscópios foram sendo aperfeiçoados, permitindo observar estruturas cada vez menores. Com isso, os cientistas descobriram que os microrganismos estão presentes nos mais variados ambientes da Terra, como no solo, na água dos rios e oceanos, no ar e até no interior de outros seres vivos.
Conheça a seguir um tipo de microscópio, chamado microscópio de luz, e algumas de suas partes.
Conjunto de lentes: ampliam com diferentes aumentos a imagem.
Mesa: onde se coloca a lâmina de vidro com a amostra (microrganismos) a ser observada.
Lâmpada: emite a luz que atravessa a amostra e permite observá-la.
Exemplo de microscópio com indicação de suas principais partes e funções.
PARA VOCÊ EXPLORAR

Que tal conhecer melhor os microscópios? Converse com o professor sobre a possibilidade de visitar o laboratório da escola ou outro local que tenha esse equipamento. O professor pode verificar se há uma universidade, um instituto de pesquisa ou um laboratório que possa receber a turma.
estudantes ao laboratório da escola para apresentar a estrutura do microscópio de luz, quando disponível, e possibilitar a observação de algumas amostras. Orientá-los sobre comportamentos e vestimentas adequadas nesse ambiente, garantindo a segurança deles. Caso a escola não disponha desse recurso, pode-se organizar uma visita a uma instituição que tenha o equipamento, onde um profissional especializado pode conduzir a exploração do instrumento e aprofundar explicações sobre ele. Nessa visita, além de planejamento, autorizações, segurança, logística, vestimentas apropriadas e supervisão da
equipe escolar, é importante orientar a turma sobre comportamentos adequados no local visitado. Outra possibilidade é convidar à escola um pesquisador que possa levar um microscópio para a manipulação dos estudantes. Para isso, é necessário providenciar, por exemplo, um espaço adequado e materiais de apoio. Esse profissional poderá compartilhar sua rotina de trabalho, contribuindo, assim, para as escolhas dos projetos de vida dos estudantes, conforme previsto na competência geral 6. Oriente-os a escutar o profissional com atenção e respeito.
BACTÉRIAS
As bactérias são microrganismos que podem ser encontrados em quase todos os ambientes do planeta Terra, sejam eles aquáticos ou terrestres. Elas também podem viver no corpo de outros seres vivos, como plantas e animais, incluindo os seres humanos.
No entanto, em situações de desequilíbrio, espécies patogênicas podem se multiplicar e provocar infecções.
Microrganismos que provocam doenças são chamados de patogênicos. Algumas bactérias podem ser patogênicas. Porém, boa parte das bactérias não causa danos a outros seres vivos. Pelo contrário: muitas delas podem ser benéficas. Por exemplo, existe um número enorme de bactérias que vivem naturalmente no intestino humano e fazem parte da microbiota, ou seja, do conjunto de microrganismos que vivem no corpo humano. Essas bactérias contribuem para o bom funcionamento do organismo, podendo atuar, por exemplo, na digestão de certos alimentos.
Bactérias que podem ser encontradas no intestino humano, auxiliando na obtenção de nutrientes (aumento aproximado de 2 400 vezes e coloração artificial).


Benéficas: que fazem bem.
Bactérias que podem ser encontradas no solo e no interior de seres vivos (aumento aproximado de 2 300 vezes e coloração artificial).

Bactérias que podem ser encontradas em diversos ambientes, inclusive sobre a casca de frutas (aumento aproximado de 3 200 vezes e coloração artificial).

de algumas bactérias que vivem no ambiente e no corpo humano.
PARA VOCÊ EXPLORAR
Os sites indicados nesta obra podem apresentar imagens e eventuais textos publicitários junto ao conteúdo de referência, os quais não condizem com o objetivo didático da coleção. Não há controle sobre esses conteúdos, pois eles estão estritamente relacionados ao histórico de pesquisa de cada usuário e à dinâmica dos meios digitais.
• SÃO PEDRO, Vinícius. Micróbios do bem. Ciência Hoje das Crianças, ed. 308, 6 mar. 2020. Disponível em: https://chc.org.br/artigo/microbios-do-bem/.
Acesso em: 19 ago. 2025.
Com a ajuda de um adulto, acesse e leia o texto sobre a microbiota que existe no corpo humano.
ENCAMINHAMENTO
Ao trabalhar o tópico Bactérias em sala de aula, é essencial ampliar a compreensão dos estudantes, mostrando que elas não são apenas agentes de doenças.
As bactérias são microrganismos procariontes, ou seja, não apresentam núcleo delimitado por membranas nem estruturas membranosas em seu interior, e estão entre as formas de vida mais antigas e abundantes do planeta.
Embora se estime a existência de trilhões de espécies, apenas cerca de 30 mil
foram identificadas até hoje, o que revela a vastidão e complexidade desse universo microscópico.
02/10/25 15:49
Muitas bactérias convivem em equilíbrio com o organismo humano, compondo a microbiota presente na pele, na boca, no intestino e em outros órgãos. No intestino, por exemplo, auxiliam na digestão, na produção de vitaminas e no fortalecimento do sistema imunitário.
Explicar que, quando a microbiota está em equilíbrio, os microrganismos que a compõem – como bactérias, fungos e protozoários – não causam danos ao corpo.
Se julgar oportuno, exibir, em sala de aula, trechos do vídeo indicado em Para o professor, a seguir, visando ampliar a compreensão dos estudantes sobre a importância dos microrganismos para o corpo humano e estimular discussões sobre hábitos de vida saudáveis que ajudam a manter a microbiota equilibrada. Após a exibição, promover uma roda de conversa ou propor aos estudantes que escrevam uma breve reflexão sobre algo novo que aprenderam com o vídeo.
| PARA O PROFESSOR
SITE. MUSEU DO MICROSCÓPIO. Disponível em: https://www.museudomi croscopio.eu/microscopes pertype.html. Acesso em: 4 ago. 2025.
Site do Museu do Microscópio, que apresenta uma coleção virtual de diversos tipos de microscópio criados ao longo da história, com descrições e imagens detalhadas.
VÍDEO . DA IMUNIDADE à mente: a importância dos micróbios intestinais. 2022. 1 vídeo (11 min 17 s). Publicado pelo canal BBC News Brasil. Disponível em: https://www.you tube.com/watch?v=d2TZ Nhz2KHo&t. Acesso em: 4 ago. 2025.
Vídeo que explica como a microbiota intestinal contribui para aspectos essenciais da saúde.
Exemplos
ENCAMINHAMENTO
Ao abordar o tópico Protozoários, destacar que, embora alguns possam causar doenças, muitos deles são importantes para o equilíbrio ecológico e fazem parte da microbiota de diversos animais, inclusive do ser humano, contribuindo para processos como a digestão.
Comentar com os estudantes que os cupins, por exemplo, só conseguem digerir celulose – substância presente na madeira – graças à presença de protozoários em seu intestino, os quais realizam esse processo por meio de uma relação simbiótica.
Ao iniciar o tópico Fungos, mencionar que, embora muitos sejam visíveis, eles ainda são considerados microrganismos. Isso ocorre porque essa classificação considera as características de parte significativa do grupo, especialmente aquelas relacionadas à sua estrutura e ao ciclo de vida. Muitos fungos são unicelulares, como as leveduras utilizadas na produção de pães e bebidas fermentadas, e só podem ser observados com o auxílio de um microscópio. Além disso, mesmo os fungos pluricelulares, como os bolores, iniciam seu desenvolvimento a partir de estruturas microscópicas, como os esporos. Ainda que não seja necessário detalhar isso tudo aos estudantes nesse momento, essa perspectiva é importante para que compreendam que a classificação não se baseia apenas na aparência final do organismo, mas também em aspectos microscópicos fundamentais para seu funcionamento e sua reprodução.
PROTOZOÁRIOS
Os protozoários também são microrganismos. Eles podem ser encontrados, em sua maioria, em ambientes aquáticos, como mares, rios e lagos. Parte deles também habita solos úmidos.
Alguns protozoários podem viver no corpo de outros seres vivos, trazendo benefícios a eles. Um exemplo é o protozoário que vive no interior do intestino de cupins e auxilia na digestão de alimentos ingeridos por esses animais. Mas também existem protozoários patogênicos.

FUNGOS
Cupim, com destaque para o protozoário (aumento aproximado de 180 vezes) que vive no interior do intestino dele.

Os fungos também são exemplos de microrganismos e podem ser encontrados em diversos ambientes, como no solo, no ar, na água e no interior de outros seres vivos. Alguns são benéficos, como aqueles que ajudam as plantas a absorver melhor os nutrientes do solo, favorecendo seu crescimento. Outros, no entanto, podem ser patogênicos.


Ao discutir com os estudantes o papel dos fungos no ambiente, destacar as micorrizas, que são associações entre fungos e raízes de plantas. Explicar que essa relação é benéfica para ambos os organismos: o fungo ajuda a planta a absorver água e nutrientes do solo, enquanto recebe dela substâncias orgânicas como alimento. Essa interação é fundamental para o desenvolvimento saudável de muitas espécies vegetais.
| PARA O PROFESSOR
Solo, com destaque para um fungo microscópico (aumento aproximado de 920 vezes e coloração artificial). Esse microrganismo ajuda a decompor restos de animais e vegetais.
SITE. MUSEUS acessíveis. Parque da Ciência, São Paulo, [20--?]. Disponível em: https://parquedaciencia.butantan.gov. br/museus-acessiveis. Acesso em: 4 ago. 2025.
Site que apresenta alguns museus brasileiros que são equipados com recursos acessíveis. Um deles é o Museu de Microbiologia.
Parte dos fungos são microscópicos, como as leveduras, presentes no fermento biológico. O fermento é um ingrediente utilizado no preparo de pães e bolos. Contudo, alguns fungos podem ser vistos a olho nu, como os cogumelos.
Leveduras, fungos que compõem o fermento biológico usado na produção de muitos alimentos (aumento aproximado de 6 000 vezes e coloração artificial).
VOCÊ LEITOR!

O maior ser vivo da Terra
[…]
Nem elefantes, nem baleias azuis, os maiores mamíferos do mundo. O maior organismo vivo descoberto pela Ciência tem um tamanho equivalente a 1 665 campos de futebol e habita uma cadeia de montanhas dos Estados Unidos. […]

Aglomerado de cogumelo-do-mel, que é do mesmo tipo do maior ser vivo do mundo. A maior parte desse ser vivo está espalhada embaixo do solo.
[…] Descoberto na região em 1998 […], o fungo é conectado em todo o espaço que ocupa, descreveram os pesquisadores […].
[…] o fungo se desenvolve sob o solo, nas raízes das árvores, das quais se aproveita de água e nutrientes. Sobre a terra, emerge em formato de pequenos cogumelos.
[…]
MAIOR organismo vivo do mundo tem o tamanho de 1,6 mil campos de futebol, aponta pesquisa. Terra, São Paulo, 26 jun. 2024. Disponível em: https://www. terra.com.br/planeta/maior-organismo-vivo-do-mundo -tem-o-tamanho-de-16-mil-campos-de-futebol-aponta -pesquisa,e5670f7adbb708cfe06ccea6fb13092ckogpw5lf. html. Acesso em: 8 maio 2025.
arredondando para menos, tem o tamanho de cerca de 1 600 campos de futebol. Consultar orientações no Livro do Professor
1. Qual é o maior ser vivo do mundo? Um fungo.
nem sempre conseguimos ver a grandiosidade de um ser vivo a olho nu. Esse exemplo evidencia que, apesar de alguns fungos desenvolverem estruturas visíveis (como cogumelos), sua maior parte é microscópica, e é isso que justifica a classificação deles como microrganismos.
| ORIENTAÇÕES E RESPOSTA
2. A atividade possibilita um trabalho integrado com o componente curricular de Matemática ao abordar o arredondamento de números, ou seja, a aproximação de valores numéricos para facilitar a leitura, a interpretação e os cálculos. Verificar a disponibilidade do docente desse componente para explorar o conteúdo utilizando o exemplo do maior ser vivo do mundo, enriquecendo o aprendizado dos estudantes.
2. Se arredondarmos, qual é o tamanho do maior ser vivo do mundo: 600, 1 000 ou 1600 campos de futebol?
3. Qual trecho do texto mostra que esse ser vivo se relaciona com outros organismos?
2. O tamanho do maior ser vivo do mundo equivale a 1 665 campos de futebol. Portanto, 17
O trecho “o fungo se desenvolve sob o solo, nas raízes das árvores, das quais se aproveita de água e nutrientes”. Ele mostra a relação do fungo com as plantas, das quais retira componentes de que precisa para viver.
VOCÊ LEITOR!
Orientar os estudantes a se organizarem em grupos formados por três a quatro integrantes. Inicialmente, cada grupo deve realizar a leitura do texto e responder às atividades propostas, registrando as respostas no caderno. Em seguida, os grupos podem compartilhar suas compreensões e respostas com o restante da turma, promovendo a troca de ideias e o enriquecimento coletivo da aprendizagem. É possível utilizar os elementos do texto como ponto de partida para incentivar
o pensamento científico e o questionamento dos estudantes. Pergunte, por exemplo:
02/10/25 15:49
• Vocês imaginavam que o maior ser vivo do mundo fosse um fungo?
• Por que não conseguimos ver a verdadeira extensão desse fungo?
Diante desses questionamentos, chamar a atenção para o seguinte: mesmo sendo o maior ser vivo do mundo, grande parte desse fungo está no subsolo, composta de uma rede de hifas (estruturas microscópicas), o que mostra que
BOGDAN ONESCU/SHUTTERSTOCKCOM
NÃO ESCREVA NO LIVRO.
5 cm
THOMAS DEERINCK,NCMIR/SCIENCE PHOTO LIBRARY/FOTOARENA
Ao abordar o tópico Algas, explicar aos estudantes que existem espécies microscópicas e macroscópicas. As algas são organismos fotossintetizantes, ou seja, realizam a fotossíntese, processo que contribui significativamente para a produção de gás oxigênio na atmosfera. Se considerar pertinente, comentar que a fotossíntese também é realizada pelas plantas –tema que será explorado na próxima unidade.
No tópico Vírus, um caso à parte, mencionar que eles são extremamente pequenos e só podem ser visualizados com o auxílio de microscópios eletrônicos. Os vírus são significativamente menores que as bactérias. Além disso, apresentam uma estrutura simples, geralmente formada por um capsídeo proteico que envolve o material genético. Ou seja, não possuem estrutura celular.
Explicar também que os vírus são parasitas intracelulares obrigatórios, ou seja, não conseguem se reproduzir fora de um organismo vivo. Fora da célula, permanecem inertes e não realizam nenhuma atividade vital, como metabolismo, troca de gases ou reprodução. Eles só se multiplicam quando invadem células hospedeiras, utilizando a maquinaria dessas células para produzir novos vírus. Por isso e por não apresentarem metabolismo próprio nem outras características típicas da vida fora de um organismo hospedeiro, muitos cientistas não os consideram seres vivos.
Em contrapartida, há argumentos que os classificam como seres vivos, especialmente quando estão dentro de uma célula e são capazes de se reproduzir, sofrer mutações e evoluir – características de seres vivos.
ALGAS
As algas habitam principalmente ambientes aquáticos. Assim como as plantas, elas são importantes para o ambiente por diversos fatores, entre eles, por liberar gás oxigênio para o ambiente. Parte das algas é microscópica, mas algumas podem ser vistas a olho nu.


VÍRUS, UM CASO À PARTE
Os vírus vivem no interior de outros seres vivos. Eles são tão pequenos que podem viver até mesmo no interior de bactérias.
Devido a seu tamanho, eles não podem ser observados por microscópios comuns. Para observá-los, são utilizados microscópios específicos, que apresentam uma capacidade de ampliação muito maior, além de permitir a visualização de muito mais detalhes.
Os vírus têm estrutura simples e não são capazes de se reproduzir fora de um organismo vivo. Para se multiplicar e realizar suas atividades, eles precisam estar dentro de um ser vivo, como uma planta ou um animal. Por esses e outros motivos, muitos cientistas não consideram os vírus como seres vivos. Alguns vírus podem causar doenças, inclusive nos seres humanos.
Vírus causadores de gripe vistos ao microscópio (aumento aproximado de 220 000 vezes e coloração artificial).
ATIVIDADES
Definir o que é vida, ou seja, o que é um ser vivo, não é uma tarefa simples. Diversos cientistas já criaram critérios para isso. Segundo um desses critérios, por exemplo, os seres vivos precisam ser capazes de se reproduzir. Propor aos estudantes que se organizem em duplas e selecionem critérios para definir o que é vida. Pedir a eles que expliquem os critérios selecionados para os demais colegas. Sugestões de critérios: precisa crescer ou mudar com o tempo; reagir ao ambiente; se alimentar; se reproduzir.

Alface-do-mar em Florianópolis, Santa Catarina, 2023. Essa alga pode ser vista a olho nu e é comum no litoral brasileiro.
Algas verdes microscópicas (aumento aproximado de 720 vezes).
ATIVIDADES
1. Microrganismos são seres vivos tão pequenos que não podemos enxergá-los sem o auxílio de instrumentos especiais que possibilitem a ampliação de imagens, como os microscópios. Os microrganismos podem ser encontrados em praticamente todos os locais do planeta Terra, como o solo, a água, o ar e o corpo de outros seres vivos.
1. O que são microrganismos e onde podem ser encontrados?
2. Quais microrganismos você estudou nesse capítulo?
Bactérias, protozoários, fungos e algas.
3. Antes mesmo de começar a chover, é possível sentir um “cheiro de chuva” característico. Esse cheiro vem de um óleo liberado por algumas plantas e de substâncias produzidas por bactérias. Quando a chuva cai no solo, as bactérias ajudam a espalhar essas substâncias pelo ar, o que nos permite sentir o cheiro.
a) Quais microrganismos produzem uma substância relacionada ao cheiro característico da chuva? As bactérias.
b) Em que outros ambientes é possível encontrar outros microrganismos desse tipo?
Além do solo, as bactérias podem ser encontradas na água, no ar e no interior de outros seres vivos, como no intestino dos humanos.
4. Diversos personagens de jogos e de desenhos animados foram inspirados em componentes da natureza. Por exemplo, em um famoso jogo de videogame há um personagem chamado Toad. Ele tem a função de ajudar o personagem principal, que é um encanador, dando dicas e participando das aventuras.
a) O personagem Toad foi inspirado no ser vivo que aparece na fotografia a seguir. Que ser vivo é esse?
4. b) Um exemplo são as leveduras, que também são fungos, porém são microscópicos.

Cogumelo Amanita sp., também conhecido como mata-moscas. Esse cogumelo é venenoso e, por isso, não deve ser tocado.
b) Existem seres vivos do grupo ao qual pertence o cogumelo que só podemos observar ao microscópio. Cite um exemplo.
c) Crie um personagem para um jogo, filme ou desenho que se baseie em algum microrganismo, que pode ser patogênico ou benéfico para os seres vivos. Se necessário, com o auxílio de um adulto da família, pesquise em livros ou na internet as características desse ser vivo. Em seguida, desenhe-o no caderno e escreva um pequeno texto sobre suas principais características. Por exemplo, se ele é um herói, um vilão, se tem alguma habilidade especial, como ser elástico ou muito forte. Use sua criatividade! Resposta pessoal. Incentivar os estudantes a desenhar e escrever as características do personagem se inspirando no que aprendeu
| ORIENTAÇÕES E RESPOSTAS
3. A atividade aborda como o cheiro característico da chuva é causado por uma combinação de fatores. Durante períodos de seca, algumas plantas liberam óleos que se acumulam no solo e são liberados quando as gotas da chuva tocam o solo. Além disso, pequenas bolhas de ar se formam e liberam substâncias produzidas por bactérias do solo. Uma delas é chamada geosmina, responsável pelo cheiro de “terra molhada”.
Se considerar pertinente, comentar que o cheiro da chuva pode variar dependendo
os estudantes: nunca se deve tocar ou consumir cogumelos encontrados na natureza, pois muitos deles podem representar sérios riscos à saúde.
03/10/25 20:50
do local e das condições do solo e do ar. Por exemplo, em áreas urbanas, onde pode haver alta concentração de poluentes, a água da chuva pode reagir com essas substâncias e gerar odores menos agradáveis.
4. Nesta atividade, há a fotografia do cogumelo Amanita sp. Esse, assim como outros tipos de fungos, é altamente tóxico. Se ingerido, pode causar sintomas como tontura, vômitos, espasmos musculares e movimentos compulsivos. Em casos mais graves, a intoxicação pode levar à morte. Com base nesse exemplo, alertar
NÃO ESCREVA NO LIVRO.
Consultar orientações no Livro do Professor
Consultar orientações no Livro do Professor.
Cogumelo Amanita sp., um fungo.
VOCÊ CIENTISTA!
Com esta atividade, objetiva-se construir, com materiais de fácil acesso, um aparato que funciona como um microscópio e observar microrganismos com esse aparato. A proposta, bem como as atividades presentes ao final da seção, favorecem o pensamento científico, contribuindo para o desenvolvimento da competência geral 2 e da competência específica 2 de Ciências da Natureza.
Ao planejar esta atividade, escolher um local que possa ser mantido escuro, pois a presença de luz ambiente pode dificultar a observação dos efeitos esperados com o uso da ponteira a laser
Verificar a potência da ponteira a laser antes da atividade. Algumas possuem potência inferior a 1 mW, o que pode ser insuficiente para a realização do experimento. Recomenda-se o uso de ponteiras com potência entre 1 mW e, no máximo, 5 mW. Modelos com potência superior a 5 mW não devem ser utilizados, por questões de segurança.
É fundamental orientar os estudantes sobre o uso responsável da ponteira a laser. Apesar de muitos modelos estarem dentro dos padrões de segurança estabelecidos pelo Instituto Nacional de Metrologia, Qualidade e Tecnologia (Inmetro), o manuseio incorreto pode representar riscos. Um estudo do Inmetro indicou que cerca de 75% das ponteiras avaliadas estão em conformidade com os critérios de segurança, mas isso não elimina a necessidade de supervisão e orientação constantes. Esses dispositivos são facilmente encontrados em papelarias
Microscópio de gota de água
Vocês acham possível observar seres microscópicos sem ter um microscópio? Como vocês poderiam fazer para enxergar esses seres vivos? Em pequenos grupos, realizem a atividade prática a seguir para conhecer uma forma.
DO QUE EU PRECISO
• Copo com água
• Fermento biológico fresco
• Colher (chá)
• Seringa descartável, sem a agulha
• Pedaço de papelão
COMO FAZER
• Régua
• Tesoura com pontas arredondadas
• Ponteira laser
• 2 prendedores de roupa
• Elástico
1. Adicionem 1 2 colher (chá) de fermento biológico ao copo com água e misturem bem.
2. Com a seringa, puxem uma pequena quantidade dessa mistura.
3. Peçam a um adulto que recorte um pedaço de papelão com 10 centímetros de largura e 20 centímetros de comprimento. Depois, peçam a ele que faça um furo no centro do papelão e o dobre em duas partes para formar um suporte.
O uso de objetos cortantes pode causar ferimentos. Tenham cuidado. A etapa 3 deve ser realizada por um adulto.
Representação da produção do suporte de papelão (etapa 3).
ou lojas de artigos eletrônicos, mas a escolha deve sempre priorizar a segurança.
Não permitir que os estudantes manuseiem a ponteira a laser de forma inadequada ou usem o equipamento para brincadeiras. Alertar para os riscos do uso indevido, como apontar o laser para os olhos de pessoas ou para aviões, prática perigosa e proibida por lei. Reforçar também a importância do cuidado ao manipular objetos cortantes e perfurantes. Realizar as etapas de corte e furo do papelão para os estudantes.

Sugere-se que o aparato seja montado em parceria com estudantes voluntários, orientando-os a seguir os procedimentos listados no livro. Contudo, ajustes podem ser necessários. Por exemplo, no procedimento 7, possivelmente será preciso ajustar a posição do laser e a distância em relação à gota de água até obter uma imagem ampliada na parede.
A turma pode observar e analisar a imagem ampliada. Para realizar as atividades propostas na seção Vamos conversar?, sugere-se organizar os estudantes em grupos de cinco integrantes. Os
Dobre aqui.
O adulto deve furar aqui.
IMAGENS FORA DE PROPORÇÃO AS CORES NÃO SÃO REAIS
4. Insiram a seringa no suporte, deixando o bico voltado para baixo. Depois, apertem o êmbolo da seringa, delicadamente, até formar uma gota na ponta da seringa. Se necessário, peçam a ajuda de um adulto.
5. Prendam o elástico no botão do laser, para que ele fique ligado continuamente.
6. Utilizem os prendedores de roupa para apoiar o laser e o posicionem a 3 centímetros
de distância da seringa.

Representação da organização da seringa no suporte de papelão (etapa 4).
7. Apaguem a luz e ajustem a posição do laser, cuidadosamente, até que ele atravesse a gota de água e atinja a parede. Se necessário, peçam a ajuda de um adulto.
ATENÇÃO!
O laser deve ser manipulado com cuidado. Nunca o apontem para os olhos.
Representação da montagem final (etapa 7).
VAMOS CONVERSAR?
3. Respostas pessoais. Espera-se que os estudantes digam que o resultado não seria o mesmo, pois, por exemplo, a água de um rio contém outros tipos de microrganismos, diferentes das leveduras presentes no fermento biológico. Assim, é provável que observassem organismos distintos, dependendo da composição da água coletada. Consultar orientações no Livro do Professor
1. Qual microrganismo vocês possivelmente visualizaram durante o experimento? Fungos (leveduras), presentes no fermento biológico.
2. Um microscópio simples, ou de luz, é composto de lâmpada, mesa e lentes de aumento. A gota de água, nesse experimento, corresponderia a qual desses componentes? Por quê?
A gota de água corresponde à lente de aumento, pois, quando o laser incide sobre ela, possibilita a formação de imagens ampliadas.
3. Se, em vez da mistura de água com fermento biológico, vocês usassem a água de uma poça formada pela chuva, por exemplo, o que esperariam observar? O resultado seria o mesmo? Justifiquem.
4. Depois de realizar a atividade, o que vocês descobriram sobre a possibilidade de observar seres microscópicos sem usar um microscópio? Isso mudou a resposta que vocês deram à pergunta inicial? Expliquem.
Respostas pessoais. Espera-se que os estudantes reflitam sobre a atividade ter permitido observar seres vivos microscópicos por meio de uma gota de água e um feixe de luz, reconhecendo que existem outras formas de ampliar imagens além do microscópio tradicional.
grupos poderão debater o que observaram e elaborar em conjunto suas respostas, estimulando a cooperação. Após esse momento, organizar a turma em uma roda, promovendo uma conversa coletiva sobre os resultados. Incentivar a participação de todos os estudantes, garantindo que possam expor seus pontos de vista.
| PARA O PROFESSOR
03/10/25 20:57
TEXTO. INSTITUTO NACIONAL DE METROLOGIA, QUALIDADE E TECNOLOGIA. Relatório da análise de apontadores a laser. Brasília, DF: Inmetro, 2014. Disponível em: http://www.inmetro.gov.br/ consumidor/produtos/relatorio_canetas_ laser.pdf. Acesso em: 4 ago. 2025. Relatório técnico, publicado pelo Inmetro, que traz informações sobre os padrões de segurança das ponteiras a laser.
3. Caso os estudantes queiram realizar essa variação da atividade, a coleta da água deve ser feita exclusivamente pelo professor, a fim de garantir a segurança de todos. É importante certificar-se de que a coleta seja feita em uma poça de água que tenha sido formada em um local livre de contaminações. Após a coleta, levar a amostra à sala de aula ou ao laboratório, para que seja utilizada nos testes. Durante todo o processo, utilizar luvas de proteção e reforçar aos estudantes a importância de não manusearem a seringa nem a amostra de água.
ATIVIDADES
Se julgar oportuno, orientar os grupos a registrar, por meio de desenhos e legendas, o que aprenderam sobre os microrganismos observados e discutidos durante a atividade prática. Para esta atividade, serão necessários os seguintes materiais: folhas de papel sulfite ou cartolina (uma por estudante), lápis de cor, giz de cera, canetinhas coloridas, lápis e borracha, régua e fitas adesivas. Caso seja possível, os desenhos podem compor um mural coletivo, com um título sugerido pela turma.
Além de promover a expressão criativa, os desenhos produzidos pelos estudantes podem servir de instrumento complementar no processo de avaliação da aprendizagem.
IMAGENS FORA DE PROPORÇÃO
ORES NÃO SÃO REAIS
elástico
ALEX ARGOZINO
ALEX ARGOZINO
ENCAMINHAMENTO
Explicar a diferença entre a mandioca-mansa e a mandioca-brava. A mandioca-mansa apresenta baixo teor de ácido cianídrico e pode ser consumida após o cozimento. Já a mandioca-brava é tóxica e exige preparo adequado para seu consumo seguro. A técnica descrita no esquema é usada com a mandioca-brava e faz parte do saber ancestral de diversos povos indígenas da Amazônia. Eles realizam a fermentação natural e a prensagem no tipiti para reduzir a toxicidade da raiz. O líquido extraído pode ser usado para produzir farinha, e a massa é usada para fazer farinha, beiju ou tapioca.
Esse exemplo mostra como os saberes tradicionais se relacionam com conceitos científicos, como o papel dos microrganismos na fermentação. Aproveitar esse contexto e promover uma reflexão sobre o valor do conhecimento indígena. A valorização de saberes e vivências culturais possibilita o trabalho com o Tema Contemporâneo Transversal (TCT) Diversidade cultural, além de contribuir para o desenvolvimento de parte da competência geral 6
| ORIENTAÇÕES E RESPOSTA
3. Resposta pessoal. É possível que os estudantes citem o iogurte como exemplo; no entanto, avaliar as respostas conforme o conhecimento que eles têm sobre o assunto.
TEXTO
DE APOIO
[...] os indígenas brasileiros preparavam bebidas fermentadas de milho, mandioca e frutas nativas há séculos. As técnicas de
DIFERENTES APLICAÇÕES DOS
MICRORGANISMOS
Conheça como alguns povos indígenas da Amazônia utilizam a ação de microrganismos para produzir alguns alimentos a partir da mandioca.

A. Após a colheita, a mandioca é deixada durante a noite nas águas de um riacho. Nesse período, microrganismos agem sobre a mandioca e ajudam a reduzir substâncias prejudiciais ao organismo (tóxicas) presentes nesse alimento.
B. A mandioca é descascada, ralada e espremida. Desse processo se obtêm um líquido amarelado e uma massa.
C. O líquido é deixado ao Sol para que os microrganismos continuem agindo. Depois, ele é fervido e se transforma em tucupi, um ingrediente muito utilizado para o preparo de caldos, sopas e molhos.
D. A massa é torrada para fazer a farinha de mandioca.
Representação da fabricação de produtos a partir da mandioca, com a participação de microrganismos, por indígenas da Amazônia.
Elaborada com base em: ALIMENTAÇÃO. Povos Indígenas do Brasil Mirim, [s. l.], c2025. Disponível em: https://mirim.org/pt-br/como-vivem/alimentacao. Acesso em: 8 maio 2025.
1. Os microrganismos realizam um processo que ajuda a remover substâncias tóxicas da mandioca.
1. Qual é a importância dos microrganismos para o consumo seguro dos produtos da mandioca?
LIVRO.
2. Foram descritas diferentes etapas do aproveitamento da mandioca pelos indígenas. De quais etapas os microrganismos fazem parte?
3. Você conhece outros alimentos que são produzidos pela ação de microrganismos?
Consultar orientações e resposta no Livro do Professor.
2. Os microrganismos fazem parte da etapa em que a mandioca, após ser colhida, é deixada na água de um riacho, auxiliando na remoção de substâncias tóxicas e no preparo do tucupi.
fermentação variavam, [...] de acordo com as regiões e os ingredientes, podendo utilizar enzimas da saliva ou leveduras espontâneas.
Na África, [...] bebidas fermentadas eram feitas à base de cereais, seivas de palmeiras e frutas. Posteriormente, povos como os Ovimbundu, do sul de Angola, passaram a usar produtos da América como o milho e o abacaxi. [...]
OLIVEIRA, Paulo. O resgate do aluá. Meus Sertões, 5 set. 2019. Disponível em: https:// meussertoes.com.br/2019/09/05/o-resgate-do -alua/. Acesso em: 4 ago. 2025.
| PARA O PROFESSOR
TEXTO. SOENTGEN, Jens; HILBERT, Klaus. A química dos povos indígenas da América do Sul. Química Nova, v. 39, n. 9, p. 1141-1150, 2016. Disponível em: https:// doi.org/10.21577/0100-4042.20160143. Acesso em: 16 ago. 2025.
Artigo que descreve as etapas de processamento da mandioca, realizado por povos indígenas da Amazônia.
NÃO ESCREVA NO
IMAGENS FORA DE PROPORÇÃO.
AS CORES NÃO SÃO REAIS.
MICRORGANISMOS E ALIMENTOS
Os microrganismos podem ser aplicados em diferentes processos envolvendo alimentos. Um exemplo é a produção de queijos, iogurtes e pães.
Para que alguns desses alimentos sejam produzidos, os microrganismos fazem um processo chamado fermentação. Nesse processo, eles consomem certos ingredientes dos alimentos, como os açúcares. Então, produzem novas substâncias, que podem dar sabor, cheiro ou texturas diferentes aos alimentos.
Os iogurtes, por exemplo, são produzidos pela fermentação realizada por bactérias chamadas lactobacilos. Essas bactérias também auxiliam nos processos que ocorrem no intestino humano, relacionados com a digestão de alimentos.
Os pães de fermentação natural também são produzidos com a ajuda de microrganismos, nesse caso, os fungos. No preparo do pão, os fungos chamados leveduras, presentes no fermento biológico, consomem o açúcar da massa e produzem um gás. Esse gás fica preso na massa, fazendo-a crescer e ficar macia.
As algas também podem ser utiliza das de diversas formas para a alimentação. De algumas algas são retiradas substâncias usadas em gelatinas, outras algas são con sumidas diretamente, como nos sushis




ENCAMINHAMENTO
Com base no tópico Microrganismos e alimentos, inicia-se o trabalho com a habilidade EF04CI07. Esse trabalho continua nos demais tópicos deste capítulo, que discorrem sobre as aplicações dos microrganismos na produção de alimentos, medicamentos, vacinas, combustíveis e na agricultura.
Antes de iniciar o trabalho com o tema, perguntar aos estudantes:
• Vocês já repararam que o termo lactobacilos aparece em embalagens de bebidas como leite fermentado e iogurte?
• O que vocês acham que são lactobacilos?
15:49
Permitir que compartilhem suas experiências. Utilizar esse momento para identificar os conhecimentos prévios da turma sobre o assunto. Então, explicar que os lactobacilos são bactérias que participam da fabricação de alguns alimentos e citar que diversos exemplos da aplicação de microrganismos serão estudados neste capítulo.
Após esse momento inicial, propor uma leitura compartilhada do texto. Durante a leitura, destacar o papel dos
microrganismos na produção de alimentos por meio do processo de fermentação, explicando que se trata de uma transformação realizada por fungos e bactérias, essencial na fabricação de produtos como pães, queijos e iogurtes.
Em seguida, explorar com a turma as imagens apresentadas na página, relacionando cada uma com o tipo de microrganismo envolvido. Chamar a atenção, por exemplo, para o queijo gorgonzola e comentar que a parte escura observada em seu interior é composta de fungos responsáveis por seu sabor e sua aparência característicos.
Ao final, solicitar aos estudantes que compartilhem outros exemplos de alimentos fermentados que conhecem ou consomem no dia a dia.
|
PARA O ESTUDANTE
VÍDEO. CIÊNCIA Explica –Por que o fermento faz a massa crescer? 2023. 1 vídeo (1 min). Publicado pelo canal ClickCiência UFSCar. Disponível em: https:// www.youtube.com/wat ch?v=8VV9c-8FJZg. Acesso em: 4 ago. 2025.
Vídeo sobre a ação das leveduras na massa do pão.
Queijo gorgonzola.
Iogurte.
IMAGENS FORA DE PROPORÇÃO.
alga
O objetivo desta atividade prática é verificar a participação de leveduras no preparo da massa de pão, contribuindo para o desenvolvimento da habilidade EF04CI07 . Para tanto, propõe-se uma pergunta inicial, para a qual os estudantes podem elaborar hipóteses sobre o crescimento da massa de pão. Essas hipóteses poderão ser testadas na atividade prática, favorecendo o desenvolvimento da competência geral 2 e da competência específica 2 de Ciências da Natureza.
Para a realização da atividade, organizar previamente todos os materiais necessários e selecionar um espaço adequado, garantindo a segurança dos estudantes e o bom andamento da proposta. Essa preparação contribui para o engajamento da turma e para a clareza na execução dos procedimentos.
A atividade pode ser realizada de forma demonstrativa, com o professor conduzindo os passos do experimento enquanto os estudantes observam atentamente cada etapa e os fenômenos naturais que se manifestam. Durante a demonstração, estimular a curiosidade deles com perguntas que incentivem a reflexão.
Alternativamente, a atividade pode ser realizada em grupos menores, sendo que todos os grupos devem realizar todas as etapas.
Alertar a turma para não consumir a massa de pão crua. Também se informar sobre casos de alergias e restrições alimentares antes de conduzir a prática.
Ao final do experimento, organizar a turma em uma roda de conversa. Esse momento coletivo é essencial
Fermentação do pão
Durante o preparo do pão caseiro, algumas pessoas colocam um pedaço da massa em um copo com água. Esse procedimento ajuda a verificar se a massa cresceu e está pronta para assar. Mas o que acontece durante esse procedimento que permite concluir que a massa do pão, de fato, cresceu?
Para explorar esse assunto, realizem, em pequenos grupos, a atividade a seguir.
• Recipiente plástico
• Copo com água
• 50 gramas ou 5 colheres (sopa) de farinha de trigo
COMO FAZER
• 100 mililitros (cerca de 1 2 xícara) de água
• 1 colher (chá) de fermento biológico fresco
• Cronômetro ou relógio
1. No recipiente, coloquem a farinha, a água e 1 colher (chá) de fermento biológico. Misturem tudo até obter uma massa.
2. Retirem um pedaço da massa e o coloquem no copo com água.
IMAGENS FORA DE PROPORÇÃO.
AS CORES NÃO SÃO REAIS

ALEX ARGOZINO
3. Aguardem 30 minutos e observem o que acontece.
VAMOS CONVERSAR?
Representação da montagem, antes de se passarem os 30 minutos.
Consultar orientações e respostas no Livro do Professor.
1. O que aconteceu com o pedaço da massa de pão no copo após 30 minutos? Descrevam o resultado observado pelo grupo.
2. Considerando os conhecimentos do grupo sobre a fermentação, como vocês explicariam o resultado observado?
3. O que poderia ter acontecido se o fermento biológico não fosse colocado na massa de pão? Conversem e apresentem a resposta de vocês ao restante da turma.
para que os estudantes compartilhem suas observações, suas opiniões e seus aprendizados, promovendo a troca de ideias e a construção colaborativa do conhecimento. Orientá-los a retomar suas hipóteses iniciais e as confrontar com os resultados observados.
| ORIENTAÇÕES E RESPOSTAS
1. Resposta pessoal. No início do experimento, a massa de pão ocupava o fundo do copo com água. Espera-se que, após 30 minutos, a massa de pão passe a flutuar na água.
2. O fermento biológico contém leveduras que fermentaram a massa do pão. Durante a fermentação, houve liberação de gás (no caso, o gás carbônico), que ficou preso na massa tornando-a menos densa que a água e fazendo-a flutuar.
3. A massa de pão permaneceria no fundo do copo, pois, sem a fermentação gerada pelas leveduras, não haveria produção de gás.
MICRORGANISMOS, MEDICAMENTOS E VACINAS
Além de produtos alimentícios, os microrganismos podem ser usados na produção de medicamentos.
ATENÇÃO!
Nunca tome antibióticos ou qualquer outro medicamento sem a indicação de um médico.
Os antibióticos são medicamentos utilizados no tratamento de doenças causadas por bactérias. Eles agem eliminando essas bactérias ou impedindo que elas se multipliquem no corpo.
O primeiro antibiótico a ser produzido em larga escala foi a penicilina, ajudando a salvar milhões de vidas. Antes dela, muitas pessoas morriam devido a certas infecções que hoje podem ser tratadas com facilidade.
A penicilina foi identificada, em 1928, pelo cientista escocês Alexander Fleming (1881-1955) enquanto estudava bactérias causadoras de doenças. Em seus estudos, Fleming preparava recipientes semelhantes a pequenos pratos, chamados placas, com nutrientes que permitiam às bactérias crescer e se reproduzir.
Certo dia, ele viajou e esqueceu algumas dessas placas com nutrientes em seu laboratório. Quando voltou, percebeu algo diferente: um fungo havia crescido sobre elas. Fleming notou que, ao redor do fungo, não havia bactérias. Ele ficou curioso e decidiu investigar. Descobriu, então, que aquele fungo produzia uma substância capaz de matar as bactérias. Foi assim que ele identificou a penicilina.
Placa com o fungo produtor do antibiótico penicilina.
DIALOGANDO
Todo medicamento deve ser usado somente com receita médica e tomado exatamente como o médico orienta. No caso dos antibióticos, o que pode acontecer se uma pessoa não seguir o tratamento corretamente?
Resposta pessoal. Espera-se que os estudantes reconheçam que o antibiótico ajuda a eliminar as bactérias que estão causando a doença. Por isso, se uma pessoa não seguir corretamente o tratamento, as bactérias que causam a doença podem não ser totalmente eliminadas, fazendo com que a pessoa continue doente ou até mesmo piore.
sistema imunitário a combater doenças, protegendo o organismo de infecções futuras. Reforçar que a vacinação é uma das medidas preventivas mais eficazes desenvolvidas pela ciência.
| PARA O PROFESSOR
VÍDEO. IBAHIA Educação –História – Descoberta da penicilina. 2014. 1 vídeo (2 min 28 s). Publicado pelo canal Ibahia. Disponível em: https://www.youtube.com/ watch?v=dsw2WkYrxAU. Acesso em: 4 ago. 2025. Vídeo que explora, de maneira objetiva, elementos históricos da descoberta da penicilina.
TEXTO. COMO são as vacinas desenvolvidas? Organização Mundial da Saúde, 4 set. 2025. Disponível em: https://www.who.int/ pt/news-room/feature-sto ries/detail/how-are-vacci nes-developed. Acesso em: 15 set. 2025.
Artigo que explica o desenvolvimento e a distribuição das vacinas.
| PARA O ESTUDANTE
As vacinas são outro exemplo de produtos da área da saúde elaborados com o uso de microrganismos. Elas ajudam o organismo humano a desenvolver defesas contra certos microrganismos e vírus que podem causar doenças. Por isso, tomar vacina é uma medida importante para prevenir doenças.
ENCAMINHAMENTO
Propor uma roda de conversa para discutir a atividade do boxe Dialogando Destacar a importância do uso correto dos antibióticos, que devem ser tomados apenas sob orientação médica. Se oportuno, abordar o conceito de resistência bacteriana, explicando que as bactérias não se adaptam aos antibióticos, mas que aquelas naturalmente mais resistentes sobrevivem quando o medicamento é usado de forma inadequada. Essas bactérias acabam se multiplicando, favorecendo a disseminação de linhagens resistentes. Isso representa
Prevenir: evitar.
02/10/25 15:49
um grave problema de saúde pública, podendo aumentar significativamente o risco de infecções de difícil tratamento. Reforçar que o uso de todo e qualquer tipo de medicamento – não somente antibióticos – deve ser feito apenas sob orientação médica. A automedicação jamais deve ser praticada. Essa discussão oportuniza a abordagem do Tema Contemporâneo Transversal (TCT) Saúde. Apresentar uma explicação breve sobre vacinas, que são produzidas a partir de microrganismos ou vírus enfraquecidos, inativos ou partes deles. Elas estimulam o
LIVRO. ROSA, Sonia. Maria Rosa, o amor e as vacinas. Rio de Janeiro: Portinho Livre, 2023. Disponível em: https://portolivre.fiocruz.br/ sites/portolivre.fiocruz.br/ files/livros_pdf/Maria%20 Rosa%2C%20o%20 Amor%20e%20as%20Vaci nas_final%20Portinho%20 Livre_0.pdf. Acesso em: 5 ago. 2025.

Reprodução da capa.
Livro que apresenta, de forma lúdica, uma história sobre a importância da vacinação.
Explicar aos estudantes que muitos microrganismos do solo contribuem diretamente para a fertilidade e a saúde das plantas, ajudando na decomposição da matéria orgânica e na liberação de nutrientes essenciais. Além disso, alguns microrganismos formam associações com raízes de plantas, como as bactérias fixadoras de nitrogênio, favorecendo o crescimento vegetal sem a necessidade de grandes quantidades de adubos industriais.
Comentar também que os microrganismos podem ser utilizados em práticas sustentáveis, como o controle biológico de pragas, substituindo o uso de pesticidas químicos, e na biorremediação, uma técnica para recuperar solos contaminados ou degradados por meio da ação de microrganismos que transformam substâncias poluentes em compostos menos tóxicos.
VOCÊ LEITOR!
Para trabalhar a seção, sugere-se organizar a turma em uma roda e promover a leitura coletiva do texto, alternando os leitores. Após a leitura, incentivar os estudantes a exercer a oralidade, explicitando aquilo que compreenderam do texto.
Incentivar a turma a refletir sobre como o uso consciente e responsável dos microrganismos pode beneficiar o ambiente e a produção de alimentos, promovendo uma agricultura mais equilibrada e sustentável. Essa reflexão contribui para o desenvolvimento da competência específica 4 de Ciências da Natureza.
Aproveitar a oportunidade para destacar que
MICRORGANISMOS E AGRICULTURA
Os microrganismos também são importantes na agricultura. Eles podem, por exemplo, ser utilizados na fabricação de fertilizantes e em outros processos.
Os fertilizantes são substâncias colocadas no solo para fornecer nutrientes às plantas e ajudar em seu crescimento. Além disso, alguns microrganismos ajudam as plantas a aproveitar melhor os nutrientes que já existem no solo. Com isso, os agricultores podem usar menos fertilizantes, o que evita a poluição da água e a degradação do solo. A capacidade de algumas bactérias auxiliarem na nutrição das plantas foi identificada pela cientista e agrônoma brasileira Johanna Döbereiner (1924-2000).

Johanna Döbereiner no laboratório em que desenvolveu pesquisas no município do Rio de Janeiro, em 1995.
Bactérias que ajudam as plantas
A descoberta de Johanna [Döbereiner] foi tão importante que, por causa dela, hoje o Brasil é o […] maior produtor de soja do mundo!
Na maioria dos países, para plantar milho, soja e outros grãos, é necessário que a terra seja fortalecida com adubos […] fabricados em laboratório, que podem ser bem caros. Sem eles, as plantas não crescem saudáveis, o que dá bastante prejuízo aos produtores.
Graças a Johanna, não é o caso do Brasil!
Acontece que, enquanto o mundo todo apostava no desenvolvimento de novos adubos, Johanna pensava que tinha que existir outra maneira […] de dar às plantas os nutrientes de que elas precisavam para crescer. Foi então que ela descobriu que o próprio solo já tem bactérias capazes de fazer o papel do adubo. […]
BONASSA, Ana Cláudia M.; FREITAS, Laura Marise de; ARAÚJO, Renan Vinícius de. Super-heróis da ciência: 52 cientistas e suas pesquisas transformadoras. Rio de Janeiro: HarperKids, 2021. p. 88.
Plantação de soja em Mato Grosso, 2025, com destaque para a vagem verde e os grãos de soja verdes e maduros.

a Ciência é um empreendimento humano, desenvolvendo a competência específica 1 de Ciências da Natureza. Promover um debate sobre a relevância da produção científica, que contribui diretamente para o desenvolvimento de soluções mais sustentáveis, eficientes e acessíveis na agricultura e em outras áreas. Ao refletir sobre os impactos da pesquisa de Johanna Döbereiner, os avanços no cultivo da soja e a posição do Brasil como líder mundial nessa produção, os estudantes são incentivados a valorizar a ciência como ferramenta de

transformação social, econômica e ambiental, desenvolvendo a competência específica 3 de Ciências da Natureza
Muitas vezes, o trabalho de cientistas mulheres não recebe o devido reconhecimento. Por isso, é fundamental valorizar e respeitar seu espaço, mostrando que a ciência pode ser feita por qualquer pessoa. Incentivar os estudantes a refletir sobre como a diversidade de ideias e de pessoas fortalece a produção científica. Valorizar o exemplo de Johanna Döbereiner como inspiração para que meninas e meninos se sintam motivados a seguir
1. É necessário que a terra seja fortalecida com adubos, pois sem eles as plantas não crescem saudáveis e geram prejuízos aos produtores.
1. De acordo com o texto, o que é necessário para plantar milho, soja e outros grãos?
2. Qual foi a descoberta de Johanna Döbereiner nesse sentido?
Consultar orientações e resposta no Livro do Professor
3. Que benefício a descoberta da cientista proporcionou aos produtores desses grãos?
Essa descoberta tornou o cultivo desses grãos mais barato.
4. Conforme o texto, devido à descoberta de Johanna, o que o Brasil se tornou em relação à produção de soja no mundo?
O Brasil se tornou o maior produtor de soja do mundo.
5. Como o texto evidencia a importância de estudar microrganismos que vivem no solo?
Consultar orientações e resposta no Livro do Professor
MICRORGANISMOS E COMBUSTÍVEIS
Os combustíveis liberam energia e podem ser utilizados para abastecer e fazer funcionar máquinas e veículos. Alguns deles podem ser produzidos com a ajuda de microrganismos.
Um exemplo é o etanol, um combustível amplamente utilizado no Brasil em automóveis, principalmente em carros. Ele é produzido de plantas, como a cana-de-açúcar, a beterraba e o milho, por meio da fermentação feita por leveduras que consomem o açúcar dessas plantas.

caminhos na ciência e a contribuir com soluções para o mundo.
As atividades propostas na seção levam os estudantes a desenvolver as habilidades de Língua Portuguesa indicadas a seguir.
• EF15LP03: Localizar informações explícitas em textos.
• EF15LP09: Expressar-se em situações de intercâmbio oral com clareza, preocupando-se em ser compreendido pelo interlocutor e usando a palavra com tom de voz audível, boa articulação e ritmo adequado.
| ORIENTAÇÕES E RESPOSTAS
2. Johanna Döbereiner descobriu uma maneira de cultivar soja sem a necessidade de utilizar fertilizantes (adubos) produzidos em laboratório.
5. O texto relata que, a partir da descoberta de bactérias que vivem naturalmente no solo, foi possível cultivar soja de uma forma mais econômica no Brasil, sem a necessidade de adubos químicos caros. Com isso, também houve redução nos possíveis impactos ambientais negativos que poderiam ser causados pelo uso de adubos químicos em excesso.
No tópico Microrganismos e combustíveis, mencionar que outro exemplo de combustível renovável é o biogás, que pode ser utilizado na geração de energia elétrica. Ele é produzido pela ação de bactérias sobre resíduos orgânicos, como restos de alimentos e esgoto, em um processo conhecido como fermentação anaeróbica, que ocorre na ausência de gás oxigênio.
A produção de biogás apresenta benefícios ambientais, como a redução da quantidade de lixo orgânico nos aterros, a diminuição da emissão de gases poluentes na atmosfera e o aproveitamento de uma fonte de energia renovável.
NÃO ESCREVA NO LIVRO.
Usina de produção de etanol em Bariri, São Paulo, 2023.
2. Esta atividade promove o desenvolvimento da habilidade EF04CI07, uma vez que os estudantes vão discorrer sobre aplicações dos microrganismos no enfrentamento de problemas da sociedade. Ela também oportuniza o exercício da habilidade de Língua Portuguesa indicada a seguir.
• EF04LP19 : Ler e compreender textos expositivos de divulgação científica para crianças, considerando a situação comunicativa e o tema/ assunto do texto.
ATIVIDADES
Solicitar aos estudantes que, com a ajuda de um adulto da família, pesquisem um produto de uso diário que envolva microrganismos em sua produção. A partir dos resultados encontrados, orientá-los a organizar as informações em forma de narrativa no caderno. Possibilitar que leiam suas narrativas em sala de aula, promovendo uma rica troca de conhecimentos e ampliando a visão da turma sobre as múltiplas aplicações dos microrganismos. A atividade propicia a integração com Língua Portuguesa, propondo o trabalho com o gênero texto narrativo.
VOCÊ CIDADÃO!
Esta seção contempla o Tema Contemporâneo Transversal (TCT) Educação ambiental, ao promover reflexões sobre a importância de reduzir o uso de materiais descartáveis feitos de plástico comum, incentivando sua substituição por alternativas biodegradáveis – algumas delas, feitas por bactérias.
Nesse contexto, promover com os estudantes um
1. A indicação significa que o iogurte contém bactérias vivas chamadas lactobacilos, que são utilizadas em seu processo de fabricação. Além de participarem da produção de bebidas lácteas, essas bactérias auxiliam nos processos que ocorrem no intestino humano, relacionados à digestão de alimentos.
ATIVIDADES
1. Na embalagem de algumas bebidas lácteas, como iogurtes, existe a indicação da presença de “lactobacilos vivos”. O que isso significa?
2. O petróleo é um recurso retirado tanto de reservas nas camadas abaixo do solo de ambientes terrestres quanto do fundo do mar. Ele tem diferentes aplicações na indústria, sendo utilizado para a produção de combustíveis como a gasolina e o óleo diesel. Durante o processo de extração, podem ocorrer acidentes que resultam em derramamento de petróleo, o que contamina a água e prejudica os seres vivos. Quando isso acontece, é preciso remover o petróleo da água o mais rápido possível, de modo a reduzir esses impactos. Uma das soluções encontradas pelos cientistas para remover o petróleo da água envolve o uso de microrganismos. Leia o trecho da notícia a seguir.
Bactéria que “come” petróleo pode ajudar a limpar os mares […]
Vazamentos de óleo no mar infelizmente são cada vez mais comuns. O que representa um grande impacto no meio ambiente, uma vez que a descontaminação é cara e não acontece rapidamente. Mas, pesquisadores encontraram uma solução microscópica […]: uma bactéria que se alimenta de [petróleo]. […]
BACTÉRIA que “come” petróleo pode ajudar a limpar os mares. CicloVivo, [s. l.], 11 abr. 2018. Disponível em: https://ciclovivo.com.br/inovacao/tecnologia/bacteria-petroleo-limpar-mares/. Acesso em: 8 maio 2025.
a) Que microrganismo é citado no texto? Uma bactéria.
b) De que maneira esse microrganismo pode ser aplicado para solucionar o problema citado no texto?
3. Leia o poema a seguir.
AS CORES NÃO SÃO REAIS
IMAGENS FORA DE PROPORÇÃO
Representação de bactérias.
Consultar orientações no Livro do Professor. 28
A bactéria se alimenta de petróleo. Por isso, pode contribuir para a limpeza de mares e oceanos contaminados por esse material.
Tão pequenos, não dá para ver, mas acredite: são de surpreender. Fazem o queijo, o iogurte e o pão, criam sabores, fazem a transformação.
Na Medicina, são proteção, Geram vacinas, trazem prevenção.
3. a) Resposta pessoal. Espera-se que os estudantes criem um título que leve em consideração as informações do poema, podendo relacionar microrganismos e tecnologia ou o uso de microrganismos pelos seres humanos, por exemplo.
Elaborado pelo autor.
a) Crie um título para o poema com base nas informações que estão nos versos.
b) Quais aplicações dos microrganismos são citadas no poema? Produção de alimentos (queijo, iogurte e pão) e produção de vacinas e medicamentos.
debate sobre atitudes cotidianas que contribuem para essa redução, como o uso de materiais reutilizáveis; por exemplo, copos e talheres de metal, sacolas de tecido, entre outros. Sobre esse assunto, há uma sugestão de atividade complementar em +Atividades.
Outro ponto relevante a ser discutido é a separação e a destinação correta dos resíduos, evitando que se acumulem em terrenos baldios, bueiros ou corpos de água. Com relação aos plásticos biodegradáveis, explicar que eles também apresentam desvantagens, como a demanda por
compostagem industrial (mais informações sobre o assunto podem ser encontradas em Para o professor). Diante disso, propor aos estudantes uma conversa sobre a dificuldade de encontrar soluções que eliminem completamente os problemas ambientais; no geral, elas tendem apenas a reduzir impactos. Ainda assim, reforçar a importância de adotá-las. Essa abordagem estimula o pensamento crítico e a responsabilidade, formando cidadãos conscientes e preparados para enfrentar os desafios ambientais.
NÃO ESCREVA NO LIVRO.
Plásticos biodegradáveis
VOCÊ
CIDADÃO!
As sacolas plásticas, produzidas do petróleo, são muito usadas no dia a dia, mas podem causar impactos negativos no ambiente. Quando descartadas de forma incorreta, poluem rios, mares e florestas. Além disso, podem prejudicar os animais, que correm o risco de ficar presos nelas ou confundi-las com comida e se engasgar, principalmente em ambientes aquáticos. Uma maneira de reduzir esses problemas seria substituir o plástico utilizado na fabricação de sacolas. Algumas bactérias podem ser utilizadas para fabricar plásticos biodegradáveis, ou seja, plásticos que se desfazem mais facilmente na natureza, sem causar tanto impacto.

Saco plástico descartado à deriva no mar.
1. Resposta pessoal. Quando descartadas de forma errada, as sacolas plásticas podem poluir o ambiente e prejudicar os animais, que podem confundi-las com comida e se engasgar ou ficar presos nelas.
1. Em duplas, conversem sobre quais impactos as sacolas plásticas podem causar no ambiente.
2. O que são plásticos biodegradáveis?
São plásticos que se desfazem mais rápido no ambiente.
3. Como os microrganismos podem ajudar a reduzir os impactos de sacolas plásticas no ambiente?
Algumas bactérias podem ser utilizadas para produzir plásticos biodegradáveis. Por se desfazerem mais rápido, reduzem o impacto no ambiente.
4. Converse com seus familiares sobre a importância de reduzir o uso de sacolas plásticas. Defina com eles uma medida que pode ser adotada por vocês no dia a dia para reduzir o impacto dessas sacolas no ambiente. Juntos, produzam um cartaz que represente essa medida. Depois, converse com o professor sobre a possibilidade de expor o cartaz em algum local da escola, incentivando outras pessoas a refletir sobre o tema.
Resposta pessoal. É importante que os estudantes reflitam sobre a necessidade de reduzir o uso de sacolas plásticas e, quando for indispensável utilizá-las, sobre a importância de descartálas corretamente, para que sejam recicladas ou destinadas a um local adequado. Consultar orientações no Livro do Professor.
| ORIENTAÇÕES E RESPOSTA
4. A atividade contribui para o desenvolvimento da competência geral 10 e da competência específica 8 de Ciências da Natureza, ao incentivar atitudes responsáveis, levando os estudantes a pensar em soluções práticas para o problema do excesso de plástico e reforçando o papel de cada um na preservação ambiental.
Auxiliar os estudantes na produção do cartaz de modo que eles façam uma relação coerente entre os textos e os
elementos gráficos. Nesse sentido, esta atividade colabora com a habilidade de Língua Portuguesa indicada a seguir.
02/10/25 15:49
• EF15LP18: Relacionar texto com ilustrações e outros recursos gráficos.
ATIVIDADES
Organizar a turma em pequenos grupos e propor uma pesquisa sobre alternativas ao plástico na fabricação de sacolas (por exemplo, papel, tecido, fibras vegetais, bioplástico produzido por microrganismos). Orientá-los a buscar também as
vantagens e desvantagens de cada material. Reservar um momento para que os grupos apresentem oralmente os resultados de suas pesquisas. A apresentação oral, nesse caso, pode ser utilizada como instrumento avaliativo da aprendizagem.
| PARA O PROFESSOR
TEXTO . CIENTISTAS brasileiros usam bactéria para transformar plástico em produto biodegradável. Jornal Nacional , 24 mar. 2025. Disponível em: https://g1.globo. com/jornal-nacional/ noticia/2025/03/24/ cientistas-brasileiros-usam -bacteria-para-transformar -plastico-em-produto -biodegradavel.ghtml. Acesso em: 5 ago. 2025. Reportagem sobre uma pesquisa realizada por cientistas brasileiros que investigaram o potencial de uma bactéria em transformar resíduos plásticos comuns em um material biodegradável.
TEXTO . OAKES, Kelly. O problema pouco conhecido do plástico biodegradável. BBC News Brasil , 9 out. 2020. Disponível em: https://www. bbc.com/portuguese/vert -fut-52926914. Acesso em: 16 ago. 2025.
Reportagem que discorre sobre diferentes aspectos relacionados aos plásticos biodegradáveis.
NÃO ESCREVA NO LIVRO.
ENCAMINHAMENTO
Para realizar o trabalho da seção, propor uma leitura coletiva do texto da página.
O poema apresenta, de forma lúdica e acessível, a relação direta entre os microrganismos e a saúde humana. Com base na história de João, destaca-se como hábitos inadequados de higiene – como não lavar as mãos antes de se alimentar – favorecem a entrada de microrganismos patológicos no corpo, causando doenças. Os versos reforçam a importância da higiene pessoal, especialmente das mãos, como medida preventiva simples, mas eficaz, para evitar a transmissão de microrganismos e vírus causadores de infecções. É um excelente ponto de partida para discutir com os estudantes o papel dos microrganismos e dos vírus na saúde e a importância de cuidados diários para se manter saudável.
Esse trabalho auxilia o desenvolvimento da habilidade de Língua Portuguesa indicada a seguir.
• EF35LP27: Ler e compreender, com certa autonomia, textos em versos, explorando rimas, sons e jogos de palavras, imagens poéticas (sentidos figurados) e recursos visuais e sonoros. Durante o trabalho com o texto, manter um ambiente respeitoso, lembrando que o personagem João é fictício. Reforçar que a história não se refere a nenhum estudante em particular e, assim, evitar comentários que possam constranger ou desrespeitar colegas com esse nome. Essa abordagem contribui para combater práticas de bullying.
CAPÍTULO
MICRORGANISMOS E SAÚDE
Leia o poema a seguir.

João, lave as mãos
Sabe o João?
[…]
Joga bola, empina pipa,
Não quer banho
Nem quer touca…
As mãos sujas de meleca
De repente
Estão na boca!
Os bichinhos que não vemos
Estão vendo
A mão de João…
E ele bota a mão na boca
Sem passar água e sabão
[…]
Mas um dia
João notou
Que a sujeira lhe castiga!
Comeu sem lavar as mãos,
E ganhou
Dor de barriga!
[…]
RENATO, Robson. João, lave as mãos
Ilustrações de Fendy Silva. Natal: Timbú, 2021.
1. O que João faz que prejudica a saúde dele?
A que seres vivos essa expressão se refere?
NÃO ESCREVA NO LIVRO.
2. O texto cita a presença de “bichinhos que não vemos” nas mãos de João.
3. Você acha que o hábito de lavar as mãos poderia ter evitado a dor de barriga de João? Por quê?
Consultar orientações e resposta no Livro do Professor Consultar orientações e respostas no Livro do Professor
Aos microrganismos. Consultar orientações no Livro do Professor 30
4. Você costuma lavar as mãos antes das refeições?
Consultar orientações e resposta no Livro do Professor
| ORIENTAÇÕES E RESPOSTAS
1. Ele não quer tomar banho, leva as mãos sujas de meleca até a boca e se alimenta sem antes lavar as mãos.
2. O termo bichinhos, usado em linguagem coloquial, diz respeito a animais. Ressaltar que os microrganismos não são animais.
3. Respostas pessoais. Utilizar esse questionamento para avaliar os conhecimentos prévios dos estudantes sobre
a importância de lavar as mãos para a prevenção de doenças. Aproveitar a oportunidade para questionar a turma sobre outros hábitos de higiene, como escovar os dentes e tomar banho diariamente.
4. Resposta pessoal. Conversar com os estudantes sobre os hábitos de higiene em geral, verificando seus conhecimentos sobre o assunto.
FOTOGRAFIA: LAPINA/SHUTTERSTOCK.COM;MÃOS: EDITORIA DE ARTE
MICRORGANISMOS E VÍRUS PODEM CAUSAR DOENÇAS
Embora muitos microrganismos sejam benéficos e usados em várias situações do dia a dia, alguns podem causar doenças. Os microrganismos e vírus patogênicos podem ser transmitidos de diferentes formas. Conheça alguns exemplos a seguir.
DOENÇAS TRANSMITIDAS PELA SALIVA
Algumas doenças podem ser transmitidas pelo contato com gotículas de saliva contaminadas, que são liberadas durante a fala, a tosse ou o espirro.
Se uma pessoa infectada espirrar e essas gotículas atingirem a boca, o nariz ou os olhos de outra pessoa que está no mesmo ambiente, ela pode se infectar e desenvolver a doença.
Infectada: que está contaminada por um agente causador de doença.
Além disso, as gotículas de saliva podem se depositar em superfícies como mesas, maçanetas, corrimãos e outros objetos. Ao tocarem esses locais, outras pessoas podem se contaminar.

Ao segurar no apoio do ônibus, nossas mãos podem ser contaminadas por gotículas de saliva liberadas por outras pessoas. Por isso, é importante lavar as mãos após a viagem e evitar tocar nos olhos, na boca e no nariz.
ENCAMINHAMENTO
Mulher preparando alimento em restaurante comunitário no Quilombo Campinho da Independência em Paraty, no Rio de Janeiro, 2021. O uso de máscara evita que gotículas de saliva que podem conter agentes patogênicos contaminem o ambiente e os alimentos.

O tópico Microrganismos e vírus podem causar doenças fornece subsídios para o desenvolvimento da habilidade EF04CI08, ao abordar as formas de transmissão e os principais sintomas de diferentes doenças causadas por microrganismos e vírus. Com base nesses conhecimentos, os estudantes terão embasamento para refletir sobre prevenção e propor estratégias, o que será aprofundado no tópico Prevenção de doenças causadas por microrganismos e vírus.
mútua e o diálogo, e conduzir uma conversa com perguntas que estimulem a reflexão e a troca de experiências. Algumas sugestões:
• Quais doenças vocês conhecem que são causadas por microrganismos e vírus?
• Vocês já tiveram alguma(s) dessas doenças? Como foi a experiência? Quais sintomas tiveram?
• Como acham que essas doenças são transmitidas de uma pessoa para outra?
• Que atitudes podemos adotar no dia a dia para evitar o contágio dessas doenças?
• Vocês sabem o que são vacinas? Já tomaram alguma? Para que servem?
Após a conversa, retomar os pontos principais discutidos e destacar que, ao longo do capítulo, os estudantes vão aprofundar os conhecimentos sobre o tema, estudando algumas doenças causadas por microrganismos e vírus, como são transmitidas e de que formas é possível preveni-las.
03/10/25 21:00
Ambos os tópicos contribuem ainda para o desenvolvimento da competência geral 8 e da competência específica 7 de Ciências da Natureza, além de abordar o Tema Contemporâneo Transversal (TCT) Saúde, ao promoverem a conscientização sobre hábitos de higiene, cuidados com o corpo e responsabilidade coletiva na prevenção de doenças.
Ao iniciar o trabalho com o tema, reservar um momento inicial para verificar os conhecimentos prévios dos estudantes sobre o assunto. Para isso, organizá-los em uma roda, favorecendo a escuta
Se considerar interessante, solicitar que registrem, no caderno, suas percepções iniciais, que podem ser retomadas ao longo do capítulo para avaliar o que aprenderam. Durante o tópico Doenças transmitidas pela saliva, se julgar oportuno, é possível diferenciar formas de transmissão direta (como espirrar ou tossir próximo a outra pessoa) e indireta (como compartilhar objetos contaminados; por exemplo, copos, talheres, garrafas ou brinquedos levados à boca).
ENCAMINHAMENTO
Além das doenças transmitidas pela saliva apresentadas, pode-se abordar a meningite e a covid-19.
A meningite pode ser provocada por bactérias ou vírus. Essa doença afeta as membranas que envolvem o cérebro e a medula espinal. Os sintomas mais comuns incluem febre alta, dor de cabeça intensa, rigidez na nuca, vômitos e sensibilidade à luz. Em casos graves, pode levar a complicações sérias se não for tratada rapidamente.
A covid-19 é uma doença causada por um vírus e tem como principais sintomas febre, mal-estar, dores de cabeça e dores no corpo. Em algumas pessoas, a doença afeta os pulmões e causa falta de ar. Essa doença atingiu praticamente todos os países do mundo no início de 2020, sendo caracterizada como uma pandemia, e levou alguns anos para ser controlada.
Comentar com a turma que a prevenção de doen ças transmitidas pela saliva passa por cuidados simples e eficazes, como higienizar as mãos com frequência, utilizar máscaras de proteção facial, evitar aglomerações e ambientes fechados com pouca ventilação, além de manter a vacinação em dia, quando houver vacinas disponíveis para determinada doença.
Ressaltar que essas atitudes são fundamentais para proteger não apenas a própria saúde, mas também a das pessoas ao redor, contribuindo para a redução da circulação de microrganismos e para a promoção do bem-estar coletivo.
Ao trabalhar o tópico Doenças transmitidas

Médico analisando raio X de pulmões de um paciente. O raio X, ou radiografia, é um exame utilizado para observar o interior do corpo e pode ajudar a identificar doenças que afetam os pulmões, como a pneumonia.
Entre as doenças que comumente são transmitidas pela saliva estão a pneumonia e a gripe.
A pneumonia é uma doença que afeta os pulmões. Ela pode ser causada por bactérias, vírus ou fungos. Os principais sintomas incluem febre, tosse e dificuldade para respirar.
Sintomas: sinais percebidos por uma pessoa que podem indicar problemas na saúde de seu organismo.
A gripe é uma doença causada por diferentes tipos de vírus. Os principais sintomas incluem febre, dor de garganta, tosse, mal-estar e dor no corpo.
DOENÇAS TRANSMITIDAS PELA ÁGUA E POR ALIMENTOS CONTAMINADOS
Quando uma pessoa consome água ou alimentos contaminados, microrganismos patogênicos podem entrar em seu corpo e causar doenças. Exemplos são a cólera, causada por uma bactéria, e a amebíase, causada por um protozoário. A cólera provoca muita diarreia e dores na região da barriga. Já a amebíase pode provocar febre, dores na região da barriga, diarreia e, em alguns casos, presença de sangue nas fezes.
A água contaminada também pode transmitir doenças pelo contato com a pele, sobretudo quando há um machucado. Um exemplo é a leptospirose, causada por uma bactéria presente na urina de ratos infectados. Em inundações, por exemplo, essa urina pode se misturar com a água, contaminando as pessoas que tiveram contato com ela. Os sintomas da leptospirose incluem febre, diarreia, dor de cabeça e dores no corpo.
Rua inundada em Porto Alegre, no Rio Grande do Sul, em 2024. Em caso de inundações, é importante evitar o contato direto com a água. Nunca brinque ou nade nessas águas.

pela água e por alimentos contaminados, ressaltar que a cólera e a amebíase são doenças que podem se espalhar rapidamente em regiões com saneamento básico precário. Isso ocorre porque, na ausência de tratamento adequado da água e do esgoto, microrganismos patogênicos presentes nas fezes humanas podem contaminar fontes de água e alimentos consumidos pela população.
Explicar que a ingestão de água contaminada ou de alimentos mal higienizados é uma das principais vias de transmissão dessas doenças e que medidas simples
como lavar bem os alimentos, ferver ou filtrar a água antes de beber, além de manter a higiene pessoal e ambiental, são essenciais para a prevenção. No caso da leptospirose, medidas de prevenção incluem evitar o contato com água ou lama de enchentes, manter o lixo bem armazenado e fora do alcance de roedores, além de utilizar botas e luvas em situações de risco.
DOENÇAS TRANSMITIDAS POR INSETOS
Algumas doenças são transmitidas por insetos. Quando o inseto pica uma pessoa infectada, ele pode adquirir o microrganismo e depois transmiti-lo a outras pessoas.
Um exemplo é a doença de Chagas. Ela é causada por um protozoário e transmitida por um inseto conhecido popularmente como barbeiro

Barbeiro, inseto transmissor da doença de Chagas e que pode ser encontrado em frestas e buracos de paredes e telhados de algumas casas, galinheiros ou galpões, sobretudo em áreas rurais.
Ao picar uma pessoa, o barbeiro deposita suas fezes perto do local da picada. Se estiverem contaminadas, essas fezes contêm o protozoário causador da doença. Ao coçar a área da picada, a pessoa pode acabar empurrando as fezes para dentro da ferida. Assim, o protozoário entra no corpo e pode causar a doença. Entre os sintomas estão febre, dor de cabeça, cansaço e, em casos mais graves, problemas no coração.

ENCAMINHAMENTO
A doença de Chagas é causada pelo protozoário Trypanosoma cruzi e transmitida principalmente pelas fezes do inseto conhecido popularmente como barbeiro, que são depositadas próximo ao local da picada. No entanto, há outras formas de transmissão dessa doença, como da mãe para o bebê durante a gestação e por transfusão de sangue contaminado. Os sintomas variam conforme a fase da doença, podendo ir de febre e inchaço no local da picada até complicações cardíacas e digestivas em casos crônicos.
Se considerar oportuno, comentar que a doença recebeu esse nome em homenagem ao médico e pesquisador brasileiro Carlos Chagas (1879-1934), que descreveu o ciclo completo da doença. Aproveitar a oportunidade para valorizar a participação brasileira no desenvolvimento científico.
Como medidas preventivas para a doença de Chagas, é possível citar o controle do barbeiro por meio da melhoria das condições de moradia e o uso de telas e inseticidas.
| PARA O ESTUDANTE
VÍDEO . UM CIENTISTA, uma história. Episódio 2: Carlos Chagas. 2015. 1 vídeo (5 min 14 s). Publicado pelo canal SESI. Disponível em: https://www. youtube.com/watch?v=ui tvjnkUDnc. Acesso em: 19 ago. 2025.
Vídeo sobre a história de Carlos Chagas, destacando aspectos de sua vida e sua trajetória profissional. Também traz informações sobre a doença de Chagas.
| PARA O PROFESSOR
TEXTO. AS 5 CURIOSIDADES sobre o barbeiro, o inseto que transmite a doença de Chagas. National Geographic Brasil , 14 abr. 2023. Disponível em: https://www.na tionalgeographicbrasil. com/animais/2023/04/ as-5-curiosidades-sobre -o-barbeiro-o-inseto-que -transmite-a-doenca-de -chagas. Acesso em: 5 ago. 2025.
Texto que aborda elementos relacionados à ecologia do barbeiro e as formas de prevenção da doença de Chagas.
Casa de pau a pique em Paraty, no Rio de Janeiro, 2024. O barbeiro costuma se esconder nas frestas desse tipo de casa. Por isso, em locais em que elas são comuns é importante haver ações públicas para o controle desse inseto e para promover melhorias nas moradias.
ENCAMINHAMENTO
Ao abordar a dengue, sugere-se destacar aspectos do ciclo de vida do mosquito Aedes aegypti . Ele se reproduz em ambientes com água parada, limpa e exposta, como vasos de plantas, pneus, garrafas, calhas entupidas e caixas-d’água destampadas. A fêmea deposita nas paredes desses recipientes os ovos, e estes podem resistir por meses em ambientes secos, eclodindo apenas após o contato com a água. Depois da ocorrência de chuvas, esses recipientes se enchem, favorecendo a eclosão dos ovos. Em poucos dias, as larvas se transformam em adultos e podem se reproduzir novamente.
No Brasil, os casos de dengue tendem a aumentar nos meses mais quentes e chuvosos, geralmente entre outubro (de um ano) e maio (do ano seguinte), com pico entre março e abril em muitas regiões. Esse aumento ocorre porque o calor e a umidade criam condições ideais para a proliferação do mosquito.
O combate à dengue exige ações contínuas de eliminação de criadouros, especialmente antes e após o período de chuvas, além da conscientização da comunidade sobre a importância de hábitos simples, como tampar reservatórios, limpar calhas e evitar o acúmulo de objetos que possam reter água.
Outras doenças transmitidas pelo mosquito Aedes aegypti incluem a zika, a chikungunya e a febre amarela. No caso da febre amarela, apenas o ciclo urbano da doença é transmitido por essa espécie de mosquito. Porém, segundo

O acúmulo de água parada favorece a reprodução dos mosquitos Aedes aegypti
Fêmea do mosquito Aedes aegypti, transmissor da dengue e outras doenças.
Outro exemplo é a dengue , causada por um vírus e transmitida pelo mosquiAedes aegypti. Nesse caso, o vírus é transmitido pela picada da fêmea do mosquito.
Os principais sintomas incluem febre alta, manchas vermelhas no corpo, dor de cabeça, dores atrás dos olhos, enjoo e diarreia.
Nos últimos anos, os casos de dengue aumentaram muito no Brasil. Esse crescimento está relacionado à maior presença do mosquito transmissor.
O aumento dos mosquitos é favorecido por hábitos inadequados dos seres humanos, como o acúmulo de resíduos em casas ou terrenos abandonados. Esses locais podem reter água da chuva, onde as fêmeas do mosquito depositam seus ovos. A água parada é o lugar ideal para o desenvolvimento desse inseto. FOCALPOINT/SHUTTERSTOCK

5 mm
informações do Ministério da Saúde, os últimos casos de febre amarela urbana registrados no Brasil ocorreram em 1942. Atualmente, o ciclo da doença que circula no país é o silvestre. Mais informações sobre os ciclos dessa doença são exploradas nas orientações específicas da seção Dialogando com Geografia
| PARA O PROFESSOR
SITE. BRASIL. Ministério da Saúde. Saúde de A a Z. Gov.br, c2025. Disponível em:
https://www.gov.br/saude/pt-br/assun tos/saude-de-a-a-z. Acesso em: 11 jul. 2025.
Site com informações complementares sobre as doenças mencionadas neste capítulo, além de diversas outras doenças comuns no Brasil. Para utilizá-lo, digitar o nome da doença ou termos relacionados no campo de busca da página.
VOCÊ CIDADÃO!
Cuidar do corpo: dos pés à cabeça
Como você já estudou, alguns microrganismos vivem naturalmente no corpo humano, enquanto outros estão no ambiente. Na maioria das vezes, eles não causam problemas. Mas, em certas condições, podem se multiplicar e provocar doenças, como a micose e a cárie.
A micose pode ser provocada por fungos que vivem no corpo do ser humano, no corpo de alguns animais ou no ambiente. Dias quentes, úmidos e roupas úmidas ou molhadas favorecem o aumento desses fungos, causando coceira, manchas e bolhas na pele.
A cárie afeta os dentes e é causada por bactérias da boca. Sem a escovação adequada, elas consomem restos de comida e se desenvolvem, danificando os dentes.

Após a prática de esportes, é importante evitar permanecer com roupas ou calçados úmidos por muito tempo para evitar o desenvolvimento de fungos.
4. Respostas pessoais. Espera-se que os estudantes proponham maneiras de melhorar seus hábitos de higiene, considerando a prevenção de doenças como a cárie e as micoses.
A maioria das pastas de dente e a água tratada contêm flúor, uma substância que ajuda a proteger os dentes da cárie.

1. Quais doenças foram mencionadas no texto? Micose e cárie.
2. Por que é importante secar bem o corpo após o banho?
3. Por que é importante escovar os dentes após as refeições?
NÃO ESCREVA NO LIVRO.
2. Secar bem o corpo ajuda a evitar o acúmulo de umidade. Isso é importante porque a umidade cria condições favoráveis ao crescimento de fungos que podem ocasionar micoses. 35
4. Reflita sobre seus hábitos de higiene. Quantas vezes você escova os dentes por dia? Você seca bem o corpo após o banho, inclusive entre os dedos? Evita roupas úmidas? Após essa reflexão, liste ações que você pode adotar para cuidar melhor de sua saúde.
3. Escovar os dentes após as refeições é importante para remover os restos de alimentos que ficam na boca e, assim, evitar a multiplicação de bactérias presentes nela, o que poderia levar ao desenvolvimento de cáries.
VOCÊ CIDADÃO!
A seção possibilita o desenvolvimento do Tema Contemporâneo Transversal (TCT) Saúde, ao promover a reflexão sobre hábitos de higiene e sua relação com doenças como micose e cárie.
Ao iniciar a abordagem desta seção, sugere-se realizar um momento de contextualização por meio de uma conversa com os estudantes. Essa introdução pode ser orientada por perguntas que incentivem o compartilhamento de experiências e de seus conhecimentos prévios, como:
• Vocês já usaram calçados úmidos ou suados por muito tempo? Sabem por que isso pode ser prejudicial ao corpo?
02/10/25 15:50
• Com que frequência vocês vão ao dentista? O que ele faz para ajudar a manter a saúde de nossos dentes? Promover um ambiente acolhedor e respeitoso. Esse momento inicial aproxima o conteúdo da realidade cotidiana dos estudantes, o que pode tornar a aprendizagem mais significativa. Reforçar a importância da escovação dentária. De acordo com a pesquisa
nacional SB Brasil, entre 2010 e 2023 aumentou o número de crianças de 5 anos livres de cárie nas regiões Sul (40,7%), Sudeste (21,9%), Nordeste (17,1%) e Norte (11,2%). Esse avanço mostra que o cuidado com a saúde bucal está melhorando, mas ainda é preciso ampliar ações de conscientização. Mais informações sobre o assunto podem ser encontradas em Para o professor.
ATIVIDADES
Organizar os estudantes em grupos e propor que criem um cartaz com dicas para prevenir a cárie dentária. Incentivá-los a usar frases curtas, ilustrações e informações aprendidas. Para a atividade, separar previamente papel kraft ou cartolina, lápis de cor, canetinhas e giz de cera, revistas para recorte, tesoura com pontas arredondadas, cola escolar, réguas e lápis grafite. Os cartazes podem ser utilizados como parte da avaliação do aprendizado dos estudantes.
A atividade propicia a integração com Língua Portuguesa, propondo o trabalho com o gênero texto narrativo.
| PARA O PROFESSOR
TEXTO. LIMA, Bianca. Aumenta número de crianças no Brasil sem cárie nos dentes. Gov.br , 13 jun. 2024. Disponível em: https://www.gov.br/ saude/pt-br/assuntos/ noticias/2024/junho/au menta-numero-de-crian cas-no-brasil-sem-carie -nos-dentes. Acesso em: 6 ago. 2025. Reportagem com dados sobre a saúde bucal infantil no Brasil dos últimos anos.
ENCAMINHAMENTO
Ao introduzir o conteúdo destas páginas, promover uma conversa com a turma sobre a importância dos hábitos de higiene e autocuidado no cotidiano. Convidar os estudantes a compartilhar o que costumam fazer para se manter saudáveis no dia a dia.
Em seguida, explorar o texto e as imagens, destacando a importância de adotar as atitudes mencionadas para a prevenção contra doenças causadas por microrganismos. A abordagem dessas atitudes possibilita aos estudantes desenvolver a habilidade EF04CI08 . Para exercitá-la, sugere-se questionar os estudantes sobre quais doenças podem ser evitadas ao adotar cada uma das atitudes citadas, incentivando a associação entre comportamento preventivo e saúde.
Abordar a necessidade de selecionar e higienizar adequadamente os alimentos, explicando que frutas, verduras e legumes devem ser lavados em água corrente e, em seguida, deixados de molho por 10 a 15 minutos em uma solução feita com cerca de 1 colher de sopa de água sanitária para cada litro de água. Orientar os estudantes quanto ao preparo correto dessa mistura e, se possível, realizar uma demonstração prática desse processo. Ressaltar que a limpeza adequada dos alimentos é essencial para a preservação da saúde, pois os alimentos in natura, como frutas, verduras e legumes, podem ser contaminados por microrganismos, parasitas e substâncias nocivas durante as etapas de plantio, cultivo e armazenamento.
PREVENÇÃO DE DOENÇAS CAUSADAS POR MICRORGANISMOS E VÍRUS
Algumas atitudes contribuem para a prevenção de doenças causadas por microrganismos e vírus. Conheça alguns exemplos a seguir.
IMAGENS FORA DE PROPORÇÃO. AS CORES NÃO SÃO REAIS.
Selecionar e higienizar os alimentos Evite alimentos com manchas ou que estejam murchos. No caso de alimentos crus, lave-os em água corrente e use produtos próprios para higienizá-los.

Ingerir água tratada e filtrada ou fervida A água para consumo deve ser, de preferência, tratada pela companhia de abastecimento. Depois, ela deve ser filtrada ou fervida.

Lavar as mãos As mãos devem ser lavadas com água e sabão, especialmente após usar o banheiro e antes de comer.


Enfatizar ainda que, para evitar infecções, é essencial ingerir apenas água tratada, filtrada ou fervida, para garantir que esteja livre de microrganismos prejudiciais à saúde.
| PARA O PROFESSOR
TEXTO. AGÊNCIA NACIONAL DE VIGILÂNCIA SANITÁRIA. Cartilha sobre boas práticas para serviços de alimentação 3. ed. Brasília, DF: Anvisa, 2004. Disponível
em: https://www.gov.br/anvisa/pt-br/cen traisdeconteudo/publicacoes/alimentos/ manuais-guias-e-orientacoes/cartilha -boas-praticas-para-servicos-de-alimenta cao.pdf. Acesso em: 6 ago. 2025.
Cartilha que aborda diversas condutas a serem adotadas para a correta higienização dos alimentos.
Criança lavando alimentos.
Criança se servindo de água tratada e filtrada.
Criança lavando as mãos.
Utilizar máscara de proteção facial
Utilizar máscara de proteção facial
Em ambientes públicos, fechados ou com muitas pessoas, o uso de máscara é importante porque evita a contaminação caso alguém tussa ou espirre. Ela reduz o risco de transmitir doenças a outras pessoas e de espalhar microrganismos e vírus no ambiente.
Em ambientes públicos, fechados ou com muitas pessoas, o uso de máscara é importante porque evita a contaminação caso alguém tussa ou espirre. Ela reduz o risco de transmitir doenças a outras pessoas e de espalhar microrganismos e vírus no ambiente.
PROSTOCK-STUDIO/SHUTTERSTOCK.COM


usando máscara dentro
Jovem usando máscara dentro de


Tomar vacina
Tomar vacina
As vacinas estimulam as defesas do corpo contra microrganismos e vírus que causam doenças. Para serem eficazes, as vacinas devem ser tomadas nas datas corretas, conforme indicado na carteira da vacinação.
As vacinas estimulam as defesas do corpo contra microrganismos e vírus que causam doenças. Para serem eficazes, as vacinas devem ser tomadas nas datas corretas, conforme indicado na carteira da vacinação.


Criança tomando vacina.
Criança tomando vacina.

Areia sendo colocada em vaso de planta.

Areia sendo colocada em vaso de planta.
Evitar focos de reprodução de mosquitos
Descartar corretamente os resíduos ajuda a evitar o acúmulo de água parada, assim como colocar areia em vasos de plantas. Essas atitudes ajudam a eliminar focos de reprodução do mosquito Aedes aegypti, por exemplo.
Evitar focos de reprodução de mosquitos Descartar corretamente os resíduos ajuda a evitar o acúmulo de água parada, assim como colocar areia em vasos de plantas. Essas atitudes ajudam a eliminar focos de reprodução do mosquito Aedes aegypti, por exemplo.
NÃO ESCREVA NO LIVRO.
VOCÊ ESCRITOR!
O acesso à saúde é um direito de todos. Mas a lei garante que crianças, adolescentes e pessoas idosas sejam atendidos primeiro. Isso está no Estatuto da Criança e do Adolescente (ECA) e no Estatuto da Pessoa Idosa. Esses direitos aparecem no dia a dia em ações como as campanhas de vacinação realizadas pelo governo.
Com a ajuda de um adulto da família, pesquise qual campanha de vacinação está acontecendo agora. Veja se você faz parte do grupo indicado e se já tomou a vacina.
Depois, em grupos, criem panfletos sobre essa campanha e compartilhem com a comunidade escolar.
Resposta pessoal. Orientar os estudantes a realizar a pesquisa, que pode ser feita no site da secretaria de saúde do município ou do estado, para verificar qual campanha de vacinação está em andamento. É importante
que confirmem com um adulto da família se já tomaram a vacina. Quanto aos panfletos, orientá-los a incluir as informações encontradas sobre a campanha, contribuindo para a conscientização da comunidade escolar. Se houver necessidade, a escola pode realizar uma campanha para as famílias. 37
ENCAMINHAMENTO
Destacar que o uso de máscara de proteção facial é essencial em situações de risco, especialmente durante surtos de doenças respiratórias. Se considerar oportuno, comentar que o uso de máscaras em ambientes públicos se tornou obrigatório durante um período da pandemia de covid-19, o que contribuiu para reduzir a circulação do vírus causador da doença. Explicar a importância das vacinas como aliadas da saúde pública, pois elas fortalecem o sistema imunitário e ajudam
a prevenir doenças, ou, ao menos, a manifestação de sintomas graves.
02/10/25 15:50
Reforçar o papel de cada um no combate à proliferação de mosquitos transmissores de doenças, como dengue, zika e chikungunya, por meio da eliminação de focos de água parada.
Retomar que as atitudes mencionadas fazem parte de nosso compromisso com a saúde individual e coletiva e são essenciais não apenas em momentos de emergência, mas devem ser incorporadas como hábitos permanentes de cuidado no dia a dia.
Reserve um momento da aula para que os estudantes elaborem os panfletos sobre a campanha de vacinação pesquisada. Eles devem destacar a importância da vacina, o público-alvo definido, o período de realização e onde as doses estão disponíveis.
Estimular a criatividade na escolha das mensagens, no uso de cores, desenhos e elementos visuais que ajudem a comunicar as informações de forma clara e atrativa para a comunidade escolar.
Ao incentivar o uso da linguagem para comunicar informações de maneira clara e criativa, a atividade contribui para o desenvolvimento da competência geral 4 e da competência específica 6 de Ciências da Natureza Além disso, por ser realizada em grupos, favorece o desenvolvimento da competência geral 9, relacionada ao exercício da empatia, ao diálogo e à cooperação. Por se tratar de uma ação coletiva responsável, também promove o desenvolvimento da competência geral 10 e da competência específica 8 de Ciências da Natureza.
A atividade propicia a integração com Língua Portuguesa, ao propor o trabalho com o gênero textual panfleto.
um ônibus.
ALEX ARGOZINO
Jovem
de um ônibus.
| ORIENTAÇÕES E RESPOSTAS
As atividades têm como objetivo levar os estudantes a retomar e consolidar os conhecimentos construídos ao longo do capítulo, além de mobilizar a habilidade EF04CI08, por meio da reflexão sobre atitudes de prevenção contra doenças causadas por microrganismos.
1. a) O cartaz convoca os moradores do bairro Jardim Alegre para fazerem um mutirão, ou seja, um trabalho voluntário em grupo, que tem por objetivo realizar ações para combater a dengue. Ele também indica o local e o horário que as pessoas deverão se encontrar.
b) Outras doenças transmitidas pelo mosquito
Aedes aegypti são zika e chikungunya, que não foram apresentadas na unidade. A febre amarela também é uma doença que pode ser transmitida por esse mosquito (apesar de não ocorrer transmissão desse tipo desde 1942), que será apresentada na seção Dialogando com Geografia
c) Resposta pessoal. Espera-se que os estudantes considerem ações que envolvam eliminar focos de reprodução do mosquito, como descartar corretamente resíduos, evitando seu acúmulo em espaços abertos; colocar areia em vasos de planta; limpar caixas-d’água regularmente.
Outras ações que podem ser citadas envolvem evitar o contato direto com mosquitos adultos, como usar repelentes e instalar telas em portas e janelas.
d) Resposta pessoal. Questione os estudantes sobre quais palavras ou elementos um cartaz assim poderia ter. Escreva na lousa essas ideias para que eles as utilizem como inspiração na composição do cartaz.
ATIVIDADES
Consultar orientações e respostas no Livro do Professor.
1. Observe a imagem do cartaz e responda às questões a seguir.

a) Qual é o objetivo do cartaz? Caso não conheça alguma palavra, faça uma pesquisa no dicionário para entender seu significado.
b) Que outras doenças o inseto mostrado no cartaz pode transmitir?
c) O que pode ser feito para prevenir as doenças transmitidas por esse inseto? Proponha ações que você possa adotar em sua residência.
d) No caderno, desenhe um cartaz que tenha o mesmo objetivo do ilustrado. Esse cartaz deve ser chamativo, atrair o interesse das pessoas e mostrar a importância da ação.
2. Copie as frases a seguir no caderno e relacione corretamente as doenças à ação que contribui para sua prevenção.
I. Amebíase.
II. Doença de Chagas.
III. Gripe.
IV. Leptospirose.
I-C; II-A; III-B; IV-D.
A. Manter as casas limpas, sem materiais acumulados onde o inseto transmissor pode se esconder.
B. Lavar as mãos com frequência e usar máscaras em locais fechados e com aglomeração.
C. Higienizar alimentos antes de ingeri-los e beber apenas água tratada e filtrada ou fervida.
D. Evitar o contato direto com água de inundações.
ATIVIDADES FAMÍLIA
Explicar aos estudantes que, no Brasil, a vacinação de crianças e adolescentes é obrigatória e fundamental para prevenir diversas doenças. Solicitar que, com o apoio de um adulto responsável, consultem a carteira de vacinação e realizem juntos uma pesquisa sobre as vacinas indicadas para a faixa etária em que se encontram. Se possível, associe esta atividade à indicada na seção Você escritor! da página anterior.
Orientá-los a verificar quais vacinas já foram tomadas e quais ainda estão previstas para os próximos anos. Incentivar a anotação dessas informações em um registro simples, como uma tabela ou um pequeno texto. Ao final, conversar com a turma sobre a importância da vacinação para a saúde individual e coletiva. Uma sugestão de fonte de pesquisa para a realização desta atividade é o Calendário de Vacinação brasileiro, disponível em: https://www.gov.br/saude/ pt-br/vacinacao/calendario (acesso em: 6 ago. 2025).
NÃO ESCREVA NO LIVRO.
VOCÊ CIDADÃO!
Mulheres na ciência
Ao longo da história, diversos cientistas dedicaram a vida a estudar os microrganismos e os vírus. Esses estudos permitiram o avanço na prevenção, no diagnóstico e no tratamento de muitas doenças. A seguir, você conhecerá as contribuições trazidas pelo trabalho de três mulheres cientistas.
• Danielle Maria Nascimento Moura (1991-): biomédica brasileira que estuda o protozoário causador da doença de Chagas. Seus estudos contribuem para o combate dessa e de outras doenças.
• Jandyra Planet do Amaral (1905-2010): médica brasileira que contribuiu para a produção de vacinas contra diversas doenças, inclusive a varíola, que foi erradicada no Brasil.
• Viviane Maimoni Gonçalves (1970-): farmacêutica brasileira que participa de um projeto para desenvolver uma vacina inalatória contra a pneumonia.
3. Resposta pessoal. Os estudantes podem procurar informações sobre a cientista e qual resultado ela obteve para determinada doença causada por microrganismos ou vírus. Separar um momento para que os resultados sejam apresentados em sala.

Erradicada: eliminada. Inalatória: que pode ser absorvida pelo nariz, inalada.
Campanha Mulheres Negras na Ciência do Núcleo de Diversidade e Inclusão da Fundação Oswaldo Cruz (Fiocruz) Pernambuco.
1. O trabalho dessas cientistas contribuiu para a prevenção e a cura de doenças, melhorando a saúde de diversas pessoas.
1. De que forma o trabalho dessas cientistas impacta a saúde das pessoas?
2. No passado, a presença de mulheres na ciência era bem menor. Além disso, seu trabalho era pouco divulgado. Em sua opinião, qual é a importância de incentivar meninas e mulheres a seguir carreiras profissionais na ciência?
3. Em grupos, façam uma pesquisa em livros ou na internet, com o auxílio do professor, sobre outras cientistas que realizaram estudos voltados à prevenção e ao tratamento de doenças. Compartilhem os resultados encontrados com os demais grupos. Deem preferência a cientistas do estado onde vocês vivem, valorizando o trabalho científico local.
2. Resposta pessoal. Conduzir uma conversa para que os estudantes percebam a importância de incentivar meninas e mulheres a seguir carreiras científicas, já que todos devem ter as mesmas oportunidades de aprender, pesquisar e descobrir coisas novas, contribuindo para a sociedade.
VOCÊ CIDADÃO!
Ao longo da história, diversos cientistas dedicaram a vida ao estudo dos microrganismos e dos vírus, contribuindo significativamente para a prevenção e o tratamento de doenças, além de promoverem avanços importantes na saúde pública. Nesse contexto, é fundamental destacar o papel de mulheres cientistas que, muitas vezes enfrentando barreiras sociais e institucionais, deixaram um legado essencial para o desenvolvimento da ciência. A reflexão sobre relações do mundo do trabalho
permite a abordagem do Tema Contemporâneo Transversal (TCT) Trabalho de forma crítica.
02/10/25 15:50
Se julgar oportuno, apresentar mais informações sobre as cientistas:
• Danielle Maria Nascimento Moura (1991-) é doutora em Genética pela Universidade Federal de Pernambuco (UFPE), com pós-doutorado no Brasil e na University of Cambridge. Pesquisadora em saúde pública na Fiocruz Pernambuco, investiga a biologia molecular de parasitas e os mecanismos de regulação gênica, contribuindo para
o avanço no estudo de doenças tropicais negligenciadas.
• Jandyra Planet do Amaral (1905-2010) foi uma das primeiras cientistas mulheres a atuar no Instituto Butantan. Pesquisadora brasileira, teve papel fundamental na produção da vacina BCG em escala industrial nos anos 1970, contribuindo para o combate à tuberculose no Brasil. Sua atuação destaca a importância da ciência nacional e da presença feminina em instituições científicas de prestígio.
• Viviane Maimoni Gonçalves (1970-), pesquisadora brasileira da atualidade, é especialista em microbiologia e desenvolve estudos relevantes sobre a produção de vacinas. Sua atuação reforça a importância da continuidade da pesquisa científica e da formação de novos profissionais comprometidos com a saúde pública.
A trajetória dessas cientistas inspira novas gerações a reconhecer o papel das mulheres na ciência, incentivando o combate a preconceitos e a promoção da equidade de gênero. Também colabora para o entendimento de que a pesquisa é um caminho essencial para enfrentar desafios sanitários e melhorar a qualidade de vida das populações.
Se considerar pertinente, as informações pesquisadas podem ser apresentadas em um seminário.
NÃO ESCREVA NO LIVRO.
Esta seção estabelece uma relação entre os Temas Contemporâneos Transversais (TCTs) Educação ambiental e Saúde , ao apresentar o impacto da degradação do ambiente na saúde das pessoas, utilizando a febre amarela como exemplo.
Esse conteúdo oportuniza reflexões sobre os impactos do desmatamento, que podem aumentar o risco de contato entre pessoas e animais silvestres transmissores de doenças. Também é uma oportunidade para abordar a importância da preservação ambiental como forma de proteger a saúde coletiva.
É importante destacar que a febre amarela apresenta dois ciclos de transmissão: urbano e silvestre. No ciclo urbano, ela é transmitida pela picada do mosquito Aedes aegypti contaminado, que também transmite outras doenças, como a dengue, já estudada na unidade.
No ciclo silvestre, que é o foco da seção, a transmissão ocorre por meio de mosquitos dos gêneros Haemagogus e Sabethes, que habitam áreas de mata. Os macacos são infectados ao serem picados por esses mosquitos. Mas o ser humano pode ser infectado acidentalmente ao adentrar ou residir em áreas florestais onde circula o vírus, sendo também picado pelos mosquitos vetores contaminados. Esse é o ciclo responsável pelos casos atuais de febre amarela no país, segundo dados do Ministério da Saúde.
Recentemente, foram registrados crimes ambientais que resultaram na morte de grupos de macacos, motivados pela equivocada ideia de que
DIALOGANDO GEOGRAFIA COM
PROTEGER AS FLORESTAS É CUIDAR DA SAÚDE!
Você já sabe que proteger as florestas é importante para cuidar dos seres vivos. Mas sabia que isso também ajuda a cuidar da saúde das pessoas?
Nas florestas vivem muitos animais que podem transmitir doenças. Quando as florestas são destruídas para construir estradas e moradias, esses animais perdem o lugar onde vivem e acabam se aproximando das pessoas. Além disso, os seres humanos também podem viver perto das florestas e ter contato com esses animais. Essas situações aumentam o risco de algumas doenças se espalharem com mais facilidade.
Um exemplo é a febre amarela. Essa doença pode ocorrer em áreas de floresta, onde vivem os mosquitos que transmitem o vírus.

1. Quando mosquitos picam macacos contaminados com os vírus, eles também ficam contaminados.
2. Ao picarem outros macacos, passam o vírus para eles.
3. Quando as pessoas entram em áreas de florestas ou moram perto de lugares desmatados, podem ser picadas por mosquitos contaminados e desenvolver a febre amarela.
Representação esquemática da transmissão da febre amarela.
Elaborada com base em: DEGRADAÇÃO ambiental também pode estar relacionada ao surto de febre amarela. UFMG Manuelzão, Belo Horizonte, 18 jan. 2018. Disponível em: https://manuelzao.ufmg.br/ degradacao-ambiental-tambem-pode-estar-relacionada-ao-surto-de-febre-amarela. Acesso em: 27 jun. 2025.
Por isso, é muito importante cuidar das florestas. Quando protegemos a natureza, evitamos que os animais silvestres se aproximem das pessoas e que doenças, como a febre amarela silvestre, se espalhem.
Os macacos não transmitem a febre amarela diretamente às pessoas, mas são importantes como alerta de que o vírus está circulando naquela região.
esses animais seriam responsáveis pela transmissão de doenças aos seres humanos. É fundamental ressaltar que os macacos não transmitem a febre amarela para as pessoas. Eles também são vítimas da doença e podem indicar a circulação do vírus na região, alertando as autoridades de saúde para a necessidade de ações preventivas, como a vacinação da população.
Aproveitar a oportunidade e propor uma reflexão sobre a importância da conservação das florestas e da fauna local, colaborando para a cosciência ambiental dos estudantes. Essa abordagem previne
interpretações equivocadas, como a ideia de que o desmatamento ou a eliminação de animais seja uma solução para combater doenças.
Também destacar que a vacinação contra a febre amarela é uma importante medida de prevenção contra a doença. No Brasil, desde 2017, ela é administrada em dose única, com proteção válida por toda a vida, conforme a recomendação da Organização Mundial da Saúde (OMS). Se julgar oportuno, orientar os estudantes a conversar com seus familiares ou responsáveis para verificar se todos já
IMAGENS
1. No esquema, as setas 1 e 3 representam o caminho que o vírus realiza do macaco até o ser humano. Qual o papel do mosquito na transmissão do vírus?
O mosquito é o responsável pela transmissão do vírus, pois, ao picar o macaco contaminado, ele também se contamina com o vírus e o transmite a outros macacos e ao ser humano ao picá-los.
2. Observe a fotografia a seguir.
2. a) A fotografia mostra casas muito próximas a uma floresta. Isso pode facilitar a transmissão de doenças porque os animais que vivem na mata, como os mosquitos, podem picar e contaminar as pessoas.
Consultar orientações no Livro do Professor

2. b) Manter a floresta protegida, evitando o desmatamento e planejando bem onde as casas e ruas serão construídas. Assim, os animais permanecem no seu ambiente e o risco de doenças diminui.
Moradias próximo à floresta em Manaus, Amazônia, 2025.
a) Segundo o texto, qual problema pode acontecer na região mostrada na fotografia?
b) O que poderia ser feito para diminuir esse risco e cuidar da saúde das pessoas?
3. Leiam o texto a seguir.
A vacina é a principal ferramenta de prevenção da febre amarela. O Sistema Único de Saúde (SUS) oferta vacina contra febre amarela para toda população.
[...]
A vacinação para febre amarela é ofertada na rotina em todos municípios do país.
BRASIL. Ministério da Saúde. Prevenção. Brasília, DF, [20--]. Disponível em: https://www.gov.br/ saude/pt-br/assuntos/saude-de-a-a-z/f/febre-amarela/prevencao. Acesso em: 11 jul. 2025.
a) Qual forma de prevenção à febre amarela é citada no texto? Por que ela é importante?
A vacinação. As vacinas estimulam as defesas do corpo contra o vírus que causa a febre amarela, evitando a manifestação da doença.
b) Com a ajuda de um adulto, façam uma pesquisa para identificar, no município onde vocês vivem, o órgão do governo responsável por organizar ações relacionadas a essa forma de prevenção.
estados, organizando as campanhas de vacinação.
O Ministério da Saúde, do governo federal, atua junto às secretarias de saúde dos municípios e dos PARA VOCÊ EXPLORAR
Converse com o professor sobre a possibilidade de visitar um posto de saúde ou a secretaria de saúde do município ou da região onde vocês moram. Elaborem algumas perguntas a serem feitas para os servidores sobre as vacinas.
foram vacinados, reforçando a importância do autocuidado e da prevenção.
Caso promova a visita sugerida no boxe Para você explorar, conversar antes com os estudantes sobre comportamentos adequados na secretaria de saúde, tanto para evitar transtornos das pessoas que trabalham no local como para garantir a segurança dos estudantes. É fundamental também ter a autorização dos responsáveis pelos estudantes e da direção da escola antes da visita e ter um planejamento e uma organização adequados visando garantir a segurança de todos.
| PARA O ESTUDANTE
02/10/25 15:50
FILME. OS SEM-FLORESTA. Direção: Tim Johnson; Karey Kirkpatrick. Estados Unidos: DreamWorks, 2006. (83 min).
Filme que conta a história de um grupo de animais que passa a conviver próximo aos seres humanos depois de a floresta em que viviam ter sido cercada por construções.
|
PARA O PROFESSOR
TEXTO. BRASIL. Ministério da Saúde. Febre amarela. Gov.br, c2025. Disponível
em: https://www.gov.br/ saude/pt-br/assuntos/sau de-de-a-a-z/f/febre-amare la. Acesso em: 6 ago. 2025. O texto traz informações sobre a febre amarela.
ATIVIDADES
Organizar a turma em grupos e orientar cada grupo a fazer um cartaz destacando a necessidade de proteger os recursos naturais, assim como a relação entre a conservação ambiental e a saúde da população, conforme estudado na seção. Promover a exposição dos cartazes na escola para incentivar a conscientização ambiental da comunidade escolar.
| ORIENTAÇÕES E RESPOSTA
2. Esta atividade promove uma integração com Geografia, ao ressaltar a importância da vacinação contra a febre amarela, uma ação regulamentada por órgãos do poder público. No item b, especificamente, aborda-se a habilidade desse componente indicada a seguir.
• EF04GE03 : Distinguir funções e papéis dos órgãos do poder público municipal e canais de participação social na gestão do Município, incluindo a Câmara de Vereadores e Conselhos Municipais.
Essa abordagem também contempla o Tema Contemporâneo Transversal (TCT) Saúde, ao promover a compreensão de que a vacinação depende da atuação articulada de políticas públicas.
ORGANIZANDO IDEIAS
Esta seção tem como objetivo retomar os conteúdos estudados na unidade a partir da interpretação de um esquema que possibilita a visualização de como as informações estão conectadas umas às outras.
Sugere-se um momento inicial no qual os estudantes sejam incentivados a relembrar os principais conceitos trabalhados nos capítulos que constituem a unidade – como microrganismos, vírus, doenças, transmissão, prevenção, vacinas. Registrar os termos citados pelos estudantes na lousa. Em seguida, orientá-los a interpretar o esquema visual apresentado no livro. Pedir que analisem quais dos termos citados por eles estão presentes no esquema e como esses conceitos estão conectados entre si. Por fim, solicitar que expliquem, com base em suas compreensões, as relações representadas no esquema, favorecendo a reflexão sobre o conteúdo estudado e as conexões entre os conceitos.
Para ampliar a atividade, propor aos estudantes que elaborem um mapa conceitual próprio, com base em outras conexões que eles mesmos podem estabelecer. Nesse caso, orientá-los a organizar os conceitos a partir de uma ideia central e conectá-la a outros termos relacionados. É importante que as conexões tragam termos ou frases que expressem a relação estabelecida. Esta atividade pode ser realizada individualmente ou em grupos, utilizando cartolinas, folhas de papel sulfite ou recursos digitais. Circular pela sala de aula, auxiliando os estudantes
ORGANIZANDO IDEIAS
Nesta unidade, estudamos os microrganismos e suas relações com o ambiente e a sociedade. Analise o esquema a seguir para relembrar esses assuntos.
MICRORGANISMOS
podem ser vistos com auxílio de
MICROSCÓPIOS
PROTOZOÁRIOS podem ser
BACTÉRIAS
FUNGOS
ALGAS
VACINAS MEDICAMENTOS ALIMENTAÇÃO
COMBUSTÍVEIS
podem ser usados em podem causar
DOENÇAS
IMAGENS FORA DE PROPORÇÃO. AS CORES NÃO SÃO REAIS. que podem ser evitadas ao
com sugestões e esclarecendo dúvidas deles sobre os conteúdos.
Ao final, reservar um momento para que os grupos compartilhem seus mapas com a turma, permitindo a troca de ideias e o reforço das conexões construídas. Essa estratégia contribui para o desenvolvimento do pensamento crítico, da capacidade de síntese e da organização das informações de forma significativa. Além disso, o mapa criado pelos estudantes pode constituir um instrumento de avaliação do aprendizado.
LAVAR AS MÃOS
SELECIONAR E HIGIENIZAR ALIMENTOS
USAR MÁSCARA FILTRAR/FERVER ÁGUA
NÃO DEIXAR ÁGUA PARADA
TOMAR VACINA
RETOMANDO
1 Uma professora coletou uma amostra da água de um rio e a observou ao microscópio com sua turma. Os estudantes perceberam que havia grande quantidade de um mesmo microrganismo. Sem revelar o nome, a professora disse que esse microrganismo vive em ambientes aquáticos e libera gás oxigênio para o ambiente. Ela também informou que, apesar de eles estarem observando exemplos microscópicos, há outros exemplos desses seres vivos que podem ser vistos a olho nu. Qual tipo de ser vivo foi descrito pela professora?
Algas.
2 O kefir é um alimento produzido a partir do leite pela ação de microrganismos, como bactérias e leveduras fermentadoras, que vivem em pequenos grãos. Ao serem adicionados ao leite, esses microrganismos realizam a fermentação, transformando o leite em kefir de forma natural.
Consultar orientações no Livro do Professor.
a) Quais microrganismos são citados no texto?
Bactérias e leveduras (fungos).
b) Qual processo é realizado pelos microrganismos para a produção de kefir natural? Explique esse processo.

3 Observe as imagens para responder às questões a seguir.
Consultar orientações e respostas no Livro do Professor
1 2


a) Qual atitude está representada na imagem 1? Quais doenças podem ser evitadas ao adotar essa atitude?
b) Qual atitude está representada na imagem 2? Quais doenças podem ser evitadas ao adotar essa atitude?
2. b) A fermentação. Nesse processo, os microrganismos fermentadores consomem certos ingredientes dos alimentos, como os açúcares, produzindo outras substâncias. Nesse caso, consomem os açúcares presentes no leite, transformando-o em kefir
RETOMANDO
Esta seção tem como propósito a retomada dos conteúdos estudados na unidade. Também propicia ao docente a avalição do aprendizado dos estudantes.
A avaliação da aprendizagem é uma etapa importante, pois possibilita acompanhar o desenvolvimento da turma, ajudando a reconhecer progressos e a identificar eventuais desafios de aprendizagem. Com base nisso, fazer os devidos ajustes no planejamento e nas estratégias pedagógicas, de modo a atender melhor às necessidades dos estudantes.
partilhar seus pontos de vista, promovendo o diálogo, a escuta ativa e a construção coletiva do conhecimento.
| ORIENTAÇÕES E RESPOSTAS
2. Esta atividade promove o desenvolvimento da habilidade EF04CI07, relacionada à verificação de aplicações dos microrganismos.
3. a) A imagem 1 representa uma pessoa higienizando frutas e verduras. A higienização de alimentos é uma atitude que evita a transmissão de doenças, como a cólera e a amebíase, por meio da ingestão de alimentos contaminados.
b) A imagem 2 representa uma pessoa colocando areia em um vaso de plantas, evitando água parada. Essa atitude auxilia no combate aos focos de reprodução do mosquito Aedes aegypti, evitando a transmissão da dengue. Esta atividade promove o desenvolvimento da habilidade EF04CI08, relacionada à proposição de atitudes de prevenção contra doenças causadas por microrganismos.
| PARA O PROFESSOR
02/10/25 15:50
Listas de atividades são apenas um dos instrumentos avaliativos que podem ser utilizados nesse processo. Ao longo deste Livro do Professor, outras sugestões foram apresentadas em diferentes momentos das orientações específicas. Outros instrumentos também podem ser consultados na página XXIX da Parte Geral deste Livro do Professor. Garantir que os estudantes tenham tempo suficiente para realizar as tarefas de forma individual, favorecendo a concentração e a autonomia no processo. Na sequência, organizar uma roda de conversa para que os estudantes possam
TEXTO. SILVA, José Luis P. B.; MORADILLO, Edilson Fortuna. Avaliação, ensino e aprendizagem de ciências. Ensaio: Pesquisa em Educação em Ciências, Belo Horizonte, v. 4, n. 1, p. 28-39, jul. 2002. Disponível em: https://www.researchgate. net/publication/299522476_ Avaliacao_ensino_e_aprendizagem_de_ciencias/ fulltext/570e8d0008ae d4bec6fddf56/Avaliacao -ensino-e-aprendizagem -de-ciencias.pdf. Acesso em: 6 ago. 2025.
Artigo que discute a avaliação escolar como um componente do processo educativo que tem como finalidade orientar o ensino e a aprendizagem das ciências.
Grãos de kefir
INTRODUÇÃO À UNIDADE
Esta unidade aborda diferentes aspectos das relações alimentares entre os seres vivos. Inicialmente, são apresentados os diferentes tipos de alimentação dos animais, com destaque para sua classificação em carnívoros, herbívoros e onívoros. Também é explorado o processo de fotossíntese, por meio do qual as plantas produzem o próprio alimento. Adiante, exploram-se as interações nas cadeias alimentares, destacando a ciclagem da matéria e o fluxo de energia. Por fim, são apresentados exemplos de cadeias alimentares em ecossistemas brasileiros e discutidas ações humanas que podem interferir no equilíbrio delas.
HABILIDADES
• EF04CI04
• EF04CI05
• EF04CI06
OBJETIVOS DE APRENDIZAGEM
• Descrever os hábitos alimentares de diferentes animais.
• Classificar os animais em carnívoros, herbívoros e onívoros.
• Explicar o processo de fotossíntese e sua importância na produção de alimento pelas plantas.
• Reconhecer a posição ocupada pelos seres vivos nas cadeias alimentares, diferenciando produtores, consumidores e decompositores.
• Construir cadeias alimentares com base na análise dos hábitos alimentares de diferentes seres vivos.
• Justificar a importância do papel ambiental dos decompositores em relação à ciclagem da matéria.
UNIDADE
2
OS SERES VIVOS E SUAS RELAÇÕES
Os seres vivos se relacionam de muitas maneiras, tanto entre si quanto com o ambiente onde vivem. Essas relações são importantes para a sobrevivência e para a manutenção do equilíbrio ambiental, ou seja, das condições naturais do ambiente que permitem a vida.
Nesta unidade, vamos conhecer exemplos dessas relações que envolvem a alimentação. Ao entender como os seres vivos se alimentam e se organizam na natureza, podemos aprender mais sobre a vida ao nosso redor e sobre a importância de cuidar do ambiente e de todos os seres vivos que fazem parte dele.
Representação de algumas relações que animais tem entre si e com o ambiente.


gia primária das cadeias alimentares.
• Explicar o fluxo de energia ao longo das cadeias alimentares.
• Comparar o ciclo da matéria e o fluxo de energia nas cadeias alimentares, identificando semelhanças e diferenças entre esses processos.
• Definir ecossistemas.
• Identificar cadeias alimentares de diferentes ecossistemas brasileiros.
• Analisar os impactos causados por atividades humanas nas cadeias alimentares.
A imagem apresentada na abertura da unidade retrata uma paisagem típica do bioma Pampa e destaca alguns dos seres vivos que habitam essa região. Incentivar os estudantes a observar atentamente a imagem e a descrever o que veem, refletindo sobre os animais, suas ações e o ambiente retratado. Alguns questionamentos podem ajudar nesse processo:
• O que está acontecendo na cena?
• Que animais aparecem na imagem? O que eles estão fazendo?
Coruja-buraqueira.
Tuco-tuco.

03/10/25 21:02

gere-se organizar uma roda de conversa destinada à verificação das concepções prévias dos estudantes. Essa etapa é fundamental para compreender o que a turma já sabe sobre os processos que envolvem as relações alimentares entre os seres vivos. Nesse processo, além de realizar as atividades indicadas, é possível aproveitar a cena representada na imagem para propor outras perguntas que estimulem os estudantes a observar as relações representadas e a refletir sobre elas. Por exemplo:
• Que fatores são necessários para que as gramíneas e as outras plantas presentes na imagem obtenham alimento?
• Que relação as plantas têm com os animais?
• Quais das relações mostradas na imagem envolvem alimentação e como podemos representá-las em um esquema visual?
Essas perguntas incentivam os estudantes a observar com atenção, desenvolver a oralidade e construir o conhecimento de forma ativa.
Se considerar interessante, solicitar aos estudantes que registrem suas respostas iniciais no caderno. Posteriormente, durante o estudo da unidade, retomar as perguntas e pedir a eles que analisem suas respostas, como maneira de avaliar a construção do aprendizado.
ENCAMINHAMENTO
Para iniciar a abordagem do capítulo, pedir aos estudantes que identifiquem o que seria o coprólito (fezes fossilizadas) pela observação das imagens da página. Essa abordagem pode ajudar a despertar a curiosidade e o interesse da turma. Aproveitar a oportunidade para discutir como vestígios orgânicos preservados, como os coprólitos, são fontes valiosas de informação para a ciência.
Definir fóssil como o resto ou a impressão deixada por um organismo que viveu há muito tempo, como ossos, penas, pegadas ou rastros, geralmente preservados em rochas.
Aproveitar o momento para explorar outras temáticas com os estudantes, questionando-os:
• O texto menciona algumas profissões, como paleontólogos, veterinários e biólogos. Vocês já ouviram falar desses profissionais? Sabem o que eles fazem?
Ao levantar questões como essa, promove-se a reflexão crítica sobre a produção de conhecimentos científicos, trabalhando os Temas Contemporâneos Transversais (TCTs) Trabalho e Ciência e tecnologia
Após a leitura coletiva do texto, organizar um tempo e um espaço adequados para que os estudantes realizem, oralmente, as atividades propostas na página. Em seguida, promover uma roda de conversa para que a turma compartilhe suas observações e respostas, trocando ideias e ampliando a compreensão sobre o conteúdo abordado. Esse momento permite aos estudantes desenvolver as habilidades de Língua Portuguesa indicadas a seguir.
• EF15LP09: Expressar-se em situações de intercâmbio oral com clareza,
A ALIMENTAÇÃO DOS
ANIMAIS E DAS
Você sabe o que é um coprólito?
PLANTAS
Esse estranho nome se refere às fezes de um animal que viveu há muito tempo no planeta Terra e que, devido a diversos processos naturais, foram preservadas no ambiente.

Representação de um tiranossauro rex.

Fotografia do maior coprólito já identificado, originado de um tiranossauro rex.
Os paleontólogos, cientistas que estudam os seres vivos de outras épocas, podem encontrar informações importantes nos coprólitos. Por exemplo, é possível saber o tamanho do animal e o que ele comia.
Nos Estados Unidos, há um museu que guarda o maior coprólito do mundo. Ele mede 44 centímetros de comprimento, pesa mais de 9 quilogramas e foi produzido no passado por um dinossauro, mais precisamente um tiranossauro rex.
A análise de fezes de animais atuais também é realizada por veterinários, biólogos e outros profissionais, fornecendo informações sobre a saúde do animal, como a presença de parasitas, sangue, entre outros. Eles conseguem até mesmo identificar seus hábitos alimentares.
3. Respostas pessoais. Verificar o conhecimento dos estudantes sobre as plantas produzirem o próprio alimento na presença de luz solar.
1. Conforme as informações do texto, o que os cientistas podem descobrir ao estudar coprólitos ou fezes de um animal?
O tamanho do animal, de que ele se alimenta, seu estado de saúde, entre outras informações.
NÃO ESCREVA NO LIVRO.
2. Imagine que, durante a análise das fezes de um animal, foram encontrados restos de plantas. Com base nesse resultado, seria possível afirmar que esse animal é exclusivamente herbívoro? Explique sua resposta.
3. No caso dos animais, é possível saber o que eles comem. Mas e as plantas? Como você acha que elas conseguem o alimento de que precisam para se desenvolver?
2. Não. Encontrar restos de plantas nas fezes mostra que o animal se alimentou de plantas, mas isso não significa que ele seja exclusivamente herbívoro. Ele pode ser um animal onívoro, que come tanto plantas quanto outros animais.
preocupando-se em ser compreendido pelo interlocutor e usando a palavra com tom de voz audível, boa articulação e ritmo adequado.
• EF15LP10: Escutar, com atenção, falas de professores e colegas, formulando perguntas pertinentes ao tema e solicitando esclarecimentos sempre que necessário.
| PARA O ESTUDANTE
ÁUDIO. COPRÓLITOS: o cocô contando história. [Locução de]: Enise Silva e Catarina Barata. Belo Horizonte: Ciência no Ar, 2015.
Disponível em: https://www.ufmg.br/cien cianoar/conteudo/coprolitos-o-coco-con tando-historia/. Acesso em: 16 ago. 2025.
O áudio Coprólitos: o cocô contando história, escrito por Bárbara Maia e publicado no portal Ciência no Ar, programa de extensão da Universidade Federal de Minas Gerais (UFMG), aborda, de forma acessível e envolvente, um tema curioso da paleontologia: os coprólitos, fezes fossilizadas que ajudam cientistas a reconstruir hábitos alimentares e comportamentos de animais pré-históricos, além dos ecossistemas de que participavam.
ALIMENTAÇÃO DOS ANIMAIS
Para crescer, se desenvolver e realizar suas atividades, como caçar, fugir de situações de perigo ou ameaças, além de se reproduzir, os animais, incluindo os seres humanos, precisam de energia. Eles obtêm nos alimentos a energia de que precisam.
Como você já estudou, os animais podem ser classificados, de acordo com o tipo de alimento que consomem, em carnívoros, herbívoros ou onívoros.
A ariranha é um animal carnívoro, que se alimenta exclusivamente de outros animais, como peixes.


A arara-canindé é um animal herbívoro, que se alimenta exclusivamente de plantas ou partes delas, como frutos e sementes.
A ema é um animal onívoro, que se alimenta de animais, como insetos, lagartixas e rãs, e partes de plantas, como folhas, frutos e sementes.

ATIVIDADES
• Leia o texto a seguir e responda às questões.
ESCREVA NO LIVRO.
O gafanhoto vive em áreas com vegetação e se alimenta de folhas e outras partes das plantas. O quati costuma procurar alimento no chão da mata. Ele come frutas, ovos e pequenos animais, como os gafanhotos. A sucuri vive perto de rios e se movimenta silenciosamente para capturar animais, incluindo o quati.
1. Classifique os animais citados no texto como carnívoros, herbívoros e onívoros.
A sucuri é carnívora, o gafanhoto é herbívoro e o quati é onívoro.
2. Os seres vivos citados no texto apresentam relações alimentares entre si. No caderno, desenhe como você poderia representar essas relações. Elas devem ser representadas em um único desenho.
Resposta pessoal. No primeiro momento, espera-se que os estudantes identifiquem as relações alimentares descritas separadamente: planta gafanhoto; gafanhoto quati; quati sucuri. A partir dessa identificação, espera-se que representem essas relações por meio de um desenho único.
ENCAMINHAMENTO
A temática alimentação dos animais foi estudada em anos anteriores, durante o trabalho com a habilidade EF03CI04 Agora, faz-se necessária a retomada desse conteúdo, de modo que possa ser aprofundado durante o estudo das cadeias alimentares – que será feito adiante nesta unidade.
Para esse momento de retomada, sugere-se fazer algumas perguntas diagnósticas, como:
• Quais são os diferentes tipos de alimento que os animais consomem?
• Vocês se lembram do que é um animal carnívoro? E um herbívoro?
• Como podemos identificar se um animal é onívoro?
• Vocês conseguem dar exemplos de animais carnívoros, herbívoros e onívoros?
Avaliar as respostas dos estudantes para fazer ajustes no planejamento, se necessário, garantindo que a turma esteja preparada para avançar no estudo das cadeias alimentares.
Se considerar oportuno, é possível destacar que os animais são chamados de heterotróficos, pois obtêm energia ao se alimentarem de outros seres vivos.
| PARA O ESTUDANTE
LIVRO. LALAU; LAURABEATRIZ. Brasileirinhos. São Paulo: Companhia das Letrinhas, 2017.

Reprodução da capa.
Livro com poemas sobre diferentes animais brasileiros e seus hábitos alimentares.
NÃO
GILBERT
VOCÊ CIDADÃO!
A seção apresenta animais sinantrópicos, isto é, que vivem próximo aos seres humanos sem ser domesticados. Esses animais, como ratos, baratas, pombos, moscas, mosquitos, pulgas, formigas e cupins, beneficiam-se dos resíduos e abrigos que encontram nas áreas urbanas.
Apesar de comuns, muitos deles podem representar riscos à saúde, sendo importantes para discussões sobre higiene, descarte de lixo e cuidados com o ambiente. Nesse sentido, a temática da seção relaciona os Temas Contemporâneos Transversais (TCTs) Saúde e Educação ambiental.
| ORIENTAÇÕES E RESPOSTAS
1. Pragas urbanas são animais que vivem nas cidades, alimentam-se de uma variedade de alimentos – incluindo restos deixados pelos seres humanos – e podem transmitir doenças.
2. Respostas pessoais. Espera-se que os estudantes reconheçam que alimentos desperdiçados, especialmente quando descartados de forma inadequada, atraem diversos animais considerados pragas urbanas, como ratos, baratas e pombos, que os consomem. Esses animais se proliferam com mais facilidade quando encontram alimento disponível nos ambientes urbanos, o que pode aumentar os riscos à saúde das pessoas.
3. Resposta pessoal. Espera-se que os estudantes indiquem atitudes como não alimentar esses animais (como os pombos), não deixar alimentos expostos, manter as lixeiras sempre bem fechadas e não jogar restos de alimento
VOCÊ CIDADÃO!
Pragas urbanas
Se você caminhar pelas ruas de uma cidade, provavelmente vai observar diferentes animais em vários lugares. Alguns deles se aproveitam das atividades humanas para conseguir abrigo e alimento. É o caso de ratos, pombos e baratas.
Alguns desses animais são onívoros e se alimentam de grande variedade de alimentos, incluindo restos deixados por seres humanos. Por isso, é comum encontrá-los em busca de alimento em lixeiras mal fechadas, em praças e ruas em que há restos de comida ou em locais onde o lixo é jogado de forma incorreta.
Esses animais são considerados pragas urbanas e oferecem riscos à saúde das pessoas e de outros animais, pois podem transmitir doenças. Por isso, é muito importante que as pessoas façam sua parte para manter a cidade limpa. Descartar os resíduos no lugar certo, manter lixeiras bem fechadas e evitar o acúmulo de restos de comida em locais públicos são atitudes simples, mas que fazem muita diferença.

Consultar orientações e respostas no Livro do Professor
1. Segundo texto, o que são pragas urbanas?
2. Leia a frase a seguir.
O desperdício de alimentos pode causar o aumento de pragas urbanas.
• Você concorda com a frase? Por quê?
3. Forme uma dupla com um colega para conversar sobre o que é possível fazer para evitar o contato com as pragas urbanas e o aumento da presença delas no dia a dia.
nas ruas, nas praças ou na escola. Outras ações envolvem embalar corretamente os resíduos e não os descartar em locais irregulares.
| PARA O PROFESSOR
TEXTO. SILVA, Elisabete Aparecida da et al. Animais sinantrópicos: manual do educador: como prevenir. São Paulo: Secretaria Municipal de Saúde da Cidade de São Paulo, [20--?]. Disponível em: https:// www.prefeitura.sp.gov.br/cidade/secreta rias/upload/Sinantropicos_1253903561. pdf. Acesso em: 8 ago. 2025.
Manual com exemplos de animais sinantrópicos presentes nas áreas urbanas, destacando seus hábitos, ciclo de vida e importância médica, além de medidas sanitárias e ações preventivas que contribuem para o controle dessas espécies e a convivência segura com elas.
NÃO ESCREVA NO LIVRO.
Pombos ciscam restos de alimento em calçada. Brasília (DF), 2019.
ALIMENTAÇÃO DAS PLANTAS
As plantas obtêm alimento de forma diferente dos animais. Para começar a entender como isso acontece, realize a atividade a seguir.
VOCÊ CIENTISTA!
As plantas e a luz solar
O que acontece com uma planta que não recebe luz do Sol? Forme um grupo com três colegas. Anotem no caderno suas ideias sobre o assunto.
DO QUE EU PRECISO
• 2 recipientes plásticos
• Solo fértil, com adubo
• Água
1. Resposta pessoal. É esperado que a planta que ficou dentro da caixa esteja menos desenvolvida que a outra, ou até mesmo morta.
• 2 plantas jovens iguais
• Caixa de papelão grande
COMO FAZER IMAGENS FORA DE PROPORÇÃO.
1. Coloquem solo até a metade dos recipientes plásticos. Em seguida, plantem uma muda em cada um deles e completem com solo.
2. Reguem as mudas com um pouco de água.
3. Coloquem um dos recipientes em um local com acesso à luz solar. O outro recipiente deve ser colocado dentro da caixa de papelão fechada.
4. Reguem as mudas com a mesma quantidade de água a cada 2 dias. Depois de uma semana, observem o que aconteceu com cada planta.
VAMOS CONVERSAR?

Representação dos dois vasos com as mudas. A caixa foi representada com transparência para mostrar o que está em seu interior.
2. Respostas pessoais. O objetivo desta atividade é que os estudantes elaborem hipóteses para explicar o motivo pelo qual a planta que não recebeu luz solar não se desenvolveu adequadamente. Neste momento, não é esperado que citem que, na ausência de luz solar, não houve fotossíntese e que, sem esse processo, a planta não consegue produzir alimento e, consequentemente, energia para se desenvolver, mas é possível avaliar o conhecimento prévio dos estudantes sobre o assunto.
1. O que vocês observaram em cada uma das plantas depois de uma semana?
2. O que vocês acham que aconteceu com a planta que não recebeu luz solar? Conversem entre si e elaborem uma explicação para esse resultado.
3. Conversem entre si e verifiquem se as ideias que vocês tiveram antes de realizar a atividade foram confirmadas.
Resposta pessoal. O objetivo desta atividade é que os estudantes verifiquem se as hipóteses levantadas no início da atividade se confirmaram ou não.
VOCÊ CIENTISTA!
A atividade prática tem como objetivo verificar a importância da luz solar para o desenvolvimento das plantas, especialmente no processo de fotossíntese. Ao envolver os estudantes em práticas científicas, a seção contribui para o desenvolvimento da competência geral 2 e da competência específica 2 de Ciências da Natureza
Para a realização da atividade experimental, organizar previamente os materiais necessários. Dividir a turma em
restos de alimentos triturados, como casca de banana, casca de ovo e borra de café. Após higienizar e preparar os materiais, eles devem ser misturados e incorporados em pequenas quantidades ao solo dos vasos ou da horta escolar. Com o tempo, essa mistura se decompõe, liberando nutrientes importantes para o desenvolvimento das plantas.
Orientar os estudantes a realizar observações durante o período de uma semana, registrando cuidadosamente as mudanças percebidas nas plantas utilizadas no experimento. Ao final desse período, promover uma roda de conversa para que cada grupo possa compartilhar suas anotações e hipóteses, comparando os diferentes resultados.
Após a realização das atividades propostas, sugere-se explorar outras questões para o aprofundamento da discussão:
• O que mais, além da luz solar, pode interferir no crescimento de uma planta?
• Como vocês explicariam a importância da fotossíntese para a vida de outros seres vivos, como os animais e os seres humanos?
• O que aconteceria se todas as plantas de um ambiente deixassem de receber luz?
02/10/25 15:51
grupos com quatro estudantes, de forma que cada participante colabore e participe ativamente. Reforçar a importância do trabalho em equipe, do respeito às funções de cada um e da escuta atenta entre os colegas.
As plantas devem ser jovens e pertencer à mesma espécie (podem ser mudas de feijão, milho ou girassol). A caixa de papelão deve ser grande o suficiente para acomodar a planta jovem.
Se for oportuno, a preparação do adubo pode ser realizada anteriormente pelos próprios estudantes, misturando
A exploração dessas questões complementares contribui para ampliar a compreensão dos estudantes sobre os fatores que influenciam o desenvolvimento das plantas e a importância da fotossíntese.
ALEX ARGOZINO
ENCAMINHAMENTO
Aproveitar a oportunidade para relacionar o conteúdo desta dupla de páginas aos resultados da atividade prática desenvolvida na seção Você cientista! da página 49.
Antes de iniciar o trabalho com a temática fotossíntese, perguntar à turma de que maneira as plantas se alimentam. Avaliar se, entre as respostas, é possível identificar possíveis percepções equivocadas, como a ideia de que as plantas “se alimentam” do solo. Caso isso ocorra, é importante explicar o conteúdo de forma acessível e descomplicada.
As plantas são seres vivos autotróficos, ou seja, produzem o próprio alimento – basicamente glicose – no processo de fotossíntese. Esse processo utiliza água, absorvida pelas raízes, e gás carbônico, absorvido pelas folhas, além da energia proveniente da luz solar. Nas plantas, a fotossíntese acontece principalmente nas folhas, que normalmente têm clorofila – o pigmento responsável por captar a luz solar. A clorofila está localizada nos cloroplastos, organelas especializadas na realização desse processo. Vale ressaltar que, além da clorofila, existem outros pigmentos que podem captar luz solar, como os carotenoides, responsáveis por cores alaranjadas, amareladas ou avermelhadas de muitos vegetais.
Explicar que as raízes das plantas não fornecem alimento propriamente dito, mas sim água e micronutrientes, como os sais minerais, que são fundamentais para o bom funcionamento das células vegetais e o desenvolvimento das plantas.
As plantas produzem o próprio alimento, que será sua fonte de energia. A produção de alimento pelas plantas ocorre por meio da fotossíntese, um processo que ocorre principalmente nas folhas.
Nesse processo, as plantas captam luz solar e transformam o gás carbônico, presente no ar, e a água em alimento e gás oxigênio. Esse alimento é um tipo de açúcar que fornece a energia para a planta se desenvolver. Observe o esquema.



Considerando a faixa etária dos estudantes, o tema da fotossíntese não foi aprofundado. No entanto, destaca-se que suas reações podem ser organizadas em duas etapas: a etapa fotoquímica, que depende diretamente da luz solar, e a etapa química, que não necessita de luz. Contudo, a etapa química só ocorre a partir dos subprodutos da etapa fotoquímica.
Orientar os estudantes a acessar, sob a supervisão de um adulto, o vídeo sobre a fotossíntese sugerido no boxe Para você

explorar. A utilização de tecnologias digitais com finalidade pedagógica contribui para o desenvolvimento da competência geral 5 e da competência específica 6 de Ciências da Natureza. Destacar a importância do respeito à proibição do uso de celulares e outros dispositivos pessoais no ambiente escolar.
IMAGENS FORA DE PROPORÇÃO AS CORES NÃO SÃO REAIS.

1. A água e os sais minerais (representados pelas setas azuis) são absorvidos do solo pelas raízes e transportados para as outras partes da planta até chegarem às folhas.
2. As folhas das plantas captam gás carbônico da atmosfera.
3. A clorofila é um pigmento verde encontrado nas plantas, principalmente nas folhas. Ela é responsável por absorver a luz solar. A folha usa essa luz, a água absorvida pelas raízes e o gás carbônico captado do ar para realizar a fotossíntese. Nesse processo, a planta libera gás oxigênio para o ambiente.
4. Os nutrientes produzidos pela fotossíntese são transportados das folhas até as demais partes da planta.
Fotografia de um ipê-amarelo-do-cerrado e, nos detalhes, representação de alguns processos que ocorrem na planta relacionados à fotossíntese: absorção de água, troca de gases e transporte de nutrientes.
Elaborada com base em: REECE, Jane B. et al Biologia de . 10. ed. Porto Alegre: Artmed, 2015. p. 779.
A FOTOSSÍNTESE das plantas. 2023. 1 vídeo (3 min 33 s). Publicado pelo canal Aprenda com a Luna! Disponível em: https://www.youtube.com/ watch?v=7eqDw8Q_cQ8. Acesso em: 22 maio 2025.
Sob a supervisão de um adulto, assista ao vídeo e conheça mais sobre o processo

ATIVIDADES
Esta atividade tem como objetivo verificar a presença de amido nas folhas das plantas. O amido é um carboidrato de reserva dos vegetais, produzido a partir dos açúcares formados durante a fotossíntese.
São necessários os seguintes materiais: planta com folhas largas e saudáveis (como feijão); papel-alumínio; quatro recipientes de vidro; pinça; água aquecida; álcool etílico (etanol); luvas; e conta-gotas com solução de iodo (lugol).
A atividade tem caráter demonstrativo e deve ser realizada pelo professor. Para iniciar, escolher uma folha saudável da planta e cobri-la com papel-alumínio, de modo que não receba luz. A planta deve ser mantida em um local bem iluminado por cerca de cinco dias.
Após esse período, retirar cuidadosamente a folha que foi coberta e colocá-la em um dos recipientes. O mesmo deve ser feito com outra folha, que foi mantida exposta à luz.
Utilizando luvas, despejar a água já aquecida nos recipientes, deixando as
folhas submersas por cerca de 1 minuto. Enquanto isso, preparar os outros dois recipientes, despejando o álcool em seu interior. Cada folha deve ser colocada em um dos recipientes com álcool para que ocorra sua despigmentação.
Em seguida, utilizando a pinça, retirar as folhas e colocá-las nos primeiros recipientes (descartar a água antes). Pingar algumas gotas de solução de lugol sobre elas e observar os resultados.
Na ausência de amido, a solução mantém sua coloração original, amarelada ou levemente marrom. Já na presença de amido, ocorre uma reação química, e a solução passa a apresentar tons azul-escuros ou arroxeados. Assim, como resultados, espera-se que a folha que recebeu luz fique azul-escura, indicando a presença de amido – sendo, portanto, um indicativo da ocorrência da fotossíntese. Já quanto à folha que estava coberta, espera-se que permaneça amarelada ou marrom, indicando ausência de amido – sendo, portanto, um indicativo de que a fotossíntese não ocorreu.
Com base nos resultados, organizar uma discussão com os estudantes sobre a importância da luz solar para a produção de alimento pelas plantas.
VOCÊ LEITOR!
Propor uma leitura compartilhada, estimulando a participação da turma com a alternância de leitores, o que favorece o envolvimento e a compreensão coletiva. A leitura e a compreensão do texto apresentado ajudam a desenvolver a habilidade de Língua Portuguesa indicada a seguir.
• EF04LP19: Ler e compreender textos expositivos de divulgação científica para crianças, considerando a situação comunicativa e o tema/assunto do texto. Se considerar pertinente, é possível apresentar aos estudantes mais informações sobre as plantas insetívoras. Muitas delas, embora sejam autotróficas e realizem fotossíntese, vivem em ambientes pobres em nutrientes, especialmente nitrogênio. Por isso, a captura de insetos serve de complemento alimentar. A captura e a digestão variam conforme a espécie: a dioneia, cuja fotografia é apresentada no Livro do Estudante, tem folhas que se fecham rapidamente ao toque; as plantas do gênero Drosera têm folhas com substâncias pegajosas que prendem insetos; já as plantas-jarro têm folhas em forma de urna com líquido digestivo, onde os insetos são aprisionados, digeridos e os nutrientes são absorvidos. Essas adaptações demonstram como diferentes plantas foram selecionadas ao longo da evolução.
Após a exploração da temática, realizar as atividades propostas, que trabalham a localização de informações presentes no texto e contemplam a habilidade de Língua Portuguesa indicada a seguir.
• EF15LP03: Localizar informações explícitas em textos.
VOCÊ
LEITOR!
Plantas carnívoras existem mesmo? […]
Diferentemente das que aparecem no cinema, as plantas carnívoras de verdade são pequenas e delicadas. Elas têm em média 15 centímetros. […] Só têm capacidade de capturar e digerir animais miúdos, em geral insetos. Por isso, os pesquisadores preferem chamar essas plantas de insetívoras.
As plantas insetívoras também fabricam seu alimento, mas só isso não é suficiente para suprir suas necessidades vitais. Por isso, os insetos que elas capturam são um complemento alimentar. […]
PLANTAS carnívoras existem mesmo? Ciência Hoje das Crianças, Rio de Janeiro, c2025. Disponível em: https://chc.org.br/plantas-carnivoras-existem-mesmo/. Acesso em: 22 maio 2025.

1. Em filmes ou desenhos, as plantas carnívoras são representadas como enormes e perigosas. Elas são assim mesmo? Explique.
Não. As plantas carnívoras geralmente são pequenas e capturam insetos como complemento alimentar.
2. Por que as plantas carnívoras também são chamadas de plantas insetívoras?
Porque elas só têm a capacidade de capturar e digerir animais pequenos, em geral insetos.
3. As plantas carnívoras realizam fotossíntese?
Sim, porém, como somente a fotossíntese não supre as necessidades delas, elas capturam insetos como complemento alimentar.

Planta carnívora do gênero Drosera, com destaque para as estruturas pegajosas de suas folhas.

Planta carnívora conhecida popularmente como planta-jarro
NÃO ESCREVA NO LIVRO.
Planta carnívora conhecida popularmente por dioneia.
OS ANIMAIS E AS PLANTAS RESPIRAM
Além da alimentação, a respiração é um processo importante para que os animais obtenham energia para viver. Ao respirar, eles absorvem o gás oxigênio do ar. No corpo, esse gás oxigênio e os nutrientes dos alimentos, juntos, são transformados em energia.
gás carbônico
IMAGENS FORA DE PROPORÇÃO
AS CORES NÃO SÃO REAIS
gás oxigênio

Representação da troca de gases durante a respiração de um animal.
As plantas também respiram. Nesse processo, do mesmo modo que os animais, as plantas absorvem o gás oxigênio do ar e liberam gás carbônico. A fotossíntese depende da luz solar e, por isso, esse processo acontece durante o dia. Mas a respiração ocorre em todos os momentos, de dia e à noite.


respiração que essa energia é liberada e utilizada. A forma como certos termos científicos são empregados no cotidiano pode influenciar diretamente a compreensão dos estudantes em sala de aula. No ensino de Ciências, palavras como alimento carregam sentidos prévios que nem sempre coincidem com os significados atribuídos no contexto científico-escolar. Isso pode gerar interpretações equivocadas sobre processos biológicos fundamentais, como a fotossíntese.
TEXTO DE APOIO




luz solar

Fotossíntese
gás carbônico

gás oxigênio


água
Respiração
gás oxigênio

gás carbônico

Respiração
gás oxigênio
gás carbônico
Representação da troca de gases na fotossíntese (setas em roxo) e na respiração (setas em laranja) em plantas, em períodos diferentes do dia.
Elaborada com base em: REECE, Jane B. et al Biologia de Campbell. 10. ed. Porto Alegre: Artmed, 2015. p. 779.
Esclarecer aos estudantes que a respiração e a fotossíntese acontecem nas mesmas células da planta, mas, para fins didáticos, o esquema foi dividido.
ENCAMINHAMENTO
Devido à idade dos estudantes, a respiração não foi aprofundada no Livro do Estudante. Contudo, destacar que esse processo é fundamental para todos os seres vivos, incluindo as plantas.
A respiração celular ocorre dentro das células, quando a energia contida nos alimentos (ou, no caso das plantas, nos nutrientes produzidos pela fotossíntese) é transformada em energia utilizável pelas células. Durante esse processo, ocorre a liberação de gás carbônico como subproduto e a liberação de energia, que
será empregada em diversas funções vitais, como o crescimento, a reprodução e a manutenção das estruturas do ser vivo. É importante reforçar com os estudantes a diferença entre a respiração e a fotossíntese. Enquanto a fotossíntese ocorre principalmente nas células das folhas e depende da presença de luz solar, a respiração celular acontece em todas as células da planta, durante o dia e a noite. Outro ponto essencial é compreender que, embora as plantas produzam o próprio alimento por meio da fotossíntese, elas também precisam de energia, e é na
02/10/25 15:51
Segundo Driver e outros (1994) há uma associação da palavra alimento a ingestão, ao ato de “comer alguma coisa”. Em muitos casos, essa compreensão pode levar o aluno a considerar que a planta produz o alimento, mas para outros seres vivos, em uma cadeia alimentar, e não para ela mesma. Situações como esta podem estar relacionadas ao fato de que em sala de aula, apesar de o professor ter o “controle do discurso”, de controlar o significado das palavras, ele não controla o movimento dos sentidos que as perpassa.
[...]
TRAZZI, Patricia Silveira da Silva; BRASIL, Elizabeth Detone Faustini. Aprendizagem dos conceitos de fotossíntese e respiração celular na perspectiva histórico-cultural. Kiri-kerê: Pesquisa em Ensino, n. 2, p. 148-149, maio 2017. Disponível em: https://periodicos.ufes.br/ kirikere/article/view/15334. Acesso em: 8 ago. 2025.
| ORIENTAÇÕES E RESPOSTAS
2. Resposta pessoal. Espera-se que os estudantes respondam que concordam, pois a luz solar e a água são dois componentes essenciais para a realização da fotossíntese. Durante o período em que a casa ficou fechada, a planta não recebeu nenhum desses componentes e, por isso, não realizou fotossíntese.
3. a) O esquema mostra a fotossíntese da planta.
b) Não, pois a fotossíntese depende da luz solar para acontecer, e na ilustração o ambiente está escuro, pois é noite.
c) Espera-se que o estudante desenhe no caderno a planta em duas situações: durante o dia (ilustrando as trocas gasosas que ocorrem na respiração e na fotossíntese) e durante a noite (ilustrando as trocas gasosas que ocorrem durante a respiração).
ATIVIDADES
A atividade a seguir permite avaliar o aprendizado dos estudantes sobre fotossíntese e respiração das plantas de forma dinâmica e interativa.
Desenhar na lousa uma planta em dois momentos: no período diurno e no período noturno. No período diurno, ilustrar duas setas em direção à planta (representando gases absorvidos) e duas setas em direção ao ambiente (representando gases liberados). No período noturno, ilustrar uma seta em direção à planta e uma seta em direção ao ambiente, representando as trocas gasosas que ocorrem nesse momento.
Convidar voluntários para ir até a lousa escrever
ATIVIDADES
1. Leia as frases a seguir e classifique-as no caderno em verdadeiras ou falsas. Reescreva no caderno as frases falsas, corrigindo-as.
a) Alguns animais produzem o próprio alimento, enquanto outros precisam se alimentar de outros seres vivos.
Falsa. Todos os animais precisam se alimentar de outros seres vivos.
b) Os animais que se alimentam exclusivamente de outros animais são chamados carnívoros. Verdadeira.
c) Nas plantas, a fotossíntese ocorre na presença de luz solar, enquanto a respiração ocorre em todos os momentos. Verdadeira.
d) Animais que se alimentam de outros animais e de plantas, ou suas partes, são chamados de herbívoros.
2. Leia a situação descrita a seguir.
Falsa. Os animais que se alimentam de outros animais e de plantas, ou suas partes, são chamados de onívoros.
Consultar orientações e resposta no Livro do Professor
Bianca tinha um vaso de planta em casa e costumava cuidar bem dele. Ela deixava o vaso próximo à janela, para que a planta recebesse luz solar, e a regava sempre que o solo estava seco. No entanto, nas duas últimas semanas, Bianca viajou com a família e não pôde cuidar da planta. Como a casa ficou fechada durante esse período, a planta não recebeu luz solar nem água. Ao retornar da viagem, Bianca percebeu que a planta estava com as folhas secas e murchas. Diante disso, ela supôs que a planta não realizou fotossíntese nesse período.
• Você concorda com o raciocínio de Bianca? Justifique sua resposta.
3. Analise o esquema ao lado.
Consultar orientações e respostas no Livro do Professor
a) Com base na troca de gases da planta com o ambiente indicado no esquema, que processo está sendo representado?
b) O esquema está correto? Por quê?
c) Faça no caderno um esquema representando as trocas gasosas que devem acontecer entre essa planta e o ambiente durante o dia e a noite.
a qual gás cada seta corresponde (gás carbônico ou gás oxigênio).
Espera-se que eles identifiquem que, no período diurno, a planta absorve gás carbônico (processo de fotossíntese) e gás oxigênio (processo de respiração), enquanto libera gás oxigênio (produto da fotossíntese) e gás carbônico (produto da respiração) no ambiente. Já no período noturno, as trocas gasosas que continuam ocorrendo se referem ao processo de respiração, uma vez que, na ausência de luz, não há fotossíntese.
carbônico gás oxigênio
NÃO ESCREVA NO LIVRO.
gás
água
IMAGENS FORA DE PROPORÇÃO AS CORES NÃO SÃO REAIS.
VOCÊ LEITOR!
A fotossíntese no mar
Leia o texto a seguir e responda às questões.
Os oceanos são muito mais do que grandes massas de água. Eles regulam o clima, abrigam milhões de espécies [de seres vivos] e produzem grande parte do [gás] oxigênio que respiramos. Na verdade, a maior parte desse [gás] oxigênio não vem das árvores, mas sim pela produção de organismos minúsculos que vivem nos oceanos.
[...]
Entre os seres vivos que realizam fotossíntese no mar, o fitoplâncton se destaca. Esse grupo de organismos inclui algas microscópicas e cianobactérias [...].
[...]

Algas microscópicas (aumento aproximado de 400 vezes).
Além disso, macroalgas como o sargaço e os kelps também contribuem para a produção de [gás] oxigênio. Embora não tenham a mesma importância que o fitoplâncton, essas algas desempenham um papel fundamental na absorção de dióxido de carbono e na liberação de [gás] oxigênio.
[...]
Cianobactérias: bactérias que fazem fotossíntese. Dióxido de carbono: gás carbônico.

COSME, Ana Luiza. Oxigênio nos oceanos – Produção e importância para a vida! 123Ecos, [s. l.], 24 mar. 2025. Disponível em: https://123ecos.com.br/docs/oxigenio-nos-oceanos/. Acesso em: 13 ago. 2025.
1. O que é fitoplâncton?
São microrganismos que realizam fotossíntese, entre eles as cianobactérias e as algas microscópicas
NÃO ESCREVA NO LIVRO.
2. As algas são importantes para a vida no planeta Terra? Explique. Sim. As algas microscópicas, que compõem o fitoplâncton, e as macroalgas produzem grande parte do gás oxigênio do planeta Terra, o que é essencial para os seres vivos que o utilizam na respiração. Além disso, as algas ajudam a absorver o gás carbônico.
VOCÊ LEITOR!
Organizar a turma em um círculo para realizar a leitura conjunta do texto, propondo a alternância entre diferentes leitores. Incentivar a participação de todos, garantindo que pratiquem a oralidade. Após a leitura, questionar os estudantes se encontraram palavras desconhecidas além daquelas apresentadas no glossário. Em caso positivo, sugerir que pesquisem seus significados em um dicionário, com o objetivo de ampliar o vocabulário.
O trabalho com o texto e as questões propostas contemplam as habilidades de Língua Portuguesa indicadas a seguir.
• EF04LP19 : Ler e compreender textos expositivos de divulgação científica para crianças, considerando a situação comunicativa e o tema/ assunto do texto.
• EF15LP03: Localizar informações explícitas em textos.
Para encerrar, se considerar oportuno, apresentar o trabalho dos ficologistas, cientistas especializados no estudo de algas, de modo a despertar o interesse dos estudantes pelas ciências e pelas profissões científicas. Também é uma oportunidade para abordar a ciência como um empreendimento humano, desenvolvendo a competência específica 1 de Ciências da Natureza e trabalhando os Temas Contemporâneos Transversais (TCTs) Trabalho e Ciência e tecnologia
02/10/25 15:51
Em seguida, realizar as atividades propostas, que visam avaliar a competência leitora dos estudantes. Se considerar oportuno, formular outras perguntas, que também permitam avaliar a construção do aprendizado da turma sobre a temática da fotossíntese. Por exemplo:
• Segundo o texto, que organismos são responsáveis pela produção da maior parte do gás oxigênio do planeta?
• Ao final do texto, são citadas trocas gasosas realizadas pelas macroalgas. Quais são essas trocas? A que processo fisiológico elas correspondem?
Alga marrom, chamada de sargaço, que pode ser vista a olho nu.
ENCAMINHAMENTO
Propor uma leitura compartilhada da tirinha e do texto, organizando a alternância de leitores para estimular a participação ativa dos estudantes. Durante a leitura, incentivar a turma a estabelecer relações entre os elementos apresentados e os temas que serão abordados no capítulo, como a alimentação dos animais e as cadeias alimentares.
Se considerar adequado, ampliar a exploração com a leitura da matéria “Lagartixa: o réptil protetor do seu lar”, no site Pensamento Verde (disponível em: https://www. pensamentoverde.com.br/ meio-ambiente/lagartixa -o-reptil-protetor-do-seu -lar/; acesso em: 6 ago. 2025), enriquecendo ainda mais o debate. Após a leitura, conduzir uma roda de conversa com a turma utilizando perguntas que favoreçam a análise crítica e a construção de sentido:
• O que Armandinho, o garoto representado na tirinha, quis dizer ao comentar sobre as lagartixas?
• Por que, muitas vezes, as pessoas se incomodam com mosquitos e lagartixas? Esse incômodo diminui a importância desses animais para o equilíbrio do ambiente em que vivem?
Após a leitura e a discussão dos textos, propor à turma a realização das atividades. Se considerar pertinente, promover uma roda de conversa para que os estudantes possam expor seus pontos de vista e aprofundar a reflexão sobre os temas trabalhados. A partir das questões, é possível estimular uma reflexão sobre equilíbrio ecológico e interdependência entre os seres vivos. Os
RELAÇÕES ALIMENTARES ENTRE OS SERES VIVOS
Leia a tirinha com atenção.

BECK, Alexandre. Pronto! Me livrei da última lagartixa! [S. l.], 4 abr. 2015. Facebook: Armandinho. Disponível em: https://www.facebook.com/ tirasarmandinho/photos/np.1428187261428268.100005065987619/95361426801 7213. Acesso em: 22 maio 2025.
Agora, leia o texto e responda às questões.

12 cm
Lagartixa comendo um inseto.
Lagartixa come traça? O que mais ela come em casa?
[…]
De hábitos noturnos, as lagartixas ajudam no controle […] de insetos […].
[…]
O pequeno réptil se alimenta de insetos de forma geral, mas principalmente mosquitos, baratas e pequenas mariposas, aranhas e escorpiões.
[…]
CAPUTO, Gabriela. Lagartixa come traça? O que mais ela come em casa? Estadão, São Paulo, 2 maio 2025. Disponível em: https://www.estadao.com.br/emais/casa-decoracao/lagartixa -come-traca-o-que-mais-ela-come-em-casa-nprec/. Acesso em: 22 maio 2025.
2. Ela afirma que parece haver cada vez mais mosquitos. Isso acontece porque as lagartixas comem mosquitos, então, se ela eliminou as lagartixas, consequentemente haverá mais mosquitos.
1. Na tirinha, o que a mãe do garoto está fazendo no primeiro quadrinho?
Ela está eliminando as lagartixas do ambiente.
NÃO ESCREVA NO LIVRO.
2. Que observação a mãe do garoto faz sobre os mosquitos, no segundo quadrinho da tirinha? Por que isso acontece?
3. Para você, se a mãe do garoto tivesse lido o texto que você leu, a atitude dela poderia ter sido diferente? Por quê?
Respostas pessoais. Espera-se que os estudantes respondam que sim, pois as lagartixas comem diversos seres vivos que podem trazer prejuízo ao ser humano.
estudantes podem perceber como a eliminação de um animal, como a lagartixa, pode gerar consequências inesperadas, como o aumento da população de mosquitos.
Essa discussão ajuda a construir a ideia de que todos os seres vivos têm papel importante no ambiente, mesmo aqueles que às vezes são indesejados. Além disso, sugere-se promover a reflexão sobre ações humanas e seus impactos ambientais, reforçando o conceito de que devemos respeitar e proteger a diversidade
de seres vivos para manter o equilíbrio dos ecossistemas.
O estudo desses assuntos será ampliado ao longo do capítulo, de acordo com a perspectiva do papel de cada ser vivo nas cadeias alimentares de que fazem parte.
CADEIA ALIMENTAR
Os seres vivos podem interagir de diversas formas na natureza, e uma delas é por meio da alimentação. As relações alimentares estabelecidas entre seres vivos de um ambiente podem ser representadas em uma cadeia alimentar.
Por exemplo, imagine o jardim de uma praça. Nele, há lagartas que se alimentam das folhas de determinada planta. Esse mesmo jardim é visitado por pássaros que se alimentam das lagartas. Esses três seres vivos compõem uma cadeia alimentar.
Podemos representar essa cadeia da seguinte forma:
planta lagarta pássaro
Nessa representação, as setas partem do ser vivo que serve de alimento e chegam ao ser vivo que o consome. Por exemplo, a seta que parte da planta em direção à lagarta representa que a planta serve de alimento para a lagarta. Esse raciocínio também é válido para a seta que parte da lagarta para o pássaro.
ATIVIDADES
• Observe um exemplo de cadeia alimentar em um lago.



1. Qual é a relação alimentar estabelecida entre a planta aquática e o caramujo-maçã? A planta aquática serve de alimento para o caramujo-maçã.
2. Qual é a relação alimentar estabelecida entre o caramujo-maçã e o gavião-caramujeiro? O caramujo-maçã serve de alimento para o gavião-caramujeiro.
ENCAMINHAMENTO
O estudo do tópico Cadeia alimentar fornece subsídios para o desenvolvimento da habilidade EF04CI04
ATIVIDADES
Nesta atividade, os estudantes vão construir cadeias alimentares de forma lúdica e dinâmica, mobilizando a habilidade EF04CI04. A proposta também se conecta ao componente curricular de Arte: • EF15AR04: Experimentar diferentes formas de expressão artística (desenho, pintura, colagem, quadrinhos, dobradura,
Orientá-los a recortar as figuras. Caso existam estudantes com deficiências físicas que enfrentem dificuldades com o manuseio da tesoura, orientar os colegas a auxiliá-los nas tarefas de recorte e colagem, seja segurando as folhas para facilitar o corte, seja ajudando na aplicação da cola nas figuras. Outra possibilidade é construir tesouras adaptadas, como estratégia de inclusão (ver indicação em Para o professor). É importante garantir que todos participem ativamente, promovendo a inclusão no trabalho em grupo. Não havendo revistas disponíveis, é possível orientar os estudantes a pesquisar os seres vivos e a ilustrá-los.
Em cartolina ou folha de papel grande, cada grupo deverá montar uma cadeia alimentar, considerando: Planta Animal herbívoro ou onívoro Animal carnívoro ou onívoro. Ao final, reservar um momento para que cada grupo apresente sua cadeia alimentar para a turma.
A apresentação e o cartaz elaborado pelos estudantes podem ser utilizados como instrumentos avaliativos do aprendizado sobre cadeias alimentares.
| PARA O PROFESSOR
02/10/25 15:51
escultura, modelagem, instalação, vídeo, fotografia etc.), fazendo uso sustentável de materiais, instrumentos, recursos e técnicas convencionais e não convencionais.
Os materiais necessários são: revistas usadas, tesouras com pontas arredondadas, colas, cartolinas ou folhas grandes de papel, canetinhas ou lápis de cor.
Para o desenvolvimento da atividade, dividir os estudantes em pequenos grupos. Entregar revistas para que procurem imagens de seres vivos: plantas, herbívoros, carnívoros e onívoros.
TEXTO. SCHIRMER, Carolina R. et al Atendimento educacional especializado: deficiência física. Brasília, DF: MEC, 2007. Disponível em: https://portal. mec.gov.br/seesp/arqui vos/pdf/aee_df.pdf. Acesso em: 6 ago. 2025. Apesar de anterior ao Decreto no 7.611/2011, esse material possibilita ao professor refletir sobre o Atendimento Educacional Especializado e construir conhecimentos e práticas. São apresentadas ainda estratégias para a adaptação de diversas atividades, incluindo recorte e colagem, para estudantes com deficiência física.
Elódea (planta aquática). Caramujo-maçã.
NÃO ESCREVA NO LIVRO.
Gavião-caramujeiro.
ENCAMINHAMENTO
Destacar que, em uma cadeia alimentar, cada organismo ocupa uma posição específica, que é chamada nível trófico. Essas posições representam o papel de cada ser vivo na transferência de energia e nutrientes dentro dos ecossistemas.
Devido à idade escolar dos estudantes, optou-se por não incluir a quimiossíntese no conteúdo trabalhado. Porém, vale ressaltar que, entre os produtores, há algumas bactérias que realizam quimiossíntese, transformando a energia de compostos químicos em alimento.
Destacar que, sem os produtores, não haveria energia disponível para os demais seres vivos. São esses organismos que fornecem a energia inicial para todos os outros níveis da cadeia. Essa discussão dá continuidade ao desenvolvimento da habilidade EF04CI04, quanto ao papel do Sol como fonte primária de energia na produção de alimentos.
Ressaltar a importância ambiental dos decompositores, uma vez que a decomposição da matéria orgânica possibilita a devolução de nutrientes ao solo. Essa discussão contribui para o desenvolvimento da habilidade EF04CI06.
VOCÊ CIDADÃO!
Esta seção trabalha os Temas Contemporâneos Transversais (TCTs) Educação ambiental, Educação para o consumo e Ciência e tecnologia, ao promover uma reflexão sobre o descarte e o tempo de decomposição de resíduos, bem como as ações que podemos adotar para reduzir o acúmulo de resíduos no ambiente. Se julgar importante, comentar que, a partir da segunda metade do século XX, avanços na química dos polímeros deram início a pesquisas
CADA UM EM SEU LUGAR NA CADEIA ALIMENTAR
Em uma cadeia alimentar, cada ser vivo ocupa uma posição. Dependendo da posição que ocupam, os seres vivos podem ser classificados em produtores, consumidores ou decompositores.
Os produtores são os seres vivos que produzem o próprio alimento. Por exemplo, as plantas e as algas produzem o próprio alimento no processo de fotossíntese.
Os consumidores são os seres vivos que se alimentam de outros organismos. De acordo com a sequência em que aparecem na cadeia, os consumidores podem ser diferenciados em primário, secundário e terciário. Por exemplo, o consumidor primário é aquele que se alimenta do produtor; o consumidor secundário é aquele que se alimenta do consumidor primário, e assim por diante.
Os decompositores incluem alguns tipos de bactérias e de fungos. Esses organismos se alimentam da matéria orgânica presente em seres vivos mortos ou dos restos deles, como folhas e galhos, relacionando-se com todas as posições das cadeias alimentares.
Esse processo, chamado de decomposição, tem um papel fundamental no ambiente.
Durante esse processo, os decompositores degradam a matéria orgânica dos seres vivos em partes menores e mais simples: os nutrientes. Os nutrientes são devolvidos ao ambiente, onde ficam disponíveis no solo e podem ser reutilizados pelas plantas, por exemplo.

Representação de uma cadeia alimentar.
sobre materiais biodegradáveis. Nos anos 1970, surgiram os primeiros plásticos à base de amido, ainda com uso restrito. Já a partir dos anos 1990, a preocupação ambiental e novas leis impulsionaram a produção de embalagens e utensílios biodegradáveis feitos de fontes renováveis, como milho, mandioca, cana-de-açúcar e PLA (ácido polilático).
O trabalho com a seção pode ser realizado de forma integrada ao componente curricular de Matemática, conforme a sugestão proposta em +Atividades, a seguir.
Elaborada com base em: REECE, Jane B. et al. Biologia de Campbell. 10. ed. Porto Alegre: Artmed, 2015.
Realizar a leitura coletiva dos dados. Explicar que o tempo de decomposição se refere ao período que determinado material leva para se desintegrar por completo. Estimular a comparação entre os diferentes tempos de decomposição dos materiais, promovendo uma reflexão crítica sobre o impacto de seu acúmulo na natureza e a importância do descarte correto e da redução de resíduos.
Considerando a idade escolar dos estudantes, não foi feita a diferenciação entre os termos lixo e resíduo. Se oportuno, explicar que lixo corresponde a um termo
fungos
IMAGENS FORA DE PROPORÇÃO. AS CORES NÃO SÃO REAIS
Tempo de decomposição
VOCÊ
CIDADÃO!
Você já pensou que quase tudo o que consumimos se transforma com o tempo? Restos de comida, folhas e animais mortos sofrem decomposição. Já materiais como plástico, vidro, papel e metal se degradam na natureza, principalmente com a ajuda da luz e do calor do Sol, do vento e de outros fatores. O que varia é o tempo: alguns materiais somem em dias ou meses, outros levam centenas ou milhares de anos.
Conheça, a seguir, o tempo aproximado de decomposição de alguns materiais.
Tempo de decomposição de resíduos sólidos

Papel
3 a 6 meses
não esteja na lista apresentada no livro, orientar a realização de uma pesquisa para descobrir o tempo aproximado de decomposição desse material.
2. Resposta pessoal. Espera-se que os estudantes citem ações que envolvam a redução do consumo e a redução do volume de lixo descartado; por exemplo, evitar comprar objetos sem necessidade, substituir materiais descartáveis por reutilizáveis; reutilizar embalagens; destinar resíduos à reciclagem (quando possível).




CHRISTOSGEORGHIOU/ SHUTTERSTOCK.

Metal mais de 100 anos
Alumínio mais de 200 anos

Plástico mais de 400 anos
Esquema indicando o tempo de degradação de diferentes materiais.
Vidro mais de 1 000 anos
Elaborado com base em: AZEVEDO, Julia. Decomposição leva tempo: entenda o processo. eCycle, [s. l.], [20--?]. Disponível em: https://www.ecycle.com.br/decomposicao/. Acesso em: 22 maio 2025.
• Organizados em pequenos grupos, respondam às questões a seguir.
1. No caderno, anotem tudo o que cada membro do grupo descartar nos recipientes de coleta (lixeira) da escola durante um dia. Depois, reflitam sobre a quantidade de resíduos descartados e por quanto tempo eles ficariam no ambiente se não tivessem o descarte correto. Se necessário, façam uma pesquisa com o auxílio do professor.
Consultar orientações e respostas no Livro do Professor
2. O que podemos fazer para reduzir o acúmulo de resíduos sólidos no ambiente? Proponham ações para resolver esse problema.
Consultar orientações e respostas no Livro do Professor
3. Alguns objetos são biodegradáveis. Isso quer dizer que são feitos de materiais que podem ser decompostos por microrganismos. Sabendo disso, entre um copo feito de plástico comum e um copo feito com material biodegradável, qual deles deve desaparecer mais rápido no ambiente? Expliquem a resposta e citem uma vantagem desse desaparecimento. O copo biodegradável deve desaparecer mais rápido no ambiente, porque é feito de um material que pode ser decomposto por microrganismos. Uma vantagem disso é que ele permanece menos tempo no ambiente, ajudando a protegê-lo.
geral, que costuma ser utilizado para designar aquilo que não tem mais utilidade para as pessoas, sendo, portanto, descartado. Já resíduo corresponde a um material descartado que ainda pode ser reaproveitado, reciclado ou tratado para gerar novos produtos ou energia, como restos de alimento (resíduos orgânicos) ou papel, vidro e metais (resíduos sólidos).
| ORIENTAÇÕES E RESPOSTAS
A realização das atividades em grupo possibilita o exercício da competência geral 9 e incentiva a ação responsável
e consciente, promovendo o desenvolvimento da competência geral 10 e da competência específica 8 de Ciências da Natureza.
02/10/25 15:51
1. Resposta pessoal. O tempo necessário para degradar os resíduos gerados pela turma em um dia deve considerar o item descartado que leva mais tempo para completar esse processo. Orientar os estudantes na realização desta atividade. Pedir a eles que anunciem os resíduos que serão descartados, de modo que não precisem manusear o conteúdo da lixeira. Caso algum dos materiais descartados
ATIVIDADES
Sugerir aos estudantes que organizem os materiais apresentados na seção Você cidadão! em ordem crescente de tempo de decomposição, do mais rápido ao mais lento. Então, pedir a cada estudante que desenhe uma linha do tempo em uma folha de papel sulfite, posicionando os materiais em pontos proporcionais aos respectivos tempos de decomposição, reforçando, assim, a noção de escala. A produção da linha do tempo respeitando a proporcionalidade oportuniza a integração com Matemática, contemplando a habilidade indicada a seguir.
• EF04MA06: Resolver e elaborar problemas envolvendo diferentes significados da multiplicação (adição de parcelas iguais, organização retangular e proporcionalidade), utilizando estratégias diversas, como cálculo por estimativa, cálculo mental e algoritmos.
NÃO ESCREVA NO LIVRO.
IMAGENS FORA DE PROPORÇÃO AS CORES NÃO SÃO REAIS.
O objetivo da atividade é verificar a decomposição de restos de alimentos a partir da construção de uma composteira. Nesta atividade, promove-se o desenvolvimento da competência geral 2 e da competência específica 2 de Ciências da Natureza É importante considerar resíduos orgânicos aproveitáveis cascas e restos de frutas, casca de ovo e borra de café. Recomenda-se não usar carnes, pois exalam odor forte e atraem pragas, nem ossos, que são decompostos de forma muito lenta.
Para uma análise mais precisa do experimento, sugerir aos estudantes que acompanhem diariamente o processo de decomposição na composteira. Para isso, podem utilizar um caderno de registros, no qual, a cada dia, uma dupla fique responsável por realizar as observações e anotações.
Ao final, destacar que o material obtido no processo pode ser utilizado como adubo. Por ser rico em nutrientes, ele pode ser usado na horta da escola (caso exista) ou em vasos e jardins. Se oportuno, reforçar que esse material contribui para a melhoria da fertilidade do solo, favorece o crescimento das plantas e reduz a necessidade de fertilizantes químicos.
Orientar os estudantes sobre alguns cuidados básicos: sempre que forem mexer no adubo ou nos restos da composteira, devem utilizar luvas e, ao terminar, lavar bem as mãos com água e sabão; é fundamental evitar levar as mãos, o adubo ou restos de alimentos à boca ou aos olhos; a composteira precisa permanecer tampada para evitar a entrada
Composteira
Os restos de alimentos podem ser reaproveitados? Em grupo, discutam como isso pode ser feito. Depois, façam a atividade a seguir.
DO QUE EU PRECISO
• Garrafa PET de 2 L com tampa
• Tesoura com pontas arredondadas
• Clipe de metal
• Meia-calça fina e elástico
COMO FAZER
• Solo e areia
• Folhas secas ou serragem
• Resíduos orgânicos (não use restos de carnes e ossos)
1. Resposta pessoal. Espera-se que os estudantes tenham notado a diminuição da quantidade de resíduo misturado à terra e a formação de um líquido escuro, conhecido como chorume. Aproveite a oportunidade para explicar a eles que o adubo e o chorume são resultado do processo de decomposição.
1. Peçam ao professor que corte a garrafa PET pela metade. A parte com o bico será um funil, e a parte inferior será um recipiente.
2. O professor deve aquecer o clipe e, com cuidado, fazer alguns furos na tampa da garrafa. Use-a para fechar a garrafa.
3. Coloquem uma camada de areia no recipiente (obtido pelo corte da garrafa).
4. Invertam o funil e encaixem no recipiente. No funil, adicionem na ordem: uma camada de areia, solo, resíduos orgânicos, novamente solo e folhas secas ou serragem.
5. Fechem a extremidade aberta do funil com a meia-calça fina e prendam com o elástico.
6. Guardem a montagem em local arejado e, após 30 dias, observem os resultados.
ATENÇÃO!
Os cortes e os furos no material utilizado devem ser feitos apenas pelo professor!
VAMOS CONVERSAR?

resíduos orgânicos serragem elástico
solo solo areia areia
Representação da montagem do experimento.
2. Os decompositores realizam a decomposição dos restos de alimentos, degradando-os e transformando-os em substâncias mais simples.
1. Quais foram os resultados observados depois de 30 dias?
2. Qual é o papel dos decompositores nesse experimento?
3. O material formado após a atividade pode ser utilizado como adubo. Com base nisso, converse com o grupo se as ideias iniciais foram confirmadas. Resposta pessoal. Reservar um momento para que os estudantes exponham suas ideias iniciais, de modo a fomentar um debate com a turma sobre elas.
de insetos e a proliferação de mosquitos; todas as etapas de observação, manutenção e uso devem ser realizadas com a supervisão de um adulto. Reforçar também a importância de, no início da montagem, tomar cuidado com os objetos cortantes e perfurantes, deixando a realização desses procedimentos para um adulto.
Aproveitar a oportunidade para promover a reflexão sobre a importância ambiental das composteiras, trabalhando o Tema Contemporâneo Transversal (TCT) Educação ambiental . Destacar como pequenas ações cotidianas (como
separar o lixo e reaproveitar resíduos orgânicos) contribuem para a conservação do ambiente, ressaltando a responsabilidade de cada um nesse processo.
IMAGENS FORA DE PROPORÇÃO AS CORES NÃO SÃO REAIS meia-calça fina
A MATÉRIA NA CADEIA ALIMENTAR
Tudo o que existe é formado de matéria, incluindo os seres vivos. Na natureza, essa matéria está sempre se transformando. Considere a cadeia alimentar a seguir como exemplo.
As gramíneas são plantas e produzem o próprio alimento por meio da fotossíntese. Ao comer a planta, o gafanhoto passa a ter em seu corpo a matéria que estava na planta. Se um sapo comer o gafanhoto, essa matéria passa para o corpo do sapo, e assim por diante. Quando os seres vivos morrem, há a decomposição e os nutrientes voltam ao solo, podendo ser usados novamente pelas plantas. Esse movimento contínuo da matéria é chamado de ciclo da matéria.
A ENERGIA NA CADEIA ALIMENTAR
A energia também está presente nas cadeias alimentares. Ela vem do Sol e é usada pelas plantas para produzir o próprio alimento durante a fotossíntese, por exemplo. Quando um animal se alimenta da planta, recebe parte dessa energia. A cada nível da cadeia, parte da energia é usada pelo organismo e parte se perde na forma de calor para o ambiente. Por isso, a energia diminui ao longo da cadeia e segue apenas em um sentido. Assim, há um fluxo de energia nas cadeias alimentares. gramíneas

Representação de uma cadeia alimentar mostrando a perda de calor e o fluxo de energia ao longo dessa cadeia. Os decompositores não foram representados.
Elaborada com base em: URRY, Lisa A. et al Campbell Biology. 12. ed. Nova York: Pearson, 2020. p. 1240.
ENCAMINHAMENTO
Retomar o papel dos decompositores ao trabalhar o tópico A matéria na cadeia alimentar, ampliando o desenvolvimento da habilidade EF04CI06.
O ciclo da matéria refere-se ao caminho que os nutrientes e elementos químicos (como carbono, oxigênio e nitrogênio) percorrem no ambiente. Esses elementos circulam continuamente entre os seres vivos e o meio físico, sendo reciclados com a ajuda dos decompositores, que devolvem ao meio físico os nutrientes
presentes nos organismos mortos e nos resíduos.
02/10/25 15:51
Já no tópico A energia na cadeia alimentar, destacar o papel do Sol como fonte primária de energia nas cadeias alimentares, dando continuidade ao trabalho com a habilidade EF04CI04.
Nas cadeias alimentares, a energia é inicialmente captada pelos produtores (como plantas e algas) por meio da fotossíntese e passa de um organismo para outro por meio da alimentação. A energia flui em um único sentido – dos produtores para os consumidores e, finalmente,
para os decompositores. A energia utilizada nas funções vitais dos organismos é dissipada ao ambiente na forma de calor (setas vermelhas da representação). Por isso, a cada nível trófico, a quantidade de energia disponível diminui. Essa dinâmica foi representada pela redução da largura das setas amarelas entre os seres vivos. Ambos os tópicos da página colaboram para o desenvolvimento da habilidade EF04CI05 , uma vez que possibilitam aos estudantes compreender o ciclo da matéria e o fluxo de energia entre os componentes de um ecossistema. Para ampliar este trabalho, sugere-se a realização da atividade proposta em +Atividades.
ATIVIDADES
Ciclo compreende algo que acontece em etapas e se repete continuamente, formando uma sequência fechada que sempre recomeça. Fluxo, por outro lado, é o movimento contínuo de algo que vai de um lugar para outro, sem voltar ao ponto de partida.
Apresentar essas informações e pedir aos estudantes que expliquem a diferença entre o ciclo da matéria e o fluxo de energia em uma cadeia alimentar.
Espera-se que os estudantes considerem que a matéria é reciclada nas cadeias alimentares graças à ação dos decompositores. Já a energia segue um fluxo nas cadeias alimentares, diminuindo ao longo delas, uma vez que é consumida pelos seres vivos e perdida, em parte, na forma de calor.
IMAGENS FORA DE PROPORÇÃO.
AS CORES NÃO SÃO REAIS.
1. Embora o teiú também se alimente de frutos, nessa cadeia alimentar ele deve ocupar a posição de consumidor secundário, pois, no exemplo apresentado, ele está se alimentando do sanhaço-cinzento, que, por sua vez, consome os frutos da goiabeira. Esta atividade possibilita a mobilização da habilidade EF04CI04.
2. Os decompositores são responsáveis por reciclar a matéria nos ambientes. Eles degradam a matéria dos seres vivos em pedaços menores e mais simples, disponibilizando no solo nutrientes que podem ser utilizados pelos seres produtores.
Ao realizar esta atividade, os estudantes mobilizam a habilidade EF04CI06.
3. Respostas pessoais. Espera-se que os estudantes concordem e reconheçam que a energia solar é captada na cadeia alimentar pelo produtor (no caso, as gramíneas – plantas). Sem esse nível trófico, não haveria energia nem alimento disponível para os consumidores primários, secundários, e assim por diante.
Ao reconhecerem o papel do Sol como fonte primária de energia na produção de alimentos, os estudantes mobilizam a habilidade EF04CI04
4. Resposta pessoal. O objetivo desta atividade é que os estudantes conheçam a diversidade de seres vivos existentes na região e suas relações alimentares. Se desejar, é possível organizar os estudantes para que uma parte deles fique responsável por pesquisar organismos terrestres e, a outra, os organismos aquáticos.
ATIVIDADES
1. c) goiabeira sanhaço-cinzento teiú decompositores
1. Leia as informações das fichas a seguir e faça o que se pede.


1. b) Produtor: goiabeira; consumidor primário: sanhaço-cinzento; consumidor secundário: teiú.
4 m
Ave que se de frutos e Árvore que produz o fruto goiaba.


1,3 m
Lagarto que se alimenta de frutos, folhas, insetos, aves e outros animais.
Consultar orientações no Livro do Professor
a) Construa, no caderno, uma cadeia alimentar utilizando todos os seres vivos das fichas. goiabeira sanhaço-cinzento teiú
b) Identifique na cadeia alimentar construída no item a o produtor, o consumidor primário e o consumidor secundário dessa cadeia alimentar.
c) Represente os decompositores na cadeia alimentar construída no item a
2. Qual é o papel ambiental dos organismos decompositores?
Consultar orientações e resposta no Livro do Professor
3. Depois de analisar uma cadeia alimentar, uma estudante do 4o ano disse:
“A serpente não faz fotossíntese, mas, sem a luz solar, ela não poderia se alimentar.”
• Você concorda com essa afirmação? Por quê?
Consultar orientações e resposta no Livro do Professor
4. Pesquise, com a orientação de um adulto da família, quais animais e plantas são comuns no local onde você vive e como eles se alimentam. Então, construa no caderno uma cadeia alimentar utilizando os seres vivos pesquisados.
Consultar orientações no Livro do Professor
NÃO ESCREVA NO LIVRO.
KELSEY M WEB ER/SHUTTERSTOCKCOM
GUTA TIMMEN/SHUTTERSTOCKCOM
Sanhaço-cinzento
Goiabeira
Teiú
1. Resposta pessoal. Orientar os estudantes a analisar a fotografia detalhadamente e tentar identificar a diversidade representada, observando os vários formatos, tamanhos e outras características dos seres vivos.
3 ECOSSISTEMAS
2. Respostas pessoais. Espera-se que os estudantes respondam que esses seres precisam de outros para sobreviver, considerando que muitos dependem uns dos outros para se alimentar e se reproduzir ou até para obter abrigo.
Observe a fotografia a seguir.

Seres vivos vistos ao microscópio (aumento aproximado de 25 vezes).
Essa fotografia foi obtida de um microscópio. Você consegue imaginar qual material foi observado?
Antes de responder a essa pergunta, é importante lembrar que os seres vivos estão presentes em praticamente todos os ambientes da Terra e que, onde há seres vivos, existe algum tipo de relação entre eles e deles com o ambiente.
1. A fotografia de abertura do capítulo é de uma gota de água do mar observada ao microscópio. Vocês imaginavam que pudesse existir tanta vida assim nesse pequeno ambiente?
2. Vocês acham que os seres vivos dessa fotografia conseguem viver sozinhos ou precisam uns dos outros para sobreviver? Por quê?
3. Além de alimento, que outras condições ou componentes vocês imaginam que são necessários para que um ser vivo possa viver?
Resposta pessoal. Possíveis respostas: abrigo, água, calor. Utilize esse questionamento para identificar o conhecimento prévio dos estudantes sobre os componentes abióticos de um ecossistema.
ENCAMINHAMENTO
Orientar a observação e a interpretação da imagem da gota de água do mar ampliada ao microscópio. Incentivar a turma a refletir sobre a diversidade de seres microscópicos presentes nos ambientes aquáticos e sobre o fato de que eles também fazem parte de uma cadeia alimentar, tendo importância nos ecossistemas.
Em seguida, propor uma leitura compartilhada do texto. Incentivar cada estudante a ler pequenos trechos, fazendo
breves comentários ao final de cada parte para reforçar os pontos principais e assegurar a compreensão do grupo.
02/10/25 15:51
Durante a leitura, promover conexões entre os componentes apresentados e os temas já discutidos na unidade, como relações alimentares, fluxo de energia e ciclos da matéria. Incentivar os estudantes a identificar, por exemplo, interações entre seres vivos e o ambiente.
É possível questionar à turma: • O que a imagem da gota de água revela sobre a vida nos ambientes aquáticos?
• Como esses seres microscópicos participam das cadeias alimentares?
Esses momentos de leitura, observação e discussão devem incentivar uma atitude investigativa e crítica em relação ao ambiente e aos seres vivos.
A partir das questões iniciais, os estudantes são incentivados a observar e valorizar a diversidade de seres vivos presentes em um ambiente microscópico, reconhecendo que cada organismo apresenta formas e funções específicas. Além disso, ao discutir a necessidade de interação entre os seres vivos para sobrevivência, eles desenvolvem a compreensão de que a vida é sustentada por relações de dependência mútua, mesmo com componentes não vivos.
ENCAMINHAMENTO
Propor aos estudantes uma leitura compartilhada de textos e da imagem que ilustram os componentes de um ecossistema. Reforçar que os componentes vivos, chamados fatores bióticos, são todos os seres vivos presentes em um ambiente, como plantas, animais e microrganismos, que interagem entre si de diferentes formas, como por meio da alimentação, da reprodução e da competição. Em seguida, destacar os componentes não vivos, chamados fatores abióticos, que influenciam a vida dos seres vivos, como a luz solar, a temperatura, a água, o solo e o ar.
Conduzir a turma a perceber que os componentes vivos e não vivos de determinado ambiente formam um ecossistema, ou seja, um conjunto dinâmico no qual seres vivos e ambiente físico se relacionam para manter a vida. Utilizar exemplos próximos da realidade dos estudantes, como uma floresta, um lago ou até mesmo um jardim, para ilustrar como esses componentes estão conectados. Nesse momento, sugere-se a realização da atividade proposta no boxe Dialogando, incentivando os estudantes a identificar os componentes vivos e não vivos presentes no ambiente em que estão no momento. Organizar uma roda de conversa, estimulando a troca de ideias. Pedir aos estudantes que observem atentamente ao redor e justifiquem, por exemplo, por que uma planta, um inseto, a luz solar ou a temperatura do ar são importantes para o ambiente.
O QUE É UM ECOSSISTEMA?
Em praticamente todos os ambientes da Terra, é possível encontrar componentes vivos em meio a componentes não vivos. Os componentes vivos são os seres vivos, como as bactérias, os protozoários, as algas, os fungos, as plantas e os animais. Já os componentes não vivos são a água, o solo, o ar e a luz solar.
Resposta pessoal. Exemplos de componentes não vivos: chão (solo), construções, água, ar, pedras, areia. Exemplos de componentes vivos: pessoas (o próprio estudante), insetos, animais de estimação, pássaros,
DIALOGANDO
plantas etc. Os estudantes podem citar, ainda, os microrganismos como componentes vivos, mesmo que não possam vê-los.
Observe o ambiente em que você está agora. Quais componentes vivos e não vivos você identifica nele?
No ambiente, os seres vivos dependem dos componentes não vivos para viver. Ao mesmo tempo, eles interagem com outros seres vivos, formando uma rede de relações. Chamamos de ecossistema o conjunto dos seres vivos e dos componentes não vivos de um ambiente e a forma como eles interagem uns com os outros.
Um ecossistema pode ter características variadas. Ele pode ser terrestre ou aquático, ou mesmo ter diferentes tamanhos. Por exemplo, uma floresta pode ser considerada um ecossistema, assim como uma gota de água do mar, como a representada na página anterior.

Valorizar todas as contribuições, reforçando que a interação entre componentes vivos e não vivos é essencial para o equilíbrio dos ecossistemas. Finalizar a roda de conversa destacando que, mesmo em ambientes aparentemente simples, como na sala de aula ou no pátio da escola, essas interações estão sempre presentes.
Floresta da Mata Atlântica. Cachoeiras de Macacu (RJ), 2018.
EXEMPLOS DE ECOSSISTEMAS
BRASILEIROS
O Brasil é um país com um território muito amplo, onde existem diversos tipos de ecossistemas. Alguns deles têm características em comum, como o tipo de vegetação, clima e solo. Por isso, são agrupados em grandes conjuntos chamados biomas. Conheça alguns exemplos a seguir.

A Caatinga é um bioma que ocorre apenas no Brasil. Ela é caracterizada por pouca chuva durante o ano e clima seco. Nos ecossistemas encontrados na Caatinga são comuns plantas com altura baixa ou média. Também há muitos cactos, que armazenam água no caule e têm folhas modificadas em espinhos.
Nesses ecossistemas, vivem animais como insetos, répteis, aves e mamíferos. Conheça, a seguir, um exemplo de cadeia alimentar de um ecossistema da Caatinga.


árvore que produz os frutos conhecidos como juá, mostrados no detalhe.


ENCAMINHAMENTO
Durante o estudo das interações entre os seres vivos nos ecossistemas brasileiros, é importante destacar para os estudantes que essas interações variam de acordo com as características do ambiente, como a disponibilidade de água, o tipo de solo, o clima e a incidência de luz solar.
No Brasil, são reconhecidos seis biomas, cada um deles com características climáticas e de solo próprias, o que influencia a presença de diferentes seres vivos e relações ecológicas particulares.
somente como recursos naturais em nosso país, mas, têm destaque como ambientes de grande riqueza natural no planeta.
[...]
BIOMAS brasileiros. IBGE Educa, c2025. Disponível em: https://educa.ibge.gov.br/ jovens/conheca-o-brasil/terri torio/18307-biomas-brasileiros. html. Acesso em: 8 ago. 2025.
| PARA O ESTUDANTE
VÍDEO. SÉRIE biomas brasileiros: Caatinga. 2022. 1 vídeo (1 min 35 s). Publicado pelo canal Ola Museu. Disponível em: https://www. youtube.com/watch?v=p 2qnvYEqKuQ. Acesso em: 7 ago. 2025.
Vídeo com informações e imagens sobre as principais características da Caatinga. Ao final, há a proposição de uma atividade de confecção do modelo de um cacto – planta típica desse bioma – utilizando papel e recortes.
A jacucaca é uma ave que se alimenta de frutos, especialmente do juazeiro.
A jiboia se alimenta de outros animais, como pequenos mamíferos, aves, como a jacucaca, e lagartos.
TEXTO DE APOIO
15:51
Bioma é um conjunto de vida vegetal e animal, constituído pelo agrupamento de tipos de vegetação que são próximos e que podem ser identificados em nível regional, com condições de geologia e clima semelhantes e que, historicamente, sofreram os mesmos processos de formação da paisagem, resultando em uma diversidade de flora e fauna própria.
Em nosso país podemos encontrar seis tipos de biomas: Amazônia, Mata Atlântica, Cerrado, Caatinga, Pampa e Pantanal. Nossos Biomas são importantes não
LIVRO. CORDEL, Vital; MEDEIROS, Rilder. Bichos da Caatinga. Natal: Timbú, 2025.

Reprodução da capa. Livro sobre diferentes animais encontrados no bioma Caatinga.
jacucaca jiboia juazeiro
Juazeiro,
Região da Caatinga em Cabaceiras (PB), 2025.
ENCAMINHAMENTO
Na Mata Atlântica, são encontradas diversas espécies de seres vivos. Sua flora inclui árvores como o ipê, a peroba e o jequitibá, enquanto sua fauna abriga espécies como o mico-leão-dourado e a onça-pintada, muitas delas ameaçadas pela degradação e pela fragmentação de seu hábitat.
É importante que os estudantes reflitam sobre a fragilidade da Mata Atlântica, que já perdeu grande parte de sua cobertura original devido à expansão urbana, à agricultura e ao desmatamento ilegal. A preservação desse bioma é essencial para manter a qualidade da água, regular o clima local, evitar a erosão do solo e sustentar as cadeias alimentares que dependem de suas florestas.
É possível promover uma discussão integrada com o componente curricular de História, abordando a exploração da Mata Atlântica durante a colonização do Brasil. Pode-se citar, por exemplo, a extração do pau-brasil, árvore que era utilizada para a produção de tinta vermelha e, atualmente, encontra-se ameaçada de extinção.
TEXTO DE APOIO
[...]
Árvore nativa da Mata Atlântica, a espécie [pau-brasil] é símbolo oficial do país conforme a Lei 6.607 de 7 de dezembro de 1978, que também declara o Dia do Pau-brasil.
Antes da colonização, a árvore era usada pelos povos indígenas para a confecção de arcos, flechas, instrumentos musicais e tintura vermelha para pintura corporal.
[...]
Outros ecossistemas se caracterizam por grande quantidade de chuva ao longo do ano e solo rico em nutrientes, o que favorece o desenvolvimento de uma grande diversidade de plantas.

2020.
Esses ecossistemas apresentam florestas com muitas árvores altas e folhas largas. Muitas dessas árvores produzem frutos, como a jabuticabeira, que produz a jabuticaba. Também apresentam grande diversidade de animais, como anfíbios, répteis, mamíferos e aves. Esses ecossistemas formam, por exemplo, o bioma Mata Atlântica.
Observe, a seguir, um exemplo de cadeia alimentar da Mata Atlântica.



O mico-leão-dourado se alimenta de frutos, como a pitanga, além de ovos, insetos, pequenos lagartos e aves.
No período de colonização o corante natural vermelho da madeira podia ser usado para tingir tecidos, o que levou o Pau-Brasil a se tornar o primeiro recurso natural explorado pelos portugueses – a bem-sucedida exportação foi a primeira atividade econômica exercida no Brasil. [...]
NORONHA, Heloísa. Conheça o pau-brasil, a árvore “vermelha” que é a cara do país. CNN Brasil, 30 abr. 2025. Disponível em: https:// www.cnnbrasil.com.br/educacao/conheca-o-pau -brasil-a-arvore-vermelha-que-e-a-cara-do-pais/. Acesso em: 7 ago. 2025.
Pitangueira, árvore que produz os frutos conhecidos como pitanga, mostrados no detalhe.

A jaguatirica se alimenta de outros animais, como pequenos mamíferos, incluindo o mico-leão-dourado, além de aves, répteis e peixes.
| PARA O ESTUDANTE
VÍDEO. A MATA Atlântica e os povos originários. 2022. 1 vídeo (6 min 38 s). Publicado pelo canal Acervo Biocultural do Grupo Entre Folhas – UFV. Disponível em: https://www.youtube.com/watch?v=pF VlIw4ryqs. Acesso em: 7 ago. 2025. Vídeo sobre conhecimentos tradicionais de povos originários sobre a Mata Atlântica. O vídeo dispõe de interpretação em Libras.
Trecho de Mata Atlântica em Nova Lima (MG),
mico-leão-dourado jaguatirica
pitangueira
Alguns ecossistemas são caracterizados por duas épocas do ano bem definidas, uma chuvosa e outra com longa estiagem. Eles podem ter vegetação com muitas gramíneas e arbustos, além de algumas árvores pequenas. Essas árvores apresentam troncos retorcidos e são frequentemente encontradas distantes umas das outras. Ecossistemas como esse fazem parte do bioma Cerrado. Neles, é possível encontrar mamíferos, como tamanduás, lobos-guará, emas, tatus, além de diversas espécies de aves, anfíbios, répteis e insetos.

Observe, a seguir, um exemplo de cadeia alimentar desses ecossistemas.


Pequizeiro, árvore que produz os frutos conhecidos como pequi, mostrados no detalhe.

A queixada se alimenta principalmente de frutos, como o pequi, mas pode ingerir alguns invertebrados e peixes.

A onça-parda se alimenta de outros animais, como mamíferos, incluindo a queixada.
ENCAMINHAMENTO
Muitas comunidades tradicionais habitam o Cerrado e utilizam seus recursos naturais de forma sustentável, contribuindo para a conservação desse bioma. No Texto de apoio a seguir, há o exemplo da comunidade remanescente de quilombo do Mumbuca.
TEXTO DE APOIO
Artesanato em capim dourado reflete a atuação da mulher quilombola na cultura do Tocantins
No Tocantins, um grupo [...] de mulheres transformou a haste de uma sempre-viva em um dos símbolos da cultura do Estado, pelo artesanato em capim dourado. Bolsas, pulseiras, potes, brincos, chapéus, mandalas e enfeites de todos os tipos [...].
A cor, naturalmente dourada, foi uma das características que fizeram com que
o “ouro do cerrado”, como também é conhecido o capim dourado, ganhasse notoriedade e o gosto do público.
Uma dessas mulheres é Diomar Ribeiro Silva Gomes, de 71 anos, ou Dona Santinha, como é conhecida no Povoado Mumbuca, localizado na zona rural de Mateiros. [...]
[...] “Meu prazer é ensinar as crianças, os adolescentes e até os adultos. Porque a natureza é a segunda mãe”, contou orgulhosa. “Quando falo do Cerrado vem água nos olhos”, continuou.
Esse sentimento também é compartilhado pela nova geração de artesãs do Mumbuca que ainda se preocupa com a sustentabilidade na colheita dessa matéria-prima.
GOVERNO DO ESTADO DO TOCANTINS. Artesanato em capim dourado reflete a atuação da mulher quilombola na cultura do Tocantins. Secretaria da Comunicação, [201-?]. Disponível em: https://www.to.gov.br/secom/ artesanato-em-capim-dourado -reflete-a-atuacao-da-mulher -quilombola-na-cultura-do -tocantins/4lcfai0yqfm0. Acesso em: 7 ago. 2025.
ATIVIDADES
Organizar a turma em seis grupos e orientar uma pesquisa sobre os biomas brasileiros. Cada grupo deve pesquisar características de um dos biomas (clima, fauna e flora) e o modo de vida de uma comunidade tradicional encontrada nele. Lembrá-los de que a pesquisa deve ser feita com o acompanhamento de um adulto.
A apresentação dos resultados pode ser feita por meio de um pôster, propiciando a integração com Língua Portuguesa, além de contemplar a competência geral 4. O pôster pode ser utilizado para a avaliação do aprendizado dos estudantes.
Região de Cerrado em São João Batista do Glória (MG), 2023.
ENCAMINHAMENTO
Ao abordar os desequilíbrios nos ecossistemas, é importante compreender como as ações humanas impactam a diversidade de seres vivos e a saúde do ambiente. Sobre o assunto, é possível promover um debate com a turma. Iniciar a conversa a partir da seguinte pergunta:
• Como a extinção de uma espécie pode afetar outras espécies dentro do mesmo ecossistema?
Após a discussão, se considerar oportuno, propor aos estudantes uma atividade de produção escrita. Eles devem escrever um pequeno texto explicando a importância do equilíbrio da natureza, refletindo sobre como as ações humanas podem afetar esse equilíbrio. Isso permitirá que eles organizem suas ideias e compreendam como o equilíbrio natural é fundamental para a sobrevivência de todos os seres vivos.
A análise dos impactos das atividades humanas sobre os fenômenos que ocorrem na natureza é uma oportunidade para desenvolver a competência específica 4 de Ciências da Natureza. A reflexão sobre a temática também pode ser aprofundada, incentivando a proposição de ações para mitigar esses impactos, de modo a abordar o Tema Contemporâneo Transversal (TCT) Educação ambiental.
DESEQUILÍBRIO
DOS ECOSSISTEMAS
Em um ecossistema, as cadeias alimentares funcionam de forma equilibrada. Diversas ações e atividades dos seres humanos podem ser responsáveis por desequilíbrios em cadeias alimentares, causando problemas. Conheça algumas dessas ações a seguir.
A caça e a pesca predatória diminuem a quantidade de animais caçados ou pescados no ambiente. Com isso, pode faltar alimento para outros seres vivos que se alimentavam desses animais, podendo ocasionar o desaparecimento de alguns deles.
Além disso, pode aumentar no ambiente o número de animais que serviam como alimento para aqueles que foram caçados, provocando um desequilíbrio nas relações entre os seres vivos daquele ecossistema.


Veado-campeiro, animal que sofre com a caça ilegal, devido à procura por sua pele e sua carne. 1,2 m
O peixe conhecido como dourado corre o risco de desaparecer do ambiente devido à pesca predatória.
ATIVIDADES FAMÍLIA
Orientar os estudantes a escolher e delimitar um ecossistema próximo ao local onde vivem, como um trecho do bairro, uma praça ou até mesmo o quintal de casa. A atividade deve ser realizada com o acompanhamento de um adulto da família. Durante a observação, eles devem registrar as características desse espaço –tipos de animais e plantas, presença de água, áreas sombreadas ou ensolaradas, entre outros elementos – e elaborar um relatório. O relatório também deve incluir
exemplos de interações entre os seres vivos e uma cadeia alimentar que possa ocorrer nesse ecossistema.
A produção do gênero textual relatório oportuniza a integração com Língua Portuguesa, contemplando a habilidade indicada a seguir.
• EF04LP24: Identificar e reproduzir, em seu formato, tabelas, diagramas e gráficos em relatórios de observação e pesquisa, como forma de apresentação de dados e informações.
O desmatamento é outra ação que prejudica os ecossistemas. Além de reduzir a vegetação da região, a derrubada das árvores faz com que muitos animais percam seu local de abrigo e sua alimentação, o que pode afetar toda a cadeia alimentar.
Outra situação preocupante para o ambiente é a inserção de animais exóticos. Esses animais não são naturais da região, mas foram trazidos de outro lugar e começaram a viver ali. Quando isso acontece, eles podem, por exemplo, competir por alimento ou abrigo com os animais que já viviam ali, causando desequilíbrios.

O tamanduá-bandeira pode desaparecer por causa da perda de abrigo ocasionada pelo desmatamento. A caça também é outra atividade que ameaça a sobrevivência desse animal.
PARA VOCÊ EXPLORAR

O javali, animal exótico no Brasil, destrói plantações para se alimentar, transmite doenças e afeta espécies naturais do país.
• ESPÉCIES ameaçadas de extinção. IBGEeduca — jovens, Rio de Janeiro, 26 ago. 2024. Disponível em: https://educa.ibge.gov.br/jovens/materias-especiais/ 22384-especies-ameacadas-de-extincao.html. Acesso em: 22 maio 2025. Sob a supervisão de um adulto, leia a matéria e conheça mais sobre as categorias de espécies ameaçadas de extinção do Brasil e do mundo.
Resposta pessoal. Incentivar os estudantes a conversar sobre o assunto. Eles podem pensar em uma resposta em conjunto, que pode ser escrita na lousa.
DIALOGANDO
Se você fosse explicar a importância do equilíbrio da natureza para alguém que não sabe nada sobre o assunto, o que diria? Converse com os colegas.
ENCAMINHAMENTO
Ao abordar a introdução de animais exóticos, comentar que muitas vezes essas espécies competem com as nativas por recursos e podem alterar a estrutura do ecossistema. Se julgar oportuno, mencionar que, além dos animais, outros seres vivos, como as plantas, também podem ser espécies exóticas quando introduzidos em ambientes fora de sua área de ocorrência natural.
Explicar que a competição, nesse caso, ocorre porque as espécies exóticas podem
específica 6 de Ciências da Natureza, ao incentivar o uso significativo das tecnologias digitais como ferramenta de ampliação e aprofundamento do aprendizado.
O boxe Dialogando oportuniza a exploração das ideias dos estudantes sobre o impacto das ações humanas nos ecossistemas e o papel de cada ser vivo na manutenção do equilíbrio natural. Além de estimular a reflexão, esta atividade favorece a argumentação e a defesa de pontos de vista, contribuindo para o desenvolvimento da consciência ambiental dos estudantes. Com isso, promove-se o trabalho com a competência geral 7 e a competência específica 5 de Ciências da Natureza
02/10/25 15:52
depender dos mesmos recursos das nativas, como alimento, abrigo ou locais de reprodução – que podem estar disponíveis de forma limitada. Caso tenham vantagens na competição, as espécies exóticas podem se tornar invasoras, dominar o ecossistema e provocar a redução ou até o desaparecimento de espécies nativas.
Recomendar que os estudantes acessem o link indicado no boxe Para você explorar sob a supervisão de um adulto. Essa é uma oportunidade de desenvolver a competência geral 5 e a competência
| ORIENTAÇÕES E RESPOSTAS
1. b) Resposta pessoal. Esta atividade permite que os estudantes expressem sua compreensão do texto de forma visual. Observar se os desenhos incluem componentes vivos (plantas e animais) e componentes não vivos (água, rochas, Sol e relevo) e se representam algum tipo de interação entre eles. Valorizar a criatividade e a coerência com o texto. Aproveitar para conversar com a turma sobre as diferentes formas de imaginar o mesmo ambiente.
c) Resposta pessoal. Exemplos de respostas possíveis: planta aquática caramujo peixe
planta aquática caramujo rã
planta aquática peixe ave
Em todos os casos, cada organismo da cadeia deve ter uma seta levando a decompositores.
2. c) Resposta pessoal. A resposta vai depender de onde os estudantes residem. Orientá-los a refletir sobre a situação do desmatamento de áreas verdes no município em que residem.
d) Resposta pessoal. Sugestões: cuidar das árvores e plantas do bairro ou da escola; ajudar a regar, não quebrar galhos e não subir nas árvores; participar de ações de plantio com a escola ou com a família; conversar com outras pessoas sobre a importância das árvores; criar cartazes ou desenhos sobre os cuidados com a natureza.
ATIVIDADES
1. Leia o texto a seguir e faça, no caderno, o que se pede.
ESCREVA NO LIVRO.
Às margens de um rio de águas calmas, há plantas aquáticas e muitas rochas. Caramujos, peixes, rãs e aves fazem parte desse lugar.
O Sol aquece a água durante o dia, e a brisa leve sopra as flores. À noite, o som dos grilos e das rãs enche o ar, e o reflexo da Lua aparece na superfície tranquila do rio. Tudo se conecta nesse ecossistema cheio de vida.
a) Faça uma lista com os componentes não vivos e vivos citados no texto.
b) Desenhe o ecossistema descrito no texto.
Consultar orientações e respostas no Livro do Professor
c) Elabore uma cadeia alimentar que você acha que pode existir nesse ecossistema. Essa cadeia deve ter pelo menos um produtor, um consumidor primário, um consumidor secundário e decompositores.
Consultar orientações e respostas no Livro do Professor.
2. Forme dupla com um colega para observar a charge a seguir.

1. a) Componentes não vivos: água, rocha, calor, luz solar e ar. Componentes vivos: plantas aquáticas, caramujos, peixes, rãs, aves, flores e grilos.
2. a) A charge faz uma crítica ao desmatamento e seu impacto para os animais. A expressão de tristeza da ave ao olhar para uma árvore cortada e pensar que ela poderia ser seu abrigo e lhe oferecer alimento.
ARIONAURO. Desmantamento. Arionauro cartuns, [s. l.], 2021. Disponível em: http://www. arionaurocartuns.com.br/2021/03/. Acesso em: 9 ago. 2025.
a) Que situação a charge representa? Que elementos ilustrados na charge permitiram que vocês chegassem a essa conclusão?
b) Por que é importante refletir sobre situações como a representada na charge?
c) A charge representa uma situação que está próxima ou distante do dia a dia de vocês?
Consultar orientações e respostas no Livro do Professor
d) Que atitudes uma pessoa pode tomar para ajudar na manutenção da cobertura vegetal de locais próximos? Juntos, proponham ações que podem ser adotadas no cotidiano.
Consultar orientações e respostas no Livro do Professor
2. b) Porque o desmatamento pode eliminar local de abrigo e alimentação de muitos animais, o que causa desequilíbrios no ecossistema, afetando, por exemplo, as cadeias alimentares do ambiente.
VOCÊ CIDADÃO!
Em razão da idade dos estudantes, alguns conceitos não foram apresentados no Livro do Estudante. Se considerar oportuno, explicar que, ao visitar uma flor em busca de néctar, a abelha acaba se cobrindo de pólen, uma estrutura que contém células reprodutivas masculinas. Quando voa até outra flor da mesma espécie, o pólen pode ser transferido para estruturas que contêm células reprodutivas femininas. A união entre essas células reprodutivas resulta na formação de sementes, as quais
podem se desenvolver e originar novas plantas.
A polinização é fundamental para a reprodução de muitas plantas. Ressaltar que esse processo pode ser feito por diferentes animais, pela água e pelo vento, sendo indispensável para o equilíbrio ambiental. Essa reflexão permite a abordagem do Tema Contemporâneo Transversal (TCT) Educação ambiental
Também destacar a importância da polinização para a produção de grande parte dos alimentos consumidos pelos seres humanos.
NÃO
Abelhas e agrotóxicos
VOCÊ CIDADÃO!
As abelhas visitam as flores principalmente em busca de néctar, um líquido açucarado que serve de alimento para esses animais. Ao se alimentarem, as abelhas acabam contribuindo para a reprodução das plantas e a manutenção do ambiente. Você sabe como isso acontece?
Tudo começa com o pólen, uma estrutura reprodutiva das plantas. Acompanhe no esquema a seguir.
Quando a abelha visita uma flor, o pólen pode grudar em diferentes partes de seu corpo.
1
Ao visitar outra flor, a abelha leva esse pólen com ela, que pode entrar em contato com partes da flor que participam de sua reprodução.
IMAGENS FORA DE PROPORÇÃO
AS CORES NÃO SÃO REAIS grãos de pólen
Representação de abelha-uruçu transferindo pólen entre flores diferentes de pitangueira.
O processo ilustrado é chamado de polinização. A partir dele se inicia a reprodução da planta, que pode, então, formar frutos e sementes.
Muitas das plantas que utilizamos como alimento dependem da polinização para se desenvolver, e as abelhas têm um papel importante nesse processo. No entanto, o uso excessivo de agrotóxicos — produtos para combater pragas nas plantações — pode causar a morte das abelhas.
• Em duplas, respondam às questões a seguir.
Consultar orientações e respostas no Livro do Professor
NÃO ESCREVA NO LIVRO.
1. Segundo o texto, como a alimentação das abelhas contribui para a polinização das plantas?
2. A abelha-uruçu é encontrada principalmente na região Nordeste do Brasil. Ela poliniza flores de pitangueira, abacateiro, entre outras. Imagine que uma situação de desequilíbrio ambiental ocasionada pelo uso excessivo de agrotóxico tenha causado a morte das uruçus em uma região de cultivo dessas plantas. O que poderia acontecer com essas plantações? Explique.
3. Com base em sua resposta à questão anterior, por que é importante existirem leis que regulamentem o uso de agrotóxicos?
4. Pense em algum lugar onde há flores ou plantas perto de sua casa ou escola. Você acha que cuidar melhor desses espaços pode ajudar as abelhas? Explique.
| ORIENTAÇÕES E RESPOSTAS
1. As abelhas visitam as flores principalmente para se alimentar. Quando uma abelha visita uma flor, os grãos de pólen dessa flor grudam no corpo dela. Ao visitar outra flor, essas abelhas liberam grãos de pólen em partes da flor que participam da reprodução. Posteriormente, a reprodução gera os frutos e as sementes da planta.
2. Se as abelhas-uruçu desaparecessem, a produção de pitanga e abacate, por exemplo, poderia ser afetada. Isso porque
a contaminação do solo, da água e de outros seres vivos.
Esta atividade requer a elaboração de argumentos que colaboram para a promoção da consciência ambiental, oportunizando o desenvolvimento da competência geral 7 e da competência específica 5 de Ciências da Natureza. 4. Sim, pois as abelhas se alimentam principalmente do néctar das flores. Assim, ao preservar locais com flores polinizadas por abelhas, estamos garantindo alimento para as abelhas e favorecendo sua sobrevivência.
| PARA O ESTUDANTE
TEXTO. PEREIRA, Fábia de M.; LOPES, Maria Teresa do R.; SOUZA, Bruno de A. Abelhas, prazer em tê-las. Ilustrações de Luciana Fernandes. Teresina: Embrapa Meio-Norte, 2020. Disponível em: https://www. infoteca.cnptia.embrapa. br/infoteca/bitstream/ doc/1124768/1/CartilhaIn fantilAbelhasSet2020.pdf. Acesso em: 8 ago. 2025. Cartilha com informações sobre diferentes espécies de abelhas.
02/10/25 15:52
as abelhas realizam a polinização, um processo essencial para a reprodução dessas plantas. Sem polinização, muitas plantas não conseguem formar sementes nem frutos, o que prejudica a reprodução delas.
3. Resposta pessoal. Espera-se que os estudantes concluam que a regulamentação do uso de agrotóxicos é importante para evitar a morte não desejada de animais polinizadores, como as abelhas. Explique também à turma que a regulamentação do uso de agrotóxicos é importante para evitar, ou ao menos reduzir,
A seção propõe uma integração entre os componentes curriculares de Ciências, Geografia e História, ao abordar as comunidades tradicionais e seus modos de vida sustentáveis. Grupos como os pescadores artesanais e as quebradeiras de coco-babaçu oferecem exemplos de relações equilibradas com a natureza, baseadas no uso responsável dos recursos naturais. Além da integração, esse assunto oportuniza o respeito e a valorização de saberes tradicionais, articulando-se à competência geral 6 e ao Tema Contemporâneo Transversal (TCT) Diversidade cultural
Para trabalhar a temática, propõe-se iniciar com uma conversa breve, questionando se os estudantes sabem o que é sustentabilidade. Permitir que apresentem suas percepções iniciais, respeitando os momentos de fala e escuta. Então, explicar que sustentabilidade é um jeito de viver que permite usar os recursos do ambiente – como plantar, pescar e construir – sem destruir a natureza, pensando não apenas no presente, mas também nas futuras gerações.
Durante a leitura do texto, fazer pausas e incentivar os estudantes a expressar o que compreenderam, exercitando a oralidade. Destacar que as comunidades tradicionais vivem em estreita relação com o ambiente e praticam atividades fundamentais para a conservação da biodiversidade.
Após a leitura, propor uma discussão em pequenos grupos, pedindo aos
DIALOGANDO GEOGRAFIA E HISTÓRIA COM
COMUNIDADES TRADICIONAIS E OS ECOSSISTEMAS
As comunidades tradicionais são grupos que mantêm costumes e modos de vida transmitidos pelos mais antigos aos mais novos. Elas costumam viver em harmonia com a natureza, usando o que precisam para comer, construir e cuidar da família, sem destruir o ambiente. Além disso, muitas dessas comunidades também vendem o que produzem, sempre procurando formas de respeitar e conservar o ambiente em que vivem. Alguns exemplos de comunidades tradicionais são os povos indígenas, os quilombolas, os ribeirinhos e os pescadores artesanais.
Os pescadores artesanais vivem em diferentes regiões do Brasil, geralmente perto de rios, lagoas ou do mar. Eles pescam apenas o suficiente para o sustento de suas famílias ou para o comércio em pequena escala nas comunidades vizinhas. Também respeitam o período de reprodução dos peixes, permitindo que os filhotes cresçam e se desenvolvam. Além disso, evitam práticas que possam prejudicar rios e lagos.
Esses cuidados ajudam os peixes a continuar se reproduzindo e garantem que outras pessoas também possam utilizar os ambientes no futuro. Assim, a pesca artesanal contribui para manter o equilíbrio dos escossistemas e para preservá-los.

estudantes que comentem o que aprenderam com os pescadores artesanais e as quebradeiras de coco-babaçu sobre o cuidado com o ambiente e que atitudes sustentáveis eles podem adotar na própria vida.
Como fechamento, os estudantes podem criar um pequeno cartaz ou desenho que represente a importância do modo de vida das comunidades tradicionais para a conservação da natureza ou escrever um slogan sobre a temática. A proposta propicia a integração com DIALOGANDO COM GEOGRAFIA E HISTÓRIA
Língua Portuguesa ao propor a criação de um cartaz ou slogan.
| PARA O ESTUDANTE
VÍDEO. CONHEÇA o movimento das quebradeiras de coco-babaçu e sua força transformadora! 2025. 1 vídeo (1 min 52 s). Publicado pelo canal MIQCB. Disponível em: https://www.youtube.com/ watch?v=jjsUBYdlm0I. Acesso em: 8 ago. 2025.
Vídeo que valoriza o modo de vida das quebradeiras de coco-babaçu.
Pescadores artesanais da comunidade de Siribinha jogando uma rede, chamada de tarrafa, para pescar. A comunidade é uma vila de pescadores localizada no litoral norte do estado da Bahia, no município de Conde. Fotografia de 2024.
1. São grupos que mantêm costumes e modos de vida passados de geração em geração. Vivem em harmonia com a natureza, utilizando seus recursos sem destruir o ambiente.
Outro exemplo são as quebradeiras de coco-babaçu, mulheres de comunidades tradicionais do Norte e do Nordeste do Brasil. Elas vivem da coleta do coco que cai das palmeiras da região e o aproveitam sem destruir a natureza. Do coco, retiram produtos como o óleo, que é usado no dia a dia ou vendido para gerar renda. Seu trabalho ajuda a proteger os babaçuais e a manter o equilíbrio do ambiente.

Quebradeira de coco-babaçu, em São Desidério (BA), 2024.
1. O que são comunidades tradicionais?
2. De que maneira o modo de vida dos pescadores artesanais e das quebradeiras de coco-babaçu contribui para o equilíbrio dos ecossistemas?
3. O modo de vida das comunidades tradicionais expressa mudanças ou permanências ao longo do tempo? Por quê? Dê exemplos.
Consultar orientações e resposta no Livro do Professor
4. Em grupo e com a supervisão do professor, façam uma pesquisa sobre as comunidades tradicionais que vivem em sua região ou em seu estado.
Consultar orientações e respostas no Livro do Professor
• Identifiquem a comunidade, o território que habita, o modo de vida e como ela interage com os ecossistemas ao redor.
• Produzam um cartaz com os resultados da pesquisa e o apresentem à turma.
2. Os pescadores artesanais pescam apenas o suficiente para o consumo próprio e local, evitando a exploração excessiva dos recursos. Já as quebradeiras de coco-babaçu aproveitam o coco que cai no chão para obter alimentos e outros produtos, sem derrubar as palmeiras.
| ORIENTAÇÕES E RESPOSTAS
3. O modo de vida das comunidades tradicionais indica permanências, pois elas mantêm práticas e conhecimentos transmitidos de geração em geração. Um exemplo é a pesca artesanal, que continua sendo realizada de forma respeitosa com a natureza, como o cuidado com o período de reprodução dos peixes. Isso mostra como essas comunidades preservam tradições que aprenderam com os mais velhos.
4. Resposta pessoal. O objetivo da atividade é que os estudantes conheçam as comunidades tradicionais brasileiras existentes na região. Caso não existam na região, é possível expandir a pesquisa para outras regiões próximas de onde moram.
Indica-se sugerir a cada grupo que investigue uma comunidade diferente. Durante as apresentações, incentive a comparação entre essas comunidades, destacando as práticas sustentáveis no uso dos recursos naturais e a contribuição de cada uma delas para a conservação do ambiente.
Esta atividade oportuniza um trabalho interdisciplinar com Geografia, ao reconhecer a importância das comunidades tradicionais para o ambiente e a sociedade. Além disso, os estudantes vão pesquisar os territórios étnico-culturais do Brasil. Assim, mobiliza-se a habilidade indicada a seguir.
• EF04GE06 : Identificar e descrever territórios étnico-culturais existentes no Brasil, tais como terras indígenas e de comunidades remanescentes de quilombos, reconhecendo a legitimidade da demarcação desses territórios.
Se considerar pertinente, as informações pesquisadas podem ser apresentadas em um seminário.
02/10/25 15:52
Esta atividade possibilita a realização de um trabalho interdisciplinar com História, promovendo reflexões sobre as permanências no modo de vida das comunidades tradicionais nos dias de hoje. Ela propicia o desenvolvimento da habilidade indicada a seguir.
• EF04HI01: Reconhecer a história como resultado da ação do ser humano no tempo e no espaço, com base na identificação de mudanças e permanências ao longo do tempo.
NÃO ESCREVA NO LIVRO.
VOCÊ ESCRITOR!
Sugere-se realizar a leitura compartilhada do texto com os estudantes. Durante a leitura, destacar palavras e expressões importantes, como biodiversidade, berçário natural e equilíbrio ambiental, buscando ampliar o vocabulário e o entendimento do conteúdo.
Após a leitura, organizar os estudantes em grupos para discutir as principais ideias do texto. Pode-se organizá-las em eixos como: funções do manguezal, espécies que dependem desse ambiente, relações entre o manguezal e a sociedade humana, além das ameaças à sua conservação.
Em seguida, realizar um momento de socialização coletiva, no qual os grupos compartilham suas respostas e ideias. O professor, como mediador, organiza as contribuições na lousa.
Para finalizar, orientar um registro individual por escrito. Cada estudante escolhe um dos eixos discutidos e escreve um texto sintetizando as ideias centrais que foram debatidas. Espera-se que o texto apresente coerência e argumentação simples, considerando a organização de ideias com início, meio e fim. A elaboração do texto oportuniza o uso da linguagem para expressar ideias, e, assim, os estudantes podem desenvolver a competência geral 4 e a competência específica 6 de Ciências da Natureza. Além disso, o trabalho com a conservação dos manguezais contribui para o desenvolvimento do Tema Contemporâneo Transversal (TCT) Educação ambiental. Pode-se indicar o livro do boxe Para você explorar como leitura complementar, colaborando para o aprimoramento da competência leitora dos estudantes.
VOCÊ ESCRITOR!
Manguezal, o berçário da vida
O manguezal é uma formação vegetal típica de zonas litorâneas, sendo muito comum nos locais em que os rios desembocam no mar. Ele é de fundamental importância para o equilíbrio ambiental e para a manutenção da vida marinha, pois [...] abriga uma grande biodiversidade e consiste em um berçário natural para várias espécies marinhas, onde peixes, moluscos e crustáceos se reproduzem e se alimentam.
CARVALHO, Roberta. Manguezal, o berçário da vida. Maragogi News, 22 dez. 2020. Disponível em: https://maragoginews.com.br/portal/colunistas/roberta-carvalho/manguezal-o-bercario-da-vida/. Acesso em: 29 maio 2025.
Manguezal localizado em Cairu (BA), 2018.
O solo dos manguezais é constituído de lama, rico em matéria orgânica em decomposição, e permanece alagado em certos períodos.

Em sua maior parte, a vegetação é formada pelos mangues, plantas que dão nome ao ecossistema. As raízes de alguns mangues crescem acima do solo, contribuindo para a sustentação deles.
1. Por que o manguezal é chamado de berçário da vida?
2. Com a ajuda de um adulto da família, pesquise o nome de três animais do manguezal que formam um exemplo de cadeia alimentar que acontece nesse ecossistema.
1. Porque ele abriga uma grande diversidade de seres vivos, como peixes, moluscos e crustáceos, que ali se reproduzem e se alimentam.
PARA VOCÊ EXPLORAR
2. Entre os animais estão caranguejos, ostras, peixes, camarões, garças e guaxinins. Um exemplo de cadeia alimentar: mangue caranguejo-uçá guaxinim.
• COMANCHE, André. Uçaúna e o mundo mangue. Barueri: NS Kids, 2023. Livro que narra as aventuras de Uçaúna, um garoto com pinças de caranguejo no lugar das mãos, em um mundo fantástico inspirado nos ecossistemas do mangue.
| PARA O ESTUDANTE
LIVRO. CABRAL, Lia. Bichos do Mangue
Natal: Timbú, 2021.
Livro com informações sobre os manguezais, destacando, de forma lúdica, criativa e imagética, animais que vivem nesse ecossistema.

Reprodução da capa.
ESCREVA NO LIVRO.
ORGANIZANDO IDEIAS
ORGANIZANDO IDEIAS
ORGANIZANDO IDEIAS
Nesta unidade, estudamos as relações alimentares entre os seres vivos. Analise o esquema a seguir para relembrar esses assuntos.
RELAÇÕES ENTRE SERES VIVOS
PRODUTORES
que produzem o próprio alimento por meio da que ocorre na presença de
FOTOSSÍNTESE
LUZ SOLAR
ALIMENTAÇÃO
formando as podem acontecer por meio da
CADEIAS ALIMENTARES
compostas de
CONSUMIDORES
animais que podem ser
CARNÍVOROS
HERBÍVOROS
ONÍVOROS
DECOMPOSITORES
que são fundamentais para o
CICLO DA MATÉRIA
IMAGENS FORA DE PROPORÇÃO AS CORES NÃO SÃO REAIS

03/10/25 21:05
O esquema visual apresentado oportuniza a retomada dos principais conceitos trabalhados na unidade. É possível utilizá-lo para consolidar a compreensão da turma sobre os conteúdos estudados. Como complemento, propõe-se uma atividade coletiva de construção de um esquema que evidencie a interligação de conceitos. Iniciar retomando com a turma os principais conceitos abordados na unidade. A partir dessa retomada oral, incentivar a turma a identificar as palavras-chave e refletir sobre como esses conceitos se relacionam. À medida que os estudantes sugerirem conexões, registre-as na lousa de forma organizada, utilizando setas, conectores e níveis hierárquicos que expressem as relações.
Após a construção coletiva do esquema, orientar os estudantes a copiá-lo no caderno, reforçando a importância de organizarem as informações de maneira estruturada. Essa prática contribui para o desenvolvimento da capacidade de síntese e da organização lógica de informações.
Os esquemas construídos pelos estudantes podem ser utilizados como instrumento avaliativo de seu aprendizado.
RETOMANDO
Esta seção tem como propósito a retomada dos conteúdos estudados na unidade. Também propicia ao docente a avalição do aprendizado dos estudantes.
A avaliação da aprendizagem é uma etapa importante, pois possibilita acompanhar o desenvolvimento da turma, ajudando a reconhecer progressos e a identificar eventuais desafios de aprendizagem. Com base nisso, fazer os devidos ajustes no planejamento e nas estratégias pedagógicas, de modo a atender melhor às necessidades dos estudantes.
Listas de atividades são apenas um dos instrumentos avaliativos que podem ser utilizados nesse processo. Ao longo deste Livro do Professor, outras sugestões foram apresentadas em diferentes momentos das orientações específicas. Outros instrumentos também podem ser consultados na página XXIX da Parte Geral deste Livro do Professor
Garantir que os estudantes tenham tempo suficiente para realizar as tarefas de forma individual, favorecendo a concentração e a autonomia no processo. Na sequência, organizar uma roda de conversa para que os estudantes possam partilhar seus pontos de vista, promovendo o diálogo, a escuta ativa e a construção coletiva do conhecimento.
RETOMANDO
1 Os animais e as plantas se alimentam da mesma maneira? Explique sua resposta.
Não. Os animais se alimentam de outros seres vivos, enquanto as plantas produzem o próprio alimento por meio da fotossíntese.
2 O gavião-carijó é uma ave que pode ser encontrada em todos os estados do Brasil.
Ele caça outros animais para se alimentar, desde insetos até pequenos vertebrados, como sapos, lagartos, aves e ratos.
Consultar orientações e respostas no Livro do Professor
a) Com base nas informações do texto, é possível dizer que o gavião-carijó é um animal herbívoro, carnívoro ou onívoro? Explique sua resposta.

Gavião-carijó.
b) Nas cadeias alimentares de que faz parte, o gavião-carijó ocupa a posição de produtor, consumidor ou decompositor? Explique sua resposta.
c) Considere que, em determinado ecossistema, predominem vastas áreas cobertas por gramíneas, que servem de alimento para os gafanhotos e as lagartas. Esses animais, por sua vez, são consumidos principalmente por sapos e lagartos, que podem ser caçados pelo gavião-carijó. Com base nessas informações, construa no caderno uma cadeia alimentar da qual o gavião-carijó faça parte.
d) Considere a cadeia alimentar que você construiu no item c. Explique como se dá o fluxo de energia ao longo dela, destacando como a energia proveniente do Sol chega ao gavião-carijó.
3 Analise a fotografia ao lado.
a) Construa no caderno uma cadeia alimentar com base na fotografia.
b) Agora, insira uma onça-pintada na cadeia alimentar construída no item a
c) Qual é a posição que cada um desses seres vivos ocupa nessa cadeia alimentar?
3. Consultar orientações e respostas no Livro do Professor 76
| ORIENTAÇÕES E RESPOSTAS

Veado-campeiro se alimentando.
2. a) Carnívoro, pois se alimenta de outros animais, como insetos, sapos, lagartos, aves e ratos.
b) Consumidor, pois se alimenta de outros seres vivos.
c) Possíveis cadeias alimentares a serem construídas, com base nas informações descritas:
gramíneas gafanhoto ou lagarta sapo ou lagarto gavião-carijó
d) As gramíneas usam a energia da luz solar para a produção do próprio alimento
por meio da fotossíntese. Quando o gafanhoto ou a lagarta come as gramíneas, ele recebe parte dessa energia. Por sua vez, o sapo ou o lagarto, ao se alimentar do gafanhoto, também recebe parte da energia. Por fim, o gavião-carijó, ao se alimentar do sapo ou do lagarto, recebe parte da energia que foi transferida ao longo dessa cadeia alimentar.
Comentar que, a cada transferência, uma parte da energia é usada pelos seres vivos e outra parte se perde na forma de calor. Por isso, a energia vai diminuindo ao longo da cadeia alimentar e o fluxo de
NÃO ESCREVA NO LIVRO.
4. Consultar orientações e respostas no Livro do Professor
4 Depois de estudar sobre cadeias alimentares durante as aulas de Ciências, uma turma de estudantes realizou uma visita ao parque da cidade com o professor para observar, na prática, os processos que ocorrem em uma cadeia alimentar. Durante a visita, eles registraram suas observações por meio de fotografias. Observe ao lado uma das fotografias da turma.

Maçãs que caíram da árvore conhecida por macieira.
a) Qual processo foi registrado nessa fotografia tirada pelos estudantes?
b) Quais seres vivos são responsáveis por esse processo?
c) Qual é a importância ambiental desse processo?
5 Candido Portinari (1903-1962) foi um pintor brasileiro conhecido por representar em sua obra a realidade do país, sobretudo a vida dos trabalhadores, das crianças e do povo do interior. Outros temas explorados pelo artista foram componentes de ecossistemas brasileiros, como na obra a seguir.

Obra do artista Candido Portinari, Flora e fauna brasileiras, 1934. Óleo sobre tela, 80 cm × 160 cm.
Consultar orientações e respostas no Livro do Professor
a) O que é um ecossistema?
b) Quais componentes vivos e não vivos estão presentes na obra de Portinari?
c) Considere que o ecossistema apresentado na obra de Portinari esteja em equilíbrio. Indique uma atividade humana que poderia tirar esse ecossistema desse equilíbrio e explique como ela o afetaria.
energia segue em um único sentido – do Sol até o último consumidor.
Esta atividade oportuniza a mobilização da habilidade EF04CI04, relativa à análise de cadeias alimentares e ao reconhecimento do Sol como fonte primária de energia na produção de alimentos.
3. a) grama veado-campeiro b) grama veado-campeiro onça-pintada
c) Grama: produtor; veado-campeiro: consumidor primário; onça-pintada: consumidor secundário.
Esta atividade oportuniza a mobilização da habilidade EF04CI04, relativa à construção e análise de cadeias alimentares.
03/10/25 22:21
4. a) A decomposição dos frutos. b) Alguns tipos de fungos e bactérias.
c) A decomposição promove a reciclagem da matéria, disponibilizando para o solo nutrientes que podem ser reaproveitados pelos produtores.
Esta atividade oportuniza a mobilização da habilidade EF04CI06, relativa ao reconhecimento da importância ambiental da decomposição.
5. a) Um ecossistema corresponde ao conjunto de componentes vivos e não vivos e suas interações.
b) Componentes vivos: animais (como a arara e o macaco) e plantas (como as árvores, as folhas, as flores e os frutos, por exemplo as bananas). Componentes não vivos: areia, água (mar ao fundo) e montanhas.
c) Entre os exemplos estudados, é possível que os estudantes citem a caça e a pesca predatórias, o desmatamento e a inserção de animais exóticos. A caça e a pesca em excesso reduzem a quantidade de animais em um ambiente, o que pode afetar cadeias alimentares (provocando a falta de alimento para uns ou aumentando descontroladamente a quantidade de outros, já que não serão predados). Por sua vez, o desmatamento agrava esse cenário ao eliminar plantas que servem de alimento e abrigo para diversos seres vivos. Já a inserção de espécies exóticas pode provocar competição com as nativas por alimentos ou abrigo, ameaçando a sobrevivência das nativas e desequilibrando o ecossistema.
| PARA O ESTUDANTE HISTÓRIA EM QUADRINHOS. CABREIRA, Juliana da Silva. Cadeia alimentar em quadrinhos . Campo Grande: Edição da autora, 2022. Disponível em: https://educapes. capes.gov.br/bitstream/ca pes/705413/1/Cadeia%20 alimentar%20em%20qua drinhos.pdf. Acesso em: 8 ago. 2025.
História em quadrinhos educativa sobre cadeia alimentar.
INTRODUÇÃO À UNIDADE
Esta unidade aborda as transformações dos materiais e as misturas. Inicialmente, destaca-se que os materiais presentes no cotidiano podem passar por transformações, classificadas em reversíveis e irreversíveis. As mudanças reversíveis são exemplificadas principalmente pelas mudanças de estado físico, provocadas pelo aquecimento ou pelo resfriamento dos materiais. Já as mudanças irreversíveis incluem o preparo de alimentos, a combustão, a decomposição, a formação de ferrugem, entre outras. Por fim, são apresentadas as misturas de materiais do cotidiano, bem como os métodos utilizados para separar seus componentes.
HABILIDADES
• EF04CI01
• EF04CI02
• EF04CI03
OBJETIVOS DE APRENDIZAGEM
• Distinguir os estados físicos da matéria.
• Explicar as mudanças de estado físico dos materiais.
• Reconhecer que os materiais do cotidiano podem passar por transformações, quando submetidos a diferentes condições, como aquecimento, resfriamento e exposição à luz e à umidade.
• Classificar as transformações dos materiais em reversíveis e irreversíveis.
• Analisar diferentes exemplos de transformação irreversível dos materiais no cotidiano, como o preparo de alimentos, a combustão, a decomposição e a formação de ferrugem.
• Investigar, por meio de atividades práticas, as
UNIDADE
OS MATERIAIS E SUAS TRANSFORMAÇÕES 3


transformações dos materiais em diferentes contextos.
• Reconhecer diferentes tipos de mistura presentes no cotidiano.
• Classificar misturas do cotidiano com base em suas propriedades físicas observáveis, como cor, textura, densidade e solubilidade.
• Propor métodos de separação de misturas adequados para diferentes situações.
ENCAMINHAMENTO
A imagem de abertura pode ser utilizada como ponto de partida para articular o cotidiano dos estudantes com os conteúdos científicos da unidade. Ao propor a observação da cena, é possível incentivar os estudantes a descrever os componentes presentes e relacioná-los com experiências pessoais, criando um ambiente acolhedor e motivador para a aprendizagem. Aproveitar para comentar sobre os doces representados, que são comuns em festas de aniversário, alertando sobre a importância de evitar
Representação de crianças em comemoração de aniversário.
IMAGENS FORA DE PROPORÇÃO.
AS CORES NÃO SÃO REAIS


o consumo excessivo de açúcar no dia a dia.
Em seguida, podem ser feitas algumas perguntas para identificar os conhecimentos prévios da turma, como:
• O que acontece com a vela quando é acesa?
• Por que o balão de festa muda de forma quando é inflado?
• O que acontece com os ingredientes do bolo quando os misturamos e levamos ao forno?
As respostas dos estudantes podem orientar o planejamento das ações
pedagógicas seguintes, possibilitando adaptar explicações, experiências e intervenções.
02/10/25 15:55
Ressalta-se que, nesta unidade, os conceitos de material e substância são abordados de forma ampla, com o objetivo de evitar o excesso de termos que possam confundir os estudantes no estágio escolar em que se encontram. Matéria é tudo aquilo que ocupa espaço – ou seja, tem volume – e apresenta massa. Dessa forma, todos os materiais são constituídos por matéria. Já a definição de substância está relacionada a uma composição
constante de matéria, caracterizada pelas espécies químicas que a compõem (átomos e moléculas, por exemplo).
Para mais informações sobre o uso do conceito substância, recomenda-se a leitura do artigo indicado em Para o professor.
ORIENTAÇÕES E RESPOSTAS
1. Resposta pessoal. Os estudantes podem citar o papel dos chapéus de festa e dos docinhos, o plástico dos copos, a cera das velas, os tecidos das roupas e a borracha (látex) dos balões. Também é possível que citem os alimentos, a água e o gelo.
2. Resposta pessoal. Os estudantes podem citar que a chama da vela está queimando o pavio e derretendo a parafina ou que o gelo está derretendo no copo. Caso não comentem, questioná-los se a massa do bolo ou os ingredientes dos doces passaram por alguma transformação.
3. Resposta pessoal. Os estudantes podem citar, por exemplo, que o bolo foi feito pela mistura de vários ingredientes e que os doces foram decorados com diferentes coberturas.
PARA O PROFESSOR
TEXTO. SILVA, João R. R. T. Diversos modos de pensar o conceito de substância química na história da ciência e sua visão relacional. Ciência & Educação, Bauru, v. 23, n. 3, p. 707722, 2017. Disponível em: https://www.scielo.br/j/ ciedu/a/yDqGVxRRWxvM zHdq6HS 9Ztc/?format=p df&lang=pt. Acesso em: 18 ago. 2025.
Artigo que reúne discussões teóricas sobre o conceito de substância química.
ENCAMINHAMENTO
Para iniciar o trabalho com a abertura do capítulo, organizar os estudantes em um semicírculo e realizar uma breve contextualização, comentando que alguns alimentos podem receber nomes diferentes dependendo da região do Brasil. Como exemplo, citar a macaxeira, que também é conhecida como aipim ou mandioca.
Em seguida, perguntar se eles sabem como o geladinho (utilizar o nome mais comum no município em que a escola se localiza) é chamado em outras regiões do país. Alguns termos foram apresentados nas imagens, como chup-chup e dindim, mas existem outros exemplos, como gelinho, sacolé e jujuba.
Explicar que essas variações linguísticas estão relacionadas, muitas vezes, à cultura e aos costumes de cada região e que reconhecer e valorizar essa diversidade é parte importante da convivência e do respeito às diferentes formas de expressão presentes no Brasil.
Com base nesse contexto, orientar os estudantes a interpretar as imagens presentes na página. Explicar que a frase “Fiado só amanhã” é uma expressão popular bem-humorada usada por vendedores para indicar que não vendem a prazo. A ideia é que o “amanhã” nunca chega, ou seja, o fiado nunca será concedido.
Reservar um momento para que os estudantes respondam, coletivamente, às perguntas propostas, com base em suas percepções e vivências. Incentivar a escuta atenta e a valorização da fala de todos. Se julgar oportuno, orientar os estudantes a
CAPÍTULO
TRANSFORMAÇÕES REVERSÍVEIS DOS MATERIAIS
Analise as fotografias e leia as legendas a seguir. Todas se referem ao mesmo alimento.

Anúncio de venda de chup-chup na comunidade quilombola de Mumbuca. Jequitinhonha (MG), 2019.

Anúncio de venda de dindim no povoado de Soledade. Caxias (MA), 2014.

1. Você conhece o alimento citado nos anún cios? Como ele é chamado em sua região?
Consultar orientações e resposta no Livro do Professor
2. Você sabe como ele é feito? Converse com um colega sobre o assunto.
Consultar orientações e resposta no Livro do Professor
3. Durante o preparo, que mudança rela cionada à temperatura acontece com esse alimento?
Resposta pessoal. Espera-se que os estudantes digam que o suco foi congelado (sofreu solidificação).
4. Essa mudança pode ser desfeita?
Anúncio de venda de geladinho no Jardim Marieta. Londrina (PR), 2016.

anúncios das fotografias.
Sim, ele pode ser descongelado, voltando a ser líquido, caso seja retirado do congelador.
registrar, após a discussão em dupla, as respostas no caderno, que podem ser retomadas no decorrer do estudo, contribuindo para a construção e a avaliação do próprio aprendizado.
| ORIENTAÇÕES E RESPOSTAS
1. Resposta pessoal. Verificar se os estudantes conseguem identificar o alimento, cujo nome varia nas diferentes regiões do Brasil. Outros exemplos de nomes são sacolé, dudu, suquinho, gelinho e juju.
2. Resposta pessoal. Não se espera que os estudantes expliquem a receita em si, mas a forma como o alimento é feito: após o preparo, o suco (ou outra bebida) precisa ser congelado. Verificar a necessidade de direcionar os estudantes para esse foco. Aproveitar a atividade para desencorajar o consumo de açúcar e de alimentos ultraprocessados em excesso.
ESTADOS FÍSICOS DOS MATERIAIS
Na natureza, os materiais podem ser encontrados em diferentes estados físicos: sólido, líquido e gasoso.

Os materiais no estado sólido apresentam forma própria e ocupam um espaço definido. Uma cadeira, um de copo plástico ou de vidro e uma pedra de gelo são exemplos de materiais no estado sólido.
Copo com gelo em seu interior. Mesmo estando dentro do copo, o gelo, exemplo de material no estado sólido, ocupa um espaço definido.
Os materiais no estado líquido também ocupam um espaço definido, mas eles assumem a forma do recipiente no qual estão armazenados. O suco e a água são exemplos de materiais no estado líquido.
O suco assume a forma da jarra ou do copo, sendo um exemplo de material no estado líquido.


Já os materiais no estado gasoso não apresentam forma própria e ocupam todo o espaço que estiver disponível. O ar que respiramos é um exemplo de material no estado gasoso.
Menino enchendo pneu de bicicleta com ar. O ar, exemplo de material no estado gasoso, ocupa todo o espaço no interior do pneu da bicicleta.
ENCAMINHAMENTO
O tópico Estados físicos dos materiais fornece subsídios teóricos para o desenvolvimento posterior das habilidades EF04CI02 e EF04CI03, relacionadas às transformações dos materiais.
Ao iniciar o trabalho com a temática proposta, perguntar o que os estudantes sabem sobre os principais estados da matéria (sólido, líquido e gasoso) e se já observaram materiais que mudam de forma ou aparência em casa ou na escola. Essa troca inicial ajuda a ativar
conhecimentos prévios e desperta o interesse pelo assunto.
Em seguida, realizar a leitura do texto com a turma. A leitura pode ser feita de forma compartilhada, com pausas estratégicas para explicar termos científicos e destacar ideias centrais.
Além dos exemplos apresentados, incentivar os estudantes a mencionar materiais do cotidiano com os quais entram em contato frequentemente e a classificá-los de acordo com seu estado físico: sólido, líquido ou gasoso. Alguns
exemplos podem incluir água, rocha, leite e madeira. Esse momento pode ser aproveitado como uma oportunidade para avaliar a construção do conhecimento da turma de forma coletiva.
Destacar que a matéria não se apresenta apenas nos três estados físicos abordados. Existem também outros estados como o plasma, considerado o quarto estado físico da matéria. Esse estado ocorre em condições específicas de temperatura e pressão, como nas estrelas. Na Terra, ele pode ser observado em lâmpadas fluorescentes e em alguns fenômenos naturais, como a aurora boreal.
PHOTOONGRAPHY/SHUTTERSTOCK.COM
ENCAMINHAMENTO
O tópico Mudanças de estado físico oportuniza o desenvolvimento da habilidade EF04CI02, uma vez que propõe o estudo de transformações dos materiais no cotidiano, ocasionadas pelo aquecimento ou pelo resfriamento.
Orientar a leitura do infográfico da dupla de páginas com o objetivo de colaborar para o entendimento das mudanças de estado físico dos materiais, com base na representação de uma cena cotidiana em uma cozinha brasileira. Para direcionar essa análise, questionar os estudantes sobre o que veem na cena, quem são os personagens e o que estão fazendo. Em seguida, propor uma discussão sobre as transformações da matéria presentes na imagem, baseada nestas perguntas:
• O que está acontecendo com o gelo no copo da menina?
• O que leva a água líquida a passar para o estado de vapor na panela?
• O vapor pode virar água de novo? Como isso é possível?
• O que acontece com a água líquida que vai ao congelador?
A imagem apresenta um ambiente simples e familiar. Uma menina observa um copo com água e gelo, o qual está derretendo (detalhe em zoom), representando a fusão. Já na parte externa do copo há gotículas de água que escorrem formando uma poça de água na base, representando a condensação. Um homem adulto cozinha utilizando duas panelas. Um detalhe em zoom mostra água fervendo com bolhas repletas de vapor (representando a vaporização do tipo ebulição) e outro detalhe mostra a formação de gotículas de água na tampa de uma das panelas, representando a
MUDANÇAS DE ESTADO FÍSICO
Na natureza, os materiais podem mudar de estado físico. Esse processo natural pode acontecer, por exemplo, se houver mudanças de temperatura. Quando a temperatura de um material aumenta, ele pode mudar de estado físico, como de sólido para líquido ou de líquido para gasoso. Quando a temperatura diminui, esse material pode passar do estado líquido para o sólido, ou do gasoso para o líquido.
Observe os exemplos de mudança de estado físico da água.

Fusão: mudança do estado sólido para o estado líquido. Isso acontece, por exemplo, quando o gelo derrete ao ser deixado em um copo fora do congelador.
DIALOGANDO
Em duplas, observem com atenção o copo de água. Agora, considerem as seguintes informações. O ar apresenta vapor de água. O gelo no interior do copo deixou sua parede fria. O lado de fora do copo estava seco inicialmente. Respondam: De onde surgiram as gotinhas que escorrem por fora do copo?
Consultar orientações e resposta no Livro do Professor
condensação. Por fim, temos uma pessoa idosa colocando uma forma de gelo com água no congelador, representando a solidificação. Também há na imagem um pano de pia, pendurado e secando (representando a vaporização do tipo evaporação).
É importante que a turma compreenda que evaporação e ebulição são variações da vaporização, ou seja, a passagem do estado líquido para o gasoso. A evaporação ocorre de forma lenta, apenas na superfície do líquido e em qualquer temperatura, desde que haja fornecimento contínuo de calor do ambiente, como a
roupa secando ao sol. Já a ebulição ocorre de forma rápida, em todo o líquido, quando se fornece calor até atingir determinada temperatura (ponto de ebulição), formando bolhas visíveis (como a água fervendo a 100 °C ao nível do mar).
Orientar a análise da representação da ebulição/condensação e destacar que o vapor de água não é visível. O que geralmente chamamos de “fumaça” saindo da panela é, na verdade, o vapor de água que se condensou ao entrar em contato com o ar mais frio, formando pequenas gotículas suspensas no ar.
IMAGENS FORA DE PROPORÇÃO. AS CORES NÃO SÃO REAIS.
Vaporização (ebulição): mudança do estado líquido para o gasoso. Isso acontece, por exemplo, quando ocorre o aquecimento da água, que vira vapor, na panela sobre o fogão. Contudo, a fumaça que sai da panela é formada por gotículas de água. A água no estado gasoso não pode ser vista.
Condensação: mudança do estado gasoso para o líquido. Isso acontece, por exemplo, quando o vapor de água encosta em uma superfície mais fria, como a tampa da panela, formando gotinhas. Nesse caso, acontece o resfriamento da água.

Vaporização (evaporação): quando a vaporização acontece de maneira lenta, ela pode ser chamada de evaporação. Isso ocorre, por exemplo, com um pano ou uma roupa secando.
Solidificação: mudança do estado líquido para o sólido. Isso acontece, por exemplo, quando colocamos água no congelador e ela vira gelo. Nesse caso, acontece o resfriamento da água.
Representação de situações que envolvem mudanças de estados físicos da água em
cozinha caseira.
calor pode provocar mudanças no estado físico dos materiais.
21:08
Também não foram abordadas a sublimação, passagem direta do estado sólido para o gasoso, e a deposição, que é a passagem do estado gasoso para o sólido (também chamada de ressublimação). A sublimação pode ser observada no gelo-seco, quando o dióxido de carbono sólido passa diretamente ao estado gasoso. Já a deposição ocorre, por exemplo, na geada, na qual o vapor de água no ar se transforma em cristais de gelo.
Outro aspecto é que as mudanças de estado físico também podem ser influenciadas por variações nas condições de pressão. Por exemplo, no interior de uma panela de pressão – em que a pressão é mais elevada –, a água vaporiza a uma temperatura mais alta do que a observada em condições normais, acelerando o cozimento dos alimentos.
O boxe Dialogando oportuniza a mobilização da habilidade EF04CI02, ao solicitar a análise de transformações dos materiais no cotidiano.
| ORIENTAÇÕES E RESPOSTA
As gotinhas de água que escorrem do lado de fora do copo vieram do ar. O vapor de água presente no ar, ao entrar em contato com a superfície fria do copo, esfria e se condensa, passando do estado gasoso para o estado líquido. Para facilitar a compreensão das mudanças de estados físicos da matéria, compor na lousa um esquema que sintetize esses fenômenos, usando como exemplo a água, como o ilustrado a seguir.
Em razão do momento escolar, algumas informações não foram abordadas no Livro do Estudante, como o conceito de calor. De modo geral, ocorre a transferência de calor sempre que dois materiais com temperaturas diferentes entram em contato: o material mais quente transfere calor para o mais frio. Nesse processo, o primeiro esfria (sua temperatura diminui) e o segundo aquece (sua temperatura aumenta). Essa troca de
Fusão Vaporização
Solidi cação Condensação
uma
VOCÊ CIENTISTA!
O objetivo da atividade é testar e relatar as mudanças de estado físico da água, mobilizando a habilidade EF04CI02, e concluir que essas mudanças são reversíveis, mobilizando também a habilidade EF04CI03 . Ao longo da atividade, os estudantes vão elaborar e testar hipóteses, envolvendo-se em práticas científicas. Assim, desenvolvem a competência geral 2 e a competência específica 2 de Ciências da Natureza.
Para a realização desta atividade experimental, organizar previamente todos os materiais necessários e escolher um espaço adequado, de preferência bem iluminado pelo Sol.
Apresentar os procedimentos e destacar a importância do trabalho em equipe, do respeito às funções atribuídas e da escuta ativa entre os colegas. A colaboração e a empatia podem, assim, ser desenvolvidas, trabalhando a competência geral 9.
Na etapa de análise dos resultados, é importante realizar a descrição oral deles, estratégia que favorece a inclusão de estudantes com deficiência visual.
Ao final, propor à turma uma roda de conversa para discutir os resultados e realizar as atividades propostas.
Onde a água foi parar?
Você já reparou que, depois de algum tempo, as roupas molhadas no varal acabam ficando secas? Mas para onde essa água vai? Seria possível recuperar a água? Em grupos, conversem sobre o assunto, anotem as ideias no caderno e realizem a atividade a seguir.
DO QUE EU PRECISO
• Recipiente plástico alto e transparente
• Água
• Caneca ou outro recipiente que não flutue na água
• Papel-filme
• Elástico e régua
• Bolinha de gude ou de borracha
COMO FAZER
1. Coloquem água no recipiente plástico até atingir cerca de 5 centímetros de altura, medindo essa marca com a régua. Em seguida, coloquem a caneca no centro do recipiente.
2. Cubram a montagem com o papel-filme e prendam as bordas com elástico. O papel-filme não deve ficar totalmente esticado.
3. Posicionem a bolinha no centro do papel-filme que está cobrindo o recipiente, de maneira que ele fique levemente afundado.
4. Deixem a montagem em local com incidência solar direta por cerca de 4 horas e observem o que acontece.
VAMOS CONVERSAR?
DICA
Vocês podem colocar uma rocha no interior da caneca para ajudar a mantê-la no lugar, dentro do recipiente plástico.
Representação da montagem final.
Consultar orientações e respostas no Livro do Professor
1. O que se formou no papel-filme que cobre o recipiente? Expliquem esse resultado.
2. O que aconteceu com a caneca colocada dentro do recipiente?
3. Que mudanças do estado físico da água foram representadas na atividade? Alguma delas ocorreu devido a seu aquecimento ou resfriamento? Conversem sobre o assunto.
4. Se vocês colocassem um pedaço de pano encharcado com água no recipiente, seria possível obter o mesmo resultado? Reflitam sobre os resultados, analisando se eles foram semelhantes às ideias iniciais do grupo.
[...]
A descrição oral é uma estratégia pedagógica essencial para garantir a compreensão dos conteúdos científicos por alunos com deficiência visual. Pereira e Lima (2017) argumentam que, ao fornecer descrições detalhadas e claras dos experimentos e fenômenos científicos, os professores ajudam os alunos a construírem imagens mentais dos conceitos abordados. [...]
CABRAL, Luan Antônio dos Santos et al. Modelos didáticos no ensino de Ciências para alunos com deficiência visual. Journal of Social Issues and Health Sciences, Teresina, v. 1, n. 7, p. 112, 2014. p. 5. Disponível em: https://ojs.thesiseditora.com.br/index.php/jsihs/article/ view/233/202. Acesso em: 18 ago. 2025.
TEXTO DE APOIO
IMAGENS FORA DE PROPORÇÃO AS CORES NÃO SÃO REAIS
OS MATERIAIS MUDAM
No dia a dia, você já deve ter visto que os materiais podem passar por transformações.
Algumas são reversíveis, ou seja, o material pode se transformar e, depois, voltar a ser como era. As mudanças de estado físico são um exemplo de transformação reversível.
A água se solidifica, por exemplo, ao ser resfriada no congelador. Nesse processo, ela se transforma em gelo, que, por sua vez, ao ser aquecido, derrete e volta a ser água em estado líquido.
O ferro é outro exemplo. Ao ser aquecido a determinada temperatura, ele sofre fusão e passa do estado sólido para o líquido. Quando esfria, sofre solidicação e passa novamente para o estado sólido.

| ORIENTAÇÕES E RESPOSTAS
1. Formaram-se gotículas de água. A água foi aquecida pelo sol, de modo que parte dela evaporou e, em seguida, se condensou ao entrar em contato com a superfície do papel-filme, formando as gotículas.
2. Coletou um pouco de água em seu interior. Essa água corresponde à que havia se condensado no papel-filme e que, depois, escorreu na direção da caneca.
3. Na atividade, foram representadas a vaporização (passagem do estado líquido
o tempo. Esse vapor se resfriaria e se condensaria ao entrar em contato com o papel-filme, formando gotículas de água. Dessa forma, pode-se afirmar que a água evaporada seria recuperada. Orientar os estudantes a ler novamente no caderno as hipóteses que elaboraram inicialmente e a compará-las com os resultados obtidos. Esta atividade oportuniza a mobilização da habilidade EF04CI03
ENCAMINHAMENTO
O tópico Os materiais mudam colabora para o desenvolvimento da habilidade EF04CI03, relacionada à classificação das transformações dos materiais em reversíveis ou irreversíveis.
Moldes sendo preenchidos com ferro no estado líquido em indústria em Cambé (PR), 2023. Os moldes são usados para definir a forma em que um material vai ser solidificado.
Iniciar o trabalho retomando os resultados da atividade prática realizada anteriormente. Perguntar aos estudantes se, ao “recuperar” a água líquida que havia vaporizado, essa situação representa uma transformação reversível ou irreversível. Ao concluírem que se trata de uma transformação reversível, aproveitar o momento para revisar outros exemplos já estudados de mudanças de estado físico, como o congelamento da água e sua fusão – que também são exemplos de transformações reversíveis.
02/10/25 15:55
para o gasoso) e a condensação (passagem do estado gasoso para o líquido) da água. Sim, ambas ocorreram devido ao aquecimento ou ao resfriamento. A vaporização ocorreu devido ao aquecimento da água pelo sol, já a condensação ocorreu em razão do resfriamento do vapor de água pela superfície do papel-filme. Esta atividade oportuniza a mobilização da habilidade EF04CI02.
4. Sim. Se um pedaço de pano encharcado com água fosse colocado dentro do recipiente, a água presente no tecido também se transformaria em vapor com
VOCÊ LEITOR!
O trabalho com a tirinha apresentada permite aos estudantes exercitar a leitura, a interpretação de texto e a aplicação de conceitos científicos no cotidiano. Colabora-se, assim, para a compreensão dos processos de mudança de estado físico da água –como fusão e vaporização (nesse caso, evaporação) – a partir da observação de uma situação representada de forma lúdica.
Pedir aos estudantes que observem com atenção a cena de cada quadrinho e, depois, leiam a tirinha relacionando o texto verbal com o não verbal. Desse modo, são desenvolvidas as habilidades de Língua Portuguesa indicadas a seguir.
• EF15LP04: Identificar o efeito de sentido produzido pelo uso de recursos expressivos e gráfico-visuais em textos multissemióticos.
• EF15LP14 : Construir o sentido de histórias em quadrinhos e tirinhas, relacionando imagens e palavras e interpretando recursos gráficos (tipos de balões, de letras, onomatopeias).
• EF15LP18 : Relacionar texto com ilustrações e outros recursos gráficos. Os estudantes também podem ser incentivados a pensar em outras situações do dia a dia que envolvam esses fenômenos, aproximando o conteúdo escolar de suas experiências pessoais. É importante destacar que, na última cena da tirinha, a “fumaça” ilustrada representa o vapor de água. No entanto, conforme já foi mencionado, do ponto de vista científico, essa representação está incorreta, pois o vapor de água é invisível. Portanto,
4. a) Foram retratadas: fusão (passagem do estado sólido para o líquido) e vaporização (passagem do estado líquido para o gasoso). Também pode ser indicada a condensação (passagem do estado gasoso para o líquido), evidenciada pela nuvem no último quadrinho e pela “fumaça” subindo de onde antes estava a poça de água.
VOCÊ LEITOR!
Do gelo ao vapor
Leia a tirinha a seguir e responda às questões no caderno.

1. O que o personagem está fazendo?
Ele está observando as mudanças de estado físico da água.
2. O personagem diz que a água tem um “caso de personalidade tripla”. A que se refere essa expressão?
A expressão faz referência aos três estados físicos da água: sólido, líquido e gasoso.
3. No último quadrinho, aparece uma “fumaça” saindo do chão. Considerando que a água no estado gasoso não é visível, essa representação está correta?
Não. A água no estado gasoso não é visível; portanto, representá-la como uma “fumaça” não está correto.
4. Observe o esquema a seguir, com as mudanças de estado físico dos materiais.
4. b) A solidificação (passagem do estado líquido para o sólido). Caso os estudantes não a tenham citado na atividade anterior, lembre-os da condensação.

a) Quais mudanças representadas nesse esquema também podem ser identificadas na tirinha?
b) Qual mudança aparece no esquema, mas não foi retratada na tirinha?
c) No caderno, faça uma história em quadrinhos que envolva pelo menos uma mudança de estado físico. Use a criatividade para inventar personagens e uma situação divertida. Crie um cenário e componha as falas dos personagens escritas em balões de fala ou pensamento. A história deve conter três quadrinhos, representando o começo, o meio e o fim da história.
Produção pessoal. Incentivar e orientar os estudantes a desenvolver a história em quadrinhos. Essa atividade permite uma abordagem integrada com Língua Portuguesa e com Arte.
vale lembrar que, em tirinhas, histórias em quadrinhos, contos e diversos outros gêneros textuais, o autor tem liberdade criativa para utilizar recursos visuais e narrativos que facilitem a compreensão da mensagem desejada, mesmo que isso envolva imprecisões científicas.
A representação da nuvem, por sua vez, está correta. As nuvens são formadas por gotículas de água condensadas, o que as torna visíveis no céu. Elas se formam quando o vapor de água presente na atmosfera se resfria e se condensa ao encontrar camadas de ar mais frias.
Tira do Bidu no 6 352, Banco de Imagens MSE.
NÃO ESCREVA NO LIVRO.
ATIVIDADES
1. Leia o texto a seguir e observe as ilustrações.
Existem determinadas lentes de óculos que mudam de cor dependendo das condições do ambiente. Em ambientes pouco iluminados, esses tipos de lente ficam transparentes. Em ambientes bem iluminados, as lentes desses óculos ficam escuras, ajudando a proteger os olhos e proporcionando maior conforto visual. Elas voltam a ser transparentes em ambientes claros.
IMAGENS FORA DE PROPORÇÃO
AS CORES NÃO SÃO REAIS.
Representação de como ficam as lentes mencionadas no texto, dependendo das condições do ambiente.
Consultar orientações e respostas no Livro do Professor
a) No exemplo citado, a cor das lentes muda quando elas são expostas a alterações em que tipo de condição: temperatura, umidade ou luz? Explique sua resposta.
b) Essa mudança na cor das lentes é um exemplo de transformação reversível? Explique sua resposta.
2. Ao tomar banho com água morna ou quente, é comum que, após um tempo, a superfície dos objetos do banheiro, como o espelho, fique úmida, conforme observado na imagem.
a) Por que a superfície do espelho fica úmida nessa situação? Explique considerando as mudanças de estado físico da água envolvidas.
Consultar orientações e resposta no Livro do Professor
b) Alguma dessas mudanças ocorre devido ao aquecimento da água? E ao resfriamento? Explique suas respostas.
Consultar orientações e resposta no Livro do Professor

c) Essa situação evidencia transformações reversíveis da água? Justifique sua resposta. Sim, pois a água líquida se transforma em vapor durante o banho e, depois, ao entrar em contato com superfícies frias, volta ao estado líquido inicial.
| ORIENTAÇÕES E RESPOSTAS
1. a) Luz. As lentes mudam de cor conforme muda a intensidade da luz do ambiente.
b) Sim. Mesmo que a cor das lentes mude em ambientes iluminados, elas retornam a seu estado inicial em ambientes pouco iluminados ou na ausência de luz.
Esta atividade possibilita o desenvolvimento da habilidade EF04CI02, que envolve a análise de transformações nos materiais do dia a dia quando expostos a diferentes condições de luz.
de água líquida que se formam quando o vapor entra em contato com o ar mais frio do ambiente e se condensa.
Esta atividade também possibilita a mobilização das habilidades EF04CI02 e EF04CI03, contudo em outro contexto: o das mudanças de estado físico da água que podem ocorrer durante o banho.
02/10/25 15:55
2. a) Porque a água no estado gasoso (vapor) resfria ao entrar em contato com superfícies mais frias, como a do espelho, passando do estado gasoso para o líquido.
b) Sim. A água do chuveiro passa para o estado de vapor devido ao aquecimento e condensa na superfície do espelho ao sofrer resfriamento.
Ao explorar esta atividade, retomar a discussão sobre a “fumaça” que fica no banheiro após um banho quente. Na realidade, o que vemos não é vapor de água, que é invisível, mas sim gotículas
NÃO ESCREVA NO LIVRO.
DIPRES/SHUTTERSTOCK.COM
3. a) A fusão é a passagem do estado sólido para o estado líquido, geralmente quando há aquecimento do material. Um exemplo dessa mudança é um picolé derretendo.
b) Sugestão de palavra na vertical: gasoso. Sugestão de cruzadinha: 1) Nome comumente dado aos materiais no estado gasoso. (gás); 2) Mudança do estado físico líquido para o sólido. (solidificação); 3) Mudança do estado físico sólido para o líquido. (fusão); 4) Estado físico que não tem forma própria, não é gás, e ocupa o espaço onde se encontra (líquido); 5) Transformação na qual, após a mudança, o material pode retornar a seu estado inicial. (reversível); 6) Mudança do estado físico gasoso para o estado líquido. (condensação) O uso de jogos como cruzadinhas torna o aprendizado mais dinâmico e aumenta o engajamento estudantil. Para aprofundar esse tema, sugere-se a leitura do Texto de apoio. 4. Embora a mudança seja reversível, o aspecto do chocolate após passar novamente para o estado sólido pode não ser idêntico ao original. Isso acontece porque, durante o resfriamento, os cristais de gordura da manteiga de cacau podem se reorganizar de forma diferente, deixando o chocolate opaco ou com textura mais quebradiça. Nesse caso, embora o chocolate não se transforme em outro material, ele deve passar por um processo adequado de resfriamento para recuperar brilho, textura e consistência semelhantes às originais (temperagem). Aproveitar a atividade para conversar com a turma sobre a importância para a saúde
3. Observe a cruzadinha a seguir, que já está resolvida, e depois faça o que se pede.
1 Metal usado para fazer pregos que, à temperatura ambiente, é sólido.
2 Estado físico da água que sai da torneira.
3 Estado físico em que um material apresenta forma própria e espaço definido.
4 Mudança do estado físico líquido para o gasoso.
5 Forma como em geral é chamada a água congelada.
1 F E R R O
2 L Í Q U I D O
3 S Ó L I D O
4 V A P O R I Z A Ç Ã O
Consultar orientações e respostas no Livro do Professor
5 G E L O
a) A palavra que surgiu na vertical da cruzadinha indica uma mudança de estado físico. Explique essa mudança com um exemplo.
b) Agora é sua vez! Em duplas, façam uma cruzadinha no caderno usando palavras do dia a dia que se refiram ao assunto deste capítulo. Ela deve formar, em uma linha vertical, uma palavra que represente um dos estados físicos dos materiais.
4. a) A barra de chocolate está derretendo, ou seja, está
passando do estado sólido para o estado líquido. Ela está sofrendo fusão.
4. Observe a fotografia e responda às questões.
Consultar orientações no Livro do Professor.
a) Que tipo de mudança de estado físico está acontecendo na imagem?
b) Explique com suas palavras se essa mudança é reversível.
c) Cite um exemplo de mudança reversível com a água.
4. c) O gelo derrete (sofre fusão), convertendo-se em água líquida. Essa água pode voltar a virar gelo (sofrer solidificação) ao ser colocada em um congelador.
Pessoa segurando uma barra de chocolate.
4. b) Sim, é reversível. Se o chocolate derretido for colocado no interior da geladeira, ele volta a endurecer e fica sólido novamente.
de evitar o consumo constante de chocolate, principalmente os ultraprocessados e ricos em açúcar, gordura e aditivos artificiais.
TEXTO DE APOIO
[...]
O uso de palavras cruzadas no ensino [...], por exemplo, é uma solução de efeito lúdico para a didática proposta em sala de aula, propiciando estímulosrespostas para ambos os sujeitos da educação, além de ser um recurso didático de baixo custo e desencadear uma série de fatores mentais que contribuirão na aprendizagem

de conceitos e teorias. De acordo com BennedettiFilho et al. (2013), a utilização das palavras cruzadas como ferramenta didática procura estimular o desafio e a curiosidade dos estudantes, facilitando o trabalho de construção do conhecimento.
[...]
PASSOS, Tainara L. de S. et al. Palavras cruzadas: uma alternativa metodológica para o ensino e aprendizagem de Biologia. In: OLIVEIRA, Neyla Cristiane R. de; SILVA, Geilza Carla de L. (org.). Ensino de Ciências e Biologia em foco. Teresina: Wissen, 2023. v. 2. p. 6270. Disponível em: https://bio10editora.com.br/bio10ed/catalog/ view/51/45/219. Acesso em: 3 set. 2025.
NÃO ESCREVA NO LIVRO.
TRANSFORMAÇÕES IRREVERSÍVEIS DOS MATERIAIS
Leia o texto, observe a imagem e responda às questões.
A descoberta que mudou a humanidade
Há centenas de milhares de anos, nas noites frias de inverno, a escuridão era um grande inimigo. Sem a lua cheia, a [...] noite, além de assustadora, era perigosa. Havia muitos predadores […] que poderiam atacar facilmente enquanto dormíamos. O frio intenso era outro inimigo. Não eram fáceis os primeiros passos da humanidade […].
[…]
Até que, um dia, talvez ao observar uma árvore atingida por um raio, […] descobriram algo que modificaria completamente o rumo da nossa evolução: o fogo. Ao dominar essa entidade, foi possível se aquecer, proteger-se dos predadores e ainda cozinhar os alimentos. […]
OLIVEIRA, Adilson de. A descoberta que mudou a humanidade. Ciência Hoje, Rio de Janeiro, c2025. Disponível em: https://cienciahoje.org.br/coluna/a-descoberta-que-mudou-a-humanidade/ Acesso em: 20 maio 2025.
IMAGENS FORA DE PROPORÇÃO AS CORES NÃO SÃO REAIS
Representação de seres humanos de milhares de anos atrás vivendo em caverna e fazendo uso do fogo.









consultar orientações e respostas no Livro do Professor
1. De que maneira o fogo ajudou os seres humanos de milhares de anos atrás a enfrentar os desafios mostrados na representação e citados no texto?
2. Observe novamente a representação. Ela apresenta diversas transformações de materiais. Quais transformações você consegue identificar?
ENCAMINHAMENTO
Iniciar contextualizando o tema da leitura proposta, explicando que o texto trata do domínio do fogo pelos seres humanos há milhares de anos e de como isso alterou profundamente a vida humana. Destacar que o controle do fogo permitiu transformar materiais, cozinhar alimentos e modificar objetos, impactando diretamente o cotidiano e a evolução humana.
O trabalho com a temática do domínio do fogo é uma oportunidade para
transformações mencionadas no texto, como:
• Que materiais foram alterados?
• De que forma o fogo mudou suas propriedades?
• Que consequências essas mudanças trouxeram para o cotidiano dos seres humanos?
Para aprofundar a compreensão, organizar uma atividade em grupo na qual os estudantes devem discutir coletivamente e registrar seus apontamentos.
|
ORIENTAÇÕES E RESPOSTAS
1. Os estudantes podem indicar que o fogo ajudou a espantar predadores, a iluminar e aquecer o ambiente e a preparar alimentos.
2. Resposta pessoal. Uma das cenas apresenta a produção de lanças de madeira e rocha. Outras cenas que podem ser apontadas pelos estudantes são a carne sendo assada no fogo e a madeira sendo queimada. Após a apresentação do conceito, retorne a esta página e questione-os sobre a reversibilidade das transformações representadas. Todas essas transformações são irreversíveis.
03/10/25 21:10
trabalhar, de forma integrada, com o componente curricular de História, contribuindo para o desenvolvimento da habilidade indicada a seguir.
• EF04HI02 : Identificar mudanças e permanências ao longo do tempo, discutindo os sentidos dos grandes marcos da história da humanidade (nomadismo, desenvolvimento da agricultura e do pastoreio, criação da indústria etc.).
Após a leitura, propor uma discussão orientada por perguntas que ajudem os estudantes a identificar as
NÃO ESCREVA NO LIVRO.
ENCAMINHAMENTO
O tópico Os materiais passam por mudanças irreversíveis dá continuidade ao desenvolvimento da habilidade EF04CI03
Iniciar a aula retomando as mudanças reversíveis, já estudadas nesta unidade. Em seguida, explicar que, em algumas situações, os materiais passam por transformações irreversíveis, isto é, não podem retornar ao seu estado original. De maneira geral, essas mudanças podem ser físicas ou químicas. Um exemplo de mudança física irreversível é retirar lascas de uma madeira: sua composição química não se altera, mas não é possível recompor o pedaço original. Já a mudança química irreversível ocorre quando a madeira é queimada, pois sua constituição se transforma, formando novas substâncias, como cinzas e fumaça.
Promover uma contextualização com situações do cotidiano, especialmente no preparo de alimentos, que é familiar aos estudantes. Por exemplo, o preparo de um bolo: ao misturar farinha, ovos, leite, óleo, açúcar e fermento e levar ao forno, o calor altera a estrutura dos ingredientes, de modo que, após assado, não é possível recuperá-los em seu estado original. Isso caracteriza uma mudança irreversível. Outros exemplos incluem cozinhar um vegetal ou assar pão.
No tópico Preparo de alimentos , aproveitar a sequência de imagens, que mostra a mudança na aparência do ovo durante diferentes tempos de cozimento, para abordar as transformações irreversíveis ocasionadas pelo aquecimento dos materiais. Outros exemplos de
OS MATERIAIS PASSAM POR MUDANÇAS IRREVERSÍVEIS
Como vimos, os materiais passam por transformações, sendo algumas delas reversíveis, como as mudanças de estado físico.
Outras mudanças são irreversíveis, ou seja, depois que acontecem, o material formado não volta a ser como era. Entre os exemplos observados no dia a dia, podemos citar o preparo de alimentos, a combustão, a decomposição e a ferrugem.
PREPARO DE ALIMENTOS
Ao serem cozidos, o aspecto dos alimentos, como textura, cor e sabor, pode mudar. Por exemplo, a clara do ovo cru é praticamente transparente, e a gema tem uma textura mais líquida. Ao cozinhar o ovo, a clara fica branca e endurece, e a gema também endurece. Essas mudanças são irreversíveis, pois não é possível fazer o ovo voltar a seu estado inicial depois de cozido.
Sequência que mostra a aparência do ovo durante diferentes tempos de cozimento. Cada número indica o tempo de cozimento em minutos (min). Observe que 0 min indica que o ovo ainda estava cru, sem cozimento.

transformações irreversíveis são explorados nas próximas páginas, como a combustão, a decomposição e a formação de ferrugem.
ATIVIDADES
Organizar a turma em pequenos grupos e propor que identifiquem exemplos de transformações reversíveis e irreversíveis dos materiais em situações do dia a dia. Cada grupo deve fazer uma lista com três exemplos de cada tipo de transformação, registrando-os no caderno. Ao
final, reservar um momento para que compartilhem suas respostas com a turma, justificando suas escolhas.
Esta atividade propicia a integração com Língua Portuguesa, ao propor o trabalho com o gênero textual lista, além de ser uma oportunidade para o exercício da habilidade EF04CI03. Os registros dos estudantes podem ser utilizados para avaliação do aprendizado sobre a temática.
COMBUSTÃO
A combustão, também chamada de queima, é outro exemplo de transformação irreversível dos materiais. Esse processo acontece na presença do gás oxigênio e produz diferentes tipos de gases, como o gás carbônico e o monóxido de carbono.
Em várias situações do dia a dia, observamos o uso da combustão. A queima da madeira, muito usada para acender fogueiras em festas típicas, é um exemplo. Quando a madeira queima, ela se transforma em carvão vegetal, um material escuro que pode ser usado para várias finalidades.

Mulher quilombola dançando carimbó ao redor de fogueira feita com a queima da madeira. Mocajuba (PA), 2022.
Outro exemplo do uso da combustão é a queima do gás usado em fogões presentes em muitas casas. Nesse caso, o gás de cozinha, ao ser queimado, gera a chama usada para cozinhar os alimentos.
A queima de combustíveis nos motores de carros, aviões e outros meios de transporte também é um exemplo de combustão. Nesses casos, a queima permite o movimento das peças do motor, o que faz os veículos se deslocarem.

ENCAMINHAMENTO
No tópico Combustão, abordar exemplos comuns desse tipo de transformação irreversível, como a queima de papel, madeira e carvão, o acendimento de uma vela ou o funcionamento de um motor de veículos movidos a combustão interna.
As fogueiras fazem parte de tradições culturais, como as festas juninas. Ressaltar que, nesses casos, o uso da madeira deve obedecer às determinações vigentes, estabelecidas por órgãos competentes (estaduais ou municipais) que
dos povos que formaram o Brasil. Além disso, promove a integração com os componentes curriculares de Arte e História, pois o carimbó é Patrimônio Cultural Imaterial do Brasil.
TEXTO DE APOIO
[...]
Grande parte dos registros apresenta o carimbó como uma invenção dos negros escravos que habitavam esta parte da Amazônia no século XVII [...]. De acordo com estas considerações, teria ocorrido uma junção do ritmo/ dança com elementos da cultura indígena e europeia, dando origem a uma manifestação singular, representada hoje pelos grupos que se espalham como miríades por vários municípios do Estado do Pará, sobretudo, pelos localizados no litoral norte de seu território.
[...]
Trânsito de veículos em Salvador (BA), 2021. A maioria dos carros e dos caminhões funciona por motores a combustão.
02/10/25 15:56
proíbem o corte de árvores sem a devida autorização. Aproveitar para destacar a importância da conservação ambiental e do combate ao desmatamento. Destacar que o carimbó é uma manifestação cultural tradicional do estado do Pará, com fortes raízes indígenas e africanas. Assim, é possível desenvolver a competência geral 3, além de trabalhar o Tema Contemporâneo Transversal (TCT) Educação para valorização do multiculturalismo nas matrizes históricas e culturais brasileiras, promovendo o respeito às heranças culturais
Geralmente, são utilizados dois ou três carimbós (também conhecidos como curimbós, são tambores feitos do tronco de árvores ocadas, tendo uma de suas extremidades coberta por couro de boi, veado ou outro animal), um par de maracas, milheiro (instrumento de zinco, com som agudo similar ao da maraca), a onça (instrumento semelhante à cuíca, que produz um som grave), um pandeiro, um banjo e um instrumento de sopro (podendo ser flauta, clarinete ou saxofone). [...]
INSTITUTO DO PATRIMÔNIO HISTÓRICO E ARTÍSTICO NACIONAL. Inventário Nacional de Referências Culturais: carimbó: dossiê. Belém: Iphan, 2014. Disponível em: https://bcr. iphan.gov.br/wpcontent/uplo ads/tainacanitems/65968/ 91581/DossiedeRegistroCarim bo.pdf. Acesso em: 27 ago. 2025.
VOCÊ CIDADÃO!
Esta seção promove uma reflexão sobre os impactos ambientais causados pela exploração do petróleo e, principalmente, pelo uso de combustíveis dele derivados, abordando o Tema Contemporâneo Transversal (TCT) Educação ambiental. Também trata da relação entre ciência, sociedade e sustentabilidade, reconhecendo a necessidade de buscar fontes de energia menos poluentes, colaborando para o desenvolvimento das competências específicas 3 e 4 de Ciências da Natureza
Recomenda-se iniciar a discussão associando o petróleo a exemplos práticos do cotidiano dos estudantes, como o abastecimento de veículos com combustíveis, a fabricação de plásticos, cosméticos, tintas, entre muitos outros produtos utilizados diariamente.
Em seguida, explicar que, apesar de sua utilidade, a exploração e o uso do petróleo trazem consequências ambientais significativas. Uma delas é a emissão de diversos gases poluentes na atmosfera durante a queima de combustíveis dele derivados, como gasolina e diesel. Por exemplo, o monóxido de carbono (CO), um gás invisível e sem cheiro, pode ser altamente prejudicial à saúde humana por dificultar o transporte de gás oxigênio no sangue. Além disso, o gás carbônico, também conhecido por dióxido de carbono (CO₂), é responsável pela intensificação do efeito estufa, e os óxidos de nitrogênio contribuem para a formação da chuva ácida e para a poluição do ar. A queima de combustíveis à base de biomassa também libera monóxido de carbono, gás
VOCÊ CIDADÃO!
A queima de combustíveis e o ambiente
O petróleo é um material da natureza que o ser humano extrai de reservas no subsolo e utiliza como matéria-prima para fabricar muitos produtos. Entre eles estão alguns combustíveis, como a gasolina e o óleo diesel, utilizados no funcionamento de veículos e máquinas. Quando esses combustíveis são queimados, liberam gases que poluem o ar e podem causar doenças respiratórias.
Para ajudar a minimizar esses problemas, é importante buscar formas de reduzir o uso desses combustíveis. Algumas ações que podem ser adotadas no cotidiano incluem usar o transporte público e andar de bicicleta ou a pé, sempre que possível. Também é preciso que os países invistam em combustíveis alternativos, menos poluentes. Dessa forma, podemos garantir um futuro melhor para as próximas gerações.
A construção de ciclovias, por exemplo, é uma ação do governo que ajuda a reduzir o consumo de petróleo. Ela estimula o uso de bicicleta como meio de transporte, de modo a diminuir a emissão de poluentes no ar.

1. Como a queima dos combustíveis derivados do petróleo pode prejudicar o ambiente e os seres vivos?
2. A queima dos combustíveis derivados do petróleo é uma transformação reversível ou irreversível? Expliquem.
3. O texto cita algumas atitudes que podem ser adotadas para reduzir o uso de combustíveis derivados do petróleo. Quais são elas? Produzam cartazes sobre essas ações para incentivar outras pessoas.
carbônico e outros compostos tóxicos. Contudo, a vantagem desses combustíveis está no fato de que, durante o cultivo da biomassa, o gás carbônico é recapturado da atmosfera, neutralizando a sua emissão.
| ORIENTAÇÕES E RESPOSTAS
1. A queima desses materiais libera gases que poluem o ar e podem prejudicar a saúde das pessoas, ocasionando doenças respiratórias.
2. É uma transformação irreversível. Após a combustão, são formados outros
produtos, que não voltam a ser o combustível inicial. Esta atividade oportuniza a mobilização da habilidade EF04CI03
3. Atitudes individuais: usar transporte público, andar de bicicleta ou a pé sempre que possível. Atitudes governamentais: investir em combustíveis alternativos, menos poluentes, e na construção de infraestrutura como corredores de ônibus e ciclovias. Orientar os estudantes na confecção de cartazes, que podem conter desenhos sobre o tema. Verificar a possibilidade de expô-los na escola, de modo a promover a consciência
NÃO ESCREVA NO LIVRO.
Ciclovia em Curitiba (PR), 2025.
Consultar orientações e respostas no Livro do Professor
DECOMPOSIÇÃO
Você já estudou que a decomposição se trata de um processo pelo qual a matéria orgânica é quebrada em partes mais simples e devolvida ao solo, onde pode ser reaproveitada pelas plantas. Quando as plantas absorvem esses nutrientes, eles voltam a fazer parte das cadeias alimentares. A decomposição também é um exemplo de transformação irreversível.

FERRUGEM
Morangos em início de decomposição.
A ferrugem é uma transformação irreversível que acontece com objetos feitos de ferro. Nesse processo, o ferro reage com o gás oxigênio presente no ar e com a umidade, formando uma camada marrom-avermelhada na superfície do objeto.
Mesmo que a ferrugem seja removida com uma lixa, isso não significa que o processo foi desfeito. O ferro já passou por uma transformação, e a parte que enferrujou não volta a ser como antes. Porém, ela pode ser retirada do objeto.


ambiental da comunidade escolar. Esta atividade incentiva ações responsáveis, embasadas em conhecimentos científicos e em princípios sustentáveis, colaborando para o desenvolvimento da competência geral 10 e da competência específica 8 de Ciências da Natureza
ENCAMINHAMENTO
No tópico Decomposição, ao trabalhar esta como um processo irreversível, relembrar a ação de decompositores sobre restos orgânicos e a importância ambiental desse processo, assuntos estudados
na unidade 2, durante a abordagem da habilidade EF04CI06.
02/10/25 15:56
No tópico Ferrugem , ao abordar o tema, explicar que se trata da oxidação do ferro em contato com o gás oxigênio e a umidade. Essa reação química também é irreversível e altera a estrutura do material, podendo causar danos a objetos e estruturas metálicas. Mostrar exemplos visuais, como pregos enferrujados ou bicicletas deixadas na chuva. Comentar que a ferrugem pode ser removida de diferentes formas, como pelo lixamento (remoção mecânica da camada
enferrujada) ou por processos químicos específicos (remoção química da camada enferrujada). No entanto, reforçar que essa remoção não transforma a ferrugem novamente em metal. Ou seja, mesmo retirando a camada enferrujada, o material metálico perdido não é recuperado. É importante que os estudantes compreendam que a exposição à umidade pode provocar transformações nos materiais, desenvolvendo, assim, a habilidade EF04CI02. Aproveitar para discutir formas de prevenir esse processo, como o uso de tintas protetoras à base de óleo. Nesse caso, o óleo impede o contato da umidade com o material metálico, evitando a formação de ferrugem – processo evidenciado na atividade prática da seção Você cientista! da página 94.
Pregos de ferro sem ferrugem.
Pregos de ferro enferrujados.
ORAYA/SHUTTERSTOCK.COM
O objetivo da atividade é investigar a formação de ferrugem em pedaços de palha de aço mantidos em diferentes condições: um submerso em água e outro em óleo. A proposta contribui para o desenvolvimento da habilidade EF04CI02, ao possibilitar a observação de transformações nos materiais provocadas pela presença de umidade.
Para a realização da atividade experimental, organizar previamente os materiais necessários e escolher um espaço adequado, garantindo a segurança e o engajamento de todos. Dividir a turma em grupos de cinco estudantes, incentivando a colaboração e o exercício da empatia, conforme a competência geral 9.
Antes de realizar o experimento, reservar um momento para que os grupos elaborem suas ideias (hipóteses) sobre a pergunta inicial, colaborando para o desenvolvimento da competência geral 2 e da competência específica 2 de Ciências da Natureza. Pedir que registrem suas hipóteses no caderno, as quais poderão ser retomadas ao final do experimento, durante a discussão dos resultados.
Como alternativa à montagem do experimento, é possível orientar os estudantes a manter o pedaço de palha de aço úmido no copo 1, sem submergi-lo em água.
É importante orientar os estudantes sobre o descarte adequado do óleo utilizado na atividade. Ele não deve ser jogado na pia, no ralo ou no vaso sanitário, pois pode causar entupimentos e contaminar a água e o solo. O ideal é armazenar o óleo usado em um recipiente com tampa e levá-lo a um ponto de coleta
Proteção contra ferrugem
Muitos objetos são feitos de ferro e podem enferrujar. Em grupos, respondam: Como é possível evitar a formação de ferrugem? Anotem as ideias no caderno e façam a atividade a seguir.
• 2 pedaços de palha de aço de tamanhos parecidos
• 2 copos descartáveis numerados com 1 e 2
1. No copo 1, adicionem água até a metade. No copo 2, adicionem a mesma quantidade de óleo.
2. Usando a colher, segurem cada palha de aço e a mergulhem até ficar submersa em cada um dos copos.
• Papel-filme e fita adesiva
• Água e óleo de cozinha
• Colher
3. Tapem os dois conjuntos com pedaços de papel-filme e prendam com fita adesiva, de forma a vedar bem.
Representação da montagem do experimento.
4. Observem o aspecto dos líquidos e dos pedaços de palha de aço. Façam registros no caderno.
5. Deixem a montagem em repouso por 7 dias. Depois, observem novamente o aspecto de cada palha de aço. Registrem o resultado no caderno.
VAMOS CONVERSAR?
Consultar orientações e respostas no Livro do Professor.
1. Houve diferenças entre os aspectos dos pedaços de palha de aço nos dois copos depois de 7 dias? Em caso positivo, descreva-as.
2. Como vocês explicariam essa diferença, considerando os líquidos utilizados?
3. Para evitar a formação de ferrugem em portões de ferro, costuma-se utilizar tinta à base de óleo. Explique o motivo de usar esse tipo de tinta, com base nos resultados da atividade prática.
4. As ideias que tiveram inicialmente foram confirmadas com essa atividade prática?
específico para descarte ou reciclagem, se disponível na comunidade. Essa orientação também se aplica ao uso do óleo em outras situações, como no preparo de alimentos. É importante incentivar os estudantes a compartilhar essas informações com os familiares, promovendo práticas sustentáveis também em casa.
| ORIENTAÇÕES E RESPOSTAS
Você cientista!
1. Espera-se que a palha de aço deixada na água (copo 1) tenha apresentado aspecto de ferrugem, enquanto a que
ficou no óleo (copo 2), não. A ferrugem se caracteriza pela cor marrom-avermelhada na superfície do objeto.
2. Espera-se que os estudantes reconheçam que a ferrugem é uma transformação que acontece na presença de gás oxigênio e umidade. A palha de aço do copo 1 teve contato com esse gás e com a umidade por estar submersa em água. Já a palha de aço do copo 2 não teve contato com esse gás nem com a umidade, pois o óleo o impediu.
3. A tinta à base de óleo forma uma camada que impede o contato do ferro do
papel-filme
água óleo
palha de aço
palha de aço
papel-filme fita adesiva
papel-filme
água óleo
IMAGENS FORA DE PROPORÇÃO. AS CORES NÃO SÃO REAIS.
ATIVIDADES
1. Observe as transformações retratadas nas fotografias a seguir e, no caderno, identifique-as como mudança reversível ou mudança irreversível.
A: mudança reversível; B: mudança irreversível.


Consultar orientações no Livro do Professor
ATIVIDADES


Folha de papel nova e durante a queima.
2. A cerâmica marajoara é uma importante expressão cultural do povo indígena Marajoara, que viveu há mais de mil anos na região da Ilha de Marajó, no atual estado do Pará. Para produzi-la, a argila é moldada, pintada e depois queimada, tornando-se resistente. Esse processo envolve diferentes transformações.
Consultar orientações no Livro do Professor
2. a) Reversível.
Moldar a argila
Peças de cerâmica feitas no estilo da cultura marajoara. Belém (PA), 2022.

compreende apenas mudar seu formato. Como ela permanece maleável, é possível desfazer o molde e recomeçar.
a) Moldar a massa feita de argila é uma transformação reversível ou irreversível? Explique sua resposta.
b) Queimar a peça de cerâmica é uma transformação reversível ou irreversível? Explique sua resposta.
Irreversível. A queima modifica a argila, tornando-a
dura e resistente. Depois de queimada, não é possível desfazer esse processo e fazer a argila voltar à forma original.
portão com a água e com o gás oxigênio do ar, evitando a formação de ferrugem.
4. Resposta pessoal. Espera-se que os estudantes confirmem ou revisem suas hipóteses e relacionem suas conclusões com a atividade. Se achar conveniente, organizar um momento da aula para que eles conversem sobre essas ideias e verificar a possibilidade de testá-las.
| ORIENTAÇÕES E RESPOSTAS
Atividades
1. Esta atividade oportuniza a mobilização da habilidade EF04CI03, ao requerer
Solicitar aos estudantes que considerem que, em vez de ser queimada, a argila foi seca ao sol. Questionar se, para eles, houve alguma alteração no tipo de transformação que ocorreu. De que maneira isso poderia influenciar a produção da cerâmica? Espera-se que eles identifiquem que houve alteração. Ao secar ao sol, a argila passa por uma transformação reversível, porque ela ainda pode ser desfeita. Por exemplo, ela pode ser novamente umedecida com água e moldada. Isso pode trazer consequências para a cerâmica, porque ela não ficará dura e resistente como quando é queimada. Sem a queima, a peça pode quebrar com facilidade e ter pouca durabilidade.
Se considerar pertinente, trazer para a sala de aula um pedaço de tijolo e um de argila seca ao sol. Propor que os estudantes comparem os dois materiais, observando suas características quanto à resistência e à dureza e o que ocorre quando são expostos à água. Esta atividade favorece a análise de transformações nos materiais com base em observações concretas.
02/10/25 15:56
que os estudantes analisem transformações ocasionadas pelo resfriamento ou aquecimento dos materiais e concluam se são reversíveis, como no caso da solidificação da água, ou irreversíveis, como a queima do papel.
2. Esta atividade também trabalha a habilidade EF04CI03, porém em outro contexto: a fabricação de peças de cerâmica. Há uma sugestão de ampliação desta atividade em +Atividades
NÃO ESCREVA NO LIVRO.
Forma com água e com gelo.
DIALOGANDO COM
ARTE E HISTÓRIA
Esta seção promove a integração entre os componentes curriculares de Ciências, Arte e História, ao abordar a pintura corporal como forma de expressão cultural adotada por diversos povos, com destaque para os povos indígenas brasileiros. A temática permite refletir sobre os significados sociais, simbólicos e identitários dessas práticas, favorecendo o desenvolvimento da competência geral 3. Também incentiva a valorização dos saberes tradicionais e o reconhecimento da diversidade cultural existente no Brasil, possibilitando o trabalho com o Tema Contemporâneo Transversal (TCT) Educação para valorização do multiculturalismo nas matrizes históricas e culturais brasileiras
Para conduzir o diálogo sobre pigmentos e corantes naturais, propor aos estudantes uma discussão sobre a origem desses elementos e sua aplicação em diferentes contextos, conectando ciência, arte e cultura.
Explicar que pigmentos e corantes naturais são substâncias extraídas de plantas, minerais ou até animais utilizadas há séculos por diversas culturas para colorir alimentos, tecidos, objetos e o próprio corpo. Além da aplicação na arte, os corantes naturais podem ser usados na culinária, na produção de alimentos e até no tingimento de tecidos.
Ao finalizar o trabalho com a temática, orientar
DIALOGANDO ARTE E HISTÓRIA COM
CORANTE NATURAL
Os seres humanos usam componentes da natureza para criar arte há muito tempo. Um deles é o jenipapo, fruto de uma árvore do Brasil. Esse fruto é usado para fazer tintas naturais, sobretudo por comunidades tradicionais brasileiras.
A pintura corporal é uma forma de expressão cultural utilizada por diferentes povos e culturas. Entre os povos indígenas do Brasil, as tintas da pintura corporal podem ser feitas com jenipapo e outros materiais, como o urucum. As pinturas têm diversos fins, como a preparação para caçadas, festas e rituais. Em algumas situações, também ajuda a afastar insetos.
A tinta feita com jenipapo é resultado de uma transformação que ocorre com o líquido extraído desse fruto. O líquido é incolor, mas, ao entrar em contato com o gás oxigênio do ar e com a pele, muda para a cor azul-escura. Depois de exposta ao ar, essa tinta não retorna ao estado original.


o acesso ao site indicado no boxe Para você explorar, que deve ser feito com o auxílio de um adulto. O incentivo ao uso de tecnologias digitais enriquece o aprendizado, contribuindo para o desenvolvimento da competência geral 5 e da competência específica 6 de Ciências da Natureza
Menina indígena do povo Iny Karajá sendo pintada com tintura de jenipapo. Ilha do Bananal (TO), 2025.
9 cm
Fruto do jenipapo.

MSPOLI/SHUTTERSTOCK.COM

Sementes de urucum dentro dos frutos.
indígenas do povo
na aldeia
em Barcelos (AM), 2019. Elas estão se pintando com tintura feita de urucum. A cor vermelha é obtida da semente do fruto do urucuzeiro.
1. Consultar orientações e resposta no Livro do Professor.
Para quais fins os indígenas usam a pintura corporal?
2. O que acontece com o líquido extraído do jenipapo quando entra em contato com o ar e a pele?
Ele se transforma de incolor para azul-escura.
3. Para obter a tinta do urucum, as sementes são esmagadas e misturadas com água. Isso é um exemplo de transformação irreversível. E a tinta feita com jenipapo? Ela passa por uma transformação reversível ou irreversível? Explique.
Irreversível. Depois de aplicada, ela muda de cor e não volta ao estado original.
4. Imagine que você vai participar de um evento artístico de pintura corporal. Desenhe no caderno um padrão de pintura que você apresentaria no evento.
Resposta pessoal. Os estudantes podem utilizar padrões diversos para a pintura, que façam sentido para eles e para o evento que imaginaram.
5. Cada povo indígena tem costumes e tradições próprias. Alguns podem ser parecidos, mas cada um tem sua maneira única de viver. Com a ajuda de um adulto da família, pesquise algum povo indígena e organize os resultados em uma apresentação oral para a turma.
Consultar orientações e resposta no Livro do Professor
PARA VOCÊ EXPLORAR
• COSTA, Tereza. Faça a sua tinta invisível. InVivo, [s. l.], 29 jul. 2024. Disponível em: https://www.invivo.fiocruz.br/experimente/faca-a-sua-tinta-invisivel/. Acesso em: 20 maio 2025.
Com a supervisão de um adulto, leia o texto e aprenda a fazer um corante de cúrcuma para revelar palavras escritas no papel que antes pareciam invisíveis.
| ORIENTAÇÕES E RESPOSTAS
1. Os indígenas usam essa expressão cultural em rituais, festas, caçadas, mas também para afastar insetos.
5. Resposta pessoal. Orientar os estudantes a pesquisar diferentes aspectos do povo indígena escolhido, como o local onde vive, a língua falada, hábitos de vida (por exemplo, principais alimentos consumidos) e elementos de sua cultura (como festividades e tradições). Como fonte de pesquisa, recomendar que acessem o site Povos Indígenas no Brasil (disponível em:
desenvolvimento da habilidade de História EF04HI05. Se considerar pertinente, as informações pesquisadas podem ser apresentadas em um seminário.
TEXTO
DE APOIO
[...]
As pinturas são usadas por quase todos os grupos sociais, sendo manifestações culturais que podem apresentar diversos significados, a depender da cultura e de quem a utiliza. Além disso, foram uma das primeiras formas de comunicação entre os seres humanos. Antes mesmo do surgimento da escrita, já era comum aos homens e mulheres pintarem o corpo e a parede das cavernas, a partir de outros elementos naturais que apresentavam colorações marcantes, as quais conseguiam ser transpostas nas rochas, árvores e peles.
02/10/25 15:56
https://pib.socioambiental.org/pt/P% C3%A1gina_principal; acesso em: 22 ago. 2025), com o auxílio de um adulto da família responsável. Esse site traz diversas informações sobre os povos indígenas brasileiros.
Esta atividade contribui para desconstruir a ideia presente no senso comum de que os povos indígenas brasileiros são todos iguais. Uma semelhança que os une é a forma como interagem com o ambiente, retirando dele apenas aquilo de que precisam para sobreviver. Além disso, a atividade pode contribuir para o
Assim, a prática e a tradição de pintar os corpos a partir da extração, ou seja, da retirada de pigmentos naturais (substâncias que contêm cores) existem há muito tempo, desempenhadas por diversos povos, como os indígenas, os africanos, entre outros. Essas pinturas são realizadas a partir da extração de pigmentos de bases naturais como é o caso do urucum e do jenipapo, que são frutos. Além disso, essa arte difere entre os povos e suas culturas, como também se altera a matéria-prima utilizada.
[...]
JESUS, Yasmin Lima de et al. Descobrindo as ciências na cultura indígena: pinturas corporais. Revista Curiá: múltiplos saberes, v. 1, n. 1, 2015. Disponível em: https:// periodicos.ufs.br/CURIA/article/ view/3627/3098. Acesso em: 18 ago. 2025.
NÃO ESCREVA NO LIVRO.
Crianças
Yanomami,
Watoriki,
ENCAMINHAMENTO
Para iniciar a abordagem do conteúdo deste capítulo, é possível fazer alguns questionamentos iniciais para verificar os conhecimentos prévios dos estudantes sobre misturas e separação de misturas, promovendo a participação ativa e o vínculo com situações do cotidiano.
• Vocês sabem o que é uma mistura?
• Quais misturas vocês já observaram em casa ou na escola?
• Quando fazemos suco de maracujá no liquidificador, o que acontece com as sementes? Como podemos separá-las da porção líquida do suco?
• Como se prepara café coado? Que tipo de material usamos para separar o pó do líquido?
Se considerar pertinente, orientar os estudantes a registrar as respostas no caderno, para que possam ser retomadas posteriormente e para que eles possam refletir sobre os avanços em sua aprendizagem.
Caso seja possível fazer uma visita a uma feira livre com a turma, garantir todos os cuidados necessários: planejamento, autorizações, segurança, logística, vestimentas apropriadas e supervisão da equipe escolar.
ATIVIDADES FAMÍLIA
Sugerir aos estudantes que realizem uma visita a uma feira livre próxima do bairro onde residem, acompanhados por um adulto da família. O objetivo é aproximá-los da realidade da agricultura familiar, fazê-los compreender o percurso dos alimentos até o consumidor e identificar misturas presentes no cotidiano da feira. Antes da atividade,
1. Resposta pessoal. Verificar a possibilidade de visitar, com a turma, uma feira livre, que aconteça próximo à escola. Aproveitar a oportunidade para explorar a diversidade de alimentos e conversar com os feirantes sobre a produção, a comercialização e outros fatores.
MISTURAS
2. Resposta pessoal. Espera-se que os estudantes remetam ao processo de catação ou peneiração. Contudo, nesse momento, não se espera que utilizem esses termos. Esse questionamento pode ser retomado após o estudo da separação de misturas.
Observe a fotografia e leia o texto com atenção.

A feira livre é um tipo de comércio comum em várias cidades do Brasil. Nela, alimentos frescos, como frutas, verduras e grãos, são expostos para venda em bancas montadas ao ar livre. Muitos desses produtos vêm direto do produtor rural e passam por pouco ou nenhum processamento antes de chegar até os consumidores. Grãos, como feijão e arroz, são expostos em grandes sacos e vendidos na quantidade escolhida. Por serem pouco processados, podem conter impurezas como folhas e pequenas rochas. Por isso, antes de cozinhar, é comum que as pessoas precisem “escolher os grãos”, ou seja, separar o que é útil do que não será aproveitado.
1. Existe feira livre na região onde você mora? Você já visitou alguma? Converse com um colega sobre o assunto.
2. Imaginem que vocês precisem “escolher” grãos de feijão depois de comprá-los na feira. Como fariam isso? Será que existe só uma maneira de separar as impurezas?
3. Os grãos de feijão com as impurezas formam um mistura. Citem mais dois exemplos de misturas que vocês conhecem.
Resposta pessoal. Nesse momento, é possível que os estudantes busquem exemplos de misturas cujos componentes sejam individualmente observáveis. Aproveite para questionar sobre misturas em que esses componentes não são observáveis, como um suco de limão, que contém sumo de limão, água e açúcar, por exemplo.
é importante conversar com a turma sobre a importância da agricultura familiar para a economia local e para a promoção de uma alimentação saudável. Não se esquecer de passar todas as orientações para a família, incluindo os objetivos da atividade e os procedimentos de segurança a serem adotados no momento da visita.
Durante a visita, os estudantes poderão observar a diversidade de produtos, entrevistar feirantes e registrar as informações no caderno. Também devem ser incentivados a identificar exemplos de
misturas, como temperos prontos, ou a realizar algum procedimento para a separação de misturas durante o preparo do alimento adquirido na feira.
A proposta reforça a importância de escolhas alimentares saudáveis, baseadas em alimentos frescos e naturais, ao mesmo tempo que estimula a curiosidade e a participação da família no processo de aprendizagem. Além disso, propicia a integração com Língua Portuguesa, ao propor o trabalho com o gênero textual entrevista.
Grãos sendo vendidos em feira livre em Itaituba (PA), 2017.
O QUE SÃO MISTURAS?
A maioria dos materiais do cotidiano são misturas. Isso significa dizer que eles são formados por dois ou mais componentes diferentes. Em algumas dessas misturas, é possível observar seus componentes separadamente. A areia, por exemplo, é formada por grãos de diferentes tama nhos, cores e materiais, como pequenos fragmentos de rochas e minerais.
Porção de areia. Ao observar a areia de perto, é possível perceber a mistura de materiais nela.



ATIVIDADES
A culinária quilombola é um patrimônio cultural brasileiro, rica em saberes, sabores e tradições transmitidos de geração em geração. Como atividade extra, sugere-se preparar, com a turma, uma das receitas do livro Receitas quilombolas, do Governo do Estado do Espírito Santo. Guaçuí: Secretaria de Cultura, [20--] (disponível em: https://guacui.es.gov. br/arquivos/files/2021/11/ arquivo/receitas_comu nidade_quilombola_ 61950732f02b4.pdf; acesso em: 18 ago. 2025).
Em outras misturas, não é possível observar os componentes separadamente. A água mineral, por exemplo, parece feita de um único componente. Contudo, ela é uma mistura de água e diversos sais dissolvidos.
Representação de uma garrafa de água mineral e, no detalhe, informações sobre sua composição.
ENCAMINHAMENTO

O tópico O que são misturas? fornece subsídios teóricos para o desenvolvimento da habilidade EF04CI01. Promover uma conversa com a turma sobre misturas que os estudantes observam em casa, na escola ou na natureza. Alguns exemplos: areia da praia, massa de bolo, papel (formado por diversas fibras) e granito (formado por diferentes minerais, de cores e brilhos distintos).
As misturas homogêneas são constituídas por componentes que estão completamente dissolvidos ou distribuídos de
forma uniforme, de modo que não são distinguíveis a olho nu nem com instrumentos ópticos simples. Um exemplo é a mistura de água com um pouco de sal. As misturas heterogêneas apresentam componentes que podem ser identificados visualmente, como a areia e o granito. Ressaltar que, em alguns casos, a mistura pode parecer ser homogênea, mas os componentes podem ser identificados com o uso do microscópio, como acontece com o leite. Também é possível diferenciá-los por outros métodos de separação, como a centrifugação, que será abordada adiante neste Livro do Professor.
02/10/25 15:56
Durante o preparo, os estudantes podem identificar os ingredientes utilizados e observar como, ao serem combinados, eles formam misturas. A proposta permite articular conhecimentos científicos com saberes tradicionais, valorizando a diversidade cultural brasileira.
É importante alertar os estudantes sobre os cuidados com o uso de materiais cortantes durante o preparo dos ingredientes e a utilização do forno, explicando que essas etapas devem ser realizadas apenas pelo professor. Ademais, reforçar os procedimentos de higiene corporal, bem como o uso de toucas e luvas. Ao final, partilhar a receita finalizada com a turma, reforçando a ideia de que muitas misturas fazem parte de nossa vida, especialmente na alimentação. É fundamental verificar se algum estudante apresenta alergia ou intolerância a algum dos ingredientes da receita.
IMAGENS FORA DE PROPORÇÃO
AS CORES NÃO SÃO REAIS
ENCAMINHAMENTO
No tópico Mistura de metais, mencionar que, à temperatura ambiente (em torno dos 20 °C), a maioria dos metais se encontra no estado sólido. Por isso, para que possam ser misturados, é necessário aquecê-los até que se fundam. Ao serem derretidos, os metais podem ser combinados, formando uma liga metálica, que pode ter novas propriedades, como maior resistência, durabilidade ou leveza.
Um exemplo comum é o aço, uma liga metálica formada principalmente por ferro e carbono, amplamente utilizado na construção civil e na fabricação de ferramentas. Outro exemplo é o bronze, uma mistura de cobre e estanho, usado desde a Antiguidade na confecção de esculturas, moedas e utensílios. Já o latão, formado por cobre e zinco, é utilizado na produção de instrumentos musicais e peças decorativas.
Se considerar oportuno, essa temática pode ser explorada de forma interdisciplinar com o componente curricular de História, abordando o desenvolvimento da metalurgia. Por volta de 5000 a.C., os seres humanos começaram a trabalhar com metais. Esse avanço marcou uma importante transformação nos grupos humanos da época, permitindo a produção de ferramentas, armas e utensílios agrícolas (como pás e enxadas) mais duráveis e eficientes.
VOCÊ ESCRITOR!
Ao abordar as próteses, é importante manter um ambiente acolhedor e respeitoso. Essa conversa deve ser planejada para garantir que todos os estudantes se sintam à vontade para participar das
MISTURA DE METAIS
Os metais também podem formar misturas. Quando dois ou mais metais são combinados, formam o que chamamos de liga metálica Essas misturas dão origem a materiais com novas características, como maior resistência ou leveza.
Um exemplo é o aço , que é uma liga metálica feita principalmente de ferro. Ele é mais resistente do que o ferro puro e está presente em muitos objetos do dia a dia, como panelas, talheres, ferramentas e até na construção de prédios.

O latão é outra liga metálica, feita principalmente de cobre. Ele é utilizado em instrumentos musicais, como o trompete e o saxofone, além de torneiras, maçanetas e puxadores de portas. É uma mistura que tem brilho e não enferruja com facilidade.
Prótese é uma estrutura artificial usada para substituir ou complementar alguma região do corpo. Ela ajuda uma pessoa, por exemplo, a se movimentar e a realizar tarefas do dia a dia sem precisar do auxílio de outras pessoas. As próteses, geralmente, são produzidas de diferentes materiais, como plásticos resistentes e ligas metálicas leves.
Consultar orientações e resposta no Livro do Professor. 100
• Com a ajuda de um adulto da família, faça uma pesquisa sobre próteses desenvolvidas com novos materiais que as tornem mais leves, resistentes e confortáveis. Com base nas informações encontradas, escreva um texto no caderno explicando essa inovação e destacando por que ela é importante para melhorar a qualidade de vida das pessoas.
com prótese na perna jogando basquete.
discussões, valorizando a empatia e o respeito às diferenças.
A temática da seção contribui para o desenvolvimento dos Temas Contemporâneos Transversais (TCTs) Ciência e tecnologia, ao evidenciar como a ciência e a tecnologia melhoram a qualidade de vida, e Educação em Direitos Humanos, ao reforçar a importância da inclusão e mostrar como avanços tecnológicos podem garantir mais autonomia para pessoas com deficiência física.
| ORIENTAÇÕES E RESPOSTA

Resposta pessoal. Sugestão de texto após o resumo da pesquisa: A ciência é importante para melhorar a vida das pessoas, incluindo aquelas que precisam usar próteses. Ao criar materiais e misturas, os cientistas ajudam a deixar a prótese mais funcional no dia a dia. Quando ela é leve, a pessoa se cansa menos. Quando é resistente, dura mais tempo. E, sendo confortável,
Criança em brinquedo de aço no parquinho.
Criança
ÁGUA COMO SOLVENTE
Quando um componente de uma mistura se dissolve em outro, falamos que ele é solúvel. O sal, por exemplo, é solúvel em água, porque se mistura a ela e parece desaparecer, mas está dissolvido nela. Já quando um componente não se dissolve, ele é chamado de insolúvel. O óleo, por exemplo, é insolúvel em água, pois ele fica separado, mesmo que a mistura seja mexida.


Muitas das misturas que usamos no dia a dia são feitas com água. Isso acontece porque a água é capaz de dissolver várias substâncias.
ATIVIDADES
1. Analise os exemplos de misturas a seguir.
ESCREVA NO LIVRO.
IMAGENS FORA DE PROPORÇÃO AS CORES NÃO SÃO


água + sal + areia água + serragem água + açúcar água + vingre
• Quais dessas substâncias se dissolveram em água? Quais não se dissolveram?
Representação do resultado de diferentes misturas. Substâncias que se dissolveram em água: sal, açúcar e vinagre. Substâncias que não se dissolveram: areia e serragem. Consultar orientações no Livro do Professor
2. Pense em misturas com água que fazem parte de seu cotidiano. Na maioria delas, os materiais se dissolvem ou não na água? Descreva um exemplo de cada.
Consultar orientações e resposta no Livro do Professor.
não machuca o corpo, podendo ser usada com mais frequência. Essas invenções mostram como a ciência e a tecnologia podem ajudar as pessoas a viver melhor.
A elaboração de um texto sobre o tema colabora para o desenvolvimento da competência geral 4 e da competência específica 6 de Ciências da Natureza.
ENCAMINHAMENTO
No tópico Água como solvente, explicar que, em uma mistura, o componente que dissolve outro é chamado de solvente,
enquanto o que é dissolvido é o soluto. No caso da água, ela frequentemente atua como solvente de uma grande variedade de substâncias, sendo essencial em diversos processos naturais e industriais. É importante ressaltar que o sal não desparece na água; ele se dissolve, formando uma solução homogênea. Destacar que nem todas as substâncias são solúveis em água, mas podem se dissolver em outros solventes. Por exemplo, o óleo não é solúvel em água, mas pode se dissolver em álcool puro ou acetona.
1. Comentar com os estudantes que o vinagre utilizado na mistura D é incolor.
2. Resposta pessoal. Espera-se que os estudantes reconheçam que, na maioria das misturas com água do cotidiano, os materiais se dissolvem nela. Exemplos: água com sal ou água com açúcar, que apresentam aspecto uniforme, pois tanto o sal quanto o açúcar se dissolvem em água. Já a mistura de água com óleo (no cozimento do macarrão, por exemplo) não apresenta aspecto uniforme, sendo possível identificar os componentes separadamente, já que o óleo não se dissolve em água. Esta atividade oportuniza a mobilização da habilidade EF04CI01.
ATIVIDADES FAMÍLIA
02/10/25 15:56
Orientar os estudantes a identificar uma mistura presente no cotidiano deles que envolva a água como solvente. Sugerir que pensem em situações habituais realizadas com familiares ou responsáveis, como preparar um suco ou ferver água para fazer macarrão. Solicitar que registrem esse momento com fotografias e peçam aos responsáveis que compartilhem as imagens com o professor, por meio das redes sociais da turma. Esta atividade pode ser utilizada como parte do processo de avaliação da aprendizagem.
Mistura de água e óleo.
Mistura de água e sal.
REAIS
NÃO
Orientar a leitura da imagem da página, verificando se os estudantes relacionam o conteúdo com situações do cotidiano, mostrando como os conhecimentos científicos estão presentes em contextos reais e relevantes para a vida em sociedade.
A separação de misturas é um conjunto de processos utilizados para separar os componentes de uma mistura, com base em propriedades físicas como o tamanho das partículas, a densidade, a solubilidade e o estado físico.
No dia a dia, encontramos diversas situações em que é necessário separar substâncias. Na cozinha, na agricultura e até na indústria farmacêutica, as técnicas de separação são amplamente utilizadas para garantir a qualidade, o aproveitamento e a segurança dos produtos.
Se considerar pertinente, é possível apresentar outros exemplos de métodos de separação de misturas. Um deles é a centrifugação, técnica utilizada em exames laboratoriais para separar os componentes do sangue, como o plasma e as células.
SEPARAÇÃO DE MISTURAS
Algumas misturas podem ser separadas. O modo de fazer isso depende das características da mistura e dos materiais que a compõem. Acompanhe a seguir alguns exemplos de métodos usados para separar misturas.
IMAGENS FORA AS CORES NÃO
Representação de processos comuns em uma




as sementes de uma fatia de melancia, por exemplo.
2. Peneiração: separa misturas formadas por um líquido e um sólido, ou por dois sólidos com tamanhos diferentes. Por exemplo, ao coar suco de maracujá, as sementes ficam na peneira e só o líquido passa. Esse método também pode ser usado para separar gravetos misturados à areia, por exemplo.
3. Filtração: separa misturas de líquidos e sólidos, se pelo menos uma parte do sólido não for solúvel no líquido. Ao passar o café pelo filtro, por exemplo, o líquido com uma parte do café dissolvido em água o atravessará. O pó de café que não foi dissolvido na água ficará retido no filtro.

Amostra de sangue após o processo de centrifugação. Na imagem, é possível observar o plasma na parte superior do tubo e as células na parte inferior.
Decantação: separa misturas com um componente líquido e componentes sólidos que são insolúveis. Ao deixar uma mistura de água e solo em repouso, por exemplo, as partículas de solo vão se depositar no fundo do recipiente. Ao ser retirada com cuidado, a água pode ser passada para outro recipiente, sendo separada das partes sólidas.
IMAGENS FORA DE PROPORÇÃO.
AS CORES NÃO SÃO REAIS.

de processo de separação da água e do solo por decantação.
Evaporação: separa misturas de líquidos e sólidos, em que um líquido se transforma em vapor (vaporização) lentamente e se dispersa no ar. Por exemplo, para fazer papel reciclado, pedaços de papel usados são rasgados (1), misturados
Evaporação: separa misturas de líquidos e sólidos, que um líquido se transforma em vapor (vaporização) lentamente e se dispersa no ar. Por exemplo, para fazer papel reciclado, pedaços de papel usados são rasgados (1), misturados

Representação da produção de uma folha de papel reciclado. Na etapa final, a evaporação seca o papel.
Folha de papel reciclado.

ENS FORA DE PROPORÇÃO
ORES NÃO SÃO REAIS.
A abordagem da decantação pode ser acompanhada por uma demonstração em sala de aula da situação representada no Livro do Estudante. Para isso, utilizar um recipiente transparente, como um copo ou pote, e misturar uma porção de solo com água. Mexer bem a mistura e deixar em repouso sobre uma superfície plana, para que os componentes comecem a se separar naturalmente. Outra possibilidade de demonstrar a decantação é apresentada na seção +Atividades. Orientar os estudantes a registrar as etapas da experiência no caderno e reforçar que esse processo também ocorre na natureza (como em um rio, após um período chuvoso) e no tratamento de água.
| PARA O ESTUDANTE
VÍDEO. MÉTODOS de separação de misturas (que a gente faz em casa). 2022. 1 vídeo (2 min 28 s). Publicado pelo canal Experimentando Ciências. Disponível em: https://www. youtube.com/watch?v=U RinpeG-4Vc. Acesso em: 18 ago. 2025.
Vídeo sobre situações cotidianas que envolvem métodos de separação de misturas.
ATIVIDADES
Para separar uma mistura de água e óleo, utilizar uma garrafa PET cortada ao meio. Na parte superior, mantida com a tampa, coloca-se a mistura, enquanto a parte inferior serve de reservatório. Antes de abrir a tampa, os estudantes devem observar a separação natural entre os líquidos. Em seguida, a tampa é aberta lentamente para que a água escorra para o recipiente de baixo. Quando a maior parte da água já tiver sido coletada, a tampa é fechada, restando o óleo na parte superior.


Experimento de separação de mistura de água e óleo com o auxílio de uma garrafa PET.
Representação
|
1. Se considerar pertinente, trazer para a sala de aula uma bacia com a mistura proposta (folhas secas + pequenas rochas + areia + água) e possibilitar que os estudantes planejem estratégias para separar esses componentes de forma prática.
3. a) O maracujá e o granito são exemplos de misturas cujos componentes podem ser identificados visualmente. Ao observar o maracujá, é possível identificar a polpa, as sementes e a casca, que são partes distintas da fruta. Já ao observar o granito, é possível identificar grãos de minerais diferentes.
Isso não ocorre ao observar a colher de aço e o café com leite, pois não é possível identificar os componentes que formam o aço (ferro e outros) nem distinguir o leite do café.
b) Resposta pessoal. Orientar os estudantes a escolher objetos que utilizam frequentemente nas atividades cotidianas. É importante lembrá-los de que, em alguns casos, os componentes das misturas podem não ser observados visualmente, mas ainda assim fazem parte da composição do objeto. Esta atividade oportuniza a mobilização da habilidade EF04CI01.
VOCÊ CIDADÃO!
Esta seção aborda o Tema Contemporâneo Transversal (TCT) Saúde, ao destacar a importância do consumo de água tratada e filtrada (ou, ao menos, fervida) para a manutenção da saúde.
A seção destaca o funcionamento do filtro de barro, presente em muitas casas brasileiras. Uma
1. Na mistura, as folhas secas provavelmente boiariam na água devido à sua menor densidade. Dessa maneira, podem ser retiradas manualmente, uma a uma (catação).
ATIVIDADES
1. Em grupos, analisem a seguinte mistura:
Consultar orientações no Livro do Professor.
Verificar se os desenhos retratam os processos indicados pelos estudantes. Após a retirada das folhas, a mistura de rochas, areia e água pode ser passada por uma peneira: as rochas ficam retidas, e a areia e a água passam pelos furos (peneiração). Por último, é possível realizar a decantação, a filtração ou a evaporação da água.
folhas secas + pequenas rochas + areia + água
Agora, pensem em como separar cada componente da mistura, um de cada vez, seguindo esta ordem:
• separar as folhas secas;
• separar as pequenas rochas;
• obter areia ao final.
Para cada etapa, utilizem um método de separação diferente, sem repetir. No caderno, façam um desenho que represente como vocês imaginam o processo de separação em cada etapa.
2. Crie, no caderno, uma história em quadrinhos sobre uma situação que você já viveu em que foi necessário separar uma mistura. Nessa história, destaque qual foi o método de separação utilizado.
3. Observe as imagens a seguir.
IMAGENS FORA DE PROPORÇÃO
Maracujá.



2. Reposta pessoal. Estabelecer parâmetros para esta atividade, como a quantidade de quadrinhos, o uso de textos curtos e a inclusão de elementos de humor.
Consultar orientações e respostas no Livro do Professor.

a) As imagens mostram exemplos de misturas. Quais dessas misturas podem ter seus componentes identificados visualmente? Justifique sua resposta.
b) Observe três objetos diferentes de sua casa que são feitos de misturas. Com a ajuda de um adulto da família, identifique se os componentes dessas misturas podem ser reconhecidos visualmente. Registre suas descobertas no caderno e as compartilhe com a turma.
das características do filtro é a presença de carvão ativado na vela filtrante. Esse material é constituído principalmente por carbono, além de apresentar alta porosidade e grande área de superfície. Essas características auxiliam na purificação de gases e líquidos por meio da adsorção, um processo em que moléculas, incluindo metais pesados, ficam retidas em seus poros superficiais.
O acesso à saúde é um direito social, garantido pela Constituição Federal de 1988. Nesse contexto, é essencial refletir
sobre os cuidados necessários para garantir a qualidade da água que abastece a população, assegurando que esteja livre de contaminantes. O uso do filtro de barro, por exemplo, representa uma alternativa eficiente, acessível e tradicionalmente valorizada por sua capacidade de reter impurezas. Assim como outros métodos de purificação, seu uso contribui para a promoção da saúde individual e coletiva.
NÃO ESCREVA NO LIVRO.
Leite com café. Pedaço de granito.
Filtro de barro
VOCÊ
CIDADÃO!
IMAGENS FORA DE PROPORÇÃO
AS CORES NÃO SÃO REAIS.
Representação de um filtro de barro, visto em corte, mostrando seu interior.
O filtro de barro é usado há muitos anos para deixar a água mais limpa e segura para beber. Ele é usado com muita frequência no Brasil e foi considerado o mais eficiente do mundo por cientistas. Descubra como ele funciona.
O filtro é feito de barro e tem em seu interior uma peça chamada vela, feita de cerâmica, que faz a filtragem da água. A água é colocada na parte de cima do filtro.
A água passa lentamente pela vela filtrante, que tem poros, ou seja, furos bem pequenos, capazes de reter impurezas e alguns microrganismos. Em geral, a vela filtrante também tem a propriedade de tirar o gosto e o cheiro ruim da água.
No final, a água que sai na parte de baixo está potável, ou seja, pronta para o consumo.
Consultar orientações e respostas no Livro do Professor
1. Como funciona o filtro de barro?
2. Qual é o método de separação de misturas utilizado nesse equipamento?
3. Em sua casa, qual é o tipo de procedimento utilizado para tornar a água segura para o consumo?
4. O filtro de barro garante o acesso à água adequada para o consumo em regiões onde não existe tratamento de água eficaz. Você concorda com essa frase? Explique.

| ORIENTAÇÕES E RESPOSTAS
1. A água é colocada no reservatório superior do filtro e passa devagar pela vela filtrante, que retém impurezas e microrganismos. O carvão ativado presente no interior da vela ajuda a tirar o gosto e o cheiro da água. Por fim, a água sai potável, pronta para o consumo.
2. Filtração.
3. Resposta pessoal. Os estudantes podem responder que realizam a filtração da água utilizando diferentes tipos de
potável e protegendo a saúde das pessoas. Conduza a atividade de modo que os estudantes comparem a situação descrita no enunciado com a própria realidade, discutida na atividade anterior.
Se considerar oportuno, explicar aos estudantes que existem filtros que dependem de energia elétrica para funcionar, seja diretamente, no caso de filtros elétricos, seja indiretamente, quando bombas são utilizadas para empurrar a água tratada até regiões afastadas. Em contrapartida, o filtro de barro é um modelo que não depende da energia elétrica, podendo ser utilizado em locais onde não há acesso à rede elétrica.
A elaboração de argumentos para a defesa de pontos de vista embasados em conhecimentos científicos e em princípios sociais e éticos colabora para o desenvolvimento da competência geral 7 e da competência específica 5 de Ciências da Natureza.
02/10/25 15:56
filtro, incluindo o de barro. Também é possível que mencionem fervura ou adição de cloro. Conversar com a turma sobre a importância de obter água potável para o consumo.
4. Resposta pessoal. Espera-se que os estudantes concordem com a frase. Um dos argumentos que podem ser utilizados é o fato de que o filtro de barro ajuda a deixar a água limpa e segura para beber, eliminando impurezas. Por isso, é útil em lugares onde não há fornecimento de água tratada, garantindo o acesso à água
NÃO ESCREVA NO LIVRO.
Filtro de barro.
VOCÊ ESCRITOR!
Organizar os estudantes em um grande círculo e iniciar o trabalho com a seção promovendo uma breve contextualização. Para isso, pode-se perguntar:
• Vocês sabem o que a gasolina, o asfalto e o gás de cozinha (botijão) têm em comum?
Incentivar os estudantes a compartilhar seus conhecimentos sobre o tema. Conduzir a conversa de forma a levá-los a refletir sobre a matéria-prima desses produtos. É provável que eles se recordem de que a gasolina é feita do petróleo, como estudado anteriormente nesta unidade. A partir disso, apresentar a informação de que, a partir do petróleo, são obtidos diversos derivados usados no cotidiano. Essa mediação contribui para a construção de sentido e aproxima o conteúdo científico da vivência dos estudantes, tornando a aprendizagem mais significativa.
Na sequência, realizar a leitura do esquema presente na seção. Após a leitura, propor uma reflexão sobre a importância do uso consciente dos recursos naturais. É importante explicar que o petróleo é um recurso natural não renovável e que, por isso, é essencial buscar alternativas sustentáveis e pensar em formas de consumo mais responsáveis. Essa reflexão possibilita o trabalho com os Temas Contemporâneos Transversais (TCTs) Educação ambiental e Educação para o consumo.
VOCÊ ESCRITOR!
O petróleo é uma mistura da qual são retirados vários produtos usados em nosso dia a dia. Eles são obtidos por meio do aquecimento do petróleo. À medida que aumenta a temperatura, um novo produto é separado da mistura. Daí esse processo ser chamado fracionamento do petróleo.
Além da gasolina e do óleo diesel, veja a seguir outros exemplos de produtos que podem ser retirados do petróleo.
Piche: usado na fabricação do asfalto e de alguns tipos de borracha industrial.
IMAGENS FORA DE PROPORÇÃO
AS CORES NÃO
SÃO REAIS

Asfalto: material escuro usado para cobrir o chão de ruas e calçadas.
Nafta: usada na fabricação de muitos produtos plásticos utilizados no dia a dia.

Gás liquefeito de petróleo: usado no fogão e em aquecedores de ambiente; também conhecido como gás de cozinha.
Parafina: usada para fazer velas. Também está presente na produção de borrachas, cosméticos e tintas.


Representação de exemplos de uso de alguns derivados de petróleo.
Consultar orientações e respostas no Livro do Professor.
NÃO ESCREVA NO LIVRO.
1. Cite ao menos dois usos em seu cotidiano de derivados do petróleo.
2. Por que é importante reduzir o uso de produtos feitos do petróleo, como o plástico? Com a ajuda de um adulto da família, faça uma pesquisa para responder a essa pergunta. Depois, no caderno, crie um texto e o leia para a turma. O objetivo é mostrar como o uso excessivo de produtos derivados do petróleo pode causar problemas para o ambiente e para a saúde humana
| ORIENTAÇÕES E RESPOSTAS
1. Resposta pessoal. Os estudantes provavelmente vão citar a nafta (produtos plásticos). Podem citar, ainda, algum dos combustíveis, o piche (presente em ruas), a vela etc.
2. Espera-se que os estudantes encontrem informações relacionadas aos impactos ambientais que podem ser causados durante a extração, o transporte, o uso e o descarte desses produtos. Oriente a produção do texto e das imagens. Elas podem ser feitas em uma folha e
posteriormente digitalizadas, para serem usadas como postagem na rede social da escola, ou podem ser produzidas digitalmente. Nesse caso, a aula pode ser realizada no laboratório de informática da escola. Se achar pertinente, organizar os grupos por tipo de material: plástico, gasolina, diesel etc. Esta atividade permite desenvolver as habilidades de Língua Portuguesa indicadas a seguir.
• EF15LP05: Planejar, com a ajuda do professor, o texto que será produzido, considerando a situação comunicativa,
ORGANIZANDO IDEIAS
ORGANIZANDO IDEIAS
Nesta unidade, estudamos os materiais e suas transformações. Analise o esquema a seguir para relembrar esses assuntos.
MATERIAIS
SÓLIDO
LÍQUIDO
GASOSO
REVERSÍVEIS
formam são encontrados nos estados por exemplo
MUDANÇAS DE ESTADO FÍSICO DA MATÉRIA
que podem ser
passam por
TRANSFORMAÇÕES
IRREVERSÍVEIS
por exemplo
COZIMENTO DOS ALIMENTOS

FERRUGEM
DECOMPOSIÇÃO COMBUSTÃO
os interlocutores (quem escreve/para quem escreve); a finalidade ou o propósito (escrever para quê); a circulação (onde o texto vai circular); o suporte (qual é o portador do texto); a linguagem, organização e forma do texto e seu tema, pesquisando em meios impressos ou digitais, sempre que for preciso, informações necessárias à produção do texto, organizando em tópicos os dados e as fontes pesquisadas.
• EF15LP06: Reler e revisar o texto produzido com a ajuda do professor e a
TEXTO. PRAUCHNER, Marcos J. et al. Combustíveis derivados do petróleo: obtenção, propriedades e uso. Revista Virtual de Química, v. 15, n. 1, p. 4360, 2022. Disponível em: https://rvq.sbq.org.br/pdf/ v15n1a05. Acesso em: 23 ago. 2025.
MISTURAS
que podem ser separadas por
CATAÇÃO FILTRAÇÃO
PENEIRAÇÃO
DECANTAÇÃO
EVAPORAÇÃO
Os derivados do petróleo são obtidos por meio da destilação fracionada, um processo de separação de misturas que permite isolar diferentes componentes de acordo com seus pontos de ebulição. O artigo apresenta mais detalhes sobre esse procedimento.
ORGANIZANDO IDEIAS
02/10/25 15:56
colaboração dos colegas, para corrigi-lo e aprimorá-lo, fazendo cortes, acréscimos, reformulações, correções de ortografia e pontuação.
• EF15LP07: Editar a versão final do texto, em colaboração com os colegas e com a ajuda do professor, ilustrando, quando for o caso, em suporte adequado, manual ou digital.
A seção possibilita retomar e consolidar os conteúdos estudados na unidade, a partir da análise do esquema apresentado. Iniciar o trabalho com a seção resgatando com os estudantes os principais conteúdos abordados, como os estados físicos da matéria, as mudanças de estado físico, transformações reversíveis e irreversíveis, misturas e métodos de separação de misturas. Orientar a análise das relações no esquema. Na sequência, propor aos estudantes que façam o próprio esquema no caderno. Esta atividade favorece a compreensão integrada dos conteúdos, o desenvolvimento da capacidade de síntese, a organização lógica das informações e o pensamento crítico. Além disso, oportuniza ao professor a avaliação do aprendizado da turma.
RETOMANDO
Esta seção tem como propósito a retomada dos conteúdos estudados na unidade. Também propicia ao docente a avalição do aprendizado dos estudantes.
A avaliação da aprendizagem é uma etapa importante, pois possibilita acompanhar o desenvolvimento da turma, ajudando a reconhecer progressos e a identificar eventuais desafios de aprendizagem. Com base nisso, fazer os devidos ajustes no planejamento e nas estratégias pedagógicas, de modo a atender melhor às necessidades dos estudantes.
Listas de atividades são apenas um dos instrumentos avaliativos que podem ser utilizados nesse processo. Ao longo deste Livro do Professor, outras sugestões foram apresentadas em diferentes momentos das orientações específicas. Outros instrumentos também podem ser consultados na página XXIX da Parte Geral deste Livro do Professor
Garantir que os estudantes tenham tempo suficiente para realizar as tarefas de forma individual, favorecendo a concentração e a autonomia no processo. Na sequência, organizar uma roda de conversa para que os estudantes possam partilhar seus pontos de vista, promovendo o diálogo, a escuta ativa e a construção coletiva do conhecimento.
RETOMANDO
1. Resposta pessoal. Os estudantes podem utilizar os exemplos apresentados no livro como referência para os desenhos. É necessário ajudá-los a encontrar esses desenhos.
1 No caderno, faça três desenhos que mostrem exemplos de situações que envolvam uma mudança de estado físico de um material.
2. b) Incorreta. Se deixarmos gelo sobre uma mesa por uma hora, ele vai passar pelo processo de fusão e virar água no estado líquido.
2 Copie as afirmações no caderno, corrigindo as que estiverem incorretas.
a) O gelo é a água no estado sólido. Correta.
Consultar orientações no Livro do Professor.
b) Se deixarmos gelo sobre uma mesa por uma hora, ele vai passar pelo processo de condensação e virar água no estado líquido.
c) As roupas secam no varal porque, com o tempo, a água presente nelas vaporiza, passando do estado líquido para o gasoso. Correta.
d) As mudanças de estado físico da água são consideradas irreversíveis.
2. d) Incorreta. As mudanças de estado físico da água são consideradas mudanças reversíveis.
3 Classifique, no caderno, as transformações a seguir em reversíveis ou irreversíveis.
Consultar orientações no Livro do Professor
ROMANSIGAEV/SHUTTERSTOCK

Água fervendo.

Irreversível. Reversível.

Reversível.
derretendo.

Irreversível.

Irreversível.

Irreversível.
| ORIENTAÇÕES E RESPOSTAS
2. Esta atividade oportuniza a mobilização da habilidade EF04CI02, relacionada às transformações dos materiais no cotidiano quando expostos a diferentes condições, bem como da habilidade EF04CI03, relacionada à conclusão de que algumas transformações, como as mudanças de estado físico, são reversíveis.
3. Esta atividade possibilita a mobilização da habilidade EF04CI03, pois os estudantes devem analisar e concluir quais das
transformações apresentadas são reversíveis e quais são irreversíveis.
4. Esta atividade oportuniza a mobilização da habilidade EF04CI01, relacionada à identificação de misturas em situações cotidianas.
5. a) Sim. A água que ferve passa por uma mudança reversível, pois ela se transforma em vapor, mas pode voltar ao estado líquido ao ser resfriada. Já o ovo cozido passa por uma mudança irreversível, pois, depois de cozido, não pode voltar ao seu estado cru.
NÃO ESCREVA
Sorvete
Pão assando.
Fungo decompondo tronco de árvore.
Lenha queimando em forno.
Carro enferrujado.
4 Analise as afirmativas a seguir sobre a água mineral e copie a afirmação correta no caderno.
I. A água mineral não é uma mistura, pois é formada apenas por água.
II. A água mineral é uma mistura, pois contém água e sais dissolvidos. Esses componentes podem ser observados separadamente.
III. A água mineral é uma mistura, pois contém água e sais dissolvidos. No entanto, não é possível observar seus componentes separadamente.
5 Observe a fotografia a seguir e faça o que se pede.

a) É correto afirmar que a situação mostrada na imagem resulta em uma mudança reversível e uma mudança irreversível dos materiais? Explique.
b) Ao cozinhar o ovo, algumas pessoas costumam colocar vinagre na água para evitar que a casca do ovo quebre durante o cozimento. A mistura de água e de vinagre poderia ser identificada visualmente? Por quê? Utilize o termo solúvel em sua resposta.
c) Algumas práticas do dia a dia têm origem no conhecimento popular e podem ou não ter explicações científicas. Um exemplo é a ideia de colocar vinagre na água citada no item b. Nesse caso, há explicações científicas que justificam esse procedimento. Você conhece outro exemplo de conhecimento popular? Com o auxílio de um adulto da família, pesquise e compartilhe com a turma, destacando se existe ou não explicação científica para ele.
b) A mistura não poderia ser identificada visualmente, porque o vinagre é solúvel na água, ou seja, ele se dissolve completamente nela.
c) Resposta pessoal. Incentivar os estudantes a conversar com seus familiares a respeito do assunto e a valorizar os saberes populares, destacando que alguns têm explicações científicas e outros não, sem desmerecer sua importância cultural.
No exemplo da atividade, a adição de vinagre à água do cozimento tem uma
[...]
Os saberes populares [...] fazem parte da prática cultural de determinado local e grupo coletivo. São conhecimentos obtidos empiricamente, a partir do “fazer”, que são transmitidos e validados de geração em geração, principalmente por meio da linguagem oral, de gestos e atitudes (GONDIM, 2007). [...] Para Pinheiro e Giordan (2010), embora algumas dessas práticas sejam realizadas sem um entendimento do porquê dos procedimentos, baseando se em crenças e opiniões, outro grupo de saberes é constituído por explicações mais elaboradas, apropriandose de outros conhecimentos. [...]
[...] Alguns autores [...] têm assinalado como função da escola a valorização desse conhecimento. Não se trata de uma supervalorização do saber popular, mas sim reconhecer o conhecimento existente nas práticas cotidianas de uma parcela da população que, muitas vezes, não é vista como detentora de saber. Trata de desconstruir o paradigma de uma única forma de educação, baseada somente no conhecimento científico, e explorar novas possibilidades.
[...]
02/10/25 15:56
explicação científica: os ácidos (como o vinagre) são capazes de desnaturar proteínas, ou seja, modificar sua estrutura. Assim como os ácidos, o sal também tem essa função. Quando estão presentes na água, esses ingredientes ajudam na solidificação da clara do ovo, de modo que, se a casca rachar durante o cozimento, evitam que o conteúdo vaze.
XAVIER, Patrícia Maria Azevedo; FLÔR, Cristhiane Carneiro Cunha. Saberes populares e educação científica: um olhar a partir da literatura na área de ensino de Ciências. Ensino, Pesquisa e Educação em Ciências, Belo Horizonte, v. 17, n. 2, ago. 2015. Disponível em: https://doi.org/10.1590/1983 21172015170202. Acesso em: 25 ago. 2025.
Ovos em cozimento na água fervendo.
NÃO ESCREVA NO LIVRO.
Alternativa III. Consultar orientações no Livro do Professor.
Consultar orientações e respostas no Livro do Professor
INTRODUÇÃO À UNIDADE
Uma das temáticas abordadas nesta unidade é a orientação espacial por meio dos astros e de instrumentos específicos, como a bússola. Para isso, são apresentados os pontos cardeais e formas de identificar suas direções de maneira aproximada, utilizando o movimento aparente do Sol, um gnômon e uma bússola. Em relação à bússola, destacam-se as propriedades magnéticas de sua agulha, fundamentais para seu funcionamento.
Outra temática explorada envolve a contagem do tempo com base em movimentos cíclicos da Terra – como a rotação e a translação – e no ciclo lunar. Um aspecto relevante é que esses movimentos foram utilizados por diferentes culturas ao longo da história para a criação de calendários, inclusive o calendário adotado pelo Brasil e por muitos outros países.
HABILIDADES
• EF04CI09
• EF04CI10
• EF04CI11
OBJETIVOS DE APRENDIZAGEM
• Reconhecer a mudança de posição do Sol no céu ao longo de um dia, fenômeno denominado movimento aparente do Sol.
• Explicar a variação de posição das sombras ao longo de um dia, em decorrência do movimento aparente do Sol.
• Localizar a direção aproximada dos pontos cardeais observando o movimento aparente do Sol, com e sem auxílio de um gnômon.


• Reconhecer a importância de instrumentos de orientação espacial, como a bússola e o GPS.
• Explicar o funcionamento de uma bússola, considerando as propriedades magnéticas envolvidas.
• Construir uma bússola caseira.
• Comparar as indicações de direção de uma bússola caseira com as de um gnômon.
• Explicar os movimentos de rotação e translação terrestres.
• Compreender o ciclo da Lua.
• Reconhecer a ciclicidade dos movimentos da Terra e da Lua e a possibilidade de utilização deles para a marcação do tempo.
• Diferenciar calendários solares, lunares e lunissolares.
Consultar orientações e respostas no Livro do Professor
1. Na imagem, a professora e um estudante estão utilizando instrumentos que podem ajudar o grupo a se localizar na trilha. Quais são esses instrumentos?
2. Qual você acha que é a posição do Sol no céu na imagem? Explique como você chegou a essa conclusão.
111


ENCAMINHAMENTO
A imagem de abertura constitui um recurso pedagógico eficaz para iniciar a unidade de forma significativa e conectada ao cotidiano dos estudantes.
Sugere-se estimular a leitura da imagem e destacar seus detalhes, como a professora utilizando um GPS em um dispositivo móvel e o estudante usando uma bússola, evidenciando diferentes formas de orientação no espaço. O cenário representado desperta a curiosidade, mobiliza conhecimentos prévios e incentiva aprendizagens investigativas.
de GPS e da bússola, e à observação da posição das sombras ao longo do dia – fortalecendo a conexão entre ciência e vivência.
Apresentar aos estudantes uma situação hipotética: considerem que a menina, ao observar as sombras, tenha dito: “Quando passamos aqui pela manhã, as sombras estavam do outro lado...”. Diante dessa situação, pode-se questionar:
Por que as sombras mudam de posição ao longo do dia?
O que isso tem a ver com o Sol?
Como podemos usar as sombras para nos orientar no espaço?
Essas questões, associadas às atividades presentes na página, funcionam como ponto de partida para o desenvolvimento dos conteúdos da unidade, promovendo a construção do conhecimento baseado na observação, na investigação e na reflexão crítica sobre os fenômenos naturais.
ORIENTAÇÕES E RESPOSTAS
02/10/25 15:58
Propõe-se iniciar com uma roda de conversa, em que os estudantes descrevam livremente a cena, observando os elementos presentes e refletindo sobre alguns pontos, como:
• O que está acontecendo?
• O que cada pessoa faz na cena?
• Quais instrumentos estão sendo usados?
• Em que a estudante de boné vermelho pode estar pensando ao olhar para a sombra do colega?
Esse momento deve acolher diferentes interpretações e estimular a partilha de experiências pessoais relacionadas ao uso
1. Verifique se os estudantes reconhecem o dispositivo móvel com aplicativo de mapas que usa o sistema de localização GPS na mão da professora que está em primeiro plano na imagem e a bússola na mão da criança que está logo atrás dela como instrumentos que podem auxiliar na localização no espaço.
2. Resposta pessoal. Espera-se que os estudantes reconheçam a posição do Sol no céu, mais à esquerda, com base na posição das sombras, voltadas para o lado oposto. Esta atividade é uma oportunidade para retomar a habilidade EF02CI07.
ENCAMINHAMENTO
Sugere-se apresentar a sequência de imagens ou construir uma narrativa com a turma com base nas ilustrações, convidando os estudantes a observar atentamente os componentes presentes em cada cena: a posição do Sol no céu, a direção da luz, as sombras projetadas e a mudança de posição do girassol. Esse momento inicial deve ser utilizado para estimular a curiosidade, estabelecer conexões com vivências pessoais e levantar os conhecimentos prévios dos estudantes sobre o tema.
Em seguida, organizar uma roda de conversa, propondo questões investigativas que instiguem a reflexão e a formulação de hipóteses, desenvolvendo a competência geral 2. Alguns questionamentos foram sugeridos na abertura da unidade e podem ser aprofundados neste momento, mas outros podem ser também apresentados, como:
• O que muda nas três ilustrações?
• Onde está o Sol em cada situação representada?
• Por que o Sol parece estar em lugares diferentes ao longo do dia? É o Sol que se move ou é a Terra?
• Por que o girassol está virado para lados diferentes em cada foto?
• As sombras mudam de posição ao longo do dia? Por quê?
Orientar os estudantes a registrar as respostas iniciais no caderno, que podem ser retomadas ao longo do estudo da unidade para que avaliem a construção do próprio aprendizado sobre essa temática.
CAPÍTULO
1
2. Resposta pessoal. Espera-se que os estudantes comentem as variadas posições do girassol e as sombras formadas por pessoas e plantas, que mudaram de direção e tamanho. É possível que alguns estudantes não saibam que o girassol é uma flor que acompanha o movimento do Sol no céu ao longo de um dia. Incentivar aqueles que conhecem a planta a compartilhar seus conhecimentos com os colegas.
NO CÉU, O SOL
Certo dia, Fabiano saiu de casa três vezes: pela manhã, para comprar pães; ao meio-dia, para levar Amanda, sua filha, à escola; e, no fim da tarde, para buscá-la na escola. Em cada trajeto, fotografou um mesmo girassol que havia no caminho. A cada nova fotografia, Fabiano percebeu que a flor estava em uma posição diferente. Observe nas ilustrações a seguir a situação descrita.
Representação de três momentos do dia de Fabiano.

1. Você já percebeu que o Sol parece mudar de posição no céu ao longo de um dia? Converse com os colegas sobre o assunto.
1. Resposta pessoal. Os estudantes podem responder que já perceberam o Sol nascendo de um lado do horizonte e se pondo do outro, por exemplo.
2. Considere que nas imagens não fosse possível ver o Sol. Quais componentes nas ilustrações ajudariam a perceber que o Sol mudou de posição no céu?
3. Você acha que, ao compreender as posições do Sol no céu ao longo do dia, podemos identificar as direções norte, sul, leste e oeste? Se sim, como?
Resposta pessoal. Utilize o questionamento para avaliar o conhecimento prévio dos estudantes sobre pontos cardeais e sua relação com as diferentes posições do Sol no céu.
| PARA O ESTUDANTE
LIVRO. PRADO, Jane. Girassol quer sol. [S. l.]: Edição da Autora, c2020. Disponível em: https:// www.janeprado.com.br/_files/ugd/16300e_14e 9ddab9cf44fa1b6b122fe94944a61.pdf. Acesso em: 21 ago. 2025.
O livro está disponível on-line e traz um poema sobre o girassol.

NÃO ESCREVA NO LIVRO.
IMAGENS FORA DE PROPORÇÃO AS CORES NÃO
DIFERENTES POSIÇÕES
DO SOL NO CÉU
Você já percebeu onde o Sol está no céu quando você chega à escola? Quando você vai embora, ele continua no mesmo lugar?
Ao longo do dia, as posições que o Sol ocupa no céu variam. Com essa mudança de posição, os ambientes são iluminados de forma diferente com o passar do tempo. Pela manhã, por exemplo, a luz do Sol vem de um lado; à tarde, vem de outro.
Observe as imagens a seguir.






ENCAMINHAMENTO
Os tópicos Diferentes posições do Sol no céu e Pontos cardeais fornecem subsídios teóricos para o desenvolvimento posterior da habilidade EF04CI09
Para iniciar a aula, propor uma conversa breve e contextualizada com a turma, fazendo algumas perguntas, como:
• O Sol “nasce” sempre no mesmo lugar?
• E onde ele se “põe”?
Esse momento inicial deve acolher as diferentes percepções e experiências dos
É fundamental alertar os estudantes a nunca olharem diretamente para o Sol, pois isso pode causar sérios danos à visão. Esse aviso deve ser reforçado continuamente ao longo da unidade, promovendo uma atitude de cuidado e responsabilidade.
ATIVIDADES FAMÍLIA
Propor aos estudantes uma atividade que possam realizar durante o fim de semana com a ajuda de um adulto da família. Nesta atividade, eles vão contornar a sombra de um objeto em uma folha de papel (papel kraft ou cartolina) em três momentos do dia (manhã, meio-dia e tarde), sempre no mesmo local e posição. É importante escolher um ambiente seguro e iluminado, como o quintal de casa, a calçada ou uma praça próxima. Caso não seja possível manter a folha e o objeto no lugar durante todo o período, deve-se marcar o chão para indicar o ponto exato, facilitando a comparação das sombras.
Representação de algumas posições em que vemos o Sol no céu ao longo de um dia.
estudantes, permitindo que compartilhem observações cotidianas. Espera-se que os estudantes compreendam, nesse primeiro contato, que o Sol parece se mover no céu. Trata-se de um fenômeno denominado movimento aparente do Sol, resultado da rotação da Terra em torno do próprio eixo –conceito que será aprofundado adiante, no capítulo 3. Mas, neste primeiro momento, o foco está na percepção e na descrição do fenômeno, incentivando os estudantes a estabelecer relações com seu cotidiano.
A proposta é que os estudantes tragam os registros para a sala de aula a fim de compará-los com os dos colegas, analisando as mudanças no comprimento e na direção das sombras ao longo do dia. Ao final, a turma pode organizar um mural coletivo com os registros.
IMAGENS FORA DE PROPORÇÃO
AS CORES NÃO SÃO REAIS
ENCAMINHAMENTO
Explicar brevemente a rosa dos ventos como representação gráfica que organiza os pontos cardeais (norte, sul, leste e oeste) e auxilia na leitura de mapas e na navegação. Se considerar pertinente, comentar também sobre os pontos colaterais – nordeste (NE), sudeste (SE), sudoeste (SO) e noroeste (NO) –, que se localizam entre os pontos cardeais e tornam a orientação ainda mais precisa.
PONTOS CARDEAIS
Os pontos cardeais – norte, sul, leste e oeste – são usados como referência para localização. Eles ajudam a indicar direções e caminhos.
Em diversos mapas, há uma figura chamada rosa dos ventos, que mostra os pontos cardeais. Nela, costumam aparecer as iniciais: N para norte, S para sul, L para leste e O para oeste.
Os mapas são organizados com base nessas direções. Ao olhar para um mapa, tudo o que estiver na direção do ponto N da rosa dos ventos está ao norte, e o que estiver na direção do ponto S está ao sul.
Rosa dos ventos.
No cotidiano, são usados frequentemente os termos nascer e pôr do Sol para se referir aos momentos em que o Sol aparece e desaparece no horizonte, respectivamente. Contudo, isso não significa que o Sol realmente se move. O evento que percebemos como o “nascer” do Sol ocorre, em geral, na direção leste; o “pôr” do Sol, na direção oeste. No entanto, essas direções são aproximadas, pois a posição exata em que o Sol “nasce” e “se põe” varia ao longo do ano, de acordo com os movimentos da Terra. Somente nos dias que marcam o início da primavera e o início do outono, chamados de equinócio (momentos do ano em que o dia e a noite têm praticamente a mesma duração, pois o Sol incide diretamente sobre a linha do equador), é que o Sol nasce exatamente no ponto cardeal leste e se põe no ponto cardeal oeste. Sobre isso, leia o Texto de apoio.
Representação de rosa dos ventos indicando os pontos cardeais.
Quando não há mapas disponíveis, também é possível estimar as direções observando o Sol. Vemos o Sol “nascer” aproximadamente na direção leste e “se pôr” aproximadamente na direção oeste. Se você estender o braço direito na direção em que o Sol “nasce” e o esquerdo na direção em que ele “se põe”, à sua frente estará o norte e, atrás de você, o sul, como representado na imagem a seguir.
IMAGENS FORA DE PROPORÇÃO
AS CORES NÃO SÃO REAIS

Representação de uma criança apontando o braço direito para a direção em que o Sol “nasce” (leste) e o braço esquerdo para a direção em que o Sol “se põe” (oeste). Estão representadas também as direções norte e sul.
Também é importante destacar que, devido a essa variação, usar o corpo para identificar as direções norte, sul, leste e oeste não é um método preciso, mas aproximado.
TEXTO DE APOIO
[...]
Os locais onde o Sol nasce e se põe e o caminho que o Sol faz no céu também [diferem] de acordo com as estações do ano. Nos equinócios, o sol nasce no ponto cardeal leste e se põe no ponto cardeal oeste, e nos solstícios nasce em máximo afastamento do ponto cardeal
leste e se põe no máximo afastamento do ponto cardeal oeste. No hemisfério sul, o máximo afastamento do nascer do sol no solstício de verão ocorre para sudeste e no ocaso para sudoeste; inversamente, no solstício de inverno o máximo afastamento do Sol no nascer é para nordeste e no ocaso para noroeste.
[...]
BRASIL. Ministério da Ciência, Tecnologia e Inovação. Observatório Nacional. Primavera chega às 22h03 do dia 22 de setembro. Gov.br, 21 set. 2022. Disponível em: https://www.gov.br/ observatorio/pt-br/assuntos/noticias/prima vera-chega-as-22h03-brt-do-dia-22-de-setembro. Acesso em: 4 set. 2025.
ATIVIDADES
ATIVIDADES
1. a) Ao abrir os braços e apontar o braço direito para a direção onde o Sol “nasce”, seu braço esquerdo estaria apontado para o oeste. Assim, à sua frente seria o norte.
1. Copie as frases no caderno e corrija as que estiverem erradas.
a) Ao abrir os braços e apontar o braço direito para a direção onde o Sol “nasce”, seu braço esquerdo estaria apontado para o sul. Assim, à sua frente seria o norte.
b) A rosa dos ventos indica os pontos cardeais. Correta.
c) O Sol “nasce” aproximadamente na direção oeste e “se põe” aproximadamente na direção leste.
O Sol “nasce” aproximadamente na direção leste e “se põe” aproximadamente na direção oeste.
2. Observe o mapa do zoológico representado a seguir e responda às questões no caderno, considerando as direções dos pontos cardeais indicadas pela rosa dos ventos.
Consultar orientações no Livro do Professor
Representação do mapa de um zoológico.
Restaurante
ENTRADA
IMAGENS FORA DE PROPORÇÃO AS CORES NÃO SÃO REAIS
a) No mapa, o portão de entrada do zoológico encontra-se ao sul, ao norte, a leste ou a oeste? Ao sul.
b) Se você estivesse vendo a serpente, em qual direção estaria o elefante?
Como sugestão de ampliação da atividade 2 do Livro do Estudante, propor aos estudantes que se organizem em duplas para criar um percurso dentro do zoológico representado na imagem, utilizando os pontos cardeais como forma de orientação.
A proposta consiste em escolher um ponto de partida e um ponto de chegada – por exemplo, sair do lago do jacaré e chegar ao recinto do rinoceronte – e descrever o trajeto utilizando apenas indicações de direção (norte, sul, leste e oeste), incluindo pontos de referência, como o restaurante ou o recinto de outros animais.
No entanto, recomendar que eles não revelem o destino final durante a descrição. O colega da dupla deverá considerar o percurso descrito e tentar descobrir, com base nas orientações dadas, qual é o local de chegada.
A atividade visa estimular a atenção, desenvolver o raciocínio espacial e reforçar a compreensão dos pontos cardeais de forma lúdica e interativa.
| PARA O ESTUDANTE
c) Se você estivesse no restaurante, qual seria a direção do lago do jacaré?
Estaria na direção norte. Seria a direção oeste.
d) Se você tivesse acabado de entrar no zoológico, que direção deveria seguir para chegar ao panda? Para a direção leste.
| PARA O PROFESSOR
TEXTO. AFONSO, Germano Bruno. Mitos e estações no céu Tupi-Guarani. Revista Ciência & Cultura, c2022. Disponível em: https://revistacienciaecultura.org.br/?arti gos=mitos-e-estacoes-no-ceu-tupi-guara ni. Acesso em: 21 ago. 2025.
Os conhecimentos sobre os pontos cardeais também fazem parte dos saberes tradicionais de diversos povos, como as comunidades indígenas brasileiras. Esse artigo apresenta alguns exemplos sobre o assunto.
| ORIENTAÇÕES E RESPOSTA
02/10/25 15:58
2. Ressaltar que os zoológicos não têm função apenas de lazer, mas também são espaços de educação e conscientização ambiental. É essencial que sejam constantemente fiscalizados, garantindo o bem-estar e o cuidado adequado dos animais. Durante a edição desta obra, tramitava a lei que atualiza as normas de criação e funcionamento de zoológicos e aquários, reforçando seu papel como centros de conservação da biodiversidade.
LIVRO. QUEIRÓS, Bartolomeu Campos de. Rosa dos ventos. São Paulo: Global, 2009.

Reprodução da capa.
O livro retrata os pontos cardeais com ludicidade e poesia.
REPRODUÇÃO/GLOBAL
NÃO ESCREVA NO LIVRO.
Panda
Girafa
Serpente
Leão Rinoceronte
Elefante
Macaco
Jacaré
Cisne
VOCÊ CIDADÃO!
Esta seção oferece uma oportunidade para trabalhar o Tema Contemporâneo Transversal (TCT)
Educação para o consumo, ao incentivar a reflexão sobre a importância de aproveitar a iluminação natural como estratégia para reduzir o consumo de energia elétrica e, consequentemente, os gastos na conta de luz. Além disso, contribui para a abordagem do Tema Contemporâneo Transversal (TCT)
Educação ambiental, ao promover a conscientização sobre a necessidade de reduzir a demanda por novas usinas de geração de energia, colaborando para a diminuição dos impactos ambientais associados a essas construções.
Sugere-se realizar a leitura compartilhada do texto com toda a turma. Destacar que o trajeto diário do movimento aparente do Sol no céu influencia diretamente o planejamento das edificações, especialmente em relação à posição dos cômodos e das janelas. Explicar que esse conhecimento é fundamental para que as construções recebam uma quantidade adequada de luz solar ao longo do dia, o que contribui para uma melhor iluminação natural e maior conforto térmico nos ambientes internos. Ressaltar que ambientes bem iluminados e ventilados naturalmente reduzem a necessidade do uso de lâmpadas e aparelhos de climatização, como ventiladores e aparelhos de ar-condicionado. Relacionar esses aspectos ao consumo consciente de energia elétrica.
| ORIENTAÇÕES E RESPOSTAS
1. Planejar a construção considerando a incidência da luz solar apresenta várias vantagens: ao aproveitar
VOCÊ
CIDADÃO!
As construções e o Sol
A posição do Sol no céu durante o dia é um fator importante na construção de casas e prédios. Saber as direções do “nascer” e do “pôr” do Sol ajuda a posicionar janelas e cômodos (quartos e sala, por exemplo) para aproveitar melhor a luz solar. Assim, é menor a necessidade de acender lâmpadas. Além disso, os ambientes ficam mais frescos, principalmente os quartos, reduzindo o uso de ar-condicionado e ventiladores. Essas ações geram redução no consumo de energia elétrica e maior conforto, sobretudo em regiões de clima quente. Com menor uso de energia, as usinas precisam gerar menos eletricidade. Isso ajuda a evitar a construção de novas usinas, que podem derrubar florestas e poluir a água e o ar. Além disso, gastar menos energia deixa a conta de luz mais barata.

1. Segundo o texto, quais são as vantagens de planejar uma construção pensando nas diferentes posições do Sol no céu em um dia?
Consultar orientações e resposta no Livro do Professor
2. Em sua escola, os ambientes aproveitam bem a luz do Sol? O que poderia ser feito para melhorar?
3. Com a ajuda do professor, montem uma proposta para reduzir o uso de lâmpadas elétricas na escola durante o dia, aproveitando mais a luz solar. Apresentem essa proposta à direção da escola.
Consultar orientações e resposta no Livro do Professor Respostas pessoais. Se necessário, promover uma visita com os estudantes a diferentes ambientes da escola para que eles façam observações e anotem os detalhes.
a iluminação natural dos cômodos ao longo do dia, a necessidade de acender lâmpadas é reduzida, os ambientes ficam mais frescos e, por isso, reduz-se o uso de ventiladores e aparelhos de ar-condicionado. Essas medidas proporcionam redução no consumo de energia elétrica, gerando economia na fatura do fornecimento de luz e diminuindo os impactos ambientais causados pela geração de energia elétrica.
3. Resposta pessoal. O objetivo desta atividade é que os estudantes proponham ideias para melhorar o aproveitamento da luz solar na escola. Algumas sugestões
que podem aparecer nas propostas são: trocar as janelas existentes por janelas maiores; usar cortinas claras que deixem a luz passar; reorganizar as salas para que as mesas recebam luz solar; entre outras. Como a pesquisa das condições de iluminação exige a visita aos diferentes ambientes da escola, orientar os estudantes a adotar um comportamento que garanta a própria segurança e evite transtornos a outras turmas e funcionários. Esta atividade colabora para o desenvolvimento da competência geral 10 e da competência específica 8 de Ciências da Natureza.
NÃO ESCREVA NO LIVRO.
Museu Oscar Niemeyer, em Curitiba (PR), em 2025. A iluminação natural é utilizada em algumas salas do interior do museu, o que reduz o consumo de energia elétrica.
GNÔMON

Você já percebeu como a posição das sombras de um mesmo objeto imagens.

diferentes horários do dia.
DIALOGANDO
Observando as fotografias, o que é possível dizer sobre a posição do Sol no céu? Espera-se que os estudantes observem a posição das sombras projetadas pelo obelisco e digam que o Sol ocupa posições diferentes no céu durante o dia.
As mudanças na posição das sombras ao longo do dia podem ser observadas com o auxílio de uma vareta fixada no chão ou em outra superfície. A sombra dessa vareta pode ser marcada em diferentes momentos do dia. Esse instrumento é chamado gnômon.
FORA DE PROPORÇÃO AS CORES NÃO SÃO REAIS.

Representação de um gnômon.
As mudanças no tamanho e na posição da sombra dos gnômons durante o dia ocorrem devido às diferentes posições do Sol no céu. Elas também mostram a passagem do tempo. Por isso, por muitos anos, os gnômons foram usados para construir relógios de sol. Esses relógios indicam as horas enquanto o Sol está visível no céu. Atualmente, esse tipo de relógio é pouco utilizado no dia a dia, mas é comum encontrá-lo em parques e museus.
Orientar os estudantes a identificar o horário marcado no relógio de sol da fotografia. O relógio marca alguns minutos após as 14 horas.
ENCAMINHAMENTO
Relógio de sol indicando o horário pela sombra do gnômon em Brasília (DF), 2023.
O tópico Gnômon fornece subsídios teóricos para o desenvolvimento da habilidade EF04CI09 e, posteriormente, para o trabalho com a seção Você cientista! das páginas 118 e 119.
Ao explorar as imagens do obelisco, explicar que essa construção é um monumento arquitetônico em forma de coluna alta e estreita, de quatro lados, que se afunila em direção ao topo e termina em uma pirâmide. Se julgar oportuno, comentar que os primeiros obeliscos, construídos no antigo Egito, eram esculpidos em um

|
PARA O ESTUDANTE
VÍDEO. QUARTO ano: aula Observatório Solar Indígena. 2020. 1 vídeo (4 min 46 s). Publicado pelo canal Instituto Iprodesc. Disponível em: https://www. youtube.com/watch?v=aH zJxSU_9Dw. Acesso em: 21 ago. 2025.
O vídeo apresenta detalhes sobre um observatório solar indígena, construído por povos Tupi-Guarani. Esse observatório conta com um gnômon na parte central.
| PARA O PROFESSOR
TEXTO . MARTINS, Max; PEREZ, Silvana. Aprendizagem baseada em projetos e o estudo de conceitos básicos de Astronomia nas séries iniciais do Ensino Fundamental: uma proposta didática baseada no movimento aparente do Sol e construção de relógios solares. Experiências em Ensino de Ciências, Cuiabá, v. 18, n. 4, 2023. Disponível em: https:// www.fisica.ufmt.br/eencio js/index.php/eenci/article/ view/1351/1064. Acesso em: 21 ago. 2025.
03/10/25 21:21
único bloco de pedra (geralmente granito) e erguido em pares na entrada de templos, como símbolo de poder ou devoção religiosa. Hoje, os obeliscos são frequentemente usados como símbolos comemorativos e elementos decorativos em praças e monumentos ao redor do mundo.
Orientar a análise da imagem do relógio de sol, perguntando aos estudantes se conseguem identificar a hora indicada. Caso encontrem dificuldades, auxilie-os a reconhecer o número para o qual a sombra da haste central aponta de forma aproximada.
O artigo apresenta uma proposta didática em forma de oficina de quatro horas para o ensino de conceitos básicos de Astronomia a estudantes do 2o ao 4o ano do Ensino Fundamental. A atividade envolve a construção de um relógio solar para investigar o movimento aparente do Sol no céu.
Fotografias do Obelisco Mausoléu aos Heróis de 32 no Parque do Ibirapuera, no município de São Paulo, tiradas em
IMAGENS
ADILSON SOCHODOLAK/SHUTTERSTOCK.COM
VOCÊ CIENTISTA!
O objetivo da atividade desta seção é que os estudantes construam um gnômon na escola e que, com base nele, localizem os pontos cardeais, mobilizando a habilidade EF04CI09
A elaboração de hipóteses, acompanhada de metodologias capazes de testá-las, colabora para o desenvolvimento da competência geral 2 e da competência específica 2 de Ciências da Natureza.
Organizar previamente todos os materiais necessários para a atividade experimental, escolhendo um espaço adequado, preferencialmente bem iluminado pela luz solar. Garantir que o local seja protegido, pois o experimento será retomado posteriormente na seção Você cientista! das páginas 127 e 128. Caso não seja possível conservar o material até esse momento, optar por realizar os dois experimentos de forma consecutiva, promovendo a discussão dos resultados no momento mais apropriado.
Antes de iniciar o experimento, reforçar o alerta para que os estudantes não olhem diretamente para o Sol, uma vez que isso pode ocasionar danos à visão deles. Cuidar também para que eles manipulem de forma adequada e segura os palitos de churrasco, evitando acidentes. Para a montagem do aparato, é necessário fixar o palito de churrasco no papelão. Isso pode ser feito utilizando cola ou fixando o palito com massa de modelar na base antes de colá-lo, garantindo maior estabilidade.
Caso não seja possível realizar a marcação das sombras nos dois horários (manhã e tarde) com a mesma turma, recomenda-se adaptar o experimento utilizando duas turmas
Gnômon e os pontos cardeais
Como um gnômon pode ajudar a descobrir as direções dos pontos cardeais? Em grupos, pensem sobre o assunto e anotem suas ideias iniciais no caderno. Em seguida, façam a atividade a seguir.
DO QUE EU PRECISO
• Quadrado de cartolina branca com lados de 30 centímetros
• Quadrado de papelão com lados de 35 centímetros
• Cola e fita adesiva
• Palito de churrasco ou vareta de madeira
• 30 centímetros de barbante
• Lápis preto e lápis de cor azul e vermelho
• Régua
COMO FAZER
1. Procurem um local do pátio da escola que receba luz do Sol tanto de manhã quanto à tarde. A atividade deve ser feita nesse local.
2. Centralizem e colem a cartolina na base de papelão.
IMAGENS FORA DE PROPORÇÃO
AS CORES NÃO SÃO REAIS
Esta atividade pode ser realizada em colaboração com turmas de outros períodos.
Representação do procedimento 2
3. Com a ajuda do professor, utilizem a cola para fixar o palito de churrasco no meio de uma das bordas da cartolina.
ATENÇÃO!
Cuidado ao manipular os palitos de churrasco. Suas pontas podem causar ferimentos. Nunca olhem diretamente para o Sol no céu. Isso pode causar sérios danos à visão.
distintas – uma do período matutino e outra do vespertino. Alternativamente, o professor pode realizar a marcação da sombra no horário complementar, garantindo a continuidade da atividade e a obtenção dos dados necessários para a análise posterior.
Ao final do experimento, organizar uma roda de conversa para que a turma socialize suas observações e discuta os dados registrados ao longo da atividade experimental. Estimular a participação ativa dos estudantes, promovendo um ambiente acolhedor e colaborativo que favoreça o engajamento de todos na troca de ideias.
Representação do procedimento 3 papelão cartolina
cartolina papelão palito de churrasco
ALEX ARGOZINO
ALEX ARGOZINO
4. Pela manhã, posicionem a montagem de maneira que a sombra do palito aponte para um dos lados da cartolina. Com a fita adesiva, fixem a montagem no chão. Depois, usem um lápis preto para marcar a sombra do palito com um traço.
IMAGENS FORA DE PROPORÇÃO.
AS CORES NÃO SÃO REAIS
Representação do procedimento 4
5. Amarrem uma ponta do barbante no palito e a outra ponta no lápis de cor azul. Tenham cuidado para o palito não sair do lugar.
6. Mantendo o barbante esticado, usem esse lápis para marcar uma linha curva até o outro lado da cartolina.
7. À tarde, observem a sombra do palito. Quando ela tocar novamente a linha curva feita na cartolina, marquem essa sombra.
8. Com a régua e o lápis de cor vermelho, tracem uma linha reta unindo as extremidades das duas sombras, a da manhã e a da tarde. Essa reta corresponde à direção leste-oeste.
palito de churrasco
palito de churrasco sombra da manhã sombra da tarde
Representação do procedimento 6 Representação do procedimento 8
VAMOS CONVERSAR?
Consultar orientações e respostas no Livro do Professor sombra da manhã
1. Pela manhã, a sombra do palito é projetada para qual lado: leste ou oeste? E a sombra da tarde? Expliquem a resposta de vocês.
2. Com a montagem que vocês fizeram, é possível descobrir onde ficam o norte e o sul? Expliquem a resposta de vocês.
3. Retomem as ideias iniciais do grupo. Elas foram confirmadas na atividade?
Ao finalizar a discussão sobre o experimento, orientar a turma a realizar as atividades propostas nesta seção. É importante valorizar as contribuições dos estudantes, incentivando-os a expressar suas hipóteses, dúvidas e descobertas e a relacionar o que foi vivenciado no experimento com situações do cotidiano.
| ORIENTAÇÕES E RESPOSTAS
1. Espera-se que os estudantes respondam que pela manhã a sombra do palito é projetada para o oeste, e, à tarde, para o leste. Considerando maior detalhamento,
de braços abertos, com o braço direito apontando para o leste e o esquerdo para o oeste, à frente será o norte e atrás será o sul. 3. Resposta pessoal. As ideias iniciais podem ser confirmadas ou não. Conduzir a conversa com os estudantes de modo que possam analisar as hipóteses e compará-las com os resultados que obtiveram na atividade.
TEXTO DE APOIO
Muitas concepções alternativas são reconhecidas entre os diversos grupos de estudantes, em especial nos da educação básica. Dentre elas, o movimento aparente do Sol, por mais quotidiano que seja, proporciona variadas interpretações. [...] As atividades práticas em sala de aula, como a de registrar o movimento do Sol por meio das sombras de um gnômon, preenchem uma pequena parcela das infinitas necessidades do ensino de ciências e da busca de uma motivação para o despertar do interesse de crianças e jovens para a ciência e suas complexas relações com o cotidiano. [...]
02/10/25 15:58
à medida que o Sol se eleva no céu, no Hemisfério Sul, a sombra vai se encurtando e inclinando-se em direção ao sul, ficando menor por volta do meio-dia solar (momento em que o Sol está no ponto mais alto do céu), quando aponta diretamente nessa direção. Na parte da tarde, a posição do Sol se desloca em direção ao oeste, fazendo a sombra se alongar e deslocar gradualmente até o leste, posição em que permanece no momento do “pôr” do Sol. 2. Sim. É possível traçar uma linha perpendicular ao eixo leste-oeste. Essa nova linha mostra a direção norte-sul. Ao ficar
[...] o trabalho docente no ensino de Astronomia deve priorizar a aproximação da explicação com a assimilação do fenômeno exposto, uma vez que esta ciência abarca conceitos abstratos à concepção humana. [...]
TROGELLO, A. G.; NEVES, M. C. D.; SILVA, S. de C. R. da. A sombra de um gnômon ao longo de um ano: observações rotineiras e o ensino do movimento aparente do Sol e das quatro estações. Revista Latino-Americana de Educação em Astronomia, n. 16, p. 7-26, 2013. Disponível em: https://www.relea.ufscar. br/index.php/relea/article/ view/179/246. Acesso em: 21 ago. 2025.
ALEX ARGOZINO
ALEX ARGOZINO
ALEX ARGOZINO
ENCAMINHAMENTO
Iniciar a proposta com uma conversa coletiva para levantar os conhecimentos prévios dos estudantes sobre instrumentos de orientação. Perguntar se já ouviram falar em bússola, GPS, mapas ou outros instrumentos utilizados na navegação espacial. Incentivá-los a relatar situações em que precisaram se localizar ou ajudar alguém a encontrar um caminho.
Contextualizar a temática, enfatizando a importância dos instrumentos de orientação ao longo da história e em diferentes contextos do cotidiano, como viagens, trilhas, navegação e até em aplicativos de celular. Estabelecer uma conexão com experiências próximas dos estudantes, como passeios em família, uso de aplicativos de mapas ou jogos que envolvam localização.
Essa discussão ajuda a desenvolver a competência específica 3 de Ciências da Natureza, além de proporcionar o trabalho com o Tema Contemporâneo Transversal (TCT) Ciência e tecnologia.
Ao finalizar a discussão, possibilitar que a turma realize seus apontamentos individuais acerca das atividades da página. Orientar o registro de suas respostas no caderno para que sejam retomadas ao longo do capítulo, permitindo que os estudantes comparem suas concepções iniciais com os conhecimentos que serão construídos.
INSTRUMENTOS
DE ORIENTAÇÃO
Atualmente, existem diferentes instrumentos que ajudam as pessoas a se localizar e a andar por lugares que não conhecem. Observe a fotografia a seguir, que mostra um desses instrumentos, e responda às questões.

Tela no interior de um veículo mostrando um caminho em um mapa no município de São Paulo, 2022. Consultar orientações e respostas no Livro do Professor
1. Você já esteve em algum veículo com um adulto que usava um dispositivo que mostra mapas, como o da imagem? Compartilhe sua experiência com os colegas.
2. Esse dispositivo funciona com um sistema para localização. Você sabe o nome dele?
3. Como você acha que as pessoas se localizavam no passado, sem a ajuda de dispositivos como esse?
4. Em filmes e imagens que mostram grandes navegações no passado, é comum aparecerem instrumentos que auxiliavam na localização dos navegadores. Você sabe o nome de algum desses instrumentos?
| ORIENTAÇÕES E RESPOSTAS
1. Resposta pessoal. Orientar os estudantes a compartilhar suas vivências, promovendo um ambiente acolhedor e respeitoso durante os momentos de fala e escuta.
2. Resposta pessoal. O nome é Sistema de Posicionamento Global (GPS). É possível que alguns estudantes já tenham tido contato com um GPS. Para auxiliá-los, comentar algumas utilidades desse sistema, como identificar sua localização
em dado momento e indicar rotas para chegar a um destino.
3. Resposta pessoal. Possíveis respostas: no passado, as pessoas se localizavam pela posição do Sol e de outras estrelas, por mapas em papel, obtendo informações de outras pessoas, por bússolas etc. Permitir que os estudantes expressem seus conhecimentos sobre o assunto e os explorem, de modo a iniciar o debate sobre o tema.
4. Resposta pessoal. Um exemplo é a bússola.
NÃO ESCREVA NO LIVRO.
BÚSSOLAS
Ao longo da história, o ser humano fez diversas descobertas. Muitas delas foram resultantes da observação que ele fazia do que acontecia ao seu redor.
Uma dessas descobertas foi a de uma rocha que atrai pedaços de ferro. Essa rocha foi encontrada em um lugar da Grécia chamado Magnésia, por isso recebeu o nome de magnetita.
Rocha magnetita atraindo objetos feitos de metal.

Também se verificou que um pedaço de magnetita suspenso no ar por um fio, por exemplo, virava sempre na mesma direção. Essas observações contribuíram para que, com o tempo, o ser humano aprendesse a utilizar essa rocha para se orientar.
Na China antiga, por exemplo, a magnetita era utilizada para fazer uma colher que ficava sobre uma placa de bronze. Nessa placa, faziam-se várias indicações relacionadas à Terra e ao céu. A colher ficava no centro da placa, e seu cabo sempre apontava para o sul. Essa foi a primeira bússola de que se tem conhecimento.

chinesa
ENCAMINHAMENTO
Sugere-se iniciar a aula organizando a turma em um semicírculo para retomar o conteúdo estudado anteriormente sobre a orientação pelo Sol. Se considerar oportuno, é possível ampliar a contextualização explicando que, além do Sol, era comum que as populações humanas, especialmente em períodos anteriores ao desenvolvimento de instrumentos modernos, recorressem também à observação dos astros no céu noturno para se localizar. Algumas estrelas e constelações, como o Cruzeiro do Sul, serviam de guia, indicando direções.
leitores. Realizar pausas estratégicas ao longo da leitura para incentivar os estudantes a compartilhar o que compreenderam, favorecendo a oralidade, a escuta ativa e a construção coletiva do sentido do texto.
A contextualização histórica apresentada sobre os primeiros estudos do magnetismo e a construção dos primeiros instrumentos utilizados como bússolas representam uma oportunidade significativa para desenvolver a competência geral 1 Ao compreenderem como os conhecimentos sobre essa temática foram historicamente construídos ao longo do tempo, os estudantes também podem entender a ciência como um empreendimento humano, desenvolvendo a competência específica 1 de Ciências da Natureza.
02/10/25 15:58
Depois dessa contextualização, apresentar a temática de instrumentos de orientação, como a bússola, e propor uma reflexão à turma:
• Por que foi importante desenvolver instrumentos como a bússola, mesmo já existindo formas de orientação baseadas nos astros?
Permitir que os estudantes apresentem suas percepções iniciais, trocando ideias com os colegas.
Após esse momento, conduzir uma leitura conjunta do conteúdo da página, promovendo a alternância entre os
Bússola
antiga, de 400 a.C., feita com uma colher de magnetita.
ENCAMINHAMENTO
Apresentar a bússola como um dos primeiros instrumentos de orientação construídos pelo ser humano. Ressaltar que ela foi fundamental ao longo da história, especialmente nas grandes navegações, explorações geográficas, caminhadas por trilhas e outras situações, uma vez que não havia tecnologias como o GPS. Mostrar que, mesmo hoje, ela continua sendo muito utilizada por navegadores, escoteiros e aventureiros em locais sem sinal de internet ou energia elétrica.
É possível promover o trabalho integrado com História ao relacionar o uso da bússola às navegações marítimas entre os séculos XII e XVI. Para isso, recomenda-se utilizar, como texto complementar, trechos da sugestão de leitura indicada em Para o professor.
No Livro do Estudante, foi apresentada a bússola magnética, cujo funcionamento é influenciado pelas propriedades magnéticas do planeta Terra – como será apresentado adiante nesta unidade. No entanto, vale ressaltar que existem outros tipos de bússola, como a bússola inercial e a bússola giroscópica.
Para o trabalho com a temática, sugere-se, se possível, apresentar uma bússola magnética à turma, para que possa manipulá-la. É fundamental que os estudantes compreendam seu funcionamento, sendo este um subsídio teórico para o desenvolvimento da habilidade
EF04CI10
Orientar os estudantes a acessar, posteriormente, sob a supervisão de um adulto responsável, o link indicado no boxe Para
Muitos anos depois da invenção da primeira bússola, foi descoberto que, se agulhas fossem esfregadas na magnetita, elas também adquiriam a propriedade de apontar sempre para a mesma direção. Essa característica possibilitou o desenvolvimento de outro tipo de bússola.
Nesse caso, a bússola funciona por meio de uma agulha que pode girar livremente sobre um suporte. Essa agulha sempre aponta para a direção norte. Quando o aparelho está alinhado corretamente, é possível identificar as outras direções (sul, leste e oeste).
Bússola moderna. Nas bússolas, as direções geralmente são representadas pelas iniciais em inglês: N (North) para norte, S (South) para sul, E (East) para leste e W (West) para oeste.
Mas por que a agulha da bússola aponta sempre para a direção norte? Isso acontece devido a um fenômeno chamado magnetismo , que vamos estudar a seguir.
PARA VOCÊ EXPLORAR

• BÚSSOLA. Museu de Astronomia e Ciências Afins, [s. l.], c2010. Disponível em: http://site.mast.br/multimidia_instrumentos/bussola_historico.html. Acesso em: 23 jul. 2025.
Sob a supervisão de um adulto, acesse o site do museu para saber mais sobre a invenção da bússola e observar imagens de outros modelos desse instrumento.
você explorar. Nele, poderão encontrar aspectos históricos sobre a bússola. O uso da tecnologia de forma significativa, aprofundando o aprendizado, é uma oportunidade para desenvolver a competência geral 5 e a competência específica 6 de Ciências da Natureza.
| PARA O PROFESSOR
ARTIGO. CORRÊA, Iran Carlos Stalliviere. A origem da bússola e sua evolução. Instituto de Geociências UFRGS, [20--]. Disponível em: http://museudetopogra fia.ufrgs.br/museudetopografia/images/ acervo/artigos/A_origem_e_uso_da_Bsso la.pdf. Acesso em: 21 ago. 2025. Artigo com informações históricas sobre a origem e o uso da bússola ao longo do tempo.
MAGNETISMO
O magnetismo é o fenômeno que explica a capacidade dos ímãs de atrair materiais feitos com alguns tipos de metais, como objetos feitos de ferro. Essa característica é chamada de propriedade magnética. A rocha magnetita, que estudamos anteriormente, tem propriedades magnéticas. Mas, na época da invenção da bússola, essa propriedade ainda não tinha sido estudada.
Os ímãs apresentam duas regiões, que foram chamadas de polo norte (N) e polo sul (S), como representado a seguir. Esses polos determinam como os ímãs interagem entre si e com outros objetos.

Representação dos polos norte (N) e sul (S) de um ímã.
Considere que durante as aulas de Ciências uma professora propôs alguns experimentos para estudar o comportamento dos ímãs.
Em um dos experimentos, os estudantes aproximaram os polos de dois ímãs de diferentes maneiras. Acompanhe, a seguir, os resultados dessa atividade.

Os estudantes perceberam que, ao aproximar polos iguais, como norte com norte ou sul com sul, os ímãs se afastaram. Já ao aproximar polos diferentes, o polo norte e o polo sul, os ímãs se atraíram. Isso ocorre porque polos opostos se atraem.
ENCAMINHAMENTO
Promover uma conversa com a turma para levantar os conhecimentos prévios dos estudantes sobre ímãs e objetos com propriedades magnéticas. Perguntar se já manusearam ímãs e o que observaram em relação ao comportamento desses materiais. Estimular a curiosidade com objetos do cotidiano, como ímãs de geladeira.
Explicar que os ímãs apresentam dois polos: norte e sul; e que esses polos se comportam de maneira específica: polos iguais se repelem e polos opostos se atraem. Destacar que essa é uma característica comum a todos os ímãs.
Complementar explicando que sempre que um ímã é quebrado em duas ou mais partes, cada uma das partes terá um polo norte e um polo sul.
ATIVIDADES
Preparar antecipadamente os materiais necessários, garantindo que cada grupo de estudantes tenha dois ímãs com os polos facilmente identificados. Propor um experimento simples com o objetivo de observar, na prática, os efeitos da atração e da repulsão magnética. Solicitar aos estudantes que se organizem em grupos e posicionem os dois ímãs sobre uma superfície lisa, como uma mesa ou bandeja, e aproximem um do outro lentamente. Pedir que observem se os ímãs sofrem atração ou repulsão. Em seguida, solicitar aos estudantes que invertam um dos ímãs e repitam o movimento de aproximação. Orientá-los a observar que os ímãs sofrerão ações opostas à situação anterior, ou seja, ímãs que sofreram atração na primeira situação, agora, tendem a se afastar mesmo quando empurrados um em direção ao outro e vice-versa.
Incentivar o registro das observações da turma por meio de anotações ou pequenos desenhos. Finalizar com uma breve discussão coletiva para explicar os resultados.
Depois de quebrado, cada pedaço do ímã continua apresentando um polo norte e um polo sul.
IMAGENS FORA DE PROPORÇÃO.
AS CORES NÃO SÃO REAIS.
Se afastam
Se afastam
Se atraem
ENCAMINHAMENTO
Devido à idade escolar dos estudantes, alguns conceitos, como o de campo magnético, não foram apresentados. Se considerar oportuno, abordar esses conceitos baseando-se nas orientações a seguir.
O campo magnético corresponde a uma região do espaço onde atuam forças magnéticas, geradas por cargas magnéticas. Ao redor dos ímãs, por exemplo, existe um campo magnético. É possível visualizar uma representação das linhas de seu campo de forma prática, na atividade sugerida em +Atividades
A Terra também apresenta um campo magnético. Acredita-se que ele seja gerado pelo movimento de metais (como ferro e níquel) em estado de fusão, existentes no núcleo externo do planeta. Esse material líquido está em constante movimento, o que gera o campo magnético ao redor da Terra, fazendo com que o planeta se comporte como um grande ímã.
Por causa disso, a Terra apresenta polos magnéticos, que ficam próximos – mas não exatamente nos mesmos lugares –dos polos geográficos. O polo sul magnético está perto do Polo Norte geográfico, e o polo norte magnético está perto do Polo Sul geográfico.
A agulha da bússola, que é imantada, é influenciada pelo campo magnético terrestre. Ela gira até se alinhar: o polo norte magnético da agulha sempre aponta para o polo sul magnético da Terra, que está localizado próximo ao Polo Norte geográfico.
Em outro experimento, os estudantes esfregaram o mesmo lado de um ímã várias vezes em uma agulha de metal. Depois, perceberam que a agulha começou a se comportar como um ímã e atrair alguns objetos de metal, ou seja, adquiriu propriedades magnéticas. Isso acontece porque os ímãs podem transformar certos objetos metálicos em ímãs. Esse processo é chamado imantação
Ao passarem pelo processo de imantação, as agulhas das bússolas se alinham na direção norte-sul, tornando possível que os seres humanos se localizem por meio dessa indicação.

O MAGNETISMO DA TERRA
A Terra também apresenta propriedades magnéticas. Assim como um ímã, o planeta tem dois polos magnéticos: o polo norte magnético e o polo sul magnético. São essas propriedades magnéticas que fazem a agulha se alinhar na direção norte-sul.
Contudo, é importante entender que os polos norte e sul magnéticos não estão exatamente no mesmo lugar dos polos Norte e Sul geográficos, que estudamos nos pontos cardeais e com o gnômon.
ATIVIDADES
Esta atividade permite que os estudantes visualizem a organização do campo magnético gerado por um ímã. Para realizá-la, separar os seguintes materiais: palha de aço em pó (que pode ser obtida fazendo cortes curtos em uma esponja de aço), folha de papel sulfite e ao menos um ímã.
Organizar a turma em grupos com cinco integrantes e preparar antecipadamente os materiais para a atividade experimental. Para realizá-la, solicitar aos estudantes
A ponta da agulha da bússola que aponta para o norte costuma vir marcada com uma cor diferente ou com a letra “N” para ajudar na identificação.
SISTEMA DE POSICIONAMENTO GLOBAL
(GPS)
Os instrumentos de orientação mais utilizados atualmente costumam usar o Sistema de Posicionamento Global, conhecido pela sigla GPS (do inglês, Global Positioning System). Esse sistema informa, com boa precisão, a posição de um aparelho em qualquer lugar do planeta. Com base nas posições indicadas pelo GPS, os aparelhos ou aplicativos que o utilizam podem ajudar as pessoas a traçar caminhos e encontrar rotas para diferentes destinos.
O GPS pode ser usado em aparelhos como celulares, tablets e computadores, além de veículos como carros, aviões e navios. Ele funciona por meio de sinais enviados e recebidos por satélites artificiais que giram em torno da Terra. Esses satélites são produzidos pelo ser humano para, entre outras funções, se comunicar com os aparelhos na Terra, o que possibilita indicar a localização pelo GPS com boa precisão.
Representação de satélites artificiais ao redor da Terra captando e enviando sinais ao celular de ciclista conectado ao GPS.

Elaborada com base em: SATELLITE Navigation – GPS – How It Works. Federal Aviation Administration, [s. l.], [20--?]. Disponível em: https://www.faa.gov/about/office_org/headquarters_ offices/ato/service_units/techops/navservices/gnss/gps/howitworks. Acesso em: 9 jul. 2025.
que espalhem a palha de aço em pó sobre uma folha de papel sulfite. Ao mover o ímã por baixo do papel, a limalha formará padrões que revelam o formato do campo magnético gerado pelo ímã. Essa experiência permitirá que os estudantes observem as linhas do campo magnético se estendendo desde os polos do ímã e a forma como elas se organizam. Ao final da atividade, sugere-se incentivar os estudantes a registrar no caderno suas observações, por meio de anotações ou desenhos, para documentar as descobertas e refletir sobre o que aprenderam.
No tópico Sistema de Posicionamento Global (GPS), promover uma conversa inicial com a turma e perguntar se já utilizaram algum aparelho com GPS e em que situações isso ocorreu. Estimular o compartilhamento de experiências cotidianas, como passeios ou viagens.
Destacar que, além de indicar posições geográficas, o GPS pode determinar a velocidade de objetos em movimento, como carros, bicicletas ou até mesmo pessoas caminhando ou correndo. Comentar suas múltiplas aplicações no cotidiano, na navegação terrestre, aérea e marítima, além do uso em esportes, serviços de entrega e monitoramento.
02/10/25 15:58

Campo magnético de um ímã evidenciado por meio do alinhamento de limalha de ferro sobre uma superfície.
IMAGENS FORA DE PROPORÇÃO AS CORES NÃO SÃO REAIS
ALEXARGOZINO
| ORIENTAÇÕES E RESPOSTAS
1. Orientar os estudantes a formar duplas para resolver as atividades propostas na página. O trabalho em duplas favorece a troca de ideias e a ampliação da compreensão sobre o conteúdo abordado.
a) O texto se refere ao GPS. Esse sistema funciona por meio de sinais enviados e recebidos por satélites artificiais que giram em torno da Terra.
b) Em dias nublados ou durante a noite, esse método de localização não pode ser utilizado.
2. b) Sim. Para funcionar, a agulha da bússola precisa ser imantada, processo no qual ela adquire propriedades magnéticas e passa a se comportar como um ímã.
ATIVIDADES
Propor aos estudantes que, organizados em duplas, pesquisem o astrolábio, outro instrumento de orientação que foi muito utilizado ao longo da história. Reforçar que para pesquisas na internet eles devem estar acompanhados de um adulto. As duplas devem pesquisar como ele foi desenvolvido, qual é sua função e de que forma contribuiu para a orientação no tempo e no espaço. Orientar as duplas a registrar as informações obtidas na pesquisa para produzir uma narrativa, incluindo personagens que utilizem o instrumento em uma situação prática, valorizando a criatividade e o uso correto das informações pesquisadas.
Para finalizar a proposta, organizar uma apresentação oral das narrativas criadas pelas duplas, desenvolvendo o trabalho com a competência geral 4.
ATIVIDADES
1. Leia o texto a seguir para responder às questões. Hoje em dia praticamente todos os aviões e navios que cruzam os oceanos [...] têm um equipamento que permite ao piloto saber sua localização no mapa a todo instante. [...]
Durante milênios os seres humanos viajaram de um lugar a outro usando marcos geográficos (montanhas, rios, etc.), o Sol e as estrelas para se orientar. […] No entanto, nem sempre fazer isso era uma coisa fácil. Por exemplo, o céu podia estar nublado por muito tempo, dificultando ver […] a posição exata do Sol. Por isso não era muito fácil navegar no mar longe do litoral, porque o barco podia facilmente se perder e ir parar muito longe. […]
PIMENTEL, Beto. Como chegar lá sem se perder. Ciência Hoje das Crianças, Rio de Janeiro, c2025. Disponível em: https://chc.org.br/coluna/como-chegar-la-sem-se-perder/. Acesso em: 9 jul. 2025.
Consultar orientações e respostas no Livro do Professor
a) A que equipamento, usado atualmente em aviões e navios, o texto se refere? Como ele funciona?
b) O texto menciona uma limitação de se localizar utilizando as posições do Sol no céu como referência. Qual é ela?
2. Observe os objetos a seguir.

REDKNAPPER/SHUTTERSTOCK.COM

a) Identifique os objetos 1 e 2 1 – ímã; 2 – bússola.
b) É correto dizer que, para funcionar, a agulha do objeto 2 precisa apresentar uma propriedade que o objeto 1 também apresenta? Justifique sua resposta.
Consultar orientações e resposta no Livro do Professor.
c) O que acontece com uma agulha de metal caso o objeto 1 seja esfregado sobre ela em uma mesma direção? Como se chama esse processo? A agulha adquire propriedades magnéticas. Esse processo é chamado de imantação.
Esta atividade oportuniza a integração com Língua Portuguesa, ao propor a produção de uma narrativa. Além disso, pode constituir parte da avaliação do aprendizado dos estudantes sobre instrumentos de orientação.
NÃO ESCREVA NO LIVRO.
IMAGENS
VOCÊ
CIENTISTA!
Bússola caseira
Se você tivesse um ímã e um clipe de metal, seria possível fazer uma bússola caseira? Em grupos, conversem sobre suas ideias iniciais e as anotem no caderno. Depois, façam a atividade a seguir.
DO QUE EU PRECISO
• 2 pedaços de cortiça, em formato similar ao de uma moeda.
• 2 clipes de metal
• 2 bacias com água
• Ímã
• Fita adesiva
• Caneta marcadora
COMO FAZER
1. O professor deve abrir os clipes de metal, deixando reta uma de suas pontas, conforme a representação.
ATENÇÃO!
Os clipes de metal devem ser manuseados com cuidado para evitar acidentes.

Representação do procedimento 1
2. Com cuidado, esfreguem o ímã na ponta aberta de um dos clipes por cerca de 2 minutos. Esse processo deve ser feito sempre no mesmo sentido, da base em direção à extremidade, como representado a seguir. O outro clipe não deve ser esfregado no ímã.

VOCÊ CIENTISTA!
Os objetivos da atividade prática proposta compreendem construir um aparato que funcione como uma bússola caseira; utilizar o aparato construído para identificar a direção dos pontos cardeais; e comparar os resultados obtidos com os do gnômon construído anteriormente. Esta atividade proporciona, assim, o exercício da habilidade EF04CI10. Também contribui para o desenvolvimento da competência geral 2, relacionada ao pensamento científico, crítico e criativo,
Representação do procedimento 2
rolha. Cada lâmina deve ter cerca de 1 centímetro de altura e, se possível, uma superfície com no mínimo 5 centímetros de diâmetro, para garantir maior estabilidade durante a montagem.
Antes de iniciar a atividade, explicar detalhadamente os objetivos do experimento, os procedimentos que devem ser realizados e as regras de segurança, reforçando a importância do trabalho em equipe e da escuta respeitosa.
A fim de evitar acidentes, vale destacar que o procedimento 1 deve ser realizado exclusivamente pelo professor. Além disso, os estudantes devem ser alertados quanto ao manuseio do clipe de metal aberto, reforçando os cuidados necessários para garantir a segurança durante a atividade.
Para a imantação do clipe, orientar os estudantes a esfregar, sempre no mesmo sentido, apenas um dos polos do ímã. Para facilitar, o clipe pode ser posicionado sobre a superfície de uma mesa durante o processo de imantação.
02/10/25 15:58
e da competência específica 2 de Ciências da Natureza, ao estimular a participação em práticas investigativas e a compreensão dos fenômenos naturais por meio da experimentação. Além disso, é possível trabalhar o Tema Contemporâneo Transversal (TCT) Ciência e tecnologia por meio da investigação dos mecanismos responsáveis pelo funcionamento de um aparato tecnológico, como a bússola.
Providenciar duas lâminas de cortiça, obtidas pelo corte transversal de uma
IMAGENS FORA DE PROPORÇÃO
AS CORES NÃO SÃO REAIS
ALEXARGOZINO
Ainda na seção Você cientista! , sugere-se orientar a turma a elaborar uma ficha de registro em folha de papel sulfite, conforme o modelo proposto a seguir, para registrar a atividade experimental e seus resultados. Escrever a ficha na lousa para que todos os estudantes possam copiá-la e preenchê-la de forma individual ou em grupo. Solicitar a entrega dos registros ao final da aula, podendo esta atividade ser utilizada como instrumento de avaliação da aprendizagem.
Nome: Data:
Materiais utilizados:
O que foi observado em cada aparato?
Para que direção o clipe de metal de cada aparato apontou?
( ) Norte ( ) Sul ( ) Leste ( ) Oeste
O que você aprendeu com esta atividade?
Após a discussão coletiva, estabelecer um tempo para que os estudantes resolvam as atividades propostas e registrem suas respostas no caderno. Destaca-se que, para realizar a atividade 5, é preciso recuperar o experimento realizado na seção Você cientista! das páginas 118 e 119.
| ORIENTAÇÕES E RESPOSTAS
1. Resposta pessoal. Espera-se que os estudantes tenham observado que o pedaço de rolha que contém o clipe imantado girou até se alinhar em uma posição estável. A parte imantada do clipe aponta sempre para a mesma direção (a direção norte). Já
3. Fixem cada clipe de papel em um pedaço da rolha usando fita adesiva. Certifiquem-se de fixar cada clipe bem no centro.
4. Com a caneta, identifiquem o pedaço de rolha no qual foi fixado o clipe de metal que foi esfregado no ímã.
3. A agulha foi construída a partir da imantação de um clipe de metal. Orientar os estudantes a retomar suas ideias iniciais e compará-las ao aparato construído que funciona como uma bússola, identificando semelhanças e diferenças entre eles.

Representação dos procedimentos 3 e 4
5. Posicionem, com cuidado, cada pedaço de rolha em uma das bacias com água. Os clipes devem ficar para cima. Observem o que acontece.
4. Resposta pessoal. Espera-se que os estudantes reconheçam que o clipe imantado se alinha na direção norte-sul. Para identificar qual das extremidades do clipe aponta para o norte, é possível que eles utilizem o corpo para
localizar essa direção, de forma aproximada. No caso, ao apontar o braço direito para o local onde o Sol “nasce”, estarão indicando aproximadamente a direção leste; o braço esquerdo indicará aproximadamente a direção oeste; à frente estará o norte;

Representação do procedimento 5
e, atrás, o sul. Após identificarem onde fica a direção norte, de forma aproximada, podem marcar com a caneta a extremidade do clipe que também aponta nessa direção.
VAMOS CONVERSAR?
1. O que vocês observaram no fim do experimento?
Consultar orientações e resposta no Livro do Professor.
2. Qual dos dois aparatos construídos funciona como uma bússola? Explique sua resposta.
Consultar orientações e resposta no Livro do Professor.
3. Como a agulha da bússola caseira foi construída? A maneira como ela foi feita ficou parecida com o que vocês haviam planejado inicialmente?
4. Como você poderia marcar a extremidade do clipe que aponta para o norte?
5. Com cuidado, levem o aparato que funciona como uma bússola até o local da escola onde foi construído o gnômon descrito nas páginas 118 e 119. Comparem a indicação dos pontos cardeais de cada instrumento. Essas indicações são similares ou diferentes?
Consultar orientações e resposta no Livro do Professor
o pedaço com o clipe não imantado pode ter flutuado aleatoriamente, girado ou se estabilizado de forma imprevisível, sem seguir uma orientação fixa.
2. O aparato com o clipe imantado funciona como uma bússola. Isso ocorre porque o clipe, ao ser esfregado no ímã, adquiriu propriedades magnéticas. Dessa forma, ele passou a interagir com as propriedades magnéticas da Terra, alinhando-se na direção norte-sul (assim, comporta-se como a agulha de uma bússola).
5. As indicações devem ser similares, já que tanto o gnômon quanto a bússola
podem ser utilizados como instrumentos de orientação, possibilitando a identificação dos pontos cardeais. No entanto, é preciso enfatizar que podem ocorrer pequenas variações, pois os polos magnéticos, que orientam a bússola, não estão exatamente no mesmo lugar do Polo Norte geográfico e do Polo Sul geográfico, indicados pelo gnômon. Além disso, pode haver imprecisões na construção ou no posicionamento dos instrumentos. O trabalho com esta atividade possibilita a mobilização da habilidade EF04CI10.
IMAGENS FORA DE PROPORÇÃO AS CORES NÃO SÃO REAIS
ALEX ARGOZINO
ALEXARGOZINO
MOVIMENTOS DA TERRA E DA LUA
Leia o poema a seguir e responda às questões.
Um dia, a dona Lua
Disse pro senhor Sol:
— Se o dia fosse noite, Seria mais legal.
E o Sol, muito exausto, Disse à Lua:
— É mesmo, Trabalhar todo dia, Me deixa muito cansado.
O Sol e a Lua
Até que o Sol com a Lua
Fez um trato:
— Eu trabalho de noite e você Trabalha de dia.
E a Lua respondeu:
— Que alegria!
Até que o dia virou noite
E a noite virou dia!
[…]
SANTANA, Jamila Mafra Sena de. O Sol e a Lua. In: SANTANA, Jamila Mafra Sena de. Viagem no espaço e a máquina do tempo. Rio de Janeiro: Quártica Editora, 2010.
IMAGENS FORA DE PROPORÇÃO.
AS CORES NÃO SÃO REAIS.
4. Não. O Sol sempre ilumina a Terra durante o dia. No entanto, a Lua pode ser vista no céu à noite e, dependendo de sua fase, pode também ser vista no céu de dia. Representações do Sol e da Lua no céu.
Assim como é feito no poema apresentado, costuma-se associar o dia ao Sol e a noite à Lua; no entanto, a Lua também pode ser vista durante o dia, dependendo da fase em que se encontra. Essa é uma oportunidade para explorar com os estudantes a liberdade poética e artística, destacando como a arte pode se apropriar de elementos da natureza para expressar sentimentos, ideias e metáforas, ainda que nem sempre reflita a realidade.
A atividade com o poema propicia a integração com Língua Portuguesa, ao estimular o trabalho com rimas, e auxilia o desenvolvimento das habilidades desse componente indicadas a seguir.
1. Que trato o Sol fez com a Lua?
O Sol combinou com a Lua que ele trabalharia de noite e a Lua de dia.
2. Com base na leitura, explique como o dia virou noite e a noite virou dia.
Na história, o dia virou noite e a noite virou dia porque o Sol e a Lua trocaram de lugar: o Sol passou a brilhar à noite e a Lua passou a aparecer de dia.
3. Em quais momentos do dia conseguimos ver o Sol no céu? E a Lua?
Consultar orientações e respostas no Livro do Professor
4. Pensando na resposta à questão anterior, o acordo feito entre o Sol e a Lua no poema representa o que acontece de verdade no céu? Por quê?
5. Estudamos que o Sol parece se movimentar no céu ao longo do dia. Para você, por que isso acontece? Resposta pessoal. Utilizar esse questionamento para avaliar o conhecimento prévio dos estudantes sobre a rotação da Terra. Não é esperado que eles saibam responder corretamente, mas que pensem sobre o assunto e exponham suas percepções iniciais.
ENCAMINHAMENTO
Realizar a leitura coletiva do poema proposto, incentivando os estudantes a prestar atenção nos versos que se relacionam aos movimentos do planeta Terra e da Lua. Estimular a escuta atenta, a identificação de rimas e a compreensão do conteúdo apresentado em linguagem poética.
Após a leitura, propor uma conversa com a turma para levantar os conhecimentos prévios sobre o que causa a ocorrência do dia e da noite e do ciclo lunar.
Estimular a formulação de hipóteses com perguntas como:
02/10/25 15:58
• O planeta está parado ou se movimenta no Universo? E a Lua?
• O aspecto da Lua no céu é sempre o mesmo?
Aproveitar esse momento para relacionar os conteúdos do poema aos conceitos científicos que serão aprofundados neste capítulo, valorizando a linguagem artística como ponto de partida para a construção do conhecimento.
• EF35LP23: Apreciar poemas e outros textos versificados, observando rimas, aliterações e diferentes modos de divisão dos versos, estrofes e refrões e seu efeito de sentido.
• EF35LP27: Ler e compreender, com certa autonomia, textos em versos, explorando rimas, sons e jogos de palavras, imagens poéticas (sentidos figurados) e recursos visuais e sonoros.
| ORIENTAÇÕES E RESPOSTA
3. Espera-se que os estudantes citem que o Sol é visível durante o dia, momento em que ilumina o céu. Já a Lua pode ser vista tanto à noite quanto durante o dia, dependendo de sua fase. Esta atividade retoma a habilidade EF03CI08 , relacionada à identificação dos períodos em que o Sol, a Lua e outros astros estão visíveis no céu.
NÃO ESCREVA NO LIVRO.
ENCAMINHAMENTO
O tópico Rotação da Terra, explorado nesta página, bem como os tópicos seguintes – Translação da Terra e Ciclo da Lua –, fornecem subsídios teóricos para o desenvolvimento da habilidade EF04CI11, pois discorrem sobre os movimentos cíclicos do planeta Terra e da Lua.
Apresentar à turma a ideia de que a Terra está em constante movimento, mesmo que não seja possível perceber isso diretamente. Introduzir o conceito de rotação da Terra, explicando que esse movimento dura aproximadamente 23 horas, 56 minutos e 4 segundos, o que equivale a um dia. Destacar que esse movimento é responsável pela alternância entre o dia e a noite.
Explicar que a duração da fase clara do dia depende do tempo em que determinado local permanece exposto à luz solar, enquanto a noite corresponde ao período em que esse local está voltado para o lado oposto ao Sol. Relacionar essas variações à posição do observador durante a rotação da Terra e ao fato de que nem todos os locais do planeta recebem a mesma quantidade de luz ao longo do dia.
ROTAÇÃO DA TERRA
A Terra realiza diversos movimentos. Neste momento, vamos estudar um deles, chamado rotação. Esse movimento é o giro que a Terra faz em torno de si mesma. Ele acontece sempre no mesmo sentido, ao redor de um eixo imaginário, uma linha imaginária que atravessa o planeta do Polo Norte ao Polo Sul.
Esse movimento dura cerca de 24 horas, ou seja, a Terra leva cerca de um dia para completar uma volta ao redor do próprio eixo.
Os dias e as noites existem por causa da rotação da Terra. Enquanto a Terra gira em torno de seu eixo imaginário, partes diferentes dela ficam voltadas para o Sol. Quando uma região da Terra está voltada para o Sol, é dia nessa região. Conforme a Terra continua girando, essa região vai deixando de receber luz solar e a noite começa.

eixo imaginário de
Por causa da rotação do planeta, vemos o Sol mudar de posição no céu todos os dias, o que passa a impressão de que é o Sol que está se movendo. Esse movimento aparente ocorre ao longo do dia da direção leste para a oeste. Na verdade, quem está se movimentando é a Terra. Por isso, chamamos o movimento do Sol no céu de aparente
| PARA O PROFESSOR
ARTIGO. SANTOS, Ana Caroline Gonçalves Gomes dos; MACHADO, Vera de Mattos. Atividades de investigação no ensino de Astronomia: sequência didática sobre os movimentos e inclinação do eixo da Terra nos Anos Iniciais do Ensino Fundamental. Vidya, Santa Maria, v. 41, n. 2, p. 115-131,
jul./dez., 2021. Disponível em: https:// periodicos.ufn.edu.br/index.php/VIDYA/ article/view/3852/2852. Acesso em: 21 ago. 2025.
Artigo sobre o uso de atividades investigativas para o ensino de conteúdos de Astronomia nos Anos Iniciais do Ensino Fundamental, especialmente no 4o ano.
Elaborada com base em: MORAES, Paulo R.; CAMPANHA, Vilma A. O planeta. São Paulo: Harbra, 1996.
Representação do movimento de rotação da Terra.
IMAGENS FORA DE PROPORÇÃO. AS CORES NÃO SÃO REAIS. sentido de rotação
Sol Terra
rotação
VOCÊ
CIENTISTA!
Modelo
de rotação
da Terra
Se você tivesse de construir um modelo para representar o movimento de rotação da Terra e a ocorrência dos dias e das noites, como você o faria? Em grupos, conversem entre si e anotem suas ideias no caderno. Depois, façam a atividade a seguir.
DO QUE EU PRECISO
• Bola de plástico • Caneta marcadora • Lanterna
COMO FAZER
1. Marquem dois pontos (A e B) em lados opostos da bola de plástico.
2. Coloquem a bola de plástico apoiada sobre uma mesa.
3. Um estudante segura a lanterna, a cerca de 1 passo da bola.
4. Apaguem as luzes da sala e acendam a
e B, que representam observadores na Terra, nos momentos em que cada um deles fica na área iluminada (dia) e na área em sombra (noite).
Organizar uma roda de conversa ao final da atividade, convidando os estudantes a compartilhar as observações feitas.
TEXTO DE APOIO [...]
5. Um estudante gira a bola devagar até dar uma volta completa em torno de si mesma.
6. Observem o que acontece com os pontos

VAMOS CONVERSAR?
O uso de modelos didáticos nas aulas costuma promover uma visão mais integradora do conteúdo, tornando a aula mais dinâmica e participativa, o que contribui para a aprendizagem significativa dos alunos.






















Representação do procedimento 5
2. À medida que a bola de plástico girava, os pontos foram iluminados pela luz da lanterna em momentos diferentes. Quando o ponto A estava sendo iluminado pela luz da lanterna, o ponto B estava no escuro e o contrário também acontece. Esse resultado mostra a relação entre o movimento de rotação da Terra e a alternância entre dias e noites: à medida que a Terra gira, diferentes regiões recebem luz solar em momentos distintos.
1. No modelo construído nesta atividade, o que a bola de plástico representa? E a lanterna? A bola de plástico representa a Terra, e a lanterna, o Sol.
2. O que ocorreu com os pontos A e B à medida que a bola de plástico girava? Existe uma relação entre esse resultado e a ocorrência dos dias e das noites?
3. O modelo construído foi parecido ou diferente da ideia inicial do grupo?
Resposta pessoal. Espera-se que os estudantes comparem suas ideias iniciais com o modelo construído, reconhecendo semelhanças e diferenças. Se possível, permitir que construam os modelos idealizados inicialmente e que verifiquem sua funcionalidade em representar a rotação da Terra.
VOCÊ CIENTISTA!
O objetivo desta atividade é construir um modelo simples que represente a rotação da Terra e a passagem dos dias e das noites.
Organizar previamente todos os materiais necessários para que todos os grupos realizem a atividade experimental, garantindo que haja bolas de plástico, lanternas e espaço suficiente para a movimentação dos grupos. Escolher um ambiente apropriado, preferencialmente com pouca iluminação, assegurando condições
de segurança, conforto e visibilidade para todos os estudantes.
02/10/25 15:58
Dividir a turma em grupos de aproximadamente cinco integrantes, incentivando a cooperação, a escuta ativa e a divisão equilibrada de tarefas.
Orientar os grupos a posicionar a bola plástica no centro de seu espaço de trabalho e a utilizar a lanterna como fonte de luz representando o Sol. Pedir a cada grupo que gire a bola lentamente, observando a alternância entre áreas iluminadas e áreas em sombra. Chamar a atenção para a observação dos pontos A
A aprendizagem significativa se concretiza ao passo em que uma nova informação de conhecimento específico se remete ao conhecimento prévio do aluno, ou seja, esse novo conhecimento incorporado é assimilado quando tem significado para o estudante, ao se relacionar com uma estrutura já existente [...].
LIMA, Rita de Cássia Gonçalves de et al. A importância dos modelos didáticos tridimensionais para o ensino de Ciências. Brazilian Journal of Development, Curitiba, v. 6, n. 8, p. 61684-61694, ago. 2020. Disponível em: https:// ojs.brazilianjournals.com.br/ ojs/index.php/BRJD/article/ view/15544/12786. Acesso em: 21 ago. 2025.
IMAGENS FORA DE PROPORÇÃO AS CORES NÃO SÃO REAIS
ALEX ARGOZINO
Orientar a realização de uma roda de conversa inicial com a turma para levantar os conhecimentos prévios da turma sobre as estações do ano, incentivando o relato de experiências pessoais relacionadas às mudanças na temperatura ambiente, na frequência de chuvas, nas paisagens, nas roupas utilizadas e na duração dos dias em diferentes épocas do ano.
Na sequência, apresentar o movimento de translação da Terra, explicando que ele corresponde ao percurso elíptico que o planeta realiza ao redor do Sol, com duração aproximada de 365 dias e 6 horas.
Embora a órbita da Terra não seja perfeitamente circular, as estações do ano não são causadas pela maior ou menor proximidade da Terra em relação ao Sol, mas sim pela inclinação do eixo imaginário da Terra, que se mantém constante durante esse movimento.
Essa inclinação provoca a variação da intensidade e da duração da luz solar em diferentes regiões do planeta ao longo do ano, resultando nas estações.
Se considerar pertinente, realizar uma demonstração do movimento de translação da Terra utilizando um globo terrestre ou os mesmos materiais da atividade prática da seção Você cientista! da página 131.
Para a demonstração, desenhar uma linha na bola que represente a linha do equador e identificar os dois hemisférios. Então, inclinar a bola ligeiramente, mantendo-a assim durante todo o movimento. Em seguida, com a lanterna fixa em um ponto central (projetando a luz para cima), movimentar a bola em torno dela.
TRANSLAÇÃO DA TERRA
Outro movimento realizado pela Terra é o de translação. A translação é o movimento que a Terra faz ao redor do Sol. Esse movimento dura cerca de 365 dias e 6 horas. Isso significa que o planeta leva mais ou menos um ano para dar uma volta completa ao redor do Sol.




Elaborada com base em: SARAIVA, Maria de Fátima O.; OLIVEIRA FILHO, Kepler de S.; MÜLLER, Alexei M. Aula 3: movimento anual do Sol e estações do ano. Porto Alegre: UFRGS, 2012. p. 3. Disponível em: http://www.if.ufrgs.br/~fatima/fis2010/Aula3-141.pdf. Acesso em: 10 jul. 2025.
A translação da Terra, em conjunto com a inclinação de seu eixo, ajuda a explicar a ocorrência das estações do ano. Ao longo do ano, a inclinação do eixo faz diferentes partes do planeta receberem mais ou menos luz e calor do Sol. Durante o verão, a região recebe mais luz e calor, os dias são mais longos (há mais horas de luz) e as temperaturas costumam ser mais altas. Já no inverno, a região recebe menos luz e calor, os dias são mais curtos (há menos horas de luz) e as temperaturas tendem a ser mais baixas.
Durante o percurso, os estudantes devem observar qual hemisfério está mais inclinado em direção à luz da lanterna e recebe, portanto, maior incidência de luz. Esse procedimento colabora para a compreensão de porque, em determinados momentos do ano, um dos hemisférios está mais iluminado (verão), enquanto o outro recebe menos luz (inverno). A atividade também permite identificar os momentos em que a luz incide de forma mais equilibrada sobre os dois hemisférios, caracterizando as estações do outono e da primavera.
Representação do movimento de translação da Terra. A imagem representa quatro momentos diferentes desse movimento ao longo do ano.
sentido de rotação
Sol Terra
IMAGENS FORA DE PROPORÇÃO.
CICLO DA LUA
Assim como a Terra, a Lua não tem luz própria. O que vemos brilhando no céu é a luz do Sol refletida na superfície dela.
A Lua também realiza movimentos. Ela gira em torno de si mesma e ao redor da Terra. A combinação desses movimentos, com a posição da Terra, da Lua e do Sol, faz com que vejamos a Lua de formas diferentes no céu. Essas diferentes formas são chamadas de fases da Lua.
As fases principais da Lua são: nova, quarto crescente, cheia e quarto minguante.
O ciclo da Lua, ou seja, o tempo para que ela tenha a mesma aparência no céu novamente, dura cerca de 29 dias. A cada 7 dias, ocorre uma das quatro fases principais da Lua.
Na fase de lua nova, não conseguimos ver a Lua no céu. Observe as imagens a seguir, que mostram como vemos a Lua no céu nas outras fases.



ENCAMINHAMENTO
Retomar com os estudantes que a Lua é um astro iluminado, ou seja, reflete a luz do Sol. Relembrar também o que é um astro luminoso: aquele que tem luz própria, como o Sol e outras estrelas.
Ao iniciar o estudo do ciclo da Lua, explicar que, ao longo do mês, é possível observar diferentes fases lunares e que elas seguem um ciclo regular e previsível.
Abordar as quatro principais fases da Lua (nova, quarto crescente, cheia e quarto minguante), ressaltar que essas fases resultam da posição relativa entre a Lua,
PARA VOCÊ EXPLORAR
Converse com o professor sobre a possibilidade de visitar um observatório ou um planetário. Nesses locais, você pode conhecer mais sobre os movimentos da Terra e da Lua, além de outras curiosidades sobre o Universo.
ângulos de iluminação que resultam nas diferentes fases lunares. Verificar com antecedência se existe um planetário ou observatório astronômico no município onde a escola está localizada, ou na região, para realizar a visita proposta no boxe Para você explorar. Para a visita, é importante obter previamente as autorizações dos responsáveis e da diretoria da escola, organizar o transporte e tomar todas as medidas de segurança pertinentes e possíveis. Orientar os estudantes sobre como se comportar durante o passeio, de modo a garantir a segurança deles e evitar transtornos aos profissionais e outras pessoas do local, além de indicar vestuário apropriado e a necessidade de uso de protetor solar, caso fiquem em áreas abertas, entre outras medidas. Se não for possível a visita presencial, buscar alternativas virtuais oferecidas por esses espaços (geralmente, associados a universidades e institutos de pesquisa) para explorá-las em conjunto com os estudantes.
| PARA O PROFESSOR
02/10/25 15:58
a Terra e o Sol e que o modo como se vê a Lua da Terra depende da porção da face da Lua voltada para o planeta Terra que está iluminada pelo Sol. Explicar que não é possível ver a lua nova no céu, pois, nesse momento, o lado da Lua voltado para a Terra não está sendo iluminado pelo Sol.
Relacionar os ciclos da Lua aos movimentos da Terra, explicando que a Lua gira ao redor de si mesma e da Terra, enquanto a Terra também se move ao redor de si mesma e do Sol. Destacar que esses movimentos determinam os
TEXTO. COUTINHO, Juliana Ferreira Bêta; RUST, Naiara Miranda. O ensino das fases da Lua por meio da literatura para alunos com deficiência visual nos Anos Iniciais. Revista Educação Especial, Santa Maria, v. 38, 2025. Disponível em: https://periodicos.ufsm.br/ educacaoespecial/article/ view/85305/67393. Acesso em: 21 ago. 2025. O artigo traz uma proposta de ensino sobre as fases da Lua voltada à inclusão de estudantes com deficiência visual nos Anos Iniciais do Ensino Fundamental, especificamente no 4o ano, por meio de uma sequência didática que articula conceitos científicos com a literatura infantil.
O tópico O calendário colabora para o desenvolvimento da habilidade EF04CI11. Apresentar aos estudantes o conceito de calendário como um sistema criado para organizar a passagem do tempo, facilitando o planejamento das atividades humanas. Explicar que o calendário gregoriano é o modelo utilizado na maior parte do mundo atualmente.
O calendário gregoriano foi criado para corrigir discrepâncias do calendário juliano, anteriormente adotado, e alinhar melhor o ano civil com o ano solar, ou seja, com o tempo que a Terra leva para completar uma volta ao redor do Sol.
| PARA O PROFESSOR
TEXTO. VEIGA, Edison. Calendário gregoriano: como papa Gregório 13 mudou contagem dos dias há 440 anos. BBC News Brasil, 5 mar. 2022. Disponível em: https://www.bbc.com/por tuguese/geral-60496904. Acesso em: 21 ago. 2025. A reportagem traz informações mais detalhadas sobre a origem do calendário gregoriano e as regras estipuladas para o ano bissexto.
O CALENDÁRIO
Diferentes culturas, ao longo do tempo, criaram diversos tipos de calendário. O calendário utilizado atualmente no Brasil e em diversos países do mundo se chama calendário gregoriano, desenvolvido em 1582. Nesse calendário, a duração de um ano está relacionada ao movimento da Terra ao redor do Sol, isto é, à translação.
Como estudamos, esse movimento dura cerca de 365 dias e 6 horas. Para compensar essas horas excedentes, a cada quatro anos adiciona-se um dia ao calendário, no mês de fevereiro. Nesses casos, o ano fica com 366 dias e é chamado de ano bissexto.
O calendário é organizado em dias, semanas, meses e anos, sendo que:
• Um dia tem 24 horas.
• Uma semana tem 7 dias.
• Um mês tem de 28 a 31 dias, e o ano é dividido em 12 meses.
• Um ano tem 365 dias. Quando é bissexto, o ano tem 366 dias.
Observe a seguir o calendário gregoriano do ano de 2027.
JANEIRO
DSTQQS S DSTQQS S
DSTQQS S DSTQQS S
DSTQQS S DSTQQS S DSTQQS S DSTQQS S
DSTQQS S DSTQQS S DSTQQS S DSTQQS S
Representação do calendário do ano de 2027.
JANEIRO ABRIL
DIALOGANDO
Qual seria o problema se não existisse o ano bissexto? Converse com um colega sobre o assunto.
Consultar orientações e resposta no Livro do Professor
ATIVIDADES
1. Joana estava conversando com os colegas sobre algumas atividades que havia planejado fazer com sua família. Leia as falas de Joana a seguir.
Hoje pela manhã, eu estudarei bastante, para que à noite eu e minha família possamos brincar com meu novo quebra-cabeça.
Daqui a um ano, eu e minha família planejamos viajar para visitar meus tios que moram em outro estado.
• As falas de Joana estão relacionadas à passagem do tempo, que, por sua vez, pode ser explicada pelos movimentos da Terra. Identifique a qual movimento da Terra o tempo associado a cada uma das falas está relacionado e justifique sua resposta.
Consultar orientações e resposta no Livro do Professor
2. Por que o movimento que vemos o Sol fazer no céu todos os dias, da direção leste para a oeste, é chamado de movimento aparente?
Consultar orientações e resposta no Livro do Professor.
3. Observe as imagens a seguir, que representam desenhos de diferentes fases da Lua. Depois, analise as afirmativas sobre as imagens e copie a correta no caderno.



a) Imagem 1: lua nova. Imagem 2: lua cheia. Imagem 3: lua quarto minguante. Todas essas fases, mais a fase da lua crescente, acontecem em 29 dias.
b) Imagem 1: lua quarto minguante. Imagem 2: lua cheia. Imagem 3: lua crescente. Todas essas fases, mais a fase da lua nova, acontecem em 29 dias.
c) Imagem 1: lua crescente. Imagem 2: lua cheia. Imagem 3: lua quarto minguante. Todas essas fases, mais a fase da lua nova, acontecem em 29 dias.
A afirmativa correta é a c. Consultar orientações no Livro do Professor
| ORIENTAÇÕES E RESPOSTA
Dialogando
Resposta pessoal. Espera-se que os estudantes digam que a falta do ano bissexto comprometeria o calendário. Ele ficaria desajustado em relação ao movimento da Terra ao redor do Sol. Com o passar dos anos, os meses passariam a acontecer um pouco depois, alterando completamente a marcação do tempo em função do movimento da Terra. Verificar se os estudantes percebem que, com o tempo, as estações do ano poderiam
mudar de lugar no calendário. Com base nisso, questionar o que poderia acontecer: por exemplo, o verão poderia começar em outro mês, e as datas de festas e colheitas precisariam ser ajustadas.
os períodos de luz (dia) e de escuridão (noite). Como Joana menciona atividades feitas pela manhã e planos para o período da noite, sua fala está diretamente ligada à passagem do tempo ao longo de um dia, ou seja, à rotação da Terra. A fala B está relacionada ao movimento de translação da Terra. Esse movimento corresponde ao percurso que a Terra faz ao redor do Sol, com duração de cerca de 365 dias, correspondente a um ano. Como Joana fala sobre planos para “daqui a um ano”, sua fala está relacionada à translação, pois se refere à passagem do tempo ao longo de um ano completo.
2. Porque quem está se movimentando é a Terra, e não o Sol. A Terra gira em torno do próprio eixo. Assim, para alguém na superfície da Terra, a rotação faz parecer que o Sol se move no céu.
3. Durante a realização desta atividade, verificar se os estudantes reconhecem as quatro principais fases da Lua: nova, quarto crescente (imagem 1), cheia (imagem 2) e quarto minguante (imagem 3), lembrando que a lua nova não é visível no céu. Avaliar se compreendem a duração do ciclo lunar, que é de aproximadamente 29 dias, ou seja, o tempo necessário para que a Lua tenha a mesma aparência no céu novamente.
15:58
| ORIENTAÇÕES E RESPOSTAS
Atividades
1. A fala A está relacionada à rotação da Terra. Esse movimento consiste no giro da Terra em torno de si mesma, com duração de cerca de 24 horas (um dia). É ele que determina a alternância entre
NÃO ESCREVA NO LIVRO.
Fala A
Fala B
4. c) Esta atividade oportuniza a mobilização da habilidade EF04CI11, pois o estudante pode relacionar os movimentos cíclicos da Terra à construção do calendário.
VOCÊ ESCRITOR!
Solicitar a cada estudante que desenhe, em uma folha de cartolina, o calendário completo do mês seguinte, incluindo os dias da semana e os números correspondentes a cada dia. Para isso, orientar a construção em formato de tabela, garantindo espaço suficiente em cada quadrado para fazer anotações.
Orientar o preenchimento de cada dia com a programação pessoal prevista, como horários de estudo, momentos de lazer, brincadeiras, passeios, feriados, aniversários, eventos escolares ou outros compromissos especiais. Enfatizar a importância de perceber a frequência dessas atividades: trata-se de um evento único, semanal, quinzenal ou mensal? Essa análise pode ser feita com o auxílio dos familiares.
Estimular a criatividade na construção do calendário, incentivando o uso de cores, desenhos, símbolos ou legendas para representar diferentes tipos de atividade. Ressaltar que não existe um único modelo correto, mas que a organização é fundamental.
Finalizar com uma roda de conversa para compartilhar os calendários produzidos, trocar ideias sobre organização pessoal e valorizar a diversidade de rotinas entre os colegas. Se julgar oportuno, pode ser proposta uma breve reflexão sobre a utilidade de calendários para o planejamento e o equilíbrio entre responsabilidades e momentos de lazer.
4. Observe a agenda de Bruno e responda às questões no caderno.
IMAGENS FORA DE PROPORÇÃO
AS CORES NÃO SÃO REAIS

Representação de página da agenda de Bruno.
a) Em que dia da semana ocorrerão os jogos de Laura? Aos sábados.
b) Qual dos compromissos de Bruno acontece todas as semanas? Em qual dia da semana ele ocorre? Aula de música, que ocorre às quartas-feiras.
c) Na agenda de Bruno, há o registro de uma data que se repete somente uma vez por ano. Que data é essa? A ocorrência dessa data pode ser relacionada à mesma duração de um dos movimentos da Terra? Se sim, explique qual deles.
O aniversário do pai de Bruno. A ocorrência dessa data pode ser relacionada ao movimento de translação da Terra, que é o movimento que a Terra realiza ao redor do Sol. Esse movimento tem duração de aproximadamente 365 dias e define a passagem de um ano. Por isso, pode ser associado à repetição anual de datas como aniversários.
Consultar orientações no Livro do Professor
Com a ajuda de um adulto da família, desenhe em uma folha de papel avulsa o calendário do próximo mês. Preencha cada dia com a programação de suas atividades para o mês indicado, relacionadas a estudos, brincadeiras, passeios, aniversários, compromissos especiais e outras atividades que quiser anotar. Depois, compartilhe seus planos com os colegas e conheça os planos deles.
Resposta pessoal. Orientar os estudantes a solicitar a ajuda dos familiares para registrar as atividades do próximo mês.
NÃO ESCREVA NO LIVRO.
Diferentes calendários
Os movimentos dos astros acontecem de forma regular, isto é, cíclica. Por isso eles serviram de referência para a construção de diversos calendários ao longo da história. O calendário gregoriano, por exemplo, é um calendário solar, pois baseia-se no movimento de translação da Terra ao redor do Sol.
Leia os trechos a seguir e conheça outros dois tipos de calendário usados por diferentes culturas.
IMAGENS FORA DE PROPORÇÃO
AS CORES NÃO SÃO REAIS
[…]
Representação do Sol no céu diurno.
1. A regularidade do movimento dos astros no céu possibilitou a marcação da passagem do tempo por diferentes culturas. Com base nessas observações, foram desenvolvidos diversos tipos de calendário ao longo da história.
Calendários lunares
Utilizam as fases da Lua para contar a passagem do tempo. Os meses duram, em média, 29,5 dias começando e terminando a cada ciclo completo da Lua. […]
O calendário islâmico é um exemplo. […]
[…]
Calendários lunissolares
Utilizam os ciclos do Sol e da Lua para a passagem dos anos. O exemplo mais conhecido é o calendário chinês. Não é utilizado oficialmente na China há mais de 100 anos, mas têm importância cultural no país […].
[…]
Representação do Sol no céu noturno.
SOBRAL, Clara; ZANLORENSSI, Gabriel; HEMERLY, Giovanna. Como funcionam os diferentes tipos de calendários existentes. Nexo Jornal, [s. l.], 10 jan. 2025. Disponível em: https://www. nexojornal.com.br/grafico/2025/01/10/como-funcionam-os-diferentes-tipos-de-calendarios.
Acesso em: 10 jul. 2025.
1. De que forma os astros serviram de base para o desenvolvimento de diferentes calendários ao longo da história?
NÃO ESCREVA NO LIVRO.
2. Com a ajuda do professor, pesquise um calendário utilizado por outra cultura, considerando:
Consultar orientações e respostas no Livro do Professor
• Em qual região ele é (ou foi) utilizado?
• Esse calendário é solar, lunar ou lunissolar?
• Ele ainda é usado atualmente? Em quais situações?
VOCÊ LEITOR!
O conteúdo desta seção colabora para o desenvolvimento da habilidade
EF04CI11, relacionada à associação entre movimentos cíclicos da Terra e da Lua e a construção de calendários por diferentes culturas.
Realizar a leitura do texto da página com a turma, explicando que o calendário é uma construção cultural e histórica e que diferentes povos adotam diferentes formas de organizar o tempo.
Para orientar a reflexão e, ao mesmo tempo, ajudar no desenvolvimento do Tema Contemporâneo Transversal (TCT) Diversidade cultural, fazer questionamentos, como:
• Por que nem todos os povos adotam o mesmo calendário?
• O que um calendário pode nos contar sobre a cultura de um povo?
• Qual é a importância de conhecer outros sistemas de contagem do tempo?
| ORIENTAÇÕES E | RESPOSTAS
2. Resposta pessoal. O objetivo desta atividade é que, com o auxílio do professor ou de outro adulto, os estudantes conheçam diferentes formas de registro da contagem e da marcação do tempo, considerando os movimentos cíclicos dos astros. Por exemplo, o calendário islâmico é do tipo lunar, com ano comum de 354 dias, e 12 meses com duração entre 29 e 30 dias. Nos anos bissextos, que totalizam 355 dias, acrescenta-se um dia a um dos meses de 29 dias. Esse calendário é adotado em países muçulmanos, como a Arábia Saudita, para fins religiosos, influenciando a vida cultural e social. Já para os registros civis, esses países também utilizam o calendário gregoriano.
02/10/25 15:58
Se julgar pertinente, é possível acessar o link do texto apresentado e explorar o mapa interativo, observando os países que utilizam exclusivamente o calendário gregoriano e aqueles que adotam outros calendários, seja como principal, seja como complementar. Analisar o mapa coletivamente, localizando os países em que o calendário gregoriano não é o único em uso. Discutir o que isso revela sobre aspectos culturais, religiosos e históricos dessas sociedades.
A pesquisa sugerida contempla a habilidade de Língua Portuguesa indicada a seguir.
• EF35LP17: Buscar e selecionar, com o apoio do professor, informações de interesse sobre fenômenos sociais e naturais, em textos que circulam em meios impressos ou digitais.
GEOGRAFIA
Esta seção desenvolve o trabalho integrado aos componentes curriculares de História e Geografia, articulando os Temas Contemporâneos Transversais (TCTs) Diversidade cultural e Educação para valorização do multiculturalismo nas matrizes históricas e culturais brasileiras, ao abordar como a passagem do tempo e as atividades diárias de comunidades indígenas brasileiras são influenciadas pelos astros. Além disso, amplia o desenvolvimento da habilidade EF04CI11, ao explorar os calendários de diferentes culturas e suas relações com fenômenos astronômicos.
Sugere-se realizar a leitura do texto com os estudantes. Durante a leitura, comentar a importância dos astros para a organização das atividades cotidianas, rituais e modos de vida dos povos indígenas citados.
Mais informações sobre os rituais indígenas citados podem ser encontradas nos materiais indicados em Para o professor. No boxe, também há materiais complementares sobre a forma que outros povos indígenas organizam a passagem do tempo.
| ORIENTAÇÕES E RESPOSTAS
Estas atividades incentivam os estudantes a reconhecer e a valorizar formas distintas de organização do tempo presentes nas culturas indígenas, como nos calendários Pataxó e Suyá. Essa abordagem permite compreender como componentes naturais, como a Lua, orientam a vida cotidiana desses povos, atendendo à habilidade de Geografia indicada a
DIALOGANDO HISTÓRIA E GEOGRAFIA COM
O TEMPO DA NATUREZA
Os primeiros grupos humanos organizavam a vida com base na observação da natureza: o dia é seguido da noite, as marés sobem e descem constantemente, as folhas se desenvolvem e caem, e assim por diante. Por isso, dizemos que eles se guiavam pelo tempo da natureza.
Ainda hoje, há grupos humanos que organizam a vida com base nos fenômenos naturais. Os indígenas Pataxó, que vivem em Minas Gerais e na Bahia, são exemplos de grupos humanos que organizam suas atividades pelo tempo da natureza, seguindo, por exemplo, as fases da Lua. Leia os trechos a seguir.
[…]
Na lua nova nós ainda tiramos madeiras e plantamos algumas plantas, porque os bichos e insetos ainda não têm poder de enxergar e furar a raiz, as sementes e as madeiras, pois está escuro. É nesta lua que a gente caça e arma as armadilhas.
[…]
[…] No tempo da lua cheia a gente não planta, porque os frutos ficam bichados, não arma as armadilhas, porque as caças enxergam longe. […]
PROFESSORES e alunos indígenas Pataxó da aldeia Muã Mimatxi. A nossa crença com a Vovó Lua Belo Horizonte: Literaterras – FALE/UFMG, 2012. p. 11, 23.
Os Pataxó usam um calendário próprio. Veja como eles marcam os meses do ano.
Representação de alguns componentes da natureza.
O povo Pataxó e suas histórias
Janeiro – Mês de preparo de solo para feijão.
Fevereiro – Mês da planta do feijão.
Março – Mês da capina.
Abril – Mês da festa do awê.
Maio – Colheita do milho.
Junho – Mês do frio.
Julho – Mês de curso dos professores indígenas.
Agosto – Mês de volta às aulas.
Setembro – Mês de preparo de solo para o milho.
Outubro – Mês da planta do milho.
Novembro – Mês das águas.
Dezembro – Mês da manga […].
ARARIBY et al O povo Pataxó e suas histórias. São Paulo: Global, 2002. p. 25.
seguir, ao destacar a contribuição dessas culturas para a formação da identidade brasileira.
• EF04GE01: Selecionar, em seus lugares de vivência e em suas histórias familiares e/ou da comunidade, elementos de distintas culturas (indígenas, afro-brasileiras, de outras regiões do país, latino-americanas, europeias, asiáticas etc.), valorizando o que é próprio em cada uma delas e sua contribuição para a formação da cultura local, regional e brasileira.
1. De acordo com o texto, os Pataxó se baseiam nas fases da Lua para realizar
IMAGENS FORA DE PROPORÇÃO AS CORES NÃO SÃO REAIS.
ARTNLERA/SHUTTERSTOCK.COM
certas atividades do cotidiano. Durante a lua nova, fase em que a Lua não está visível no céu, eles caçam, armam armadilhas, cortam madeira e plantam, pois, como as noites são mais escuras, os insetos e animais não enxergam bem e não prejudicam as sementes, raízes ou madeiras. Já na lua cheia, fase em que a face da Lua voltada para a Terra está completamente iluminada, eles evitam essas atividades, pois o ambiente está mais iluminado e os animais enxergam melhor, o que dificulta a caça, e os frutos tendem a ser atacados por insetos, prejudicando o plantio.
Acompanhe agora como outro povo indígena, o Suyá, que vive no Parque Indígena do Xingu, em Mato Grosso, organiza suas atividades ao longo do ano.
IMAGENS FORA DE PROPORÇÃO
AS CORES NÃO SÃO REAIS

Janeiro: Colheita do milho.
Fevereiro: Mês do rio cheio.
Março: Época do abacaxi.
Abril: Mês da pescaria.
Maio: Época da derrubada da mata para o plantio.
Junho: Tempo de gaivota.
Julho: Mês que o tracajá (tartaruga) bota ovo.
Agosto: Festa Kuarup.
Setembro: Plantio da mandioca.
Outubro: Época do pequi.
Novembro: Início do verão.
Dezembro: Mês da melancia.
Representação do calendário indígena do povo Suyá.
Consultar orientações e respostas no Livro do Professor
1. De acordo com o texto, qual é a relação entre as atividades cotidianas dos Pataxó e as fases da Lua?
2. Compare os calendários Pataxó e Suyá e copie o quadro a seguir no caderno, completando as informações dos meses de fevereiro a dezembro, seguindo janeiro como modelo.
Janeiro Preparo do solo para o feijão. Colheita do milho.
Fevereiro
Março
Abril
Maio
Junho
Julho
Agosto
Setembro
Outubro
Novembro
Dezembro
2. Pataxó
Janeiro: Preparo do solo para o feijão; Fevereiro: Plantio do feijão; Março: Capina; Abril: Festa do awê; Maio: Colheita do milho; Junho: Frio; Julho: Curso dos professores indígenas; Agosto: Volta às aulas; Setembro: Preparo do solo para o milho; Outubro: Plantio do milho; Novembro: Águas; Dezembro: Manga.
Suyá
Janeiro: Milho; Fevereiro: Peixes; Março: Abacaxi; Abril: Pescaria; Maio: Derrubada da mata; Junho: Tempo de gaivota; Julho: Tracajá bota ovo; Agosto: Festa Kuarup;
Setembro: Plantio de mandioca; Outubro: Pequi; Novembro: Verão; Dezembro: Melancia.
02/10/25 15:58
Esta atividade contribui para o trabalho com diferenças e semelhanças, bloco conceitual da maior importância em História. Na medida em que possibilita ao estudante compreender que alguns povos – a exemplo dos Pataxó e dos Suyá – continuam organizando sua vida com base nos fenômenos naturais, nos dias atuais, pode colaborar também para o desenvolvimento da habilidade desse componente indicada a seguir.
•
EF04H101: Reconhecer a história como resultado da ação do ser humano no tempo e no espaço, com base na identificação de mudanças e permanências ao longo do tempo.
| PARA O PROFESSOR
SITE . POVOS Indígenas no Brasil. Disponível em: https://pib.socioambien tal.org/pt/Povo:Patax% C3%B3. Acesso em: 3 set. 2025.
Site com informações sobre o modo de vida e a cultura dos indígenas Pataxó, incluindo detalhes sobre o ritual do awê.
TEXTO. BRASIL. Ministérios dos Povos Indígenas. Fundação Nacional dos Povos Indígenas. Ritual do Kuarup reforça laços familiares e culturais dos indígenas do Xingu. Gov.br, 26 out. 2022. Disponível em: https://www.gov. br/funai/pt-br/assuntos/ noticias/2022-02/ritual -do-kuarup-reforca-lacos -familiares-e-culturais-dos -indigenas-do-xingu. Acesso em: 3 set. 2025.
Texto com informações sobre o ritual do Kuarup, realizado por diferentes povos indígenas do Parque do Xingu, localizado em Mato Grosso.
LIVRO. SCARAMUZZI, Igor et al . (org.). Livro dos marcadores do tempo : pesquisas indígenas sobre percepções ambientais e mudanças do clima. Oiapoque; São Paulo: Iepé Oiapoque, 2023. Disponível em: https://institu toiepe.org.br/wp-content/ uploads/2023/09/Livro -dos-Marcadores-do-Tem po-1.pdf. Acesso em: 20 ago. 2025.
O livro reúne marcadores do tempo que orientam a vida dos povos indígenas do Oiapoque.
Pataxó
Suyá
NÃO ESCREVA NO LIVRO.
ORGANIZANDO
IDEIAS
Esta seção apresenta um esquema visual que articula os principais conceitos estudados nesta unidade. Para iniciar a aula, sugere-se resgatar com a turma os principais conceitos abordados, como: pontos cardeais, movimento aparente do Sol, gnômon, instrumentos de orientação (bússola e GPS), magnetismo, rotação, translação e ciclo da Lua. Registrar esses conceitos na lousa, organizando-os em uma lista.
Em seguida, convidar os estudantes a propor conexões entre os conceitos, promovendo uma construção coletiva de um esquema na lousa. Incentivá-los a justificar as conexões propostas, de modo a avaliar o próprio aprendizado. Orientar os estudantes a copiar o esquema nos cadernos e a personalizá-lo com cores, símbolos e elementos visuais que auxiliem na organização das informações.
Ao final, propor a análise do esquema apresentado no Livro do Estudante e a comparação com o esquema elaborado em sala de aula, avaliando as semelhanças e diferenças que eles percebem.
Esta atividade favorece a compreensão integrada dos temas estudados, o desenvolvimento da capacidade de síntese, a estruturação lógica do pensamento e o estímulo ao pensamento crítico, contribuindo para uma aprendizagem mais significativa.
RETOMANDO
Esta seção tem como propósito a retomada dos conteúdos estudados na unidade. Também propicia ao docente a avalição do aprendizado dos estudantes.
ORGANIZANDO IDEIAS
Nesta unidade, estudamos sobre a observação dos astros para a localização no espaço e para a contagem do tempo. Analise o esquema a seguir para relembrar esses assuntos.
OBSERVAÇÃO DO CÉU
possibilita
LOCALIZAR-SE NO ESPAÇO
a partir dos
PONTOS CARDEAIS
para saber suas
GPS
BÚSSOLA GNÔMON
A avaliação da aprendizagem é uma etapa importante, pois possibilita acompanhar o desenvolvimento da turma, ajudando a reconhecer progressos e a identificar eventuais desafios de aprendizagem. Com base nisso, fazer os devidos ajustes no planejamento e nas estratégias pedagógicas, de modo a atender melhor às necessidades dos estudantes. Listas de atividades são apenas um dos instrumentos avaliativos que podem ser utilizados nesse processo. Ao longo deste Livro do Professor, outras sugestões foram apresentadas em diferentes
CALENDÁRIOS
CONTAR A PASSAGEM DO TEMPO organizada em a partir dos MOVIMENTOS DOS ASTROS como
TRANSLAÇÃO DA TERRA CICLO DA LUA
ROTAÇÃO DA TERRA
momentos das orientações específicas. Outros instrumentos também podem ser consultados na página XXIX da Parte Geral deste Livro do Professor Garantir que os estudantes tenham tempo suficiente para realizar as tarefas de forma individual, favorecendo a concentração e a autonomia no processo. Na sequência, organizar uma roda de conversa para que os estudantes possam partilhar seus pontos de vista, promovendo o diálogo, a escuta ativa e a construção coletiva do conhecimento.
IMAGENS FORA DE PROPORÇÃO.
AS CORES NÃO SÃO REAIS.
RETOMANDO
1 Analise a fotografia para responder às questões.
Consultar orientações e
respostas no Livro do Professor.
a) Considere que essa fotografia tenha sido tirada logo ao amanhecer, quando o Sol “está nascendo”. Nesse caso, seria possível encontrar aproximadamente as direções norte, sul, leste e oeste sem o uso de instrumentos? Justifique sua resposta.

b) Nesta unidade, você estudou instrumentos que ajudam a identificar a direção dos pontos cardeais. Cite um desses instrumentos e explique como ele pode ser utilizado para essa finalidade.
2 O texto a seguir contém símbolos no lugar de algumas palavras. Utilize as palavras dos quadros para substituir corretamente cada símbolo.
★ = rotação.
❤ = dia.
✿ = translação.
❂ = ano.
A Terra realiza alguns movimentos. Um deles, chamado ★, compreende um giro ao redor do próprio eixo. A duração desse movimento é de cerca de um ❤. A Terra também realiza uma trajetória ao redor do Sol, movimento chamado ✿. Sua duração é de cerca de um ❂.
3 Observe a aparência da Lua que Cecília viu em determinada noite.
a) Qual fase da Lua foi observada por Cecília nessa noite?
b) Após alguns dias, Cecília observou novamente a Lua. Desenhe no caderno como ela teria visto a Lua e qual é o nome dessa próxima fase. Depois, responda: A cada quantos dias ocorre cada uma das quatro fases principais da Lua?

Consultar orientações e resposta no Livro do Professor
141
02/10/25 15:58
1. a) Sim. Como a fotografia foi tirada logo ao amanhecer, o Sol “está nascendo” na direção leste e, assim, a sombra da pessoa está projetada para o lado oposto ao Sol, ou seja, para a direção oeste. Assim, é possível estender o braço direito para o leste e o braço esquerdo para o oeste. A frente estará voltada para o norte e as costas para o sul.
b) Resposta pessoal. Os estudantes podem citar a bússola e o gnômon. A bússola funciona com base nas propriedades magnéticas da Terra. Sua agulha é imantada e gira livremente, alinhando-se à direção norte-sul. Assim, ao observar a direção indicada pela agulha, é possível identificar o norte e, a partir dele, os demais pontos cardeais. Já o gnômon é um instrumento que possibilita registrar as mudanças de sua sombra com base no movimento aparente do Sol. Ao observar a sombra produzida pelo gnômon no início da manhã e no final da tarde, é possível traçar uma linha leste-oeste. A partir dessa linha, também é possível determinar os demais pontos cardeais.
Esta atividade recupera conteúdos trabalhados durante a abordagem das habilidades EF04CI09 e EF04CI10.
3. b) Espera-se que o estudante responda lua quarto minguante e desenhe seu formato no caderno. Cada fase principal da Lua ocorre aproximadamente a cada sete dias.
Esta atividade recupera conteúdos trabalhados durante a abordagem da habilidade EF04CI11.
NÃO ESCREVA NO LIVRO.
Pessoa caminhando no Largo de São Sebastião, em Manaus (AM), 2025.
Lua vista em Santa Maria (RS), 2021.
Lua cheia.
O QUE
APRENDEMOS
Esta seção contribui para a avaliação do aprendizado consolidado pelos estudantes ao longo do ano letivo. Para desenvolvê-la, sugere-se orientá-los a realizar as atividades individualmente, registrando as respostas no caderno. Ao final, convidar a turma a compartilhar suas respostas oralmente, promovendo uma discussão coletiva. Alternativamente, é possível solicitar que as respostas sejam registradas e entregues em uma folha de papel sulfite, de modo que possam ser utilizadas como parte do processo avaliativo.
| ORIENTAÇÕES E RESPOSTAS
1. Nesta atividade, é mobilizada a habilidade EF04CI07, ao solicitar ao estudante que reconheça a participação de microrganismos na produção de alimentos.
2. c) Porque nesse período podem ocorrer alagamentos que facilitam a dispersão da urina de ratos infectada.
d) Resposta pessoal. Os estudantes podem citar, por exemplo: não andar descalço ou sem proteção em áreas alagadas; usar botas e luvas ao fazer limpezas após alagamentos; manter os lixos tampados para não atrair roedores. Ao requerer que os estudantes proponham medidas de prevenção da doença, a atividade favorece a mobilização da habilidade EF04CI08
Ao trabalhar a atividade, se considerar oportuno, estimular a reflexão sobre o descarte inadequado de resíduos, trabalhando o Tema Contemporâneo Transversal (TCT) Educação ambiental.
3. b) As gramíneas usam a energia da luz solar na
O QUE APRENDEMOS
1. Os microrganismos são utilizados na fabricação de queijos. Nesse processo, certos tipos de bactérias realizam a fermentação do leite, transformando-o em queijo. Consultar orientações no Livro do Professor
1 Observe a fotografia.
• De que forma os microrganismos se relacionam ao alimento presente nessa imagem?
Queijo minas frescal, um queijo típico do estado de Minas Gerais.

2 Leia o título da notícia a seguir e responda às questões.
Período de chuvas reforça alerta contra Leptospirose em Natal
PERÍODO de chuvas reforça alerta contra Leptospirose em Natal. Prefeitura de Natal, Natal, 5 jun. 2024. Disponível em: https://natal.rn.gov.br/news/post2/41105. Acesso em: 5 ago. 2025.
Consultar orientações no Livro do Professor
a) Que doença é citada nesse título de notícia?
b) Como essa doença é transmitida?
Leptospirose.
A leptospirose é transmitida principalmente pelo contato com água contaminada pela urina de ratos infectados.
c) Por que o período de chuvas levanta alertas sobre essa doença?
d) Considerando suas respostas aos itens b e c, proponha medidas que podem ser adotadas para a prevenção dessa doença.
2. c) e d) Consultar orientações e respostas no Livro do Professor
3 Analise a cadeia alimentar a seguir para responder às questões.



Representação de uma cadeia alimentar, em que os decompositores não estão ilustrados.
a) Classifique os seres vivos representados nessa cadeia alimentar em produtor ou consumidor.
A gramínea é um produtor, e a capivara e a onça-pintada são seres consumidores.
b) Explique como a energia chega até a onça-pintada, passando pelos seres vivos dessa cadeia alimentar. Inicie sua explicação pela luz solar.
Consultar orientações e respostas no Livro do Professor
produção do próprio alimento por meio da fotossíntese. Quando a capivara se alimenta das gramíneas, ela recebe parte dessa energia. A onça-pintada, ao se alimentar da capivara, também recebe parte da energia. A cada transferência, uma parte da energia é usada pelos seres vivos e outra parte se perde em forma de calor. Por isso, a energia vai diminuindo ao longo da cadeia alimentar e o fluxo de energia segue em um único sentido – do Sol até o último consumidor.
Espera-se que os estudantes reconheçam a posição ocupada pelos seres vivos
na cadeia alimentar apresentada, identificando os produtores e os consumidores. Também é esperado que eles expliquem como cada organismo contribui para a transferência de energia, reconhecendo o papel desempenhado pelo Sol como fonte primária de energia. Assim, poderão mobilizar a habilidade EF04CI04
NÃO ESCREVA NO LIVRO.
Gramínea Capivara
Onça-pintada
GABRIEL
4 Analise as imagens a seguir para responder às questões.




Consultar orientações e respostas no Livro do Professor.
a) As mudanças representadas em 1 e 2 foram ocasionadas por qual fator: aquecimento, resfriamento, luz ou umidade? Justifique sua resposta.
b) A mudança representada em 1 é reversível ou irreversível? Justifique sua resposta.
c) A mudança representada em 2 é reversível ou irreversível? Justifique sua resposta.
5 As frases a seguir apresentam diferentes formas de se identificar as direções norte, sul, leste e oeste. Copie-as no caderno e corrija as falsas.
Consultar orientações e respostas no Livro do Professor.
a) Ao estender o braço direito para a direção onde o Sol “nasce”, e o braço esquerdo para a direção onde o Sol “se põe”, você estará de frente para o sul.
b) A sombra projetada pela manhã por um gnômon aponta para o lado oeste, pois o Sol está no leste.
c) A agulha da bússola se alinha na direção norte-sul da Terra. Ela apresenta marcações que ajudam a identificar para onde é o norte e para onde é o sul. A direção norte apontada pela bússola é exatamente o Norte geográfico da Terra.
6 Aline nasceu no dia 29 de fevereiro de 2016. Contudo, ela costuma comemorar seu aniversário no dia 28 de fevereiro. Por que ela faz isso? Em sua explicação utilize o termo translação.
Consultar orientações e resposta no Livro do Professor
4. a) Aquecimento. Na imagem 1, o gelo derreteu e virou água ao ser deixado à temperatura ambiente. Na imagem 2, o macarrão ficou cozido porque foi aquecido pela água quente.
b) A mudança representada em 1 é reversível, pois a água líquida pode virar gelo de novo se for colocada no congelador.
c) A mudança representada em 2 é irreversível, pois, depois de cozido, o macarrão não volta a ser cru. Não é possível desfazer o cozimento de alimentos.
Esta atividade possibilita a mobilização das habilidades EF04CI02 e EF04CI03 ao propor a análise de uma sequência de imagens que representam transformações dos materiais em função do aquecimento. Espera-se que os estudantes reconheçam mudanças reversíveis e irreversíveis.
5. a) Falsa. Ao estender o braço direito para a direção onde o Sol “nasce”, e o braço esquerdo para a direção onde o Sol “se põe”, você estará de frente para o norte.
b) Verdadeira.
c) Falsa. A agulha da bússola se alinha na direção norte-sul da Terra. Ela apresenta marcações que ajudam a identificar para onde é o norte e para onde é o sul. Contudo, a direção norte apontada pela bússola não é exatamente a mesma do norte geográfico da Terra. Ela aponta para o sul magnético, que fica próximo ao norte geográfico.
Nesta atividade, os estudantes podem resgatar a identificação das direções associadas aos pontos cardeais por meio da análise da projeção de sombras de um gnômon, temática relacionada à habilidade EF04CI09.
6. Aline nasceu em um ano bissexto, que acontece a cada quatro anos. Só nesses anos o mês de fevereiro tem 29 dias. Nos outros anos, fevereiro termina no dia 28. Por isso, para comemorar seu aniversário, Aline escolhe o dia 28 de fevereiro, que acontece todos os anos. O ano bissexto existe devido ao movimento de translação da Terra. Nesse movimento, nosso planeta leva 365 dias e algumas horas para completar a volta ao redor do Sol. Essas horas vão se acumulando, e, a cada quatro anos, somam quase um dia inteiro. Para compensar isso, é acrescentado um dia no mês de fevereiro em alguns anos.
Esta atividade permite o desenvolvimento da habilidade EF04CI11 ao promover a relação entre a periodicidade dos movimentos da Terra e a organização de calendários.
NÃO ESCREVA NO LIVRO.
Macarrão antes e após o cozimento.
Copo com cubos de gelo e copo com água líquida.
IMAGENS FORA DE PROPORÇÃO.
REFERÊNCIAS BIBLIOGRÁFICAS
COMENTADAS
ATKINS, Peter; JONES, Loretta; LAVERMAN, Leroy. Princípios de Química: questionando a vida moderna e o ambiente. 7. ed. Porto Alegre: Bookman, 2018.
O livro aborda princípios de Química, como estados físicos da matéria e reações químicas. BIOMAS. Gov.br , [5 set. 2024]. Disponível em: https://www.gov.br/mma/pt-br/ assuntos/biodiversidade-e-biomas/biomas-e -ecossistemas/biomas. Acesso em: 6 ago. 2025. Nessa página do site do Ministério do Meio Ambiente, é possível acessar informações sobre os biomas brasileiros.
BROWN, Theodore L. et al. Química: a ciência central. 13. ed. São Paulo: Pearson Education do Brasil, 2016.
No livro, são abordados diversos assuntos relacionados à Química, entre eles, estados físicos da matéria, mudanças de estado físico, reações químicas, misturas e separação de misturas.
EVERT, Ray F.; EICHHORN, Susan E.; RAVEN, Peter H. Biologia vegetal. 8. ed. Rio de Janeiro: Guanabara Koogan, 2014.
No livro, são apresentadas as principais características anatômicas e os processos fisiológicos dos grupos de plantas, como a fotossíntese.
HALLIDAY, David; RESNICK, Robert; WALKER, Jearl. Fundamentos de Física: eletromagnetismo. 10. ed. Rio de Janeiro: LTC, 2016. v. 3. Nesse volume, são explorados os fundamentos do Eletromagnetismo, por meio de conceitos como magnetismo e campo magnético.
HICKMAN, Cleveland P. et al. Princípios integrados de zoologia. 16. ed. Rio de Janeiro: Guanabara Koogan, 2019. No livro, são apresentadas características anatômicas e fisiológicas dos grupos de animais invertebrados e vertebrados, como aspectos de sua alimentação.
MADIGAN, Michael T. et al Microbiologia de Brock. 14. ed. Porto Alegre: Artmed, 2016. O livro traz características dos vírus e de diversos grupos de microrganismos, destacando estrutura deles, os papéis ambientais, as aplicações na sociedade e as relações que estabelecem com a saúde humana, incluindo infecções e doenças.
MARCUSCHI, Luiz Antônio. Produção textual: análise de gêneros e compreensão. São Paulo: Parábola Editorial, 2008.
O autor aborda o uso da linguagem para produção e compreensão de textos no dia a dia e são analisados os diferentes gêneros e seus sentidos.
OLIVEIRA FILHO, Kepler de Souza; SARAIVA, Maria de Fátima Oliveira. Astronomia e astrofísica.
3. ed. São Paulo: Livraria da Física, 2014.
O livro trata de definições, características e fenômenos referentes aos astros, como seus movimentos aparentes.
PICAZZIO, Enos (ed.). O céu que nos envolve: introdução à astronomia para educadores e iniciantes. São Paulo: Odysseus, 2011.
No livro, são apresentados diversos aspectos dos principais astros visíveis no céu, além de abordar o uso do gnômon como instrumento de observação astronômica.
REECE, Jane B. et al. Biologia de Campbell. 10. ed. Porto Alegre: Artmed, 2015.
O livro traz uma síntese abrangente e detalhada dos principais ramos da Biologia, como a Microbiologia, a Zoologia, a Botânica e a Ecologia.
RICKLEFS, Robert; RELYEA, Rick. A economia da natureza. 7. ed. Rio de Janeiro: Guanabara Koogan, 2016.
No livro, são abordados temas da Ecologia, entre eles, as relações alimentares entre os seres vivos nos ecossistemas, além do ciclo da matéria e o fluxo de energia nas cadeias alimentares.
TAIZ, Lincoln et al. Fisiologia e desenvolvimento vegetal. 6. ed. Porto Alegre: Artmed, 2017. Nesse livro, são detalhados os processos fisiológicos das plantas, como a fotossíntese.
TORTORA, Gerard J.; FUNKE, Berdell R.; CASE, Christine L. Microbiologia. 12. ed. Porto Alegre: Artmed, 2017.
O livro trata de assuntos relacionados à Microbiologia, como a microscopia e as principais características de vírus e dos diferentes grupos de microrganismos.
YOUNG, Hugh D.; FREEDMAN, Roger A. Física III: Eletromagnetismo. 14. ed. São Paulo: Pearson Education do Brasil, 2015.
Nesse livro, são explorados conceitos e fenômenos físicos do tema Eletromagnetismo, como magnetismo, campo magnético e funcionamento de uma bússola.
MATERIAL DE APOIO
AO PROFESSOR
Esta coleção para os Anos Iniciais do Ensino Fundamental tem alguns pilares de sustentação, que listamos a seguir.
1.ORIENTAÇÕES GERAIS
Neste tópico, são destacados aspectos relacionados à Base Nacional Comum Curricular (BNCC), abordando seus princípios, sua estrutura e organização. Também são enfatizadas questões referentes à alfabetização e ao ensino de Ciências.
1.1 A BNCC
A BNCC é um documento de caráter normativo que define o conjunto de aprendizagens essenciais a serem desenvolvidas ao longo da Educação Básica. Ela orienta políticas educacionais e subsidia a elaboração de currículos, conteúdos e materiais didáticos das redes e sistemas de ensino, visando garantir a equidade no processo formativo.
1.1.1 A LEGISLAÇÃO QUE DÁ SUPORTE À BNCC
A BNCC está respaldada em um conjunto de marcos legais. Um deles é a Constituição de 1988, que, em seu artigo 210, determina que “serão fixados conteúdos mínimos para o ensino fundamental, de maneira a assegurar formação básica comum e respeito aos valores culturais e artísticos, nacionais e regionais” (BRASIL, [Constituição (1988)]).
Outro marco é a Lei no 9.394, de 1996 – Lei de Diretrizes e Bases da Educação Nacional (LDB) –, que, no inciso IV de seu artigo 9o, determina:
A União incumbir-se-á de: [...] estabelecer, em colaboração com os Estados, o Distrito Federal e os Municípios, competências e diretrizes para a educação infantil, o ensino fundamental e o ensino médio, que nortearão os currículos e seus conteúdos mínimos, de modo a assegurar formação básica comum.
BRASIL. Lei no 9.394, de 20 de dezembro de 1996. Estabelece as diretrizes e bases da educação nacional. Brasília, DF: Presidência da República, 1996. Disponível em: http://www.planalto.gov.br/ccivil_03/leis/L9394.htm. Acesso em: 5 out. 2025.
A LDB determina também que as diretrizes são comuns, enquanto os currículos são diversos. Essa relação entre o básico-comum e o que é diverso está presente no artigo 26 da LDB:
Os currículos da educação infantil, do ensino fundamental e do ensino médio devem ter base nacional comum, a ser complementada, em cada sistema de ensino e em cada estabelecimento escolar, por uma parte diversificada, exigida pelas características regionais e locais da sociedade, da cultura, da economia e dos educandos.
BRASIL. Lei no 9.394, de 20 de dezembro de 1996. Estabelece as diretrizes e bases da educação nacional. Brasília, DF: Presidência da República, 1996. Disponível em: http://www.planalto.gov.br/ccivil_03/leis/L9394.htm. Acesso em: 5 out. 2025.
Disso decorre que o currículo a ser construído deve, então, ser contextualizado. Entendem-se por contextualização a inclusão e a valorização das diferenças regionais, ou mesmo locais, e oatendimento à diversidade cultural. Esses são os fundamentos das Diretrizes Curriculares Nacionais Gerais para a Educação Básica, de 2010, que estabeleceram marcos comuns para os Anos Iniciais do Ensino Fundamental e demais níveis do Ensino Básico, respaldadas na LDB.
Outro marco legal em que a BNCC se apoia é na Lei no 13.005, de 2014, que promulgou o Plano Nacional de Educação. Isso é coerente com o fato de que o foco da BNCC não é o ensino, mas a aprendizagem como estratégia para impulsionar a qualidade da Educação Básica em todas as etapas e modalidades.
1.1.2 A BNCC E A BUSCA POR EQUIDADE
A busca por equidade na educação demanda currículos diferenciados e afinados com as diferentes realidades do país. Na busca por equidade, leva-se em conta também a variedade de culturas constitutivas da identidade brasileira. Além disso, reconhecem-se a diversidade de experiências que os estudantes trazem para a escola e as diferentes maneiras que eles têm de aprender.
Na busca por equidade, pretende-se, ainda, incluir grupos minoritários, como indígenas, ciganos e quilombolas, e as pessoas que não tiveram a oportunidade de frequentar uma escola, além de estudantes com algum tipo de deficiência, reconhecendo a necessidade de práticas pedagógicas inclusivas, conforme estabelecido na Lei Brasileira de Inclusão da Pessoa com Deficiência (Lei no 13.146, de 2015).
1.1.3 A BNCC E OS CURRÍCULOS
A BNCC e os currículos estão alinhados com os marcos legais citados e têm papéis complementares. Para cumprirem tais papéis, na BNCC são propostas as seguintes ações:
• contextualizar os conteúdos dos componentes curriculares [...];
• decidir sobre formas de organização interdisciplinar dos componentes curriculares [...];
• selecionar e aplicar metodologias e estratégias didático-pedagógicas [...];
• conceber e pôr em prática situações e procedimentos para motivar e engajar os alunos nas aprendizagens;
• construir e aplicar procedimentos de avaliação formativa de processo ou de resultado [...];
• selecionar, produzir, aplicar e avaliar recursos didáticos e tecnológicos [...];
• criar e disponibilizar materiais de orientação para os professores [...];
• manter processos contínuos de aprendizagem sobre gestão pedagógica e curricular [...].
BRASIL. Ministério da Educação. Base Nacional Comum Curricular: educação é a base. Brasília, DF: MEC, 2018. p. 16-17. Disponível em: https://www.gov.br/mec/pt-br/escola-em-tempo-integral/BNCC_EI_EF_110518_ versaofinal.pdf. Acesso em: 5 out. 2025.
A implementação da BNCC deve levar em conta, então, os currículos elaborados por estados e municípios, bem como por escolas. No aspecto pedagógico, os conteúdos curriculares devem estar a serviço do desenvolvimento de competências (destacadas no tópico seguinte).
A elaboração de currículos com base em competências está presente em grande parte das reformas curriculares de diversos países. É essa também a abordagem adotada nas avaliações internacionais da Organização para a Cooperação e Desenvolvimento Econômico (OCDE), que coordena o Programa Internacional de Avaliação de Alunos (Pisa – sigla do termo em inglês Programme for International Student Assessment).
1.1.4 AS COMPETÊNCIAS PROPOSTAS PELA BNCC
Como destacado, ao longo de sua escolarização, os estudantes devem desenvolver competências. Competência pode ser entendida como a capacidade de utilizar o conhecimento em situações que requerem sua aplicação para tomar decisões pertinentes. Na BNCC, as competências são classificadas em gerais e específicas.
As competências gerais abrangem todas as áreas do conhecimento, objetivando a formação humana integral e a construção de uma sociedade mais justa, democrática e inclusiva. Na BNCC, estão definidas dez competências gerais, apresentadas a seguir.
1. Valorizar e utilizar os conhecimentos historicamente construídos sobre o mundo físico, social, cultural e digital para entender e explicar a realidade, continuar aprendendo e colaborar para a construção de uma sociedade justa, democrática e inclusiva.
2. Exercitar a curiosidade intelectual e recorrer à abordagem própria das ciências, incluindo a investigação, a reflexão, a análise crítica, a imaginação e a criatividade, para investigar causas, elaborar e testar hipóteses, formular e resolver problemas e criar soluções (inclusive tecnológicas) com base nos conhecimentos das diferentes áreas.
3. Valorizar e fruir as diversas manifestações artísticas e culturais, das locais às mundiais, e também participar de práticas diversificadas da produção artístico-cultural.
4. Utilizar diferentes linguagens – verbal (oral ou visual-motora, como Libras, e escrita), corporal, visual, sonora e digital –, bem como conhecimentos das linguagens artística, matemática e científica, para se expressar e partilhar informações, experiências, ideias e sentimentos em diferentes contextos e produzir sentidos que levem ao entendimento mútuo.
5. Compreender, utilizar e criar tecnologias digitais de informação e comunicação de forma crítica, significativa, reflexiva e ética nas diversas práticas sociais (incluindo as escolares) para se comunicar, acessar e disseminar informações, produzir conhecimentos, resolver problemas e exercer protagonismo e autoria na vida pessoal e coletiva.
6. Valorizar a diversidade de saberes e vivências culturais e apropriar-se de conhecimentos e experiências que lhe possibilitem entender as relações próprias do mundo do trabalho e fazer escolhas alinhadas ao exercício da cidadania e ao seu projeto de vida, com liberdade, autonomia, consciência crítica e responsabilidade.
7. Argumentar com base em fatos, dados e informações confiáveis, para formular, negociar e defender ideias, pontos de vista e decisões comuns que respeitem e promovam os direitos humanos, a consciência socioambiental e o consumo responsável em âmbito local, regional e global, com posicionamento ético em relação ao cuidado de si mesmo, dos outros e do planeta.
8. Conhecer-se, apreciar-se e cuidar de sua saúde física e emocional, compreendendo-se na diversidade humana e reconhecendo suas emoções e as dos outros, com autocrítica e capacidade para lidar com elas.
9. Exercitar a empatia, o diálogo, a resolução de conflitos e a cooperação, fazendo-se respeitar e promovendo o respeito ao outro e aos direitos humanos, com acolhimento e valorização da diversidade de indivíduos e de grupos sociais, seus saberes, identidades, culturas e potencialidades, sem preconceitos de qualquer natureza.
10. Agir pessoal e coletivamente com autonomia, responsabilidade, flexibilidade, resiliência e determinação, tomando decisões com base em princípios éticos, democráticos, inclusivos, sustentáveis e solidários.
BRASIL. Ministério da Educação. Base Nacional Comum Curricular: educação é a base. Brasília, DF: MEC, 2018. p. 9-10. Disponível em: https://www.gov.br/mec/pt-br/escola-em-tempo-integral/BNCC_EI_EF_110518_ versaofinal.pdf. Acesso em: 5 out. 2025.
As competências específicas, por sua vez, são próprias de cada área do conhecimento. As de Ciências da Natureza envolvem o incentivo ao interesse, à curiosidade científica dos estudantes, à investigação e à compreensão dos fenômenos naturais. Na BNCC, estão definidas oito competências específicas de Ciências da Natureza para o Ensino Fundamental, apresentadas a seguir.
1. Compreender as Ciências da Natureza como empreendimento humano, e o conhecimento científico como provisório, cultural e histórico.
2. Compreender conceitos fundamentais e estruturas explicativas das Ciências da Natureza, bem como dominar processos, práticas e procedimentos da investigação científica, de modo a sentir segurança no debate de questões científicas, tecnológicas, socioambientais e do
mundo do trabalho, continuar aprendendo e colaborar para a construção de uma sociedade justa, democrática e inclusiva.
3. Analisar, compreender e explicar características, fenômenos e processos relativos ao mundo natural, social e tecnológico (incluindo o digital), como também as relações que se estabelecem entre eles, exercitando a curiosidade para fazer perguntas, buscar respostas e criar soluções (inclusive tecnológicas) com base nos conhecimentos das Ciências da Natureza.
4. Avaliar aplicações e implicações políticas, socioambientais e culturais da ciência e de suas tecnologias para propor alternativas aos desafios do mundo contemporâneo, incluindo aqueles relativos ao mundo do trabalho.
5. Construir argumentos com base em dados, evidências e informações confiáveis e negociar e defender ideias e pontos de vista que promovam a consciência socioambiental e o respeito a si próprio e ao outro, acolhendo e valorizando a diversidade de indivíduos e de grupos sociais, sem preconceitos de qualquer natureza.
6. Utilizar diferentes linguagens e tecnologias digitais de informação e comunicação para se comunicar, acessar e disseminar informações, produzir conhecimentos e resolver problemas das Ciências da Natureza de forma crítica, significativa, reflexiva e ética.
7. Conhecer, apreciar e cuidar de si, do seu corpo e bem-estar, compreendendo-se na diversidade humana, fazendo-se respeitar e respeitando o outro, recorrendo aos conhecimentos das Ciências da Natureza e às suas tecnologias.
8. Agir pessoal e coletivamente com respeito, autonomia, responsabilidade, flexibilidade, resiliência e determinação, recorrendo aos conhecimentos das Ciências da Natureza para tomar decisões frente a questões científico-tecnológicas e socioambientais e a respeito da saúde individual e coletiva, com base em princípios éticos, democráticos, sustentáveis e solidários.
BRASIL. Ministério da Educação. Base Nacional Comum Curricular: educação é a base. Brasília, DF: MEC, 2018. p. 324. Disponível em: https://www.gov.br/mec/pt-br/escola-em-tempo-integral/BNCC_EI_EF_110518_ versaofinal.pdf. Acesso em: 5 out. 2025.
Para contribuir efetivamente para a formação de cidadãos críticos e participativos, tanto as competências gerais quanto as específicas devem ser desenvolvidas de maneira integrada e articulada ao longo do processo educativo.
1.1.5 AS HABILIDADES PROPOSTAS PELA BNCC
Além das competências, a BNCC apresenta habilidades que se espera que os estudantes desenvolvam em cada etapa da escolarização. As habilidades, pois, são expressas por verbos que indicam os processos cognitivos envolvidos, associadas aos objetos de conhecimento que devem ser adquiridos. Por exemplo, a habilidade EF03CI04 é a de:
Identificar características sobre o modo de vida (o que comem, como se reproduzem, como se deslocam etc.) dos animais mais comuns no ambiente próximo.
BRASIL. Ministério da Educação. Base Nacional Comum Curricular: educação é a base. Brasília, DF: MEC, 2018. p. 337. Disponível em: https://www.gov.br/mec/pt-br/escola-em-tempo-integral/BNCC_EI_EF_110518_ versaofinal.pdf. Acesso em: 5 out. 2025.
O processo cognitivo envolvido no desenvolvimento dessa habilidade é indicado pelo verbo “identificar”, e o objeto de conhecimento refere-se a “características e desenvolvimento dos animais”. Considera-se que os estudantes desenvolveram essa habilidade quando são capazes de observar animais do ambiente próximo e reconhecer tais características.
Essa e as demais habilidades são identificadas por códigos alfanuméricos, interpretados da seguinte forma:
• primeiro par de letras – indica a etapa da escolarização;
• primeiro par de números – indica o ano no qual a habilidade deve ser desenvolvida;
• segundo par de letras – indica o componente curricular;
• segundo par de números – indica a posição da habilidade na numeração sequencial daquele ano.
Portanto, o código EF03CI04 diz respeito à quarta habilidade de Ciências da Natureza a ser desenvolvida no 3o ano do Ensino Fundamental.
Outro aspecto relacionado às habilidades é: elas são organizadas em unidades temáticas. Em Ciências da Natureza há três unidades: Matéria e energia – trata da natureza da matéria, de suas transformações e do uso de recursos naturais e energéticos; Vida e evolução –envolve as características dos seres vivos, suas interações, os processos evolutivos e a conservação da biodiversidade; e Terra e Universo – envolve a exploração da composição, dos movimentos e dos fenômenos relacionados à Terra, à Lua, ao Sol e a outros corpos celestes.
Tendo explicitado essas informações, apresentam-se a seguir as habilidades da BNCC a serem desenvolvidas do 3o ao 5o anos do Ensino Fundamental, organizadas por ano e por unidade temática.
Matéria e energia
(EF03CI01) Produzir diferentes sons a partir da vibração de variados objetos e identificar variáveis que influem nesse fenômeno.
(EF03CI02) Experimentar e relatar o que ocorre com a passagem da luz através de objetos transparentes (copos, janelas de vidro, lentes, prismas, água etc.), no contato com superfícies polidas (espelhos) e na intersecção com objetos opacos (paredes, pratos, pessoas e outros objetos de uso cotidiano).
(EF03CI03) Discutir hábitos necessários para a manutenção da saúde auditiva e visual considerando as condições do ambiente em termos de som e luz.
Vida e evolução
(EF03CI04) Identificar características sobre o modo de vida (o que comem, como se reproduzem, como se deslocam etc.) dos animais mais comuns no ambiente próximo.
(EF03CI05) Descrever e comunicar as alterações que ocorrem desde o nascimento em animais de diferentes meios terrestres ou aquáticos, inclusive o homem.
(EF03CI06) Comparar alguns animais e organizar grupos com base em características externas comuns (presença de penas, pelos, escamas, bico, garras, antenas, patas etc.).
Terra e Universo
(EF03CI07) Identificar características da Terra (como seu formato esférico, a presença de água, solo etc.), com base na observação, manipulação e comparação de diferentes formas de representação do planeta (mapas, globos, fotografias etc.).
(EF03CI08) Observar, identificar e registrar os períodos diários (dia e/ou noite) em que o Sol, demais estrelas, Lua e planetas estão visíveis no céu.
(EF03CI09) Comparar diferentes amostras de solo do entorno da escola com base em características como cor, textura, cheiro, tamanho das partículas, permeabilidade etc.
(EF03CI10) Identificar os diferentes usos do solo (plantação e extração de materiais, dentre outras possibilidades), reconhecendo a importância do solo para a agricultura e para a vida.
Habilidades de Ciências da Natureza – 3o ano
Matéria e energia
Habilidades de Ciências da Natureza – 4o ano
(EF04CI01) Identificar misturas na vida diária, com base em suas propriedades físicas observáveis, reconhecendo sua composição.
(EF04CI02) Testar e relatar transformações nos materiais do dia a dia quando expostos a diferentes condições (aquecimento, resfriamento, luz e umidade).
(EF04CI03) Concluir que algumas mudanças causadas por aquecimento ou resfriamento são reversíveis (como as mudanças de estado físico da água) e outras não (como o cozimento do ovo, a queima do papel etc.).
Vida e evolução
Terra e Universo
(EF04CI04) Analisar e construir cadeias alimentares simples, reconhecendo a posição ocupada pelos seres vivos nessas cadeias e o papel do Sol como fonte primária de energia na produção de alimentos.
(EF04CI05) Descrever e destacar semelhanças e diferenças entre o ciclo da matéria e o fluxo de energia entre os componentes vivos e não vivos de um ecossistema.
(EF04CI06) Relacionar a participação de fungos e bactérias no processo de decomposição, reconhecendo a importância ambiental desse processo.
(EF04CI07) Verificar a participação de microrganismos na produção de alimentos, combustíveis, medicamentos, entre outros.
(EF04CI08) Propor, a partir do conhecimento das formas de transmissão de alguns microrganismos (vírus, bactérias e protozoários), atitudes e medidas adequadas para prevenção de doenças a eles associadas.
(EF04CI09) Identificar os pontos cardeais, com base no registro de diferentes posições relativas do Sol e da sombra de uma vara (gnômon).
(EF04CI10) Comparar as indicações dos pontos cardeais resultantes da observação das sombras de uma vara (gnômon) com aquelas obtidas por meio de uma bússola.
(EF04CI11) Associar os movimentos cíclicos da Lua e da Terra a períodos de tempo regulares e ao uso desse conhecimento para a construção de calendários em diferentes culturas.
Habilidades de Ciências da Natureza – 5o ano
Matéria e energia
(EF05CI01) Explorar fenômenos da vida cotidiana que evidenciem propriedades físicas dos materiais – como densidade, condutibilidade térmica e elétrica, respostas a forças magnéticas, solubilidade, respostas a forças mecânicas (dureza, elasticidade etc.), entre outras.
(EF05CI02) Aplicar os conhecimentos sobre as mudanças de estado físico da água para explicar o ciclo hidrológico e analisar suas implicações na agricultura, no clima, na geração de energia elétrica, no provimento de água potável e no equilíbrio dos ecossistemas regionais (ou locais).
(EF05CI03) Selecionar argumentos que justifiquem a importância da cobertura vegetal para a manutenção do ciclo da água, a conservação dos solos, dos cursos de água e da qualidade do ar atmosférico.
(EF05CI04) Identificar os principais usos da água e de outros materiais nas atividades cotidianas para discutir e propor formas sustentáveis de utilização desses recursos.
(EF05CI05) Construir propostas coletivas para um consumo mais consciente e criar soluções tecnológicas para o descarte adequado e a reutilização ou reciclagem de materiais consumidos na escola e/ou na vida cotidiana.
Vida e evolução
Terra e Universo
(EF05CI06) Selecionar argumentos que justifiquem por que os sistemas digestório e respiratório são considerados corresponsáveis pelo processo de nutrição do organismo, com base na identificação das funções desses sistemas.
(EF05CI07) Justificar a relação entre o funcionamento do sistema circulatório, a distribuição dos nutrientes pelo organismo e a eliminação dos resíduos produzidos.
(EF05CI08) Organizar um cardápio equilibrado com base nas características dos grupos alimentares (nutrientes e calorias) e nas necessidades individuais (atividades realizadas, idade, sexo etc.) para a manutenção da saúde do organismo.
(EF05CI09) Discutir a ocorrência de distúrbios nutricionais (como obesidade, subnutrição etc.) entre crianças e jovens a partir da análise de seus hábitos (tipos e quantidade de alimento ingerido, prática de atividade física etc.).
(EF05CI10) Identificar algumas constelações no céu, com o apoio de recursos (como mapas celestes e aplicativos digitais, entre outros), e os períodos do ano em que elas são visíveis no início da noite.
(EF05CI11) Associar o movimento diário do Sol e das demais estrelas no céu ao movimento de rotação da Terra.
(EF05CI12) Concluir sobre a periodicidade das fases da Lua, com base na observação e no registro das formas aparentes da Lua no céu ao longo de, pelo menos, dois meses.
(EF05CI13) Projetar e construir dispositivos para observação à distância (luneta, periscópio etc.), para observação ampliada de objetos (lupas, microscópios) ou para registro de imagens (máquinas fotográficas) e discutir usos sociais desses dispositivos.
1.1.6 OS TEMAS CONTEMPORÂNEOS TRANSVERSAIS (TCTs)
PROPOSTOS PELA BNCC
Os TCTs presentes na BNCC desafiam os estudantes a se posicionar diante de questões urgentes e decisivas para seu desenvolvimento socioemocional, intelectual e como cidadãos. Os TCTs se interligam às competências gerais e específicas e, ao mesmo tempo, envolvem a reflexão e o debate sobre desafios do dia a dia deles, contribuindo para que desenvolvam seu projeto de vida e preparando-os para atuar com consciência e autonomia na comunidade em que vivem.
Ao compreender os TCTs, os estudantes podem refletir e agir para preservar o ambiente, adotar o consumo consciente e aprender a lidar com o próprio dinheiro, cuidar de sua saúde, com atenção à alimentação, respeitar as regras de trânsito, reconhecer e valorizar a diversidade cultural e usar a ciência e a tecnologia para solucionar problemas e em defesa da humanidade, entre outros aspectos. Assim, eles se relacionam a importantes direitos e normas da legislação brasileira, com destaque para:
• Direitos das crianças e adolescentes (Lei no 8.069, de 1990);
• Educação para o trânsito (Lei no 9.503, de 1997);
• Estatuto da Pessoa Idosa (Lei no 10.741, de 2003);
• Educação ambiental (Lei no 9.795, de 1999);
• Educação alimentar e nutricional (Lei no 11.947, de 2009);
• Educação em Direitos Humanos (Decreto no 7.037, de 2009).
Vale dizer também que, no atual contexto, o enfrentamento desses temas por todos é necessário e urgente. Daí serem chamados de contemporâneos. Além disso, os TCTs podem e devem ser trabalhados por professores de diferentes componentes curriculares; por isso, são chamados de transversais. Os TCTs não integram uma área de conhecimento específica, mas se relacionam a todas elas e se conectam à realidade dos estudantes.
Há 15 TCTs. Eles estão agrupados em seis macroáreas temáticas (Meio ambiente, Economia, Saúde, Cidadania e civismo, Multiculturalismo e Ciência e tecnologia), como pode ser observado no organograma a seguir.
Meio ambiente
Ciência e tecnologia
Ciência e tecnologia
Multiculturalismo
Diversidade cultural
Educação para valorização do multiculturalismo nas matrizes históricas e culturais brasileiras
Educação ambiental Educação para o consumo
Temas
Contemporâneos Transversais na BNCC Economia Trabalho
Cidadania e civismo
Vida familiar e social Educação para o trânsito Educação em direitos humanos Direitos da criança e do adolescente Processo de envelhecimento, respeito e valorização do idoso
Educação financeira
Educação fiscal
Saúde
Saúde
Educação alimentar e nutricional
Fonte: BRASIL. Ministério da Educação. Temas Contemporâneos Transversais na BNCC. Brasília, DF: MEC, 2019, p. 7. Disponível em: https://basenacionalcomum.mec.gov.br/images/implementacao/guia_pratico_temas_ contemporaneos.pdf. Acesso em: 5 out. 2025.
1.2 ALFABETIZAÇÃO
Com base nos estudos da educadora e pesquisadora brasileira Magda Soares, a alfabetização pode ser entendida como a aquisição do sistema de escrita (código alfabético), enquanto o desenvolvimento de práticas sociais de leitura e escrita, por parte do estudante, se relaciona ao letramento. Embora distintos, a autora destaca o fato de que esses processos não devem ocorrer de forma separada.
O ensino tradicional de alfabetização em que primeiro se aprende a “decifrar um código” a partir de uma sequência de passos/etapas, para só depois se ler efetivamente, não garante a formação de leitores/escritores.
Por outro lado, é importante destacar que apenas o convívio intenso com textos que circulam na sociedade não garante que os alunos se apropriem da escrita alfabética, uma vez que essa aprendizagem não é espontânea e requer que o aluno reflita sobre as características do nosso sistema de escrita.
Nessa perspectiva, concordamos com a distinção que Soares (1998a) faz entre alfabetização e letramento. Para essa autora:
Alfabetizar e letrar são duas ações distintas, mas não inseparáveis, ao contrário: o ideal seria alfabetizar letrando, ou seja: ensinar a ler e escrever no contexto das práticas sociais da leitura e da escrita, de modo que o indivíduo se tornasse, ao mesmo tempo, alfabetizado e letrado [...].
SANTOS, Carmi Ferraz; MENDONÇA, Márcia (org.). Alfabetização e letramento: conceitos e relações. Belo Horizonte: Autêntica, 2007. p. 18.
Tomando como base esses pressupostos, esta coleção propicia ao estudante a inserção em práticas multiletradas, entendendo que isso o ajudará a se comunicar, refletir, propor, opinar e posicionar-se diante de situações desafiadoras, preparando-se para o exercício da cidadania. Reconhecemos, entretanto, que tais práticas também dialogam com o processo de alfabetização, pois envolvem situações que favorecem a consolidação do sistema alfabético.
De acordo com Albuquerque (apud Santos; Mendonça, 2007), a interação com textos de diferentes gêneros, bem como o envolvimento com distintas propostas de escrita, contribui para a formação de leitores e escritores competentes. Entende-se por leitor competente aquele que é capaz de realizar leituras com diferentes propósitos (estudar, buscar informações, seguir instruções, entre outros) e compreendê-las. Já por escritor competente entende-se aquele que consegue se comunicar (oralmente ou por escrito) e se fazer compreender. Vale ressaltar o fato de que a produção oral também precisa ser considerada produção textual e que os gêneros orais, como debates regrados e seminários, devem ser ensinados no espaço escolar.
Para a formação do leitor autônomo, faz-se necessário investir em situações que favoreçam o domínio da fluência em leitura. A fluência envolve ritmo, entonação e compreensão global tanto na leitura em voz alta quanto na leitura realizada silenciosamente. Entende-se, pois, que um leitor fluente é capaz de atribuir significado ao que lê ao localizar e extrair informações explícitas, fazer inferências, interpretar e relacionar ideias e informações, além de analisar e avaliar conteúdos e elementos textuais.
Assim, além da fluência em leitura, é preciso promover o desenvolvimento do vocabulário, tanto o receptivo quanto o expressivo. Para dominar o vocabulário de leitura, no processo inicial, os estudantes têm como referência a própria fala, forma de linguagem que já desenvolveram.
A produção escrita, por sua vez, diz respeito às habilidades necessárias para escrever palavras e produzir textos. O progresso nos níveis de produção escrita acontece à medida que se consolida a alfabetização e se avança no letramento. Para crianças mais novas, escrever ajuda a reforçar a consciência fonêmica e a instrução fônica. E, para as mais velhas, a escrita ajuda a entender as diversas tipologias e os gêneros textuais.
1.2.1 LER E ESCREVER É UM COMPROMISSO DE TODAS AS ÁREAS
O desenvolvimento da competência leitora e escritora faz parte de todas as áreas de conhecimento, e não somente da de Língua Portuguesa. Nesse sentido, a área de Ciências da Natureza tem papel fundamental na promoção do desenvolvimento dessas competências, uma vez que a compreensão de conceitos científicos depende diretamente da capacidade de ler, interpretar e produzir diferentes tipos de registro. Isso ajuda a explicar a ênfase que demos à leitura e à escrita nos três volumes desta coleção.
Parte do que os estudantes aprendem nas aulas de Ciências é resultado da leitura de textos e imagens, daí a importância de familiarizá-los com os procedimentos de leitura, específicos e diferenciados, e adequados a cada um desses registros. Sem entrar na discussão teórica do assunto, é importante lembrar que imagem e texto apresentam estatutos diferentes e demandam tratamentos e abordagens diversos.
Sabendo que a leitura possibilita o acesso a conteúdos e conceitos científicos, a tarefa de ensinar a ler e escrever deve ser considerada parte do ensino de Ciências da Natureza para os Anos Iniciais do Ensino Fundamental. Ao receberem tratamento adequado, os textos e as imagens deixam de servir só para ilustrar ou exemplificar determinado tema e passam a ser interrogados, confrontados, comparados e contextualizados.
Com esse objetivo, incentiva-se, nesta coleção, a leitura de diferentes gêneros de texto e exploram-se de forma sistemática a leitura e a interpretação de diferentes registros visuais.
Além de valorizar a leitura e a interpretação, pretende-se incentivar o desenvolvimento da competência escritora, fortalecendo a capacidade dos estudantes de comunicar ideias. Eis uma contribuição de especialistas no assunto:
O que seria ler e escrever nas diferentes áreas do currículo escolar? Esse é um dos objetivos que estabelecemos para este livro: desconfinar a discussão sobre leitura e escrita, ampliando o seu âmbito desde a biblioteca e a aula de português para toda a escola. E um dos méritos desse desconfinamento foi a descoberta da leitura e da escrita como confluências multidisciplinares para a reflexão e ação pedagógica.
[...]
Temos claro que ler e escrever sempre foram tarefas indissociáveis da vida escolar e das atribuições dos professores. Ler e escrever bem forjaram o padrão funcional da escola elitizada do passado, que atendia a parcelas pouco numerosas da população em idade escolar. Ler e escrever massiva e superficialmente tem sido a questão dramática da escola recente, sem equipamentos e estendida a quase toda a população.
A sociedade vê a escola como o espaço privilegiado para o desenvolvimento da leitura e da escrita, já que é nela que se dá o encontro decisivo entre a criança e a leitura/escrita.
Todo estudante deve ter acesso a ler e escrever em boas condições, mesmo que nem sempre tenha uma caminhada escolar bem traçada. Independente de sua história, merece respeito e atenção quanto a suas vivências e expectativas. Daí a importância da intervenção mediadora do professor e da ação sistematizada da escola na qualificação de habilidades indispensáveis à cidadania e à vida em sociedade, para qualquer estudante, como são o ler e o escrever.
NEVES, Iara C. Bitencourt (org.) et al. Ler e escrever: compromisso de todas as áreas. 9. ed. Porto Alegre: Editora da UFRGS, 2011. p. 15-16.
1.2.2 O COMPROMISSO NACIONAL CRIANÇA ALFABETIZADA
Dados do Sistema de Avaliação da Educação Básica (Saeb) de 2019 e 2021 revelaram um grave impacto da pandemia de covid-19 na alfabetização das crianças brasileiras: a queda no percentual de 54,8% para 49,4% de crianças alfabetizadas. Considerando as consequências dessa defasagem na trajetória escolar e, de modo mais amplo, na vulnerabilização social e econômica dessas crianças, o Ministério da Educação retomou o Pacto Nacional pela Alfabetização na Idade Certa e propôs uma reformulação nessa política pública à luz dos desafios do presente. Disso resultou o Compromisso Nacional Criança Alfabetizada, de junho de 2023, que:
[...] tem como finalidade garantir o direito à alfabetização das crianças brasileiras até o final do 2o ano do ensino fundamental e foca a recuperação das aprendizagens das crianças do 3o, 4o e 5o ano afetadas pela pandemia. O Compromisso estabelece, entre seus princípios, a promoção da equidade educacional, sendo considerados aspectos regionais, socioeconômicos, étnico-raciais e de gênero; a colaboração entre os entes federativos; e o fortalecimento das formas de cooperação entre estados e municípios.
BRASIL. Ministério da Educação. Compromisso Nacional Criança Alfabetizada. Gov.br, 2023. Disponível em: https://www.gov.br/mec/pt-br/crianca-alfabetizada. Acesso em: 2 out. 2025.
O Compromisso Nacional Criança Alfabetizada reforça a ideia de que a alfabetização é um direito de todas as crianças, consolidando-a como prioridade nacional e reconhecendo o papel da escola e dos docentes como mediadores desse direito fundamental. Alinhando-se às premissas do Compromisso Nacional Criança Alfabetizada, esta coleção trabalha situações de uso da linguagem que apoiam a alfabetização, como ressaltado anteriormente. Os suportes textuais apresentados e as situações de escrita propostas são contextualizados e orientados por uma função social da escrita, de modo que a leitura de fontes, a análise de informações, a produção de textos e a participação em debates se tornam caminhos para aprender sobre fenômenos que ocorrem na natureza e, simultaneamente, para desenvolver habilidades de leitura, escrita e oralidade.
1.3 O ENSINO DE CIÊNCIAS DA NATUREZA
A ciência está presente em diversas situações cotidianas: na programação do alarme de um aparelho eletrônico, no preparo e no consumo de uma refeição, na utilização de um veículo para deslocamentos ou em pesquisas na internet, entre outras. Além de influenciar nossa vida diária, a ciência se relaciona a grandes desafios globais, como as mudanças climáticas e o desmatamento.
Esse empreendimento humano oferece diversas formas de compreender o mundo, tomar decisões informadas e desenvolver soluções para problemas complexos. Por isso, a Educação Básica, sobretudo por meio da área de Ciências da Natureza, deve preparar os estudantes para entender conceitos científicos e aplicá-los de forma prática, fortalecendo o letramento científico.
1.3.1 LETRAMENTO CIENTÍFICO: FUNDAMENTOS
Entende-se o letramento científico como um dos pilares do ensino de Ciências no século XXI. Segundo a BNCC:
Para debater e tomar posição sobre alimentos, medicamentos, combustíveis, transportes, comunicações, contracepção, saneamento e manutenção da vida na Terra, entre muitos outros temas, são imprescindíveis tanto conhecimentos éticos, políticos e culturais quanto científicos. Isso por si só já justifica, na educação formal, a presença da área de Ciências da Natureza, e de seu compromisso com a formação integral dos alunos.
Portanto, ao longo do Ensino Fundamental, a área de Ciências da Natureza tem um compromisso com o desenvolvimento do letramento científico, que envolve a capacidade de compreender e interpretar o mundo (natural, social e tecnológico), mas também de transformá-lo com base nos aportes teóricos e processuais das ciências.
BRASIL. Ministério da Educação. Base Nacional Comum Curricular: educação é a base. Brasília, DF: MEC, 2018. p. 321. Disponível em: https://www.gov.br/mec/pt-br/escola-em-tempo-integral/BNCC_EI_EF_110518_ versaofinal.pdf. Acesso em: 5 out. 2025.
A abordagem do letramento científico ultrapassa a mera apropriação de conteúdos conceituais, envolvendo a capacidade de compreender, interpretar, aplicar e criticar conhecimentos científicos em diversos contextos da vida cotidiana. Mais do que formar estudantes tecnicamente competentes, busca-se desenvolver cidadãos éticos, informados e capazes de atuar de forma transformadora na sociedade (Sasseron; Carvalho, 2021; Chassot, 2003).
Essa perspectiva orienta a presente coleção e está em consonância com a definição de letramento científico proposta por Hodson, em 1988 (apud Cachapuz; Praia; Jorge, 2004), que compreende três dimensões interligadas:
• aprender ciência – aquisição de conhecimentos científicos fundamentais, como leis, teorias e conceitos;
• aprender sobre a ciência – compreensão da natureza da ciência, incluindo seus métodos, seus limites e seu papel na sociedade;
• aprender a fazer ciência – participação em práticas investigativas, formulação de hipóteses e análise de dados.
Integradas ao processo educativo, essas dimensões contribuem para que professores e estudantes compreendam a ciência como uma construção social, dinâmica e contextualizada. O ensino, assim, deixa de ser uma simples transmissão de conteúdos e passa a promover uma postura crítica e investigativa diante da realidade.
1.3.2 LETRAMENTO CIENTÍFICO COMO FERRAMENTA CONTRA
A DESINFORMAÇÃO
O letramento científico também se revela essencial no enfrentamento da desinformação, fenômeno intensificado pela era digital, caracterizada pela disseminação de fake news, pseudociências e informações imprecisas. Desenvolver a capacidade de analisar, julgar e selecionar informações com base em evidências e critérios científicos torna-se, portanto, indispensável para a formação de sujeitos críticos e conscientes (Chassot, 2003).
Educar cientificamente é, nesse sentido, formar leitores críticos da realidade, capazes de distinguir argumentos fundamentados de opiniões infundadas ou ideologicamente manipu-
ladas. O letramento científico concretiza-se quando os estudantes aplicam o conhecimento adquirido para interpretar o mundo, identificar problemas e propor soluções fundamentadas em evidências.
Essa articulação entre saberes escolares e desafios reais – como as mudanças climáticas, os problemas de saúde pública, as desigualdades sociais e o uso da tecnologia – promove uma aprendizagem significativa. Ao relacionar o ensino de Ciências à vida cotidiana dos estudantes, estimulam-se o engajamento, o protagonismo e o pensamento crítico, por meio de estratégias como a resolução de problemas e a investigação científica.
Um cidadão letrado em Ciências é, assim, capaz de participar de debates públicos, tomar decisões fundamentadas e compreender os impactos sociais, éticos e ambientais das inovações tecnológicas. Essa capacidade é fundamental para o exercício pleno da cidadania.
1.3.3 PROTAGONISMO ESTUDANTIL E MEDIAÇÃO DOCENTE
No contexto da educação científica, os estudantes devem ser reconhecidos como protagonistas de seu aprendizado. Isso significa que devem não apenas receber informações, mas também participar ativamente da construção do conhecimento, relacionando o que aprendem com suas experiências, seus interesses e suas vivências.
Os estudantes, portanto, são os responsáveis finais por sua aprendizagem, pois atribuem significado e constroem sentidos para os conhecimentos. Contudo, cabe ao professor definir as estratégias que favorecem a integração dos conceitos e a construção desses significados.
Nesse processo, o docente atua como mediador. Em Ciências, por exemplo, é quem propõe situações desafiadoras, incentiva a problematização, orienta investigações e assegura que o saber científico seja compreendido e apropriado de forma significativa pelos estudantes.
Mais do que um transmissor de conteúdos, o professor deve atuar como facilitador da aprendizagem, planejando estratégias que articulem teoria e prática, valorizem os saberes prévios dos estudantes e promovam a investigação e o pensamento crítico. Deve também assumir uma postura reflexiva sobre a própria prática, observando, escutando, avaliando e ajustando suas ações de acordo com as necessidades e potencialidades de cada turma.
Diante dos desafios contemporâneos – como as desigualdades sociais, a desinformação e os impactos ambientais –, cabe ao professor formar sujeitos capazes de compreender, argumentar e agir com ética, responsabilidade e compromisso social.
O ensino de Ciências, portanto, deve ser concebido como um processo formativo, reflexivo e socialmente engajado. Ao integrar conhecimento, linguagem, valores e ação, o letramento científico se consolida como um alicerce para o exercício da cidadania e para a construção de uma sociedade mais equitativa, sustentável e solidária.

Ao atuar como mediador do processo educativo, o professor colabora para a autonomia e o protagonismo dos estudantes.
2. ORIENTAÇÕES DIDÁTICO-METODOLÓGICAS
Neste tópico, são apresentados aspectos relacionados à progressão da aprendizagem e às estratégias de ensino que fundamentaram a elaboração do Livro do Estudante. Além disso, são abordadas questões relativas à inclusão em sala de aula, à avaliação e ao planejamento didático.
2.1 PROGRESSÃO DA APRENDIZAGEM
A proposta didático-pedagógica considerada está alicerçada em uma abordagem na qual se valoriza a construção ativa e significativa do conhecimento. Por meio dessa abordagem, reconhece-se o estudante como protagonista do processo educativo e compreende-se que a aprendizagem se desenvolve de maneira mais eficaz quando novas informações se integram de forma não arbitrária aos conhecimentos prévios.
O eixo dessa proposta é a teoria da aprendizagem significativa, concebida por David Ausubel, em que, conforme Ferro e Paixão (2017) e Silveira (2014), a aprendizagem ocorre de maneira efetiva quando um conhecimento novo se ancora em estruturas cognitivas previamente estabelecidas. Ou seja, os novos conhecimentos precisam ter coerência interna e devem ser apresentados de modo que o estudante consiga integrá-los aos conhecimentos que já detém. Complementando essa visão, Ferro e Paixão (2017) ressaltam a ideia de que, para a aprendizagem ser significativa, é essencial que o conteúdo selecionado seja potencialmente significativo, organizado logicamente e apresentado de forma coesa, conectando-se com o que o estudante já sabe. Nesse sentido, o papel do professor é fundamental para planejar estratégias de ensino considerando as estruturas cognitivas dos estudantes e favorecendo a construção ativa do conhecimento.
A teoria também contempla os mecanismos de diferenciação progressiva, em que ideias mais gerais se desdobram em conceitos mais específicos, e de reconciliação integrativa, por meio do qual se buscam a reorganização e a ampliação das estruturas existentes, promovendo a compreensão cada vez mais profunda dos conteúdos.
Com base nesses fundamentos, pretende-se com a proposta:
• promover o desenvolvimento de aprendizagens significativas pautadas nos conhecimentos prévios dos estudantes;
• incentivar a reflexão, a curiosidade e a atitude investigativa no ensino de Ciências;
• fomentar a construção da autonomia e do pensamento crítico;
• promover a contextualização do conhecimento científico e sua articulação com a vida cotidiana. Diante disso, a progressão da aprendizagem é entendida como um processo dinâmico de construção de significados, em que o conhecimento novo se articula progressivamente com estruturas cognitivas anteriores. Recursos como organizadores prévios, mapas conceituais, analogias e situações-problema tornam-se fundamentais para facilitar essa progressão. Além disso, para que seja significativa e relevante, a aprendizagem precisa estar conectada com a realidade social e cultural dos estudantes.
A prática pedagógica fundamentada na aprendizagem significativa articula múltiplas estratégias, como:
• ativação de conhecimentos prévios com base em perguntas orientadoras ou discussões, propostas de leitura e interpretação de imagens;
• organizadores prévios que forneçam uma visão ampla dos conteúdos;
• situações-problema contextualizadas que incentivem o pensamento científico;
• experimentos investigativos, estimulando a curiosidade e a análise de dados;
• avaliação formativa e contínua, focada no processo, e não apenas no resultado.
Nessa proposta, o professor assume o papel de mediador da aprendizagem, planejando intervenções pedagógicas que facilitem o processo de construção do conhecimento e valorizem a participação ativa dos estudantes.
2.2 ESTRATÉGIAS DE ENSINO
A elaboração do Livro do Estudante foi embasada em diferentes estratégias de ensino, visando conduzir os conteúdos a fim de ampliar as oportunidades de aprendizado. A seguir, apresentamos cada uma delas.
2.2.1 LEVANTAMENTO DE CONHECIMENTOS PRÉVIOS
Os conhecimentos prévios representam o conjunto de saberes, experiências, percepções e formas de pensar que os estudantes detêm antes de depararem com novos conteúdos escolares. Esses conhecimentos não se restringem ao que foi aprendido em ambientes formais de ensino, mas incluem aprendizagens adquiridas em outros momentos, com a família, a comunidade, a mídia, as vivências pessoais e as redes sociais. Além de conteúdos conceituais, envolvem habilidades desenvolvidas, atitudes e valores internalizados ao longo da vida.
Cada estudante chega à sala de aula com um repertório composto de informações e experiências que, embora nem sempre organizadas de modo lógico ou sistemático, influenciam diretamente sua forma de aprender. Compreender esse repertório inicial é essencial para promover um ensino que respeite a individualidade e a diversidade dos estudantes, favorecendo a construção de novos conhecimentos de maneira significativa e contextualizada.
Nesse processo, investigar os conhecimentos prévios dos estudantes constitui uma etapa importante do planejamento pedagógico. Essa prática possibilita ao professor determinar um “ponto de partida” para planejar experiências de aprendizagem alinhadas ao nível de desenvolvimento, às necessidades, aos interesses e ao contexto sociocultural deles.
O levantamento de conhecimentos prévios é, portanto, uma ação pedagógica intencional, voltada a tornar a aprendizagem mais próxima da realidade dos estudantes, mais relevante e conectada com suas vivências. Quando o educador reconhece e valoriza o que os estudantes já sabem – mesmo que essas concepções estejam em desacordo com os conhecimentos científicos –, cria-se um espaço propício ao diálogo, à problematização e à reconstrução conceitual.
Mapear os conhecimentos dos estudantes vai além de simplesmente questioná-los sobre o que sabem. É necessário observar, escutar atentamente, propor situações diversificadas de aprendizagem e analisar as respostas, os comportamentos e as atitudes deles em diferentes contextos. Essa investigação pode ocorrer por meio de atividades diagnósticas, dinâmicas de grupo, rodas de conversa, estudos de caso, dramatizações, jogos, debates, resolução de problemas ou situações reais relacionadas aos temas em estudo.
Nesta coleção, as atividades propostas na abertura das unidades e no início dos capítulos do Livro do Estudante auxiliam nesse mapeamento. Adicionalmente, há sugestões, ao longo das orientações presentes no Livro do Professor, que podem contribuir para isso.
2.2.2 CONTEXTUALIZAÇÃO
A contextualização no ensino de Ciências deve ser compreendida como uma estratégia didática essencial para atribuir sentido e relevância aos conhecimentos escolares. Mais do que inserir exemplos do cotidiano, trata-se de criar experiências em que os estudantes sejam incentivados a estabelecer conexões entre seus saberes prévios e os novos conceitos científicos, de forma crítica, criativa e situada em sua realidade sociocultural.
Em um ambiente escolar marcado pela pluralidade e pela diversidade, a contextualização torna-se condição indispensável para superar a fragmentação dos conteúdos e favorecer o protagonismo dos estudantes no processo de aprendizagem. Quando é inserido em contextos significativos, o conhecimento escolar torna-se mais envolvente, desperta a curiosidade e estimula uma aprendizagem ativa e reflexiva.
A contextualização dinamiza os conteúdos científicos e os insere em situações sociais, ambientais, históricas e culturais relevantes. Isso contribui não apenas para a compreensão conceitual, mas também para o fortalecimento do letramento científico.
As situações de ensino devem, portanto, considerar tanto os contextos de produção do conhecimento nas Ciências Naturais quanto a realidade dos estudantes e professores, valorizando suas histórias, suas experiências e seus territórios. Isso implica a elaboração de propostas pedagógicas que, além de transmitirem informações, os provoquem a identificar relações, articular o saber científico a suas vivências e projetar ações concretas em seus contextos.
Nesse cenário, a contextualização deve atravessar todas as dimensões do processo educativo – desde a organização curricular, expressa nos temas das unidades e nas atividades propostas, até as práticas cotidianas em sala de aula.
Nesta coleção, a contextualização está presente em diversos momentos: na abertura das unidades, no início dos capítulos e ao longo deles, e em seções do Livro do Estudante, como Atividades e Dialogando com.
2.2.3 PENSAMENTO CRÍTICO E ARGUMENTAÇÃO
O ensino de Ciências contribui para o desenvolvimento do pensamento crítico e da argumentação fundamentada. A BNCC reconhece a importância dessas competências e as estabelece como princípios formativos desde os anos iniciais da Educação Básica. Em um contexto contemporâneo, caracterizado pela ampla circulação de informações e por desafios sociocientíficos complexos, essas habilidades se mostram essenciais para a formação dos estudantes.
A argumentação é uma prática fundamental para a construção do conhecimento científico. Costa (2008) afirma que ensinar os estudantes a argumentar cientificamente deve ser um objetivo pedagógico prioritário, pois contribui para o desenvolvimento de capacidades cognitivas e linguísticas como descrever, explicar, justificar e demonstrar. Para isso, é necessário criar situações didáticas em que eles possam elaborar e defender ideias com base em evidências, compreendendo os princípios éticos que sustentam o exercício da cidadania.
De acordo com Munford e Teles (2015), eventos de argumentação, mesmo quando não planejados intencionalmente, oferecem oportunidades significativas de aprendizagem em aulas de Ciências. Tais práticas possibilitam aos estudantes desenvolver habilidades de análise, reflexão crítica e posicionamento diante de diferentes perspectivas.
Para fortalecer a argumentação, é fundamental que os estudantes aprendam a estruturar seu raciocínio com coerência e embasamento e cabe ao professor criar oportunidades que contribuam para o desenvolvimento dessas habilidades, por meio de atividades como:
• debates e discussões orientadas – promover a exposição e a análise de diferentes pontos de vista com base em dados confiáveis;
• análises críticas de textos – identificar falhas argumentativas (como digressões, generalizações e vieses) e propor reescritas;
• projetos de investigação – incentivar a formulação de hipóteses, coleta de dados e apresentação de conclusões fundamentadas.
Nesta coleção, o exercício da argumentação é oportunizado em algumas propostas de atividades de diferentes seções do Livro do Estudante.
2.2.4 ATIVIDADES PRÁTICAS
As atividades práticas ocupam papel central no ensino de Ciências, pois transformam o estudante em protagonista de sua aprendizagem, promovendo o letramento científico, o desenvolvimento de habilidades investigativas e a construção significativa do conhecimento. A formação científica deve articular teoria e prática, considerando os conhecimentos prévios dos estudantes e favorecendo o desenvolvimento de competências cognitivas, socioemocionais e atitudinais.
Ao vivenciar processos científicos por meio da observação, da formulação, da testagem de hipóteses, da experimentação e da análise de dados, os estudantes não apenas assimilam conteúdos conceituais, mas também desenvolvem o pensamento crítico, a autonomia e a capacidade de resolver problemas complexos do cotidiano.
De acordo com Costa, Nogueira e Cruz (2020), atividades práticas bem conduzidas despertam o interesse, a curiosidade e o senso crítico dos estudantes, tornando o processo de aprendizagem mais prazeroso e significativo.
As atividades práticas oportunizam não apenas ilustrar aspectos teóricos tratados nas aulas, mas também problematizar, investigar e desafiar os estudantes. Conforme Andrade e Massabni (2011), é preciso investir em propostas que promovam o desenvolvimento da capacidade de questionamento, da experimentação e da reflexão sobre os fenômenos.
Os espaços para a realização dessas atividades não devem se restringir aos laboratórios. A sala de aula, a biblioteca, a cozinha, o pátio, os arredores da escola, parques e áreas de conservação ambiental também são ambientes ricos para o desenvolvimento de práticas significativas. O uso de jogos didáticos, saídas de campo, experimentos de baixo custo, feiras de ciências e construção de maquetes são algumas das estratégias que incentivam a criatividade, o trabalho colaborativo e o protagonismo.
O ensino de Ciências precisa, portanto, estar alicerçado em metodologias ativas que conectem a teoria à prática. Como propõe a BNCC, o processo investigativo deve permear o currículo, promovendo a definição de problemas, a coleta e a análise de dados, a elaboração de modelos explicativos e a comunicação de resultados. Essas ações ampliam o letramento científico e favorecem o desenvolvimento de competências como argumentação, sistematização e tomada de decisão.
Para que as atividades práticas sejam efetivas, é necessário que o professor atue como mediador atento, propondo desafios e incentivando a autonomia dos estudantes. Também é fundamental que a escola e os órgãos gestores ofereçam suporte estrutural e formação continuada aos docentes, garantindo as condições necessárias para o planejamento e a execução dessas práticas.

As experiências práticas, quando bem articuladas ao conteúdo teórico e aos contextos vividos pelos estudantes, contribuem para a formação de sujeitos críticos, investigativos e capazes de atuar de forma consciente e transformadora na sociedade. Mais do que uma metodologia complementar, a atividade prática é parte estruturante do ensino de Ciências, importante para que a aprendizagem ocorra de maneira significativa, contextualizada e emancipadora.
Nesta coleção, propostas de atividades práticas são encontradas na seção Você cientista!, do Livro do Estudante, e em Encaminhamento e +Atividades, neste Livro do Professor
Ao participar de atividades científicas, os estudantes podem construir conhecimento de maneira significativa.
2.2.5 USO DE IMAGENS
Em um cenário educacional cada vez mais desafiador, marcado pelo excesso de informações e pelo predomínio de linguagens multimodais, o uso pedagógico de imagens assume papel relevante no ensino de Ciências. Longe de serem meros recursos ilustrativos, as imagens constituem ferramentas cognitivas que potencializam a aprendizagem significativa, o letramento científico e o desenvolvimento do pensamento crítico.
O uso de múltiplas linguagens no processo de ensino-aprendizagem, sobretudo por meio de representações visuais como diagramas, esquemas, fotografias e infográficos, desempenha um papel fundamental na compreensão de fenômenos científicos. Esses recursos possibilitam aos estudantes visualizar o que não é diretamente observável, representar conceitos abstratos e construir modelos mentais que facilitam a assimilação dos conteúdos científicos.
Conforme discutido por Oliveira e Zanetic (2014), as imagens científicas cumprem funções fundamentais: documentam fenômenos, sintetizam ideias e viabilizam inferências. Elas são parte constitutiva do discurso científico, servindo tanto para a análise como para a construção e a comunicação do conhecimento.
Nesse sentido, integrar imagens ao processo de aprendizagem significa reconhecer que elas não apenas representam o conteúdo, mas também são conteúdos. A leitura de imagens é tão importante quanto a de textos. Para realizá-la, são necessárias habilidades interpretativas, análise crítica e correlações com o conhecimento prévio. A leitura visual possibilita aos estudantes reconhecer estruturas, compreender processos e estabelecer relações entre diferentes conceitos científicos.
A pesquisa de Ribeiro (2017) mostra que o trabalho com imagens em sala de aula estimula a observação atenta, a formulação de hipóteses, a argumentação e a inferência. Ao analisar imagens, os estudantes ampliam sua capacidade de abstração e exercitam o raciocínio lógico, aspectos essenciais à prática científica. Quando acompanhadas de perguntas norteadoras e estratégias de leitura guiada, as imagens contribuem para a promoção de um aprendizado mais profundo e duradouro.
A imagem facilita a ancoragem de novos conhecimentos na estrutura cognitiva do estudante, pois oferece múltiplas possibilidades de representação e conexão com os saberes prévios. Quando bem exploradas, as imagens ativam esquemas mentais, promovem inferências e ajudam na construção de significados mais elaborados e contextualizados.
Do ponto de vista metodológico, o uso de imagens deve estar integrado às etapas do planejamento didático. Isso implica não apenas selecionar imagens esteticamente atrativas, como também escolher aquelas que dialoguem com os objetivos de aprendizagem, possibilitando múltiplas leituras e discussões. Recomenda-se, por exemplo, propor atividades em que os estudantes construam, analisem ou interpretem infográficos, identifiquem erros conceituais em representações visuais ou criem esquemas com base em dados científicos.
Além disso, como parte do processo investigativo, as imagens podem ser usadas para levantar hipóteses, registrar observações e comunicar resultados. Elas também fomentam o protagonismo estudantil, ao possibilitar aos estudantes a exploração, a manipulação e a ressignificação do conteúdo visual de acordo com os próprios percursos de aprendizagem.
Em síntese, a imagem no ensino de Ciências deve ser compreendida como conteúdo. Sua utilização favorece o letramento científico, a aprendizagem significativa e o desenvolvimento de competências essenciais para que os estudantes compreendam, critiquem e transformem o mundo em que vivem.
Nesta coleção, as imagens são exploradas em diferentes momentos, como na abertura das unidades, ao longo dos capítulos e em seções e atividades do Livro do Estudante.
2.2.6 ABORDAGEM INTERDISCIPLINAR
A integração curricular configura uma prática pedagógica que vai além da simples justaposição de conteúdos disciplinares. Conforme as discussões propostas por Thiesen (2008), entende-se que integrar o currículo implica uma articulação intencional e reflexiva entre as diferentes áreas do conhecimento, com o objetivo de construir uma aprendizagem significativa e contextualizada. Essa abordagem pressupõe o trabalho colaborativo entre professores, que planejam em conjunto e articulam seus componentes curriculares para promover conexões efetivas entre os saberes, ampliando a compreensão crítica dos estudantes.
Nesse sentido, a integração curricular se aproxima dos TCTs, que podem ser trabalhados de forma interdisciplinar em todas as etapas da Educação Básica. Por meio dessa orientação, sugere-se que os docentes desenvolvam práticas pedagógicas que favoreçam a articulação entre os diferentes componentes curriculares, contribuindo para que os estudantes adquiram uma visão integrada dos desafios contemporâneos.
Para que a prática interdisciplinar avance, é importante que os professores se envolvam na busca por caminhos que os auxiliem a superar os desafios existentes. É preciso reconhecer que ainda há uma resistência cultural e institucional em muitas escolas, nas quais a fragmentação disciplinar permanece presente.
Apesar desses desafios, Thiesen (2008) ressalta as potencialidades da integração curricular, sobretudo na formação de estudantes críticos, capazes de compreender o mundo em sua complexidade e interconectividade. Quando estruturada de forma consistente, a interdisciplinaridade pode contribuir para superar a fragmentação do conhecimento, alinhando a escola às demandas sociais contemporâneas e promovendo uma educação mais democrática e significativa.
Para isso, é importante que as escolas construam um compromisso coletivo entre professores, gestores e demais atores envolvidos, favorecendo planejamento estruturado, formação continuada e políticas educacionais que estimulem a colaboração e a inovação pedagógica. Além disso, a elaboração conjunta de aulas por docentes de diferentes áreas pode ser incentivada, com o oferecimento de subsídios práticos e teóricos que facilitem essa articulação curricular, conforme as estratégias alinhadas aos TCTs propostas na obra.
Assim, a integração curricular pautada na integração dos conhecimentos configura uma estratégia essencial para promover nos estudantes uma visão crítica e integrada do mundo, fomentando aprendizagens que dialoguem diretamente com os desafios do século XXI.
Nesta coleção, a abordagem interdisciplinar é oportunizada em diferentes momentos dos capítulos, com destaque para a seção Dialogando com, do Livro do Estudante. As temáticas escolhidas para a construção da seção se alinham, em geral, a pelo menos um TCT, favorecendo a integração de conteúdos e uma reflexão sobre questões atuais de forma contextualizada.
2.2.7 DIVERSIFICAÇÃO DA ORGANIZAÇÃO DO ESPAÇO EM SALA DE AULA
A organização do espaço físico na sala de aula desempenha um papel crucial na dinâmica do processo de ensino-aprendizagem, influenciando diretamente a interação entre os estudantes e a construção do conhecimento coletivo. Embora o modelo convencional, com carteiras enfileiradas voltadas para o professor, seja amplamente utilizado, pode restringir a comunicação e limitar as oportunidades de colaboração entre eles.
De acordo com Teixeira e Reis (2012), a diversificação da organização do ambiente pode favorecer significativamente a aprendizagem, uma vez que diferentes arranjos espaciais promovem interações efetivas e engajamento ativo dos estudantes. O professor, portanto, pode experimentar diversas formas de dispor a turma, criando um ambiente que incentive o diálogo, o trabalho em grupo e o protagonismo.
Exemplos práticos de organização da turma que facilitam a interação incluem:
• duplas – agrupar os estudantes em pares favorece a cooperação direta e o intercâmbio de ideias;
• semicírculo – dispor as cadeiras em semicírculo amplia a visibilidade e facilita a participação em exposições, diálogos e apresentações, mantendo o contato visual entre todos;
• formato em “U” – essa organização incentiva a interação coletiva e o trabalho colaborativo;
• divisão em dois blocos – organizar a turma desse modo favorece debates, dinâmicas simultâneas e jogos, promovendo envolvimento ativo e autonomia;
• pequenos grupos distribuídos – agrupar os estudantes em equipes menores em diferentes locais da sala de aula favorece a realização de projetos colaborativos, com mais flexibilidade e trocas entre os participantes.
Segundo Teixeira e Reis (2012), essas alternativas contribuem para um ambiente mais acolhedor e dinâmico, no qual a aprendizagem ocorre de forma mais significativa, pois os estudantes interagem não só com o professor, mas também uns com os outros, fortalecendo vínculos sociais e desenvolvendo competências socioemocionais essenciais.
O professor, ao diversificar a organização espacial, considera as necessidades da turma, o tipo de atividade proposta e o objetivo pedagógico, tornando-se um agente ativo na construção de um ambiente de aprendizagem que valorize a cooperação e o respeito às diferentes formas de aprender.
Assim, a flexibilização do espaço em sala de aula emerge como um recurso pedagógico fundamental para ampliar as oportunidades de interação, participação e engajamento dos estudantes, contribuindo para o desenvolvimento integral e para a construção de uma comunidade escolar mais integrada e participativa.
Nesta coleção, em algumas propostas presentes nas seções Encaminhamento e +Atividades, do Livro do Professor, sugere-se variar a organização da sala de aula, a fim de tornar as atividades mais dinâmicas, favorecer a interação entre os estudantes e potencializar a aprendizagem.
2.2.8 ESPAÇOS NÃO FORMAIS DE APRENDIZAGEM
A educação em Ciências deve ultrapassar os limites da sala de aula, promovendo a aprendizagem ativa por meio da exploração de espaços não formais de aprendizagem. Visitas guiadas a museus de ciência e tecnologia, centros de pesquisa, teatros, zoológicos, jardins botânicos, parques e outras instituições científicas e culturais configuram oportunidades pedagógicas ricas para aproximar os estudantes do conhecimento científico de maneira contextualizada e significativa. Tais experiências favorecem a compreensão dos conteúdos ao relacioná-los com situações do cotidiano, contribuindo para uma formação crítica e curiosa.
Nesse contexto, é essencial o desenvolvimento de estratégias educacionais nas quais se considerem essas possibilidades e o incentivo de práticas que integrem a escola a esses ambientes. Como destacam Marandino et al. (2003), a educação em Ciências constitui uma prática social que se amplia continuamente nos espaços não formais, demandando abordagens que favoreçam a apropriação do saber científico em diferentes contextos sociais.
Diversos pesquisadores afirmam que a educação, nos dias de hoje, não pode mais se ater ao ambiente estritamente escolar [...]. Neste contexto, a utilização de espaços não formais pode representar uma importante estratégia de ensino e de aprendizagem, na tentativa de despertar o encantamento, a motivação e a contextualização dos saberes associados estritamente à escola. [...]
[...]
Entretanto, para o sucesso do uso de espaços não formal como estratégia de ensino-aprendizagem, é importante que o professor conheça previamente as características do
local a ser visitado e que faça um planejamento criterioso desta atividade, na tentativa de atender as expectativas tanto dos estudantes, quanto as suas próprias. [...]
TERCI, D. B. L.; ROSSI, A. V. Dinâmicas de ensino e aprendizagem em espaços não formais. In: ENCONTRO NACIONAL DE PESQUISA EM EDUCAÇÃO EM CIÊNCIAS, 10., 2015. Anais [...]. Águas de Lindóia: Abrapec, 2015. Disponível em: https://www.abrapec.com/enpec/x-enpec/anais2015/resumos/R0977-1.PDF. Acesso em: 5 out. 2025.
Nesta coleção, é possível encontrar propostas de exploração de espaços não formais de aprendizagem no boxe Para você explorar, do Livro do Estudante, e em algumas atividades. Também são propostas sugestões nas seções Encaminhamento e +Atividades, do Livro do Professor.

Turma de estudantes visitando o Jardim Sensorial do Jardim Botânico do Rio de Janeiro, no município do Rio de Janeiro (RJ), 2023. Jardins botânicos oferecem diferentes oportunidades para enriquecer o aprendizado dos estudantes.
2.2.9 USO PEDAGÓGICO DA TECNOLOGIA
O uso da tecnologia na educação tem se mostrado uma ferramenta significativa para ampliar as possibilidades de aprendizagem (Reis; Negrão, 2022). Por meio das Tecnologias Digitais de Informação e Comunicação (TDICs), que incluem computadores, tablets e celulares, bem como programas, softwares e plataformas digitais, os estudantes têm acesso a conteúdos multimídia e a materiais interativos que enriquecem o processo de ensino-aprendizagem, tornando-o mais dinâmico.
No entanto, considerando os riscos decorrentes do uso excessivo da tecnologia (como distração, redução da concentração e impactos na saúde mental), torna-se fundamental conscientizar estudantes e famílias sobre o uso responsável dos recursos digitais. No ambiente escolar, é essencial que o uso da tecnologia na educação seja intencional e orientado pelo professor. Este deve verificar o melhor momento e a forma adequada para utilizar os dispositivos, respeitando a Lei no 15.100, de 2025, que restringe o uso de celulares durante aulas e intervalos, permitindo seu uso apenas para fins pedagógicos autorizados pelo professor ou em situações específicas, como no atendimento à acessibilidade ou em razão de condições de saúde.
Quando integrado de maneira adequada, o uso pedagógico da tecnologia contribui para a formação de cidadãos críticos, conscientes e preparados para o mundo. Com esse objetivo, nesta coleção, recomenda-se o uso de recursos tecnológicos sobretudo no boxe Para você explorar, do Livro do Estudante, e em Para o estudante, do Livro do Professor. No entanto, esses recursos devem ser utilizados sob a supervisão de um adulto da família ou do professor, e apenas em momentos adequados.
CHICO FERREIRA/PULSAR IMAGENS
2.3 VALORIZAÇÃO DE SABERES TRADICIONAIS
No ensino de Ciências, a valorização dos saberes tradicionais é fundamental para ampliar a compreensão sobre a relação entre o ser humano e a natureza, bem como para reconhecer a diversidade cultural existente no Brasil. Além do conhecimento científico, é importante considerar os saberes produzidos por comunidades tradicionais, que detêm experiências, práticas e interpretações do mundo natural construídas ao longo de gerações. Esses conhecimentos, transmitidos oralmente ou por meio de práticas cotidianas, revelam formas próprias de observar, interpretar e interagir com o ambiente.
O Decreto no 8.750, de 9 de maio de 2016, reconhece 29 comunidades tradicionais brasileiras, entre as quais estão os povos indígenas, quilombolas, caiçaras, pescadores artesanais, extrativistas e ribeirinhos. Cada uma dessas comunidades detém saberes próprios, intimamente ligados a seu modo de vida.
Conhecimentos tradicionais podem ser estudados por um campo multidisciplinar chamado Etnociência, que envolve a investigação da maneira como diferentes culturas compreendem a natureza e interagem com ela.
A ciência tem por objetivo estudar todos os fenômenos naturais e culturais, auxiliando o homem a compreender a realidade onde se insere. Do ponto de vista institucional, a ciência é uma organização coletiva constituída por objetos de pesquisa, interlocutores, campos e pesquisadores que exibem um sistema de crenças, saberes e práticas fortemente enraizados e influenciados pelos conhecimentos produzidos dentro da própria comunidade científica. [...]
A Etnociência posiciona-se como caminho alternativo à rigidez científica, sem menosprezar nenhuma das metodologias construídas pela ciência ocidental, mas utilizando-se delas como ferramentas para releituras que propiciem compreensão mais adequada e respeitosa da relação entre humanidade e natureza. [...]
WIECZORKOWKI, Juscinete Rosa Soares; PESOVENTO, Adriane; TÉCHIO, Kachia Hedeny. Etnociência: um breve levantamento da produção acadêmica de discentes indígenas do curso de educação intercultural. Revista Ciências & Ideias, v. 9, n. 3, p. 188-204, set./dez. 2018. Disponível em: https://revistascientificas.ifrj.edu.br/index. php/reci/article/view/948/620. Acesso em: 5 out. 2025.
Ao trazer a temática para a sala de aula, o professor de Ciências contribui para o reconhecimento e a valorização dos saberes tradicionais, promovendo o respeito à diversidade cultural e incentivando o diálogo entre o conhecimento científico e os saberes locais. Essa abordagem não apenas enriquece o aprendizado, como também promove o respeito às diferentes formas de compreender a natureza.
2.4 INCLUSÃO EM SALA DE AULA
Na busca pela superação das desigualdades de acesso e pela permanência dos estudantes com deficiência na escola, em consonância com a Lei Brasileira de Inclusão da Pessoa com Deficiência (Lei no 13.146, de 2015), é necessário estruturar ações pedagógicas e didáticas tomando como base a ideia de que todas as pessoas aprendem. Para isso, as escolas devem garantir em seus projetos pedagógicos as diretrizes para tais ações. Ao mesmo tempo, o professor deve lançar mão de ferramentas e conhecimentos para promover a inclusão e garantir a participação de todos os estudantes. Conhecer a cognição dos estudantes e seu comportamento é a base para elaborar estratégias de ensino-aprendizagem inclusivas. O entendimento de que os seres humanos são neurodiversos e aprendem de modos e em tempos diferentes amplia o desafio de ensinar. A educação inclusiva é destinada, em última instância, a garantir às pessoas com deficiência o direito de aprender, conviver e se desenvolver em ambiente escolar. O grupo atendido pela educação inclusiva é vasto e muito diverso, contemplando todos os estudantes com deficiências físicas e de neurodesenvolvimento e algumas síndromes.
Há um conjunto de estratégias pedagógicas que podem ser úteis aos professores no trabalho com a educação inclusiva. Elas variam em tipologia e nas formas de aplicação. Muitas podem ser úteis não só para os estudantes que necessitam desses recursos adaptativos e de acessibilidade, mas para todo o grupo-turma.
2.4.1 EDUCAÇÃO INCLUSIVA: ESTRATÉGIAS PEDAGÓGICAS COLETIVAS
1. Para desenvolver habilidades gerais:
• elogiar, estimular e encorajar, atentando à autoestima dos estudantes;
• encorajar habilidades de autonomia e responsabilidade;
• verificar conteúdos, habilidades e conhecimentos adquiridos (sondagens são bem-vindas);
• estimular habilidades sociais;
• variar materiais e atividades para ensinar os mesmos conceitos e objetivos.
2. Para promover o desenvolvimento da organização:
• fornecer instruções diretas e precisas durante as aulas e as atividades;
• incentivar os estudantes a revisar as próprias produções, sempre que possível;
• reduzir o uso de distratores;
• propor o uso rotineiro de cronograma e de quadros de avisos;
• evitar instruções longas, fornecendo comandos breves e objetivos;
• dividir as tarefas complexas em etapas para evitar que os estudantes se percam entre elas, acompanhando o processo;
• monitorar o progresso dos estudantes e oferecer devolutivas frequentes;
• evitar o uso de ambiguidades, metáforas, ironias e outras subjetividades;
• certificar-se de que os estudantes estão atentos antes de passar a instrução – nem sempre haverá contato visual, mas garantir que a atenção exista é fundamental;
• ajudar na organização das tarefas, de modo que os estudantes saibam o que têm de fazer;
• oferecer poucos materiais para uso pessoal dos estudantes;
• apresentar o conteúdo em ordem crescente de complexidade;
• utilizar estratégias “passo a passo”;
• alternar as formas de registro a fim de compensar as dificuldades na escrita;
• inserir repetições e reforços extras sempre que necessário;
• escolher o nível adequado de apoio pedagógico quando algum estudante demandar um educador auxiliar e apoio de um colega, do professor ou de toda a turma;
• adequar contextos de aprendizagem, determinando quando o estudante acompanhará a turma inteira e quando estará em outras configurações, como grupos pequenos, em dupla ou em tutoria individualizada;
• usar fontes simples sobre fundo liso e em letras maiúsculas;
• reforçar instruções orais com apoio visual, acrescentando recursos visuais, como fotografias, ilustrações e esquemas para auxiliar no entendimento do conteúdo – a comunicação visual pode auxiliar na memorização;
• usar materiais concretos e práticos para superar dificuldades com a linguagem, os conceitos abstratos e as habilidades de resolução de problemas;
• usar linguagem simples e familiar.
3. Para desenvolver a leitura e a escrita:
• usar fontes de traços simples;
• empregar palavras simples e sentenças curtas;
• destacar informações em textos, por meio de grifos ou cores;
• criar atividades com apoio de recursos gráficos e visuais.
Outras estratégias, entretanto, são mais assertivas para grupos específicos, categorizadas segundo o tipo de deficiência ou especificidade dos estudantes.
2.4.2 EDUCAÇÃO INCLUSIVA: ESTRATÉGIAS PEDAGÓGICAS ESPECÍFICAS
1. Para desenvolver habilidades gerais:
• investir nas qualidades e no potencial dos estudantes;
• informar-se sobre a condição dos estudantes, reduzindo estigmas, como a ideia de que são preguiçosos;
• fazer contato visual para que se mantenham atentos tanto quanto possível – há estudantes que não respondem a esse estímulo ou que se desregulam;
• envolver os estudantes na rotina da sala de aula, como a atuação em monitoria;
• avaliá-los com questões de múltipla escolha;
• evitar notas atribuídas por caligrafia e ortografia;
• combinar gestos discretos que servirão de alerta para uma possível mudança de comportamento;
• usar sequências de imagens, palavras e textos com espaços em branco ou lacunas a serem preenchidos pelos estudantes;
• utilizar recursos adicionais para auxiliar na escrita (diferentes tipos de lápis, linhas mais grossas, balões e caixas no papel para encorajar um tamanho consistente das letras, papéis com linhas, papéis quadriculados, quadros e painéis para escrita);
• oferecer métodos alternativos de memorização, como copiar, sublinhar ou contornar a resposta correta, copiar e colar imagens, copiar e colar sequências de cartões para formar frases, com ou sem imagens, e usar ferramentas digitais.
2. Para desenvolver a organização:
• aumentar o tempo em tarefas e avaliações;
• antecipar textos usados nas avaliações para estudo prévio;
• em avaliações, oferecer o recurso da leitura em voz alta;
• evitar que os estudantes se sentem próximo de portas e janelas;
• repetir instruções e pedir aos estudantes que as reproduzam;
• antecipar situações que saiam da rotina;
• adaptar procedimentos, atividades, trabalhos e instrumentos de avaliação quando necessário;
• promover rotinas e organização para dar segurança aos estudantes;
• respeitar o tempo e o ritmo dos estudantes na realização das tarefas, atividades e provas –pausas para descanso podem ajudá-los a se reorganizar;
• sempre que necessário, adaptar o material gráfico (exemplos: letras de tamanho maior, letra bastão, maior espaço para registro);
• utilizar recursos visuais como estratégias de ensino, atentando para o excesso de estímulos visuais no ambiente;
• solicitar a ajuda de um colega no lugar da ajuda de um adulto sempre que possível, preferencialmente que se comunique de igual para igual e não tenha excesso de cuidados;
• atentar para momentos com muitos estímulos sensoriais que podem desencadear comportamentos desorganizados e até crises hipersensoriais;
• escrever uma atividade por página nas fichas.
3. Para desenvolver a leitura e a escrita:
• usar fontes de traços simples e limpos;
• usar letras maiúsculas para facilitar a leitura;
• adaptar o tamanho do texto quando possível;
• reduzir a quantidade de material de leitura;
• intercalar textos curtos com perguntas;
• reduzir o tamanho das consignas e retirar distratores;
• incentivar a escrita sobre temas que façam parte da experiência e da compreensão pessoal dos estudantes;
• fazer uso produtivo dos interesses dos estudantes para chamar a atenção deles e engajá-los na proposta, ampliando o repertório de conhecimentos;
• usar programas de estudo ou conceitos básicos de anos anteriores.
4. Para desenvolver habilidades motoras e psicomotoras:
• observar se os estudantes executam movimentos como rolar, engatinhar, arrastar-se, saltar e correr e se conseguem permanecer sentados e andar com ou sem apoio. Criar atividades para que eles executem esses movimentos em circuitos;
• observar como são o passo e o pisar dos estudantes (equilíbrio, ritmo e possíveis estereotipias) e criar atividades para que eles melhorem o caminhar;
• em momentos expositivos, utilizar recursos visuais para que os estudantes acompanhem as explicações;
• elaborar estratégias para que os estudantes aprendam a respeitar regras, oferecendo uma instrução por vez;
• elaborar atividades em que os estudantes possam demonstrar aos colegas o que sabem fazer bem;
• realizar propostas para o desenvolvimento da coordenação motora (grossa e fina);
• corrigir o modo como os estudantes seguram os materiais por meio de exemplos, e não só de explicação;
• oferecer modelos para a realização das práticas esportivas, corporais e artísticas;
• antecipar as atividades da aula, explicando com exatidão o que deverão realizar;
• tornar os estudantes parceiros na aula, atribuindo-lhes alguma função;
• fazer dos estudantes protagonistas em alguns momentos – escolher os colegas para formar um grupo, sugerir um jogo ou atividade física/esportiva/corporal, criar e compartilhar uma regra em um jogo ou brincadeira;
• realizar atividades para que os estudantes percebam sua posição relativa no espaço (trabalhar com a lateralidade);
• oferecer outras opções de atividades em caso de resistência, recusa, cansaço ou desinteresse.
2.4.3 PARA SABER MAIS
• CUNHA, Eugênio. Práticas pedagógicas para inclusão e diversidade. 4. ed. Rio de Janeiro: WAK Editora, 2018.
A obra discute práticas pedagógicas voltadas para a valorização da diversidade e para a inclusão no ambiente escolar.
• DELIBERATO, Débora; GONÇALVES, Maria de Jesus; MANZINI, Eduardo José (org.). Formação colaborativa para profissionais da educação especial: tecnologia assistiva e comunicação alternativa na escola. Goiânia: Sobama, 2024.
A obra reúne pesquisas e práticas que promovem a formação de educadores no uso de tecnologia assistiva e comunicação alternativa, fortalecendo a inclusão escolar e a colaboração entre profissionais da educação e da saúde.
• INSTITUTO JÔ CLEMENTE. Guia da autodefensoria: vamos juntos que agora o papo é nosso! 2. ed. São Paulo: Instituto Jô Clemente, 2022.
Este guia apresenta, de forma acessível e ilustrada, o movimento de autodefensoria das pessoas com deficiência intelectual, incentivando a autonomia e o protagonismo na defesa de seus direitos.
• MASCARO, Cristina A. de C.; ESTEF, Suzani; BUROCK, Neuzilene (org.). Práticas pedagógicas sob a lente da acessibilidade: caminhos para equidade no ensino de estudantes com deficiência intelectual e ou necessidade educacional específica. São Carlos: Pedro & João Editores, 2025.
O texto aborda caminhos para tornar o ensino mais acessível e equitativo, especialmente para estudantes com deficiência intelectual ou necessidades educacionais específicas.
2.5 AVALIAÇÃO
O processo de construção do conhecimento é dinâmico e não linear. Assim, avaliar a aprendizagem implica avaliar também o ensino oferecido. É importante que toda a avaliação esteja relacionada aos objetivos propostos. Assim, os resultados de uma avaliação devem servir para reorientar a prática educacional, e nunca para estigmatizar os estudantes.
Para pensar a avaliação, cuja importância é decisiva no processo de ensino-aprendizagem, lançamos mão das reflexões de César Coll (1999). Para Coll, a avaliação pode ser definida como uma série de atuações que devem cumprir duas funções básicas:
• diagnosticar, ou seja, identificar o tipo de ajuda pedagógica que será oferecido aos estudantes e ajustá-lo progressivamente às características e às necessidades deles;
• controlar, ou seja, verificar se os objetivos foram ou não alcançados (ou até que ponto o foram).
Para diagnosticar e controlar o processo educativo, César Coll recomenda o uso de três tipos de avaliação:
Avaliação diagnóstica Avaliação formativa Avaliação somativa
O que avaliar? Os esquemas de conhecimento relevantes para o novo material ou situação de aprendizagem.
Quando avaliar?
Como avaliar?
No início de uma nova fase de aprendizagem.
Consulta e interpretação do histórico escolar do estudante. Registro e interpretação das respostas e dos comportamentos dos estudantes ante perguntas e situações relativas ao novo material de aprendizagem.
Os progressos, as dificuldades, os bloqueios etc. que marcam o processo de aprendizagem.
Durante o processo de aprendizagem.
Os tipos e graus de aprendizagem que estipulam os objetivos (finais, de nível ou didáticos) a propósito dos conteúdos selecionados.
Ao final de uma etapa de aprendizagem.
Observação sistemática e pautada do processo de aprendizagem. Registro das observações em planilhas de acompanhamento. Interpretação das observações. Observação, registro e interpretação das respostas a perguntas e dos comportamentos dos estudantes em situações que exigem a utilização dos conteúdos aprendidos.
Fonte: COLL, César. Psicologia e currículo. São Paulo: Ática, 1999. p. 151.
Por meio da avaliação diagnóstica, busca-se verificar os conhecimentos prévios dos estudantes e proporcionar a eles a oportunidade de tomar consciência de suas limitações (imprecisões e contradições dos seus esquemas de conhecimento) e da necessidade de superá-las. A seção O que sabemos?, do Livro do Estudante, apresenta subsídios para esse tipo de avaliação no início do ano letivo.
A avaliação formativa é empregada para avaliar o processo de aprendizagem, podendo ser feita por meio da observação sistemática dos estudantes. A seção Retomando, do Livro do Estudante, apresenta subsídios para esse tipo de avaliação ao fim das unidades. Ao longo deste Livro do Professor, as sugestões do boxe +Atividades também podem servir ao propósito da avaliação formativa.
A avaliação somativa é utilizada para medir os resultados da aprendizagem dos estudantes confrontando-os com os objetivos que estão na origem da intervenção pedagógica, a fim de verificar se estes foram ou não alcançados ou até que ponto o foram. Ao final do Livro do Estudante, há a seção O que aprendemos, com atividades que contribuem para essa avaliação.
Note-se que os três tipos de avaliação estão interligados e são complementares, podendo se desdobrar em processos com diferentes propostas. Nesta obra, há atividades variadas, que podem servir a esses propósitos avaliativos. Por meio dessas propostas avaliativas, o professor colhe elementos para planejar, o estudante toma consciência de suas conquistas, dificuldades e possibilidades, e a escola identifica os aspectos das ações educacionais que necessitam de mais apoio.
A avaliação, portanto, deve visar ao processo educativo como um todo, e não ao êxito ou ao fracasso dos estudantes.
2.5.1 ORIENTAÇÕES PARA AVALIAÇÃO
Recomendamos que se empreguem na avaliação:
a) Observação sistemática – a fim de trabalhar as atitudes dos estudantes. Para isso, pode-se utilizar o diário de classe ou instrumento semelhante para fazer anotações. Exemplo: foi solicitado aos estudantes que trouxessem material sobre a questão do meio ambiente, e
um estudante, cujo rendimento na prova escrita não havia sido satisfatório, teve expressiva participação na execução dessa tarefa. Isso deverá ser levado em consideração na avaliação daquele bimestre. A observação sistemática será fundamental, por exemplo, nas atividades distribuídas ao longo dos capítulos nas seções Você cidadão! e Você cientista!, por exigirem espírito associativo e realização de produções variadas.
b) Análise das produções dos estudantes – para estimular a competência dos estudantes na produção, na leitura e na interpretação de textos e imagens. Sugerimos levar em conta toda a produção, e não apenas o resultado de uma prova, e avaliar o desempenho em todos os trabalhos (pesquisa, relatório, história em quadrinhos, releitura de obras clássicas, prova etc.). Note-se que, para o estudante escrever ou desenhar bem, é necessário que ele desenvolva o hábito.
c) Atividades específicas – para estimular, sobretudo, a objetividade dos estudantes ao responder a um questionário ou ao expor um tema. Espera-se que eles sejam capazes de identificar e apresentar o cerne da resposta, distinguindo as informações essenciais de complementos ou detalhes secundários.
d) Autoavaliação – para ajudar o estudante a ganhar autonomia e a desenvolver a autocrítica. Os estudantes avaliam suas produções e a recepção de seus trabalhos pelos colegas, bem como a comunicação de seus argumentos e os resultados das atividades.
2.5.2 ESTRATÉGIAS DE AVALIAÇÃO
A seguir, são apresentadas diferentes estratégias de avaliação que podem ser adaptadas à sua realidade escolar e às necessidades dos estudantes.
a) Portfólio
É uma mostra de exemplos de produções dos estudantes em determinado intervalo de tempo. Pode ser entendida como uma coletânea de trabalhos (produção escrita, oral, visual, apresentação em slides, quadrinhos ou outros suportes) que contribuem para o desenvolvimento de habilidades, atitudes e conhecimentos. O texto a seguir é de Carolina de Castro Nadaf Leal, doutora em Educação e psicopedagoga.
Avaliar por portfólio nos Anos Iniciais do Ensino Fundamental
Sousa C. (1994, p. 89) ressalta que “a avaliação deve ser utilizada com o apoio de múltiplos instrumentos de coleta de informações”. É nesse contexto que se inclui o portfólio como instrumento capaz de superar uma avaliação excludente, classificatória e seletiva, permitindo ao aluno e professor se apropriarem de uma avaliação formativa, com vistas a orientar e organizar o processo de ensino-aprendizagem. [...]
Crockett (1998) conceitua portfólio como uma amostra de exemplos, documentos, gravações ou produções que evidenciam habilidades, atitudes e/ou conhecimentos e aquisições obtidas pelo estudante durante um espaço de tempo. Harp e Huinsker (1997, p. 224), com ideia semelhante, caracterizam o portfólio como “uma coletânea de trabalhos, que demonstram o crescimento, as crenças, as atitudes e o processo de aprendizagem de um aluno”. Sendo assim, um portfólio deve incluir, entre outros itens, planos e reflexões sobre os temas importantes tratados em sala de aula, estudos de caso pertinentes aos conteúdos em evidência, relatórios, sínteses de discussões, produções escritas ou gravadas, que devem ser a base para a avaliação contínua e evolutiva do progresso dos alunos em relação ao aprendizado. Portfólio, de acordo com Shores e Grace (2001, p. 43), é “uma coleção de itens que revela, conforme o tempo passa, os diferentes aspectos do crescimento e do desenvolvimento de cada criança”.
De acordo com elas, dois portfólios nunca podem ser iguais, porque os alunos são diferentes e suas atividades também devem ser diferentes. Acrescentam ainda que uma avaliação realizada por meio de portfólio encoraja a reflexão e a comunicação de todos os envolvidos no processo educativo: professores, alunos, famílias e outros. Ao individualizar as experiências da aprendizagem, o portfólio permite que cada criança possa crescer no seu
próprio potencial máximo; possibilita a cada professor determinar o seu próprio ritmo, encorajando seu desenvolvimento profissional; e acompanha o trabalho da criança através de diferentes domínios das aprendizagens.
Para Rangel (2003, p. 152) a implementação do uso do portfólio “é uma ruptura do modelo técnico e quantitativo de avaliação para um processo multidimensional, solidário e coletivo de ensino/aprendizagem”.
É, portanto, uma proposta que convida o aluno a retomar suas produções, analisá-las, para em seguida assumir um compromisso com o aprender. Em consonância com a tendência atual da educação, a avaliação da aprendizagem por portfólio permite que os professores tenham clareza do que os alunos realmente aprenderam e que os alunos tenham uma referência do que necessitam aprender. É um instrumento de avaliação capaz de organizar o processo de ensino-aprendizagem.
LEAL, Carolina de Castro Nadaf. Avaliar por portfólio nos Anos Iniciais do Ensino Fundamental. In: COLÓQUIO INTERNACIONAL EDUCAÇÃO, CIDADANIA E EXCLUSÃO – DIDÁTICA E AVALIAÇÃO, 4., 2015, Rio de Janeiro. Anais [...]. Rio de Janeiro: [s. n.], 2015. Disponível em: https://editorarealize.com.br/editora/anais/ ceduce/2015/TRABALHO_EV047_MD1_SA4_ID1816_06062015204218.pdf. Acesso em: 5 out. 2025.
b) Seminário
O seminário é um gênero oral empregado com objetivo de expor conhecimentos sobre determinado assunto e que ajuda no desenvolvimento da competência discursiva. Em um seminário, os estudantes, com orientação do professor, investigam um tema e o expõem oralmente (Bezerra, 2003).
O texto a seguir oferece subsídios teóricos sobre o gênero seminário, a fim de orientar sua aplicação em sala de aula. Ressalta-se que, considerando a faixa etária dos estudantes dos Anos Iniciais do Ensino Fundamental, bem como as características da realidade escolar, é possível realizar adaptações em sua estrutura.
[...]
Sobre a arquitetura interna do gênero, Chaves (2008) aponta, ao seguir o modelo de análise de gêneros orais de Dolz (1998/2004), que o seminário é dividido em três momentos: a) etapa pré-expositiva – momento em que os alunos buscam informações, estudam o conteúdo temático, organizam um roteiro da apresentação, isto é, preparam-se para serem especialistas no assunto; b) etapa expositiva – momento em que o seminário se concretiza em sala de aula; c) etapa pós-expositiva – momento em que os alunos interagem com o professor e a plateia.
A etapa expositiva subdivide-se, conforme Chaves (2008), em oito etapas, que apresentamos na Tabela [...]. Antes disso, é importante destacar que, pautados em Bakhtin (2003), compreendemos que essas etapas formam a construção composicional do gênero por se tratar da organização estrutural e discursiva do conteúdo temático.
Tabela [...]: A construção composicional do seminário
Etapas
Abertura
Tomada da palavra
Introdução ao tema
Apresentação do plano de exposição
Desenvolvimento do tema
Recapitulação e síntese
Conclusão
Encerramento
Descrição das atividades a se desenvolver
Momento em que o professor introduz o aluno (ou grupo) apresentando-o para a sala. Esse momento é onde o emissor ou expositor assume o papel social de especialista no assunto.
O aluno cumprimenta a plateia, apresentando-se e assumindo seu lugar como expositor.
O expositor informa à plateia qual o tema do seu seminário, justificando sua importância, para assim despertar interesse dos receptores.
Apresenta o roteiro da apresentação.
O aluno desenvolve o tema seguindo o roteiro.
Relembra a plateia, de maneira concisa, dos principais pontos abordados sobre o tema durante a apresentação.
Momento de encerramento da exposição. Apresentam-se as conclusões sobre o assunto, dando o parecer de um especialista no tema ou deixando o assunto em aberto para debater com a plateia e o professor.
Momento de agradecer à plateia, informar o término da apresentação e se colocar à disposição para responder perguntas e sanar dúvidas sobre algum ponto da exposição.
MENDONÇA, Felipe da Silva; STRIQUER, Marilúcia dos Santos Domingos. O gênero discursivo/textual seminário no livro didático de Língua Portuguesa. Criar Educação, Criciúma, v. 9, n. 1, p. 40-55, jan./jul. 2020. Disponível em: https://periodicos.unesc.net/ojs/index.php/criaredu/article/view/4299/5319. Acesso em: 5 out. 2025.
c) Sarau
No século XIX, os saraus eram eventos que ocorriam no entardecer, promovidos pela nobreza. Atualmente, são eventos populares nas periferias das cidades brasileiras em que os habitantes desses locais contam suas histórias e vivências. O texto a seguir é da professora Mara Mansani. Em 2014, ela recebeu o Prêmio Educador Nota 10, da Fundação Victor Civita, na área de alfabetização.
[...]
Como organizar um sarau
O primeiro passo é apresentá-lo para os alunos. Explique o que é, como pode ser feito, apresente algumas experiências em vídeo e conversem sobre as impressões. Depois, faça um convite para que façam um sarau.
Coletivamente, definam quais serão as apresentações, o local e a duração. Também combinem como irá funcionar, se haverá convidados, quando serão os ensaios e tudo que for necessário para se preparar para o grande dia. [...]
Em sala de aula, mesmo quando as crianças não leem e escrevem convencionalmente, pode começar propondo que apresentem textos que sabem de memória, tradicionais da cultura oral, como parlendas, trava-línguas, versinhos, poemas, entre outros.
Para as próximas vezes que levar a proposta, pode ampliar as possibilidades e explorar diferentes manifestações artísticas de diferentes culturas, como uma dança, uma declamação, uma performance teatral, entre outras. O sarau também pode ser temático. Já pensou que incrível pode ser a experiência de um sarau que explore a arte e cultura africana?
Esse evento pode acontecer só com sua turma, com todos os alunos do ciclo de alfabetização, com toda a escola ou com a participação das famílias. Não há um único formato para o sarau. O que não podemos perder de vista é o caráter democrático da expressão popular de todos e para todos.
MANSANI, Mara. Como organizar saraus na alfabetização. Nova Escola, 4 jul. 2022. Disponível em: https:// novaescola.org.br/conteudo/21288/como-organizar-saraus-na-alfabetizacao. Acesso em: 2 out. 2025.
d) Roda de conversa
Um recurso bastante comum no ensino escolar nos Anos Iniciais do Ensino Fundamental é a roda de conversa. O texto a seguir trata da importância dessa prática no desenvolvimento cognitivo, ético e socioemocional dos estudantes.
A roda de conversa se configura como um dispositivo metodológico que vai além de uma simples atividade de fala. Trata-se de um espaço de construção de sentido, onde a escuta atenta e o respeito à diversidade de opiniões favorecem o desenvolvimento de habilidades socioemocionais, o fortalecimento dos vínculos interpessoais e a reflexão crítica sobre os mais diversos temas. Essa prática tem sido amplamente utilizada em diversas etapas da educação básica, sobretudo na Educação Infantil e nos anos iniciais do Ensino Fundamental [...].
[...] A importância dessa metodologia também é reconhecida nas diretrizes educacionais brasileiras. Os documentos curriculares, como a Base Nacional Comum Curricular (BNCC), ressaltam a necessidade de formar cidadãos críticos, autônomos, empáticos e capazes de se comunicar de forma assertiva e respeitosa. Tais competências são diretamente promovidas pela roda de conversa, que oferece aos estudantes oportunidades reais de expressar suas ideias, argumentar, escutar os colegas e elaborar soluções coletivas para problemas comuns. Além disso, a prática dialogada contribui para o desenvolvimento de competências linguísticas, ampliando o vocabulário, a fluência verbal e a capacidade de organizar e defender um ponto de vista.
Outro aspecto relevante da roda de conversa é sua contribuição para o clima escolar e para a cultura de paz. Ao permitir que os conflitos sejam abordados de forma aberta, respeitosa e construtiva, essa metodologia ajuda a prevenir situações de violência, bullying e discriminação. A escuta ativa e o reconhecimento das emoções e necessidades do outro criam um ambiente de empatia, solidariedade e cooperação. A roda torna-se, assim, um instrumento potente para a promoção de relações saudáveis, para o fortalecimento do senso de pertencimento e para a valorização da diversidade no espaço escolar.
[...] A roda de conversa, como estratégia pedagógica, emerge em um cenário educacional que demanda práticas mais dialógicas, humanizadoras e centradas no estudante. Em um sistema historicamente marcado por modelos de ensino expositivos e verticais, a roda de conversa apresenta-se como uma ruptura epistemológica e metodológica. Ela valoriza o diálogo como instrumento de aprendizagem e promove a participação ativa dos estudantes no processo educativo, oferecendo um espaço seguro para a expressão de ideias, sentimentos, dúvidas e conhecimentos. Esse espaço, quando bem conduzido, é capaz de fomentar o pensamento crítico, a empatia e a construção coletiva do saber, aspectos essenciais para uma formação cidadã e integral. [...]
MANTOVANI, Girlene Nascimento da Silva. Roda de conversa. Revista Primeira Evolução, São Paulo, ano VI, n. 59, p. 99-106, jun. 2025. Disponível em: https://primeiraevolucao.com.br/index.php/R1E/article/ download/725/753. Acesso em: 5 out. 2025.
e) Personalização de atividades
O texto a seguir é da pesquisadora Lilian Bacich, doutora em Psicologia Escolar e do Desenvolvimento Humano pela Universidade de São Paulo. Nele, são apresentadas algumas reflexões sobre a prática da personalização e seu papel de incentivo ao protagonismo dos estudantes.
[...] O que estamos considerando ao falar em personalização? Qual é, efetivamente, o papel dos estudantes e dos educadores? Como os recursos digitais podem ser aliados nessa abordagem?
[...] A proposta está centrada no desenho do percurso educacional de acordo com um contexto que faça sentido aos alunos, por meio da oferta de experiências de aprendizagem que estejam alinhadas às necessidades possíveis de serem contempladas dentro de um campo de experiência indicado para a faixa etária e que, de alguma forma, favoreçam o protagonismo e o desenvolvimento da autonomia. Personalização está relacionada, neste aspecto, à identificação das reais necessidades de aprendizagem dos estudantes, individual e coletivamente, e das intervenções que o educador irá realizar no sentido de possibilitar que seus alunos aprendam mais e melhor. [...]
Desenhar experiências de aprendizagem transforma o papel do professor, que deixa de ser alguém que transmite conteúdos e verifica se eles foram apreendidos, para um designer de percursos educacionais. Para desenhar esses percursos, é importante que o educador tenha dados em mãos, dados que são obtidos por meio de uma avaliação formativa, digital ou não, e que podem incluir as plataformas adaptativas, questionários on-line, além da observação, discussão, interação “olho no olho”. Diversas pesquisas [...] têm enfatizado esse olhar para a personalização em que os estudantes podem ser estimulados a entrar em contato com diferentes experiências de aprendizagem, aquelas de que necessitam, porque têm dificuldade, e aquelas que podem oferecer oportunidade de irem além, pois não estão relacionadas às suas dificuldades, mas às suas facilidades. Essas experiências podem envolver diferentes elementos, digitais ou não, que favoreçam a comunicação, a colaboração, a resolução de problemas, pensamento crítico.
A personalização ocorre quando, ao entrar em contato com diferentes experiências, desenhadas de acordo com as necessidades identificadas em toda a turma, os estudantes são envolvidos em propostas que fazem sentido para eles. Além disso, constroem conhecimentos coletivamente, ao interagirem com seus pares. O professor, nesse momento, não está mais na frente da turma, mas ao lado de grupos de alunos, ou acompanhando uma das experiências que considera mais desafiadora, por exemplo. [...]
[...]
Dessa forma, considerar a personalização no planejamento de aulas inovadoras ao possibilitar o protagonismo e o desenvolvimento da autonomia nas instituições de ensino é uma possibilidade de alcançar o potencial transformador das práticas educativas e fortalecer ainda mais a adoção de metodologias ativas na educação.
BACICH, Lilian. Personalização na prática: algumas reflexões. Inovação na Educação, 5 jan. 2019. Disponível em: https://lilianbacich.com/2019/01/05/personalizacao-na-pratica-algumas-reflexoes/. Acesso em: 5 out. 2025.
2.6 PLANEJAMENTO
O planejamento pedagógico é um componente essencial da prática docente, pois nele o professor organiza e orienta suas ações com base em intencionalidades educativas bem definidas. Mais do que cumprir cronogramas ou executar conteúdos preestabelecidos, planejar significa atuar com base em fundamentos teóricos, prevendo as ações pedagógicas que favoreçam a apropriação crítica e significativa do conhecimento pelos estudantes (Giordan; Guimarães, 2012).
O planejamento pedagógico tem como funções principais garantir a coerência entre ensino, aprendizagem e avaliação, adaptar os conteúdos às características da turma e antecipar possíveis dificuldades, propondo estratégias para superá-las. Trata-se de um processo reflexivo, flexível e contínuo, que deve ser constantemente ajustado com base nas observações em sala de aula, nas necessidades dos estudantes e nas dinâmicas do contexto escolar.
Apesar de sua dinamicidade, é possível propor matrizes de planejamento – tanto de rotina quanto de sequência didática – para organizar de forma prática e sistemática as atividades, os recursos e os objetivos de cada aula ou período de ensino, ampliando a eficiência no trabalho docente.
2.6.1 MATRIZ DE PLANEJAMENTO DE ROTINA
A seguir, é apresentada uma sugestão de matriz de planejamento de rotina. Esse é um recurso importante para a organização da aula, pois estabelece uma rotina previsível, otimiza o tempo e os recursos, além de facilitar o atendimento de estudantes com diferentes ritmos de aprendizagem. Cabe destacar o fato de que se trata de uma sugestão, a ser adaptada de acordo com a realidade de cada escola e turma.
Acolhida
Ativação de saberes
Desenvolvimento de conteúdo
Prática
Socialização
Variável
Variável
Variável
Variável
Recepção dos estudantes
Correção de tarefa, revisão de conteúdo etc.
Apresentação e discussão do conteúdo
Realização de atividades ou seções
Variável
Encaminhamento
Variável
Correção das atividades e compartilhamento dos resultados
Retrospectiva da aula e revisão de estudo
Criar um ambiente acolhedor
Identificar conhecimentos prévios e defasagens
Introduzir ou ampliar o estudo de conceitos
Desenvolver habilidades e competências
Estimular a reflexão e a troca de ideias
Avaliar se os objetivos da aula foram alcançados
Roda de conversa, música etc.
Avaliação diagnóstica, jogos etc.
Lousa, atividades dinâmicas, vídeos etc.
Atividades individuais ou em grupo, jogos, brincadeiras etc.
Lousa, roda de conversa, correção cruzada etc.
Avaliação formativa ou de resultado, questionário, debate etc.
2.6.2 MATRIZ DE PLANEJAMENTO DE SEQUÊNCIA DIDÁTICA
Com o planejamento detalhado de uma sequência didática, busca-se garantir a coerência no processo de ensino-aprendizagem e a efetividade dos objetivos definidos. Além disso, recomenda-se assegurar-se de que os estudantes sejam os protagonistas da ação.
A seguir, é apresentada uma sugestão de matriz de planejamento de sequência didática, que deve ser adaptada de acordo com cada turma e o conteúdo a ser desenvolvido.
Etapa
Definições preliminares
Objetivo
Escolher o tema e os objetivos
Seleção e organização dos conteúdos
Definir os conteúdos abordados
Recursos didáticos
Elencar os recursos didáticos a serem utilizados
Cronograma
Planejamento das aulas
Estabelecer um cronograma
Definir o que será realizado em cada aula
Execução e monitoramento
Assegurar o alinhamento ao tema e aos objetivos definidos
Descrição
Definir um tema central e detalhar os objetivos que devem ser atingidos, indicando as competências e as habilidades da BNCC a serem desenvolvidas
Delimitar os conteúdos, indicando os capítulos do Livro do Estudante e outros materiais a serem estudados
Listar e providenciar os recursos didáticos necessários em cada etapa, como materiais manipuláveis, instrumentos, jogos
Detalhar o cronograma de acordo com cada etapa a ser realizada, incluindo a quantidade de aulas necessária
Descrever de maneira detalhada o trabalho previsto em cada aula, incluindo atividades e outras práticas dos estudantes
No desenvolvimento das aulas, fazer os ajustes necessários ao ritmo da turma e realizar os registros sobre a participação individual e coletiva dos estudantes
Socialização e avaliação
Verificar se os objetivos definidos foram atingidos
Avaliar a realização da sequência didática, a participação dos estudantes e o desenvolvimento da aprendizagem
DISTRIBUIÇÃO DOS CONTEÚDOS, COMPETÊNCIAS E HABILIDADES
3. AS SEÇÕES E OS BOXES DO LIVRO
A coleção é composta de três volumes. Cada volume está organizado em quatro unidades, que abrigam três capítulos cada, cujos conteúdos são enriquecidos com diversos recursos gráficos e visuais, além de seções e boxes complementares e atividades.
As seções e os boxes que compõem cada volume estão listados a seguir.
O QUE SABEMOS?
As atividades da seção visam contribuir para a avaliação diagnóstica. De modo geral, nelas são retomados conteúdos trabalhados no ano anterior, estabelecendo conexões com os que serão estudados ao longo deste volume.
ABERTURA
DA UNIDADE
A página dupla de abertura é constituída de fotografias, ilustrações ou fotomontagens, acompanhadas de um texto introdutório e de questões orais que oferecem aos estudantes a oportunidade de expor seus conhecimentos prévios sobre o tema. Busca-se com esse conteúdo despertar o interesse deles e motivá-los para o estudo da unidade. As respostas iniciais dadas podem ser retomadas pelo professor ao fim da unidade e utilizadas para refletir, em conjunto com a turma, sobre os aprendizados construídos.
ABERTURA DO CAPÍTULO
Os capítulos iniciam-se com imagens e textos de diferentes gêneros, acompanhados de atividades, que proporcionam uma breve contextualização de alguns dos assuntos que serão abordados. As atividades também possibilitam o levantamento dos conhecimentos prévios dos estudantes sobre o conteúdo do capítulo.
DIALOGANDO
Este boxe é formado por um questionamento para incentivar a participação oral da turma no estudo da unidade. Com esse questionamento, espera-se que os estudantes analisem alguma temática que se relaciona ao conteúdo estudado ou que reflitam sobre ela, por vezes aproximando-a de seu cotidiano e de suas experiências pessoais.
GLOSSÁRIO
Este boxe apresenta o significado de palavras do texto que possam ser desconhecidas dos estudantes.
PARA VOCÊ EXPLORAR
Este boxe reúne sugestões de espaços não formais de aprendizagem, como visitas a museus e observatórios. Nele também são indicados livros, filmes, textos complementares, simuladores e vídeos, com o objetivo de expandir o conhecimento construído em sala de aula por meio do uso de Tecnologias Digitais da Informação e Comunicação (TIDCs), sempre com orientações de acompanhamento para uso seguro e responsável.
VOCÊ CIENTISTA!
Nesta seção, propõe-se a execução de atividades práticas com uso de materiais de fácil acesso. Ela se inicia com questionamentos orais que direcionam o assunto da prática, podendo levar os estudantes, com base em observações ou ideias iniciais, a levantar hipóteses. Na sequência, tem-se a descrição dos materiais necessários (Do que eu preciso) e dos procedimentos a serem realizados
(Como fazer). Ao final da seção (Vamos conversar?), há questionamentos sobre os resultados observados, podendo ser proposto o confronto das hipóteses levantadas no início da atividade com esses resultados.
ATIVIDADES
Esta seção é constituída por atividades diversas, em que se utilizam diferentes recursos, como charges, tirinhas, fotografias, ilustrações, reportagens e poemas. Elas foram elaboradas para atender a diferentes finalidades, que incluem, além da consolidação do aprendizado, o desenvolvimento de competências e a mobilização de habilidades da BNCC, assim como o exercício das competências de leitura, escrita e oralidade.
Ademais, esta seção pode auxiliar os professores a avaliar o aprendizado dos estudantes.
VOCÊ LEITOR!
Esta seção tem como finalidade ampliar a competência leitora dos estudantes por meio do contato com diferentes gêneros textuais e imagéticos. Os recursos apresentados favorecem a interpretação, a análise crítica e a construção de sentidos em diálogo com os conteúdos de Ciências, enriquecendo a compreensão e possibilitando conexões com temas científicos que complementam e aprofundam o estudo da unidade.
VOCÊ ESCRITOR!
Pretende-se com esta seção desenvolver a competência escritora dos estudantes por meio de atividades que os incentivam a produzir textos de gêneros variados relacionados aos temas da unidade. A proposta é estimular a escrita como forma de organizar ideias, argumentar e expressar conhecimentos, levando os estudantes a conectar os conteúdos de Ciências à prática da escrita e a fortalecer sua compreensão e sua participação ativa no processo de aprendizagem.
VOCÊ CIDADÃO!
Por meio desta seção, os estudantes são incentivados a conhecer seu entorno, sua comunidade, seu município e seu país, e a refletir sobre melhorias para esses espaços. Ao mesmo tempo, promove-se a articulação dos conteúdos de Ciências com os TCTs, favorecendo a formação crítica e preparando os estudantes gradualmente para o exercício da cidadania.
DIALOGANDO COM
Esta seção tem como finalidade integrar os conteúdos de Ciências da Natureza com outros componentes curriculares, como os de Língua Portuguesa, Matemática, História, Geografia e Arte. Ao relacionar saberes, conceitos e práticas de diferentes componentes, as atividades favorecem um aprendizado mais significativo, interdisciplinar e conectado também aos TCTs.
ORGANIZANDO IDEIAS
A seção, por meio de um esquema, apresenta a relação entre os principais conceitos da unidade, favorecendo o estabelecimento de conexões entre eles, o que contribui para a organização do conhecimento. A seção pode ser utilizada como ferramenta de avaliação somativa.
RETOMANDO
A seção oferece atividades para revisão dos temas da unidade. Elas dão subsídios para a avaliação formativa e para o monitoramento da aprendizagem.
O QUE APRENDEMOS
Ao fim do ano letivo, as atividades desta seção encerram o livro e oferecem subsídios para a avaliação somativa dos conteúdos estudados.
4. MATRIZ ARTICULADORA DESTE VOLUME
Conceitos
• Microscópios
• Microrganismos (bactérias, protozoários, fungos e algas)
• Vírus
1
• Aplicações dos microrganismos na produção de alimentos, medicamentos, combustíveis e outros
• Doenças causadas por microrganismos e vírus (formas de transmissão, sintomas e atitudes para a prevenção)
• Classificação dos animais quanto aos hábitos alimentares (carnívoros, herbívoros e onívoros)
• Fotossíntese
• Cadeia alimentar
• Classificação dos seres vivos quanto à posição que ocupam nas cadeias alimentares (produtores, consumidores e decompositores)
• Ciclo da matéria nas cadeias alimentares
• Fluxo de energia nas cadeias alimentares
• Ecossistema
• Exemplos de ecossistemas brasileiros
• Impactos de atividades humanas nos ecossistemas
Competências e Temas
Contemporâneos Transversais
Competências gerais:
• 1, 2, 4, 6, 8, 9, 10
Competências específicas de Ciências da Natureza para o Ensino
Fundamental:
• 1, 2, 3, 4, 6, 7, 8
Temas
Contemporâneos
Transversais:
• Diversidade cultural
• Educação ambiental
• Trabalho
• Saúde
Objetos de conhecimento
Habilidades
• Microrganismos (EF04CI07) Verificar a participação de microrganismos na produção de alimentos, combustíveis, medicamentos, entre outros.
(EF04CI08) Propor, a partir do conhecimento das formas de transmissão de alguns microrganismos (vírus, bactérias e protozoários), atitudes e medidas adequadas para prevenção de doenças a eles associadas.
Competências gerais:
• 2, 4, 5, 6, 7, 9, 10 Competências
específicas de Ciências da Natureza para o Ensino
Fundamental:
• 1, 2, 4, 5, 6, 8
Temas
Contemporâneos
Transversais:
• Ciência e tecnologia
• Diversidade cultural
• Educação ambiental
• Edução para o consumo
• Saúde
• Cadeias alimentares simples
• Microrganismos
(EF04CI04) Analisar e construir cadeias alimentares simples, reconhecendo a posição ocupada pelos seres vivos nessas cadeias e o papel do Sol como fonte primária de energia na produção de alimentos.
(EF04CI05) Descrever e destacar semelhanças e diferenças entre o ciclo da matéria e o fluxo de energia entre os componentes vivos e não vivos de um ecossistema.
(EF04CI06) Relacionar a participação de fungos e bactérias no processo de decomposição, reconhecendo a importância ambiental desse processo.
Conceitos
• Estados físicos dos materiais (sólido, líquido e gasoso)
• Mudanças de estados físicos (vaporização, condensação, solidificação e fusão)
• Transformações reversíveis
• Transformações irreversíveis
• Cozimento dos alimentos
• Combustão
• Decomposição
• Ferrugem
• Misturas
• Processos de separação de misturas (catação, peneiração, filtração, decantação e evaporação)
• Movimento aparente do Sol
• Pontos cardeais
• Rosa dos ventos
• Gnômon
• Bússola
• Magnetismo
• Sistema de Posicionamento Global (GPS)
• Movimentos da Terra (rotação e translação)
• Ciclo da Lua
• Calendários
Competências e Temas
Contemporâneos Transversais
Competências gerais:
• 2, 3, 4, 5, 7, 9, 10
Competências específicas de Ciências da Natureza para o Ensino Fundamental:
• 2, 3, 4, 5, 6, 8 Temas
Contemporâneos Transversais:
• Ciência e tecnologia
• Educação ambiental
• Educação em Direitos Humanos
• Educação para o consumo
• Educação para valorização do multiculturalismo nas matrizes históricas e culturais brasileiras
• Saúde
Competências gerais:
• 1, 2, 5, 10
Competências específicas de Ciências da Natureza para o Ensino
Fundamental:
• 1, 2, 3, 6, 8
Temas
Contemporâneos
Transversais:
• Ciência e tecnologia
• Diversidade cultural
• Educação ambiental
• Educação para o consumo
• Educação para valorização do multiculturalismo nas matrizes históricas e culturais brasileiras
Objetos de conhecimento Habilidades
• Misturas
• Transformações reversíveis e não reversíveis
• Pontos cardeais
• Calendários, fenômenos cíclicos e cultura
(EF04CI01) Identificar misturas na vida diária, com base em suas propriedades físicas observáveis, reconhecendo sua composição.
(EF04CI02) Testar e relatar transformações nos materiais do dia a dia quando expostos a diferentes condições (aquecimento, resfriamento, luz e umidade).
(EF04CI03) Concluir que algumas mudanças causadas por aquecimento ou resfriamento são reversíveis (como as mudanças de estado físico da água) e outras não (como o cozimento do ovo, a queima do papel etc.).
(EF04CI09) Identificar os pontos cardeais, com base no registro de diferentes posições relativas do Sol e da sombra de uma vara (gnômon).
(EF04CI10) Comparar as indicações dos pontos cardeais resultantes da observação das sombras de uma vara (gnômon) com aquelas obtidas por meio de uma bússola.
(EF04CI11) Associar os movimentos cíclicos da Lua e da Terra a períodos de tempo regulares e ao uso desse conhecimento para a construção de calendários em diferentes culturas.
5. SUBSÍDIOS PARA O PLANEJAMENTO (BIMESTRAL,
TRIMESTRAL E SEMESTRAL)
Os quadros a seguir podem subsidiar o seu planejamento, a depender do cronograma da escola, por meio de uma sugestão de organização dos conteúdos em propostas bimestrais, trimestrais e semestrais a serem desenvolvidas no ano letivo. Para a produção destas sugestões de planejamento, foi considerado o ano letivo com 40 semanas e duas aulas semanais de Ciências da Natureza.
B – Bimestre T – Trimestre S – Semestre
CONTEÚDOS
Avaliação diagnóstica: O que sabemos? 8 e 9 1 1o 1o 1o
Abertura da unidade 1 – Mundo microscópico 10 e 11 1
Abertura do capítulo 1 – Seres vivos microscópicos 12 2
Microscópios: revelando o que está escondido 13 e 14 2
3 Vírus, um caso à parte 18 e 19 4
Você cientista! – Microscópio de gota de água 20 e 21 4 e 5
Abertura do capítulo 2 – Diferentes aplicações dos microrganismos 22 5
Microrganismos e alimentos
Você cientista! – Fermentação do pão
Microrganismos, medicamentos e vacinas
5
5
Microrganismos e agricultura 26 5
Você leitor! 26 e 27 6
Microrganismos e combustíveis 27 e 28 6
Você cidadão! – Plásticos biodegradáveis 29 6
Abertura do capítulo 3 – Microrganismos e saúde 30 7
Microrganismos e vírus podem causar doenças 31 7
Doenças transmitidas pela saliva 31 7
Doenças transmitidas pela água e por alimentos contaminados 32 7
Doenças transmitidas por insetos 33 e 34 8
Você cidadão! – Cuidar do corpo: dos pés à cabeça 35 8
Prevenção de doenças causadas por microrganismos e vírus 36 a 38 8
Você escritor! 37 8
Você cidadão! – Mulheres na ciência
Dialogando com Geografia
9
e 41 9 Organizando ideias
10
CONTEÚDOS
Abertura da unidade 2 – Os seres vivos e suas relações 44 e 45 11
Abertura do capítulo 1 – A alimentação dos animais e das plantas 46 11
Alimentação dos animais
Você cidadão! – Pragas urbanas
11
12
Alimentação das plantas 49 a 51 12 e 13
Você cientista! – As plantas e a luz solar 49 13
Você leitor! 52 13
Os animais e as plantas respiram 53 e 54 14
Você leitor! 55 14
Abertura do capítulo 2 – Relações alimentares entre os seres vivos 56 15
Cadeia alimentar
Cada um em seu lugar na cadeia alimentar
Você cidadão! – Tempo de decomposição
Você cientista! – Composteira
15
15
15
15 e 16
A matéria na cadeia alimentar 61 16
A energia na cadeia alimentar
61 e 62 16
Abertura do capítulo 3 – Ecossistemas 63 17
O que é um ecossistema? 64 17
Exemplos de ecossistemas brasileiros
Desequilíbrio dos ecossistemas
65 a 67 17 e 18
68 a 70 18
Você cidadão! – Abelhas e agrotóxicos 71 19
Dialogando com Geografia e História 72 e 73 19
Você escritor! 74 19
Organizando ideias
Avaliação formativa: Retomando
75 20
76 e 77 20
CONTEÚDOS
Abertura da unidade 3 – Os materiais e suas transformações
Abertura do capítulo 1 – Transformações reversíveis dos materiais
Estados físicos dos materiais
Mudanças de estado físico
Você cientista! – Onde a água foi parar?
Os materiais mudam
e 79 21 3o
21
21
e 83 22
22
23
Você leitor! 86 a 88 23
Abertura do capítulo 2 – Transformações irreversíveis dos materiais 89 24
Os materiais passam por mudanças irreversíveis 90 24 Preparo de alimentos
Você cidadão! – A queima de combustíveis e o ambiente
Decomposição
Ferrugem
Você cientista! – Proteção contra ferrugem
Dialogando com Arte e História
Abertura do capítulo 3 – Misturas
O que são misturas?
Mistura de metais
Você escritor!
Água como solvente
Separação de misturas
Você cidadão! – Filtro de barro
Você escritor!
Organizando ideias
Avaliação formativa: Retomando
24
24
24
25
e 95 25
25
e 97 26
26 3o
27
27
27
28
a 104 28 e 29
30
e 109 30
CONTEÚDOS
Abertura da unidade 4 – O céu me orienta: Sol, Lua e instrumentos 110 e 111 31 4o 3o 2o
Abertura do capítulo 1 – No céu, o Sol 112 31
Diferentes posições do Sol no céu 113 32
Pontos cardeais 114 e 115 32
Você cidadão! – As construções e o Sol 116 33
Gnômon 117 33
Você cientista! – Gnômon e os pontos cardeais 118 e 119 33
Abertura do capítulo 2 – Instrumentos de orientação 120 34
Bússolas 121 e 122 34
Magnetismo 123 e 124 34
O magnetismo da Terra 124 34
Sistema de Posicionamento Global (GPS) 125 e 126 35
Você cientista! – Bússola caseira 127 e 128 35
Abertura do capítulo 3 – Movimentos da Terra e da Lua 129 36
Rotação da Terra 130 36
Você cientista! – Modelo de rotação da Terra 131 36
Translação da Terra 132 37
Ciclo da Lua 133 37
O calendário 134 a 136 37
Você escritor! 136 38
Você leitor! 137 38
Dialogando com História e Geografia 138 e 139 38
Organizando ideias 140 39
Avaliação formativa: Retomando 141 39
Avaliação somativa: O que aprendemos 142 e 143 40
REFERÊNCIAS BIBLIOGRÁFICAS COMENTADAS
ANDRADE, D. F.; MASSABNI, V. G. O desenvolvimento de atividades práticas na escola: um desafio para os professores de Ciências. Ciência & Educação , Bauru, v. 17, n. 4, p. 835-850, 2011. Disponível em: https://www.scielo.br/j/ciedu/a/ vYTLzSk4LJFt9gvDQqztQvw/?format=pdf&lang=pt. Acesso em: 2 out. 2025.
No artigo, são abordados conceitos e práticas relacionados ao ensino de Ciências.
BACICH, Lilian. Personalização na prática: algumas reflexões. Inovação na Educação , 5 jan. 2019. Disponível em: https://lilianbacich.com/2019/01/05/ personalizacao-na-pratica-algumas-reflexoes/. Acesso em: 5 out. 2025.
O trabalho apresenta reflexões sobre a personalização na prática educativa, destacando como o uso de metodologias inovadoras pode favorecer a aprendizagem significativa e o protagonismo dos estudantes.
BEZERRA, M. A. Seminário – mais que uma técnica de ensino, um gênero discursivo. In: CONGRESO DE LA ASOCIACIÓN LATINOAMERICANA DE ESTUDIOS DEL DISCURSO, 2., 2003, Puebla-Mx. Caderno de Resumos Puebla-Mx: [s. n.], 2003. v. 1, p. 62-63. O trabalho apresenta o seminário como um gênero discursivo, indo além da visão de simples técnica de ensino.
BRASIL. [Constituição (1988)]. Constituição da República Federativa do Brasil . Brasília, DF: Presidência da República, 1988. Disponível em: http://www.planalto.gov.br/ccivil_03/constituicao/ constituicaocompilado.htm. Acesso em: 5 out. 2025. O documento estabelece os princípios fundamentais e os direitos e deveres que regem o Estado e a sociedade brasileira, servindo de base para todas as demais leis do país.
BRASIL. Lei no 9.394, de 20 de dezembro de 1996 Estabelece as diretrizes e bases da educação nacional. Brasília, DF: Presidência da República, 1996. Disponível em: http://www.planalto.gov.br/ccivil_03/leis/L9394. htm. Acesso em: 5 out. 2025.
O documento institui a Lei de Diretrizes e Bases da Educação Nacional (LDB), definindo os princípios, os fins e a organização da educação brasileira em todos os seus níveis e modalidades de ensino.
BRASIL. Lei no 13.005, de 25 de junho de 2014. Aprova o Plano Nacional de Educação – PNE e dá outras providências. Brasília, DF: Presidência da República, 2014. Disponível em: https://www2.camara.leg.br/legin/fed/lei/2014/lei13005-25-junho-2014-778970-publicacaooriginal-144468pl.html. Acesso em: 5 out. 2025.
O documento define as diretrizes, metas e estratégias para a política educacional brasileira no período de 2014 a 2024, orientando ações voltadas à garantia do direito à educação de qualidade para todos.
BRASIL. Lei no 13.146, de 6 de julho de 2015. Institui a Lei Brasileira de Inclusão da Pessoa com Deficiência (Estatuto da Pessoa com Deficiência). Brasília, DF: Presidência da República, 2015. Disponível em: https://
www.planalto.gov.br/ccivil_03/_ato2015-2018/2015/lei/ l13146.htm. Acesso em: 5 out. 2025.
O documento garante os direitos das pessoas com deficiência e promove sua inclusão em todos os aspectos da sociedade.
BRASIL. Ministério da Educação. Base Nacional Comum Curricular: educação é a base. Brasília, DF: MEC, 2018. Disponível em: https://www.gov.br/mec/ pt-br/escola-em-tempo-integral/BNCC_EI_EF_110518_ versaofinal.pdf. Acesso em: 5 out. 2025.
O documento orienta as diretrizes curriculares brasileiras.
BRASIL. Ministério da Educação. Compromisso Nacional Criança Alfabetizada. Gov.br, 2023. Disponível em: https://www.gov.br/mec/pt-br/crianca-alfabetizada. Acesso em: 2 out. 2025.
O documento define as metas, estratégias e ações articuladas entre União, estados e municípios para assegurar a alfabetização de todas as crianças brasileiras até o final do 2o ano do Ensino Fundamental.
BRASIL. Ministério da Educação. Temas Contemporâneos Transversais na BNCC. Brasília, DF: MEC, 2019, p. 7. Disponível em: https:// basenacionalcomum.mec.gov.br/images/ implementacao/guia_pratico_temas_contemporaneos. pdf. Acesso em: 5 out. 2025.
O documento orienta a inserção dos Temas Contemporâneos Transversais na Base Nacional Comum Curricular, propondo abordagens integradas que promovem a formação ética, crítica e cidadã dos estudantes.
CACHAPUZ, A.; PRAIA, J.; JORGE, M. Da educação em ciência às orientações para o ensino das ciências: um repensar epistemológico. Ciência & Educação , v. 10, n. 3, p. 363-381, 2004. Disponível em: https://www.scielo.br/j/ciedu/a/ dJV3LpQrsL7LZXykPX3xrwj/?format=pdf&lang=pt. Acesso em: 6 out. 2025.
O artigo aborda reflexões epistemológicas relacionadas ao ensino de Ciências Naturais.
CHASSOT, A. Alfabetização científica: uma possibilidade para a inclusão social. Revista Brasileira de Educação , n. 22, jan./abr. 2003. Disponível em: https://www.scielo.br/j/rbedu/a/ gZX6NW4YCy6fCWFQdWJ3KJh/?format=pdf&lang=pt. Acesso em: 2 out. 2025.
O artigo discute a alfabetização científica como ferramenta de transformação social.
COLL, César. Psicologia e currículo. São Paulo: Ática, 1999.
O livro explora a aplicação da Psicologia na construção de currículos educativos.
CONCEIÇÃO, E. M. S. M. da et al. A rotina na educação infantil. Revista Ibero-Americana de Humanidades, Ciências e Educação, São Paulo, v. 9, n. 2, fev. 2023. Disponível em: https://periodicorease.pro.br/rease/ article/view/4045/1568. Acesso em: 6 out. 2025.
O artigo aborda elementos associados à rotina escolar das crianças.
COSTA, A. Desenvolver a capacidade de argumentação dos estudantes: um objectivo pedagógico fundamental. Revista Iberoamericana de Educación, v. 46, n. 5, p. 1-8, 2008. Disponível em: https://rieoei.org/RIE/ article/view/1951. Acesso em: 6 out. 2025.
A pesquisa discute a argumentação como objetivo na área de Ciências Naturais.
COSTA, T. P. A.; NOGUEIRA, C. S. M.; CRUZ, A. P. As atividades práticas no ensino de Ciências: limites e possibilidades sobre o uso desse recurso didático no processo de ensino-aprendizagem. Revista Macambira, v. 4, n. 2, jul./dez. 2020. Disponível em: https://doi.org/10.35642/rm.v4i2.501. Acesso em: 6 out. 2025.
O artigo aborda as possibilidades didáticas para as atividades práticas no ensino de Ciências.
COTTA, D. B.; SILVA, M. E. B.; SASSERON, L. H. Alfabetização científica: aprender Ciências para transformar a sociedade. SciELO em Perspectiva: Humanas, 2021. Disponível em: https://humanas.blog. scielo.org/blog/2021/12/16/alfabetizacao-cientifica -aprender-ciencias-para-transformar-a-sociedade/. Acesso em: 6 out. 2025.
O artigo aborda a relação entre o ensino de Ciências e a aprendizagem crítica.
FERRO, M. G. D.; PAIXÃO, M. S. S. L. Psicologia da aprendizagem: fundamentos teórico-metodológicos dos processos de construção do conhecimento. Teresina: EDUFPI, 2017. Disponível em: https://www. ispsn.org/sites/default/files/documentos-virtuais/pdf/ livro_psicologia_da_aprendizagem_e-book_.pdf. Acesso em: 6 out. 2025.
Nesse livro, discutem-se variadas correntes psicológicas relacionadas à educação.
GIORDAN, M.; GUIMARÃES, Y. A. F. Estudo dirigido de iniciação à sequência didática. Especialização em Ensino de Ciências, Rede São Paulo de Formação Docente (REDEFOR). Faculdade de Educação da Universidade de São Paulo, São Paulo, 2012. Disponível em: http://www.lapeq.fe.usp.br/textos/fp/fppdf/ giordan_guimaraes-redefor-sd-2012.pdf. Acesso em: 2 out. 2025.
Introdução à elaboração de sequências didáticas com base no modelo topológico de ensino.
HAYDT, R. C. C. Curso de Didática Geral. São Paulo: Ática, 2011.
Nesse livro, a autora discorre sobre diversos aspectos da prática docente. Um dos capítulos é destinado à avaliação, no qual é possível encontrar a conceituação de seus tipos e suas funções.
LEAL, C. de C. N. Avaliar por portfólio nos Anos Iniciais do Ensino Fundamental. In : COLÓQUIO INTERNACIONAL EDUCAÇÃO, CIDADANIA E EXCLUSÃO – DIDÁTICA E AVALIAÇÃO, 4., 2015, Rio de Janeiro. Anais [...]. Rio de Janeiro: [s. n.], 2015. Disponível em: https:// editorarealize.com.br/editora/anais/ceduce/2015/ TRABALHO_EV047_MD1_SA4_ID1816_06062015204218. pdf. Acesso em: 5 out. 2025. O artigo discute a avaliação por portfólio nos Anos Iniciais do Ensino Fundamental, destacando sua importância como ferramenta de diagnóstico e acompanhamento do desenvolvimento dos estudantes.
MANSANI, M. Como organizar saraus na alfabetização. Nova Escola, 4 jul. 2022. Disponível em: https:// novaescola.org.br/conteudo/21288/como-organizar -saraus-na-alfabetizacao. Acesso em: 6 out. 2025. O texto apresenta orientações sobre como organizar saraus na alfabetização, valorizando a integração da leitura e a expressão artística na Educação Infantil.
MANTOVANI, G. N. da S. Roda de conversa. Revista Primeira Evolução, São Paulo, ano VI, n. 59, p. 99-106, jun. 2025. Disponível em: https://primeiraevolucao. com.br/index.php/R1E/article/download/725/753. Acesso em: 5 out. 2025.
O texto aborda a prática da roda de conversa como uma estratégia pedagógica para promover a reflexão e a interação entre os estudantes, desenvolvendo habilidades sociais e cognitivas.
MARANDINO, M. et al. A educação não formal e a divulgação científica: o que pensa quem faz? In : ENCONTRO NACIONAL DE PESQUISA EM EDUCAÇÃO EM CIÊNCIAS, 4., 2003, Bauru. Anais [...]. Bauru: Abrapec, 2003. Disponível em: https://fep.if.usp.br/~profis/ arquivo/encontros/enpec/ivenpec/Arquivos/Orais/ ORAL009.pdf. Acesso em: 6 out. 2025.
O artigo aborda elementos teórico-práticos relacionados à educação não formal.
MENDONÇA, F. da S.; STRIQUER, M. dos S. D. O gênero discursivo/textual seminário no livro didático de Língua Portuguesa. Criar Educação, Criciúma, v. 9, n. 1, p. 40-55, jan./jul. 2020. Disponível em: https:// periodicos.unesc.net/ojs/index.php/criaredu/article/ view/4299/5319. Acesso em: 5 out. 2025.
O estudo analisa o uso do gênero discursivo seminário nos livros didáticos de Língua Portuguesa, destacando suas potencialidades e seus desafios no ensino da língua.
MOREIRA, M. A.; MASINI, E. F. S. Aprendizagem significativa: a teoria de David Ausubel. São Paulo: Centauro, 2006.
O livro aborda elementos relacionados ao conceito de aprendizagem significativa.
MUNFORD, D.; TELES, A. P. S. Argumentação e a construção de oportunidades de aprendizagem em aulas de Ciências. Ensaio: Pesquisa em Educação em Ciências , Belo Horizonte, v. 17, p. 161-185, 2015. Disponível em: https://www.scielo.br/j/epec/a/ vSfsgjym8KzcBM9j3Y9xfbn/abstract/?lang=pt. Acesso em: 6 out. 2025.
O artigo apresenta reflexões teórico-metodológicas associadas às oportunidades de argumentação em aulas de Ciências.
NARDI, R.; GATTI, S. R. T. Uma revisão sobre as investigações construtivistas nas últimas décadas: concepções espontâneas, mudança conceitual e ensino de Ciências. Ensaio: Pesquisa em Educação em Ciências, Belo Horizonte, v. 6, n. 2, p. 165-184, jul./dez. 2004. Disponível em: https://www.scielo.br/j/ epec/a/M3YCG49X3CWZkqLn9WWx3dJ/?format=pdf. Acesso em: 6 out. 2025.
O artigo aborda elementos relacionados aos conhecimentos prévios e ao ensino de Ciências nas décadas de 1970, 1980 e 1990.
NEVES, I. C. Bitencourt (org.) et al. Ler e escrever: compromisso de todas as áreas. 9. ed. Porto Alegre: Editora da UFRGS, 2011.
A obra reúne reflexões sobre a importância de ler e escrever como um compromisso de todas as áreas do conhecimento, destacando práticas interdisciplinares no ensino da língua portuguesa.
OLIVEIRA, J. C.; ZANETIC, J. Imagens científicas e ensino de Ciências: uma experiência docente de construção de representação simbólica a partir do referente real. Cadernos CEDES, Campinas, v. 34, n. 92, abr. 2014. Disponível em: https://www.scielo.br/j/ ccedes/a/8PW6GNCjmQJdNM5BQhc33VM/. Acesso em: 2 out. 2025.
No artigo, destaca-se a relação entre as imagens e o ensino de Ciências Naturais com base em uma experiencia pedagógica.
PEREIRA, R. G. Prescrições curriculares e formação docente para o ensino de Ciências : possíveis implicações das escolhas do Currículo da Cidade para a formação de estudantes do Ensino Fundamental da rede pública municipal de São Paulo. 2024. 330 f. Tese (Doutorado em Educação) – Faculdade de Educação, Universidade de São Paulo, São Paulo, 2024. Na tese, ressaltam-se aspectos do letramento científico na organização curricular em Ciências Naturais.
REIS, D. A. dos; NEGRÃO, F. da C. O uso pedagógico das tecnologias digitais: do currículo à formação de professores em tempos de pandemia. Revista da FAEEBA: Educação e Contemporaneidade, Salvador, v. 31, n. 65, p. 174-187, 2022. Disponível em: https:// revistas.uneb.br/index.php/faeeba/article/view/11392.
Acesso em: 6 out. 2025.
No artigo, discutem-se questões relacionadas ao uso pedagógico da tecnologia.
RIBEIRO, M. F. Ensino de ciências por meio da leitura de imagem: estado do conhecimento de dissertações e teses brasileiras. Ambiente: Gestão e Desenvolvimento, [S. l.], v. 17, n. 2, p. 127-147, 2024. Disponível em: https:// periodicos.uerr.edu.br/index.php/ambiente/article/ view/1353. Acesso em: 6 out. 2025.
No artigo, debate-se a imagem como elemento pedagógico no campo das Ciências Naturais.
SANTOS, C. F.; MENDONÇA, M. (org.). Alfabetização e letramento: conceitos e relações. Belo Horizonte: Autêntica, 2007.
Nesse livro, as autoras discorrem sobre a conceituação de alfabetização e letramento.
SASSERON, L. H.; CARVALHO, A. M. P. Alfabetização científica e domínios do conhecimento científico: proposições para uma perspectiva formativa comprometida com a transformação social. Ensaio Pesquisa em Educação em Ciências, v. 23, 2021. Disponível em: https://www.scielo.br/j/epec/a/ ZKp7zd9dBXTdJ5F37KC4XZM/. Acesso em: 2 out. 2025. No artigo, conceituam-se os principais aspectos relacionados ao letramento científico.
SILVEIRA, N. L. D. da. Psicologia educacional : desenvolvimento e aprendizagem. Florianópolis: Universidade Federal de Santa Catarina, 2014. 175 p. Il. No livro, descrevem-se diversas correntes relacionadas à Psicologia da Educação, assim como suas aplicações.
SOBRAL, L. R.; TEIXEIRA, S. C. M. Conhecimentos prévios: investigando como são utilizados pelos professores de Ciências das séries iniciais do Ensino Fundamental. In: ENCONTRO NACIONAL DE PESQUISA EM EDUCAÇÃO EM CIÊNCIAS, 6., 2007, Florianópolis. Anais [...]. Florianópolis: Abrapec, 2007. p. 1-11. Disponível em: https://abrapec.com/atas_enpec/ vienpec/CR2/p654.pdf. Acesso em: 6 out. 2025.
No artigo, aborda-se a relação entre os conhecimentos prévios dos estudantes e o ensino de Ciências.
TEIXEIRA, M. T.; REIS, M. F. A organização do espaço em sala de aula e as suas implicações na aprendizagem cooperativa. Meta: avaliação, Rio de Janeiro, v. 4, n. 11, p. 162-187, maio/ago. 2012. Disponível em: https:// revistas.cesgranrio.org.br/index.php/metaavaliacao/ article/view/138/pdf. Acesso em: 2 out. 2025.
No artigo, debatem-se questões relacionadas à organização do espaço pedagógico como possibilidade de engajamento nas ações educativas.
TERCI, D. B. L.; ROSSI, A. V. Dinâmicas de ensino e aprendizagem em espaços não formais. In: ENCONTRO NACIONAL DE PESQUISA EM EDUCAÇÃO EM CIÊNCIAS, 10., 2015. Anais [...]. Águas de Lindóia: Abrapec, 2015. Disponível em: https://www.abrapec.com/enpec/x -enpec/anais2015/resumos/R0977-1.PDF. Acesso em: 5 out. 2025.
O trabalho explora as dinâmicas de ensino e aprendizagem em espaços não formais, discutindo as possibilidades educativas fora do ambiente escolar tradicional.
THIESEN, J. S. A interdisciplinaridade como um movimento articulador no processo ensino-aprendizagem. Revista Brasileira de Educação , v. 13, n. 39, p. 545–554, 2008. Disponível em: https:// doi.org/10.1590/S1413-24782008000300010. Acesso em: 15 out. 2025.
No artigo, o autor discute questões relacionadas à interdisciplinaridade.
WIECZORKOWKI, J. R. S.; PESOVENTO, A.; TÉCHIO, K. H. Etnociência: um breve levantamento da produção acadêmica de discentes indígenas do curso de educação intercultural. Revista Ciências & Ideias, v. 9, n. 3, p. 188-204, set./dez. 2018. Disponível em: https:// revistascientificas.ifrj.edu.br/index.php/reci/article/ view/948/620. Acesso em: 5 out. 2025.
O artigo faz um levantamento sobre a produção acadêmica de discentes indígenas no curso de educação intercultural, ressaltando a contribuição dessas pesquisas para o campo educacional.
